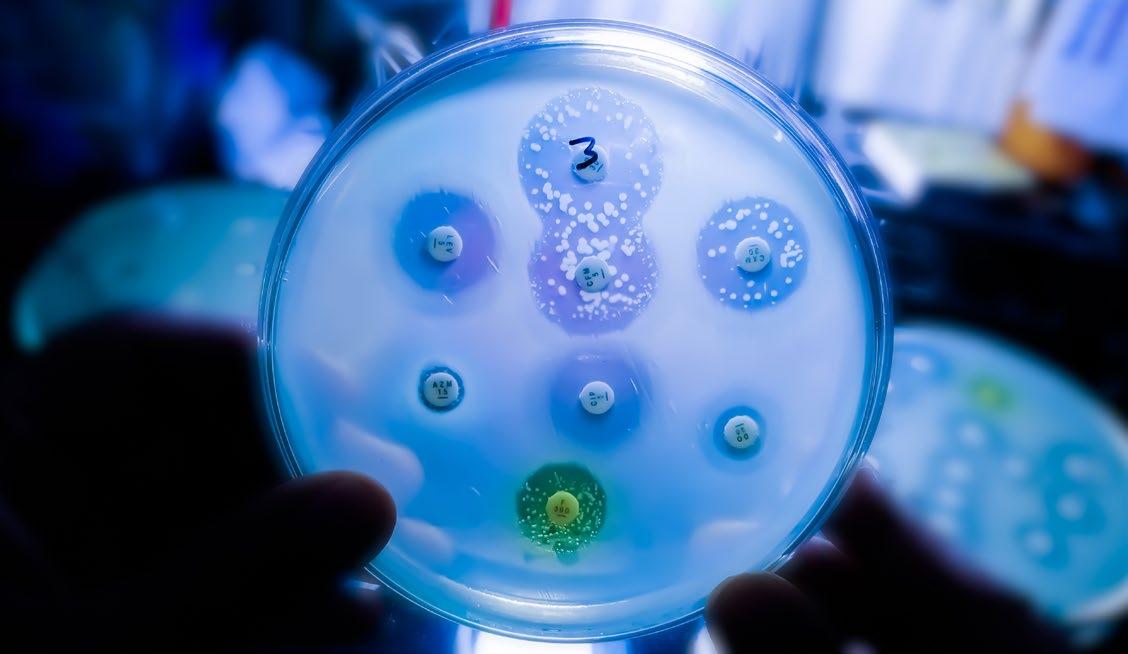

MONTHLY MAGAZINE FOR INDUSTRIAL SANITISATION AND ENVIRONMENTAL HYGIENE
















4CleanPro

RECYCLED FROM PAPER THAT HAS NEVER BEEN USED
Paper not coming from post-consumer and/or municipal waste.

RECYCLED SOLUTIONS AS STRONG YET
DELICATE AS PURE PULP PAPER
RESISTANT
Strong, even when wet.
PLEASANT SMELLING
Non-invasive smell, even when wet.
ABSORBENT
Outstanding absorbency.
AFFORDABLE
An ideal solution across the Away From Home sector.
SOFT
Pleasant to the touch.
DELICATE ON THE SKIN
Dermatologically tested.
AN INNOVATIVE “FIRST-HAND” RECYCLED PAPER
E-Tissue recycled paper is a unique product, created through an exclusive manufacturing process that reuses Kraft offcuts and pure pulp fibres that have been recovered from the converting line In a circular economy perspective, the productive cycle even incorporates manufacturing offcuts of E-Tissue itself.
RECOVERY OF PURE CELLULOSE FIBRES
THE E-TISSUE RECYCLING PROCESS CONVERTING

FLUTECH TECHNOLOGY RESULTS IN CLOG-FREE PIPES*
Thanks to Flutech technology, E-Tissue toilet paper dissolves in water within 15 seconds once flushed, avoiding frustrating blockages and plumbing costs.
*Flushability tests carried out as per Regulation AFNOR: NF Q 34-020:1998, in an external laboratory



15s PEFC/18-32-24 PEFCRecycled CRITERIA EU GPP CAM
E-TISSUE
LINE
PRE-CONSUMER

Combining quality, cost-effectiveness and the commitment of Industrie Celtex E-Tissue range strikes the perfect quality performance and environmental care that the Away doesn’t generate fibre waste by using giving new life to materials that would otherwise be thrown away .


* No optical brighteners are intentionally added during our production process. ** Compared to conventional methods employed by Industrie Celtex. -20%***
0 0 -75%** FIBRE WASTE GENERATED ADDED OPTICAL BRIGHTENERS* CO2 EMISSIONS WATER CONSUMPTION









“FIRST-GEN” RECYCLED PAPER VISIT US Booth 10.207 www.industrieceltex.com








VISIT FALPI 01.407








 Soluzioni d’igiene e di protezione professionale
Soluzioni d’igiene e di protezione professionale

Quine Srl
Via G. Spadolini, 7 - 20141 Milano www.quine.it | info@quine.it | Tel. 02 864105
Direttore Responsabile Giorgio Albonetti
Direttore editoriale
Ornella Zanetti | ornella.zanetti@quine.it
Direttore Tecnico Maurizio Pedrini
Coordinamento editoriale
Chiara Scelsi | c.scelsi@lswr.it | Tel. +39 349 0099322
Redazione
Cristina Cardinali | c.cardinali@lswr.it Tel. +39 347 4238879
Simone Ciapparelli | s.ciapparelli@lswr.it Tel. +39 344 0571950
Loredana Vitulano | l.vitulano@lswr.it Tel. +39 342 6618995
Consulenti tecnico scientifici per la sezione Igiene&Ambiente Chiara Dassi - Graziano Dassi
Ufficio traffico e Servizio abbonamenti
Ornella Foletti | o.foletti@lswr.it | Tel. +39 342 7968897
Direttore Commerciale
Costantino Cialfi - c.cialfi@lswr.it | Tel. +39 346 6705086
Pubblicità e Sviluppo: Filippo Viola | f.viola@lswr.it
Guido Rossi | g.rossi@lswr.it





Edoardo Rossi | e.rossi@lswr.it
Elena Brusadelli | e.brusadelli@lswr.it

Realizzazione grafica Paolo Marchetti




COLLABORATORS /









Produzione&Stampa Antonio Iovene | a.iovene@lswr.it | Tel. +39 349 1811231

Stampa CPM – Centro Poligrafico Milano S.p.A. – Casarile (MI)


Cristina Cardinali, Fabio Chiavieri, Simone Ciapparelli, Elena Consonni, Chiara Dassi, Graziano Dassi, Francesca De Vecchi, Francesco Gullo, David Migliori, Stefania Milanello, Maurizio Pedrini, Loredana Vitulano


Prezzi e abbonamenti
• Abbonamento annuale: 49 euro
• Annuale estero: 160 euro
• Copia arretrata: 17 euro
• Costo di una copia: 1.30 euro abbonamenti.quine@lswr.it | Tel. 02 864105 www.quine.it www.dimensionepulito.it

IN THE SPOTLIGHT IN PRIMO PIANO


Responsabilità

Dimensione Pulito periodico mensile registrato: autorizzazione del Tribunale di Milano N. 598 del 9.11.92 Quine è iscritta al Registro Operatori della Comunicazione n. 12191 del 29/10/2005.


La pubblicazione o ristampa di articoli e immagini della rivista deve essere autorizzata per iscritto dall’editore. Gli articoli pubblicati su Dimensione Pulito sono sotto la responsabilità degli autori. I manoscritti e i disegni pubblicati non saranno restituiti.
INFORMATIVA AI SENSI DEL GDPR 2016/679 Ai sensi dell'art. 13 Regolamento Europeo per la Protezione dei Dati Personali 679/2016 di seguito GDPR, i dati di tutti i lettori saranno trattati sia manualmente, sia con strumenti informatici e saranno utilizzati per l’invio di questa e di altre pubblicazioni e di materiale informativo e promozionale. Le modalità di trattamento saranno conformi a quanto previsto dagli art. 5-6-7 del GDPR. I dati potranno essere comunicati a soggetti con i quali Quine Srl intrattiene rapporti contrattuali necessari per l’invio delle copie della rivista. Il titolare del trattamento dei dati è Quine Srl, Via G. Spadolini 7 - 20141 Milano, al quale il lettore si potrà rivolgere per chiedere l’aggiornamento, l’integrazione, la cancellazione e ogni altra operazione di cui agli articoli 15-21 del GDPR.
© Quine srl – Milano





18 Made in Italy on the big stage at Interclean Il Made in Italy sul grande palcoscenico di Interclean Maurizio Pedrini
COVER IN COPERTINA




20 Cover’s trade marks Marchi di copertina Loredana Vitulano
32 Developing a European culture of industrial cleaning Sviluppare una cultura europea della pulizia industriale Maurizio Pedrini 18
Periodico mensile edito da
Distribuzione 1. Rivenditori
Imprese di servizi 3. Aziende alimentari 4. Sanità e RSA 5. Enti pubblici 6. Pubblici esercizi 7. Hotellerie 8. Lavanderie professionali 9. Disinfestazione e servizi ambientali 10. Grande distribuzione Quine srl Via G. Spadolini, 7 20141 Milano - Italia Tel. +39 02 864105 Fax. +39 02 70057190 LA GUIDA DA PORTARE SEMPRE CON SÉ PER CONOSCERE TUTTI TRUCCHI DEL MESTIERE LA DISTRIBUZIONE NEGLI IMPIANTI DI RISCALDAMENTO GUIDE dell’Installatore Professionale 7 YOUR INFORMATION
QUINE COLLABORA CON: www.quine.it Organo ufficiale AiCARR LA RIVISTA PER I PROFESSIONISTI DELL’HVAC&R Organo Ufficiale AiCARR TAVOLA ROTONDA Conto Termico TEE. che punto siamo? DALLA TEORICA ALLA PRATICA EPB, LE NOVITÀ DELLE NUOVE NORME IMPIANTI AD ARIA PRIMARIA VS VAV Analisi del processo case study FILTRAZIONE QUALITÀ DELL’ARIA ADIABATICO PER LA FRIGOCONSERVAZIONE ALIMENTARE #42 COMMISSIONING RISPARMIO ENERGETICO NEL TERZIARIO Organo ufficiale ANGAISA LA VOCE PIÙ AUTOREVOLE DEL SETTORE IDROTERMOSANITARIO #251 Bosch riparte da… Bosch CLASSIFICHE 2015 Produttori e distributori: ce la si può fare! FALANGA Quando la differenza bagno che calza pennello www.bluerosso.it LA VOCE AUTOREVOLE DEL CANALE IDROTERMOSANITARIO PIÙ DINAMICA LA PIATTAFORMA ITALIANA DELLA PRODUZIONE MUSICALE E DELL’AUDIO PROFESSIONALE www.audiofader.com WEBSITE AGGIORNATO QUOTIDIANAMENTE MAGAZINE MENSILE DIGITALE IVO GRASSO e MASSIVE ARTS Lo studio di modernoregistrazione SALVATORE ADDEO L’amore per l’SSL STRUMENTI AVID PRO TOOLS DOCK IL PUNTO DI RIFERIMENTO PER CHI OPERA NEL CAMPO DELLA PULIZIA INDUSTRIALE, SANIFICAZIONE E FACILITY MANAGEMENT www.pulizia-industriale.it DA 50 ANNI LA VOCE AUTOREVOLE DEL CLEANING www.casaeclima.com L’INFORMAZIONE EFFICIENTE, COMPLETA E IN TEMPO REALE OLTRE 200.000 UTENTI MESE Organo ufficiale FINCO LA RIVISTA CHE HA PORTATO LA PROGETTAZIONE SOSTENIBILE IN ITALIA SAIE INNOVATION 2016 A “IMPATTO ZERO” PCM Passo obbligato grande opportunità SPECIALE BIM A SCUOLA DI EFFICIENZA Per PENSARE, PROGETTARE COSTRUIRE SOSTENIBILE www.commercioelettrico.com Organo ufficiale FME IL BUSINESS MAGAZINE DEI DISTRIBUTORI E GROSSISTI DI MATERIALE ELETTRICO DAL 1952 IL PERIODICO D’INFORMAZIONE PER INGEGNERI E ARCHITETTI NEWSLETTER – L’AGGIORNAMENTO PROFESSIONALE VIA MAIL Ogni 15 giorni raggiunge oltre 42.000 iscritti R FOCUS SPECIALE crisi ancora “morde”, contesto politico barcolla, alta l’attenzione sul governo degli ingegneri e cambiamento Un CNI eletto per dare risposte In USA volano le infrastrutture Eucentre per ricostruire la sicurezza Ancora trattative consultazioni? I pareri degli Ordini dopo l’esito del referendum del dicembre Newsletter Programma Corsi di Aggiornamento Professionale QUOTA RINNOVABILI EDIFICI obblighi e proroghe SCIA, operativo il modello unico Tutti rinvii SPECIALE MILLEPROROGHE Top infrastrutturemegadel 2016 LA RIVISTA PER PROGETTARE LA SMART INDUSTRY Organo ufficiale Confapi INFORMAZIONE TECNICO SCIENTIFICA PER LE PMI www.rivistainnovare.it –------d u o---www.ammonitore.com MENSILE DI FORMAZIONE E AGGIORNAMENTO PER IL MECCATRONICO www.MTEDocs.it INFORMAZIONE TECNICHE PER L’AUTORIPARAZIONE MECCANICA&AUTOMAZIONE PERIODICO BUSINESS TO BUSINESS NEL MONDO DELL’INDUSTRIA MECCANICA E DELLE MACCHINE UTENSILI per settore Lamiera IN QUESTO NUMERO Gianfranco Carbonato, www.meccanica-automazione.com IL PORTALE CHE TI GUIDA VERSO LA SMART INDUSTRY TUTTI VOLTI E LE AZIENDE DELLA MECCATRONICA www.terminidellameccanica.com IL TRADUTTORE MULTILINGUE DELLA MECCATRONICA URBAN & PARTNER MILANO (I) WRODAW (PL) GALLARATE (I) PIACENZA (I) TIRANA (AL) SARAGOZZA (ES) MILANO (I) Quine srl Via G. Spadolini, 7 20141 Milano - Italia Tel. +39 02 864105 Fax. +39 02 70057190 YOUR INFORMATION PARTNER QUINE COLLABORA CON: www.quine.it Organo ufficiale ANGAISA LA VOCE PIÙ AUTOREVOLE DEL SETTORE IDROTERMOSANITARIO #251 BOSELLI Bosch riparte CLASSIFICHE 2015 Produttori e distributori: ce la si può fare! ANTONIO DISTRIBUZIONE bagno che FOCUS Un anno logistica CONNECTION www.bluerosso.it LA VOCE AUTOREVOLE DEL CANALE IDROTERMOSANITARIO PIÙ DINAMICA LA PIATTAFORMA ITALIANA DELLA PRODUZIONE MUSICALE E DELL’AUDIO PROFESSIONALE www.audiofader.com WEBSITE AGGIORNATO QUOTIDIANAMENTE MAGAZINE MENSILE DIGITALE IVO GRASSO e MASSIVE ARTS Lo studio di modernoregistrazione SALVATORE ADDEO L’amore per l’SSL principi programmazione AVID PRO TOOLS DOCK IL PUNTO DI RIFERIMENTO PER CHI OPERA NEL CAMPO DELLA PULIZIA INDUSTRIALE, SANIFICAZIONE E FACILITY MANAGEMENT www.pulizia-industriale.it DA 50 ANNI LA VOCE AUTOREVOLE DEL CLEANING www.casaeclima.com L’INFORMAZIONE EFFICIENTE, COMPLETA E IN TEMPO REALE OLTRE 200.000 UTENTI MESE Organo ufficiale FINCO LA RIVISTA CHE HA PORTATO LA PROGETTAZIONE SOSTENIBILE IN ITALIA UNA SCELTA A SCUOLA DI EFFICIENZA Per PENSARE, PROGETTARE COSTRUIRE SOSTENIBILE www.commercioelettrico.com Organo ufficiale FME IL BUSINESS MAGAZINE DEI DISTRIBUTORI E GROSSISTI DI MATERIALE ELETTRICO PERIODICO D’INFORMAZIONE E ARCHITETTI L’AGGIORNAMENTO PROFESSIONALE VIA MAIL raggiunge oltre 42.000 iscritti FOCUS eletto per dare risposte USA volano le infrastrutture per ricostruire la sicurezza trattative consultazioni? Newsletter RINNOVABILI EDIFICI proroghe modellooperativo unico Tutti rinvii SPECIALE MILLEPROROGHE Top infrastrutturemegadel 2016 LA RIVISTA PER PROGETTARE LA SMART INDUSTRY Organo ufficiale Confapi INFORMAZIONE TECNICO SCIENTIFICA PER LE PMI www.rivistainnovare.it MENSILE PER LA SUBFORNITURA E LA PRODUZIONE INDUSTRIALE –----------–-----p d---www.ammonitore.com MENSILE DI FORMAZIONE E AGGIORNAMENTO PER IL MECCATRONICO www.MTEDocs.it INFORMAZIONE TECNICHE PER L’AUTORIPARAZIONE MECCANICA&AUTOMAZIONE PERIODICO BUSINESS TO BUSINESS NEL MONDO DELL’INDUSTRIA MECCANICA E DELLE MACCHINE UTENSILI #4maggio 2016 STORIA DI COPERTINA IN QUESTO NUMERO Generative design, come cambierà mondo Sempre più al centro www.meccanica-automazione.com IL PORTALE CHE TI GUIDA VERSO LA SMART INDUSTRY TUTTI VOLTI E LE AZIENDE DELLA MECCATRONICA URBAN & PARTNER MILANO (I) WRODAW (PL) GALLARATE (I) PIACENZA (I) TIRANA (AL)
Testata Associata
2.
PARTNER
CONTENTS/SOMMARIO
HANNO COLLABORATO
ANNO 33 N.4 MAGGIO 2024
EUROPEAN OBSERVATORY OSSERVATORIO EUROPEO
32 129


Solutions for professional cleaning Soluzioni per la pulizia professionale COMAC S.p.A. Via Maestri del Lavoro, 13 - 37059 Santa Maria di Zevio - Verona - ITALY Tel. 045 8774222 - www.comac.it - com@comac.it Comac S.p.A. org. cert. ISO 9001:2015, ISO 14001:2015, ISO 45001:2018, SA 8000:2014 Meet us at Interclean Amsterdam Booth 01.421A Vediamoci a Interclean Amsterdam Stand 01.421A Download the catalogue Scarica il catalogo
FACILITY MANAGEMENT
FACILITY MANAGEMENT
42 Priorities for a competitive, sustainable and efficient industry
Da EFCI le priorità per un’industria competitiva, sostenibile ed efficiente
Maurizio Pedrini
MADE IN ITALY MADE IN ITALY
50 Italian Golden Suppliers
Italian Golden Suppliers Maurizio Pedrini
SERVICE INDUSTRY
SERVIZI
62 New procurement code and minimum wage
Nuovo codice degli appalti e salario minimo
Maurizio Pedrini
REGULATION NORMATIVA
72 Corporate sustainability reporting
Reporting di sostenibilità aziendale
Cristina Cardinali
OVERSEAS COLLABORATION COLLABORAZIONE OLTREOCEANO
82 Cleaning as a science
La scienza del pulito
Cristina Cardinali
DETERGENT MARKET MERCATO DELLA DETERGENZA
90 Service, a winning weapon
L’arma vincente è il servizio



42 62 72
CONTENTS/SOMMARIO






SAFETY Visit us at INTERCLEAN Amsterdam Netherlands - RAI Amsterdam 14/17 May 2024 Hall 1 Booth 01.421B
CONTENTS/SOMMARIO
Data processing Cerved Marketing Intelligence edited by David Migliori
102 The challenge of ecological transition
La sfida della transizione ecologica edited by Cristina Cardinali
CLEANING COMPANIES
IMPRESE DI PULIZIA
106 Cleaning and sanitation in the workplace
Pulizia e sanificazione nei luoghi di lavoro edited by Cristina Cardinali
EVENTS
EVENTI
116 Planetary Health Festival 2024
Planetary Health Festival 2024 Fabio Chiavieri
ON THE MARKET TODAY
124 Technology, research, development: the latest news from the cleaning world edited by Loredana Vitulano



102 106 116

INDEX OF ADVERTISERS/INDICE INSERZIONISTI
4CleanPro 20, 28, 29, 30, 31
Adiatek 20, 54, 55
Allegrini 16, 20
Arexons/Fulcron
20, S 26, S 27, S 28, S 29
Basf S 59
Comac 12, 21
Convegno CleaningPiù S 60
Copyr S 47
Christeyns 21, 97
Dulevo 21, 49, 57
Ekommerce S 54, S 55
Essecinque 21, 65
Falpi 6, 22
Fimap 14, 22
Filmop 85
Ghibli & Wirbel 40, 41
Hygenia 22, 114, 115 Ica 22, 60, 61
Igeax 23, S 3
Indupharma 23, 110, 111
Industrie Celtex 23, C/Battente I
Copertina, II Copertina, 5
Industrie Celtex/Infibra 23 Italchimica 95
Kairosafe S II Copertina Kroll 24, 88, 89
L.R. Flavours 17
Lindhaus 7
Lucart 24, III
Copertina, IV Copertina, C/Battente IV
Copertina
MarPlast 24, 67 MK 24
MP-HT
UNFORGETTABLE
Fragrances
Produttori di Fragranze e Aromi, dal 1998. La fragranza è più di un profumo. È personalità, stile ed eleganza, un’esperienza che ti accompagna nel tempo, lasciando un’impressione duratura.
L.R. Industries crea la tua firma olfattiva distintiva, che trasformerà i tuoi prodotti in esperienze indimenticabili.
L.R. FLAVOURS & FRAGRANCES INDUSTRIES S.p.A. info@lrindustries.it | lrindustries.it
25, 47, S 4, S 5
Nettuno 93
Newpharm S 42, S 43
Orma 25, 104, 105
Paperdì 10, 25
Papernet/Sofidel 25, 122, 123
Paredes 9, 26
Polychim 26, 100, 101
RCM 8, 26
RG Strumenti 26, S 14, S 15
Rosiwit 27, 35
Rubino Chem 27, S I Copertina STI Industry 109
Synclean 78, 79, 80, 81
Tenax 37
TTS 70, 71
Vebi S 49

IN THE SPOTLIGHT
Made in Italy on the big stage at Interclean
The history of Interclean, which at the RAI in Amsterdam from Tuesday, May 14 to Friday, May 17, 2024, will focus the world's attention on professional cleaning is closely intertwined with the birth and development of hygiene technology production branded Made in Italy.
The affirmation of the great Dutch key exhibition show on the international scene owes much, in fact, to our manufacturers, who have always been a "flagship" of it by believing in and investing in this fair to showcase, lend luster and visibility to their achievements.
 Pedrini Direttore Tecnico Dimensione Pulito
Pedrini Direttore Tecnico Dimensione Pulito
Machines, equipment and cleaning products that are the result, not only of their constant commitment and sacrifice, but above all of the design and creativity - all Italian - that distinguish their recognized appeal. A particularly rich and varied product offering, capable of withstanding the increasingly fierce competition on the global market.
Remained always competitive thanks to the constant search for new, innovative technological solutions increasingly oriented to green and environmental sustainability.
We are therefore proud of the announcement, made by AFIDAMP that at the 2024 edition, Italy will be the first state at the fair, both in terms of the number of exhibiting companies - as many as 144 - and the number of square meters occupied: about 9,000. The only association representing Italian manufacturers and distributors, this year has also decided to make an extraordinary effort to give great visibility to our companies, promoting the excellence of Made in Italy. In fact, the Italian Golden Suppliers formula will accompany visitors from the entrance to the fair to the stands, with the contribution of informative materials and specially dedicated floor plans.
A brief historical excursus follows to show how deep is the relationship between Interclean, manufacturers and the Italian professional cleaning market.
As early as 1967, the year the event was founded, Giulio
Guizzi-now AFIDAMP Ambassador-president of Pulindustria in Italy and Cimex distributor, was present at the Cimex International booth to receive the first Italians who timidly appeared at the great exhibition kermesse. When the Guizzi brothers later became manufacturers with the Pulex company, in 1980, Giulio and Alfredo, arrived (after a long and adventurous journey) in Amsterdam with their Fiat Ducato loaded with prototypes for display, finding comforting interest from visitors.
The first organized presence of Italian manufacturers in the land of tulips, however, dates back to 1985, thanks to the farsighted intuition of then AFIDAMP secretary Alfredo Pellizzari, who had for the first time the institutional support of Agenzia ICE, Istituto Commercio Estero, whose top management was convinced of the goodness of the initiative-as well as by Giulio Guizzi and Alfredo Pellizzari-also by then AFIDAMP president Renato Prestero. The participation of Italian companies was immediately a success, in terms of the size, mode and quality of the stands. Thus, the foundations were laid for a presence that, over the course of the following editions, became better and better configured, not only through the exhibitors, but also with groups of cleaning contractors, associations and individual users, thanks to the undoubted tourist attraction exerted by the city of Amsterdam.
Then, in 2018, the sudden separation of what until then had been a consolidated duo, almost to the point of appearing stainless: that is, the alliance between ISSA and Interclean. The "consensual divorce" between the two global trade fair giants opened up - in fact - the prospect and opportunity for American distributors and manufacturers to also be present in Europe with our ISSA Pulire, brought to Milan in 2023.
We are therefore certain that, continuing a successful tradition, this year too Made in Italy will be the absolute protagonist on the great stage of Interclean.
Maurizio
18 DIMENSIONE PULITO | 04/2024
IL MADE IN ITALY SUL GRANDE PALCOSCENICO
DI INTERCLEAN
La storia di Interclean, che al RAI di Amsterdam da martedì 14 a venerdì 17 maggio 2024, focalizzerà l’attenzione mondiale del professional cleaning si intreccia strettamente con la nascita e lo sviluppo della produzione di tecnologie per l’igiene marchiata Made in Italy.
L’affermazione del grande Salone espositivo olandese in chiave sulla scena internazionale deve molto, infatti, ai nostri fabbricanti, che ne sono stati sempre un “fiore all’occhiello” credendo e investendo su questa fiera per mettere in mostra, dar lustro e visibilità alle loro realizzazioni. Macchine, attrezzature e prodotti per la pulizia frutto, non solo del loro costante impegno e sacrificio, ma soprattutto del design e della creatività – tutta italiana – che ne contraddistinguono il riconosciuto appeal. Un’offerta merceologica particolarmente ricca e variegata, capace di reggere la sempre più agguerrita concorrenza sul mercato globale. Rimasta sempre competitiva grazie alla costante ricerca di nuove, innovative soluzioni tecnologiche sempre più orientate al green e alla sostenibilità ambientale.
Siamo quindi orgogliosi dell’annuncio, fatto da AFIDAMP che all’edizione 2024 l’Italia sarà il primo Stato in fiera, sia per numero di aziende espositrici – ben 144 – sia per numero di metri
quadrati occupati: circa 9.000 mq. L’unica associazione che rappresenta i produttori e i distributori italiani, quest’anno ha inoltre deciso di compiere uno sforzo di straordinaria portata per dare grande visibilità alle nostre aziende, promuovendo l’eccellenza del Made in Italy. La formula Italian Golden Suppliers accompagnerà infatti il visitatore dall’ingresso in fiera fino agli stand, con l’apporto di materiali informativi e piantine appositamente dedicate. Segue un breve excursus storico per dimostrare quanto profondo sia il rapporto tra Interclean, i produttori e il mercato italiano della pulizia professionale. Già nel 1967, anno di fondazione della manifestazione, Giulio Guizzi – oggi AFIDAMP Ambassador – presidente di Pulindustria in Italia e distributore Cimex, era presente nello stand Cimex International per ricevere i primi italiani che si affacciavano timidamente alla grande kermesse espositiva. Quando poi i fratelli Guizzi divennero fabbricanti con l’azienda Pulex, nel 1980, Giulio ed Alfredo, giunsero (dopo un lungo e avventuroso viaggio) ad Amsterdam con il loro Ducato Fiat carico di prototipi da esporre, riscontrando un confortante interesse da parte dei visitatori. La prima presenza organizzata dei fabbricanti italiani nella terra dei tulipani risale però al 1985, grazie alla lungimirante intuizione dell’al-
lora segretario di AFIDAMP Alfredo Pellizzari, che ebbe per la prima volta il sostegno istituzionale di Agenzia ICE, Istituto Commercio Estero, i cui vertici furono convinti della bontà dell’iniziativa- oltre che da Giulio Guizzi e Alfredo Pellizzari- anche dall’allora presidente di AFIDAMP Renato Prestero. La partecipazione delle aziende italiane fu subito un successo, per entità, modalità e qualità degli stand. Furono gettate così le basi per una presenza che, nel corso delle successive edizioni, andò sempre meglio configurandosi, non solo attraverso gli espositori, ma anche con gruppi di impresari di pulizia, associazioni e singoli utenti, complice l’indubbia attrazione turistica esercitata dalla città di Amsterdam.
Poi, nel 2018, la separazione improvvisa di quello che fino ad allora era stato un binomio consolidato, fin quasi ad apparire inossidabile: ovvero, l’alleanza tra ISSA e Interclean. Il “divorzio consensuale” tra i due colossi fieristici mondiali apriva – di fatto -la prospettiva e l’opportunità per i distributori e i fabbricanti americani di essere presenti in Europa anche con la nostra ISSA Pulire, portata a Milano nel 2023. Siamo dunque certi che, proseguendo una fortunata tradizione, anche quest’anno il Made in Italy sarà protagonista assoluto sul grande palcoscenico di Interclean.

19 DIMENSIONE PULITO | 04/2024

4 CleanPro Srl
Via dei Tigli 20
50013 Firenze
Tel.: +39 055 898139
www.4cleanpro.com
4CleanPro is a company that has been operating in the market for over twenty years. Its machinery is appreciated mainly for the construction and quality of the components. The stainless steel frames make the machines extremely resistant The company organization is structured to guarantee professionalism and speed of response to any request.
4CleanPro è un azienda che opera nel mercato da oltre vent’anni. I suoi macchinari sono apprezzati principalmente per la costruzione e la qualità dei componenti. I telai in acciaio inox rendono le macchine estremamente resistenti ed efficienti. L’organizzazione aziendale è strutturata con l’obiettivo di mantenere rapporti solidi nel tempo e garantisce professionalità e velocità di risposta a qualsiasi richiesta.
BEST SELLER

FEATURES
Product name: Mira Ergo 40 Plus: New Design in the upper part, lighter and easier to drive with a quick-release tank.

Adiatek Srl
Via Monte Pastello 14
37057 S. Giovanni Lupatoto (VR)
Tel.: +39 045 8779086 www.adiatek.com
Adiatek is an Italian floor cleaning machines brand, with a range of both walk-behind and ride-on machines that stand out for their design and engineering. Adiatek models differ for dimension, brushes type (round, cylindrical and pads), work system (scrubbers and sweepers) and power supply (battery or electric plug). The working widths go from 35 to 130 cm.
Adiatek è un’azienda italiana che produce lavasciuga pavimenti industriali, con operatore a terra e a bordo, che si distinguono per il design e la tecnica applicata. Produce modelli diversi per dimensioni, tipologia di spazzole (circolari, cilindriche o orbitali) sistema di lavoro (lavante o lavante/ spazzante) e alimentazione (elettrica o batteria). Le larghezze di lavoro vanno da 35 a 130 cm.

FEATURES
Product name:
R-QUARTZ 70 autonomous scrubber dryer
Plus: Powered by lithium batteries, 7”touch screen display, up to 6 hours of autonomy, travel speed up to 4.5 km/h.

Allegrini Spa
Vicolo Carlo Allegrini 24050 Grassobbio (BG) Tel.:+39 035 424 2111 www.allegrini.com
Founded in 1945, Allegrini is now a leading company in Italy in the production of professional detergents for all areas and targets that require cleaning, hygiene and disinfection: among these, the hospitality sector, that includes accommodation structures, hospitals and residence structures, commercial and communal caterings, cleaning companies and commercial areas.
Fondata nel 1945, Allegrini è oggi un’azienda leader in Italia nella produzione di detergenti professionali per tutti gli ambiti e i target che richiedano pulizia, igiene e disinfezione: tra questi, il settore dell’ospitalità che comprende le strutture ricettive, ospedaliere e residenziali, la ristorazione commerciale e collettiva, le imprese di pulizia e gli spazi commerciali.
BEST SELLER

FEATURES
Product name: Ecolabel Stovilmatic
Plus: Ecolabel-certified liquid detergent with high degreasing power for professional dishwashers. Formulated without phosphates, EDTA and NTA.

Arexons Spa
Via Strada Antica di Cassano 23
20063 Cernusco S. N. (MI) Tel.: +39 02 924361 www.fulcron.it
Fulcron, a brand owned by the italian company Arexons and appreciated for over 30 years for the iconic Concentrated Degreaser, offers a complete range to satisfy all professional cleaning needs. The range includes over 60 products such as dishwasher detergents, floor cleaners, disinfectants, degreasers, specific cleaners and hand cleaners.
Fulcron, è il brand di Arexons, azienda italiana che da 100 anni produce prodotti per l’auto, l’industria, la casa e il fai da te. Fulcron, apprezzato da oltre 30 anni per lo Sgrassatore Concentrato, offre una gamma prestazionale per soddisfare le esigenze di pulizia professionale. La gamma conta oltre 60 prodotti tra Detergenti Lavastoviglie, Lavapavimenti, Disinfettanti, Sgrassatori, Pulitori Specifici e Lavamani.
BEST SELLER
FEATURES
Product name:

Fulcron Super degreasing Food Grade
Plus: NSF A1 registered, designed for the food sector. 99% biodegradable formula, without residue. Suitable for HACCP plan use.
20 DIMENSIONE PULITO | 04/2024 COVER’S TRADE MARKS
BEST SELLER

Christeyns Italia Srl
Via Aldo Moro 30 20060 Pessano con Bornago (MI) Tel.: +39 0299 765200 www.christeyns.com
Christeyns stands for premium chemicals, reliable equipment and flexible, customized service. Its portfolio includes hygiene solutions for professional textile care, food processing & retail, the professional cleaning industry and the medical and life sciences sectors. Christeyns is a big international player, able to really understand client’s needs and expectations.
Christeyns significa prodotti chimici di alta qualità, attrezzature affidabili e servizio flessibile e su misura. Il portfolio comprende soluzioni per pulizia professionale dei tessuti, industria alimentare, food retail, pulizia professionale, settore medico e Life Sciences. Da sempre attenta alle esigenze locali, Christeyns può soddisfare ogni esigenza e aspettativa da parte del cliente.
BEST SELLER

FEATURES
Product name:
Duo Solid System
Plus: The Duo Solid concept combines a solid detergent and a solid rinse aid in one dosing unit. This 2-in-1 dosing system is a unique concept for automatic dishwashing.

Comac Spa
Via Maestri del Lavoro 13 37059 Santa Maria di Zevio (VR) Tel.: +39 045 8774222 www.comac.it
For 50 years, Comac has been designing and producing machines for professional floor cleaning, including floor scrubbers, sweepers, single disc machines, vacuum cleaners, sanitizers, and high pressure washers able to solve cleaning problems in different conditions of use and on any type of surface. One of Comac’s main qualities is the capacity to innovate and rejuvenate itself.
Da 50 anni Comac progetta e produce macchine per la pulizia professionale dei pavimenti, tra cui lavasciuga pavimenti, spazzatrici, monospazzole, aspiratori, sanificatori e idropulitrici, capaci di soddisfare ogni esigenza di pulizia in diverse condizioni di uso e su ogni tipo di superficie. Comac sa distinguersi per la sua capacità di innovare e rinnovarsi sul mercato della pulizia professionale.
BESTSELLER

FEATURES
Product name: C120
Plus: Performing industrial ride on floor scrubber, designed to ensure excellent performance during all maintenance and deep cleaning activities.

Dulevo International Spa Via G. Guareschi 1 43012 Fontanellato (PR) Tel.: +39 0521 827711 www.dulevo.com
Dulevo was founded in 1976 in the heart of Italy’s Motor Valley and is now part of the Fayat Group, France’s largest privately-owned construction, industrial and road infrastructure group. The slogan, ‘Timeless Quality through Passion’, reflects Dulevo’s commitment to providing innovative, high quality cleaning solutions to municipalities and industry, with a focus on environmental care.
Dulevo è stata fondata nel 1976 nel cuore della Motor Valley italiana e oggi fa parte del Gruppo Fayat, il più grande gruppo privato francese nel settore delle costruzioni, dell’industria e delle infrastrutture stradali. Lo slogan, “Qualità senza tempo attraverso la passione”, riflette l’impegno di Dulevo nel fornire soluzioni di pulizia innovative e di alta qualità alle municipalità e all’industria, con un’attenzione particolare all’ambiente.
BEST SELLER

FEATURES
Product name: Dulevo D.Zero2
Plus: Eco-friendly technology, huge performance and quietness: perfect to meet the needs of towns and large enterprises.

Essecinque Srl Via Biancon 10/12
35010 Villa del Conte (PD) Tel. + 39 049.9390114
www.essecinque.net
Essecinque is a company that was founded in 2005 thanks to a simple idea of the founders: transferring the experience in the field of textiles and clothing to the field of professional cleaning products. In the catalog: Mops, flat mops (hook and loop fastening system, pockets or flaps), cloths, handles, trolleys, windows equipment
Essecinque è un’azienda nata nel 2005 grazie a una semplice idea dei fondatori: trasferire l’esperienza maturata nel campo del tessile/ abbigliamento al settore dei prodotti per la pulizia professionale. Produce gli articoli in cotone e nelle altre fibre tessili, lavorate utilizzando il più innovativo know-how. In catalogo: Mop, flat mop (con sistema a strappo, tasche o alette), panni, manici, carrelli, attrezzature per i vetri.
BEST SELLER

FEATURES
Product name: MICROFAST
Plus: This flat mop allows a complete wet cleaning thanks to the interweaving between microfiber and cotton. Hook and loop fastening system. Different sizes available.
21 DIMENSIONE PULITO | 04/2024 MARCHI DI COPERTINA

Falpi Srl
Frazione Ponzone 120 13835 Valdilana (BI) Tel.: + 39 015 7387777 www.falpi.com
Falpi has clear ideas: to bring the dynamism and desire to innovate of a young and motivated team to the world of professional cleaning equipment, always faithful to the quality of “Made in Italy” and environmental sustainability. Falpi products are designed for cleaning companies, hospitals, communities, hotels and are made with recyclable materials.
Falpi ha le idee chiare: portare il dinamismo e la voglia di innovare di un team giovane e motivato nel mondo delle attrezzature per la pulizia professionale, sempre fedele alla qualità del “Made in Italy” e alla sostenibilità ambientale. I prodotti Falpi sono pensati per imprese di pulizie, ospedali, aziende, comunità, hotel e sono realizzati con materiali riciclabili.
BEST SELLER

FEATURES
Product name:
Kubi Ecolabel
Plus: The Kubi trolley obtained both the EU Ecolabel certification and the ‘EU Ecolabel Award 2021’.
Fimap Spa
Via Invalidi del Lavoro 1 37059 S. Maria di Zevio (VR) Tel.: +39 045 6060411 www.fimap.com
Fimap is a leading domestic and international company in the production of professional cleaning equipment. Fimap designs its products in an innovative way so as to provide a customized service and guaranteed results.

Hygenia Srl
Via Latina 20 00179 Roma (RM) Tel.: +39 06 83512183 www.hygenia.it
Hygenia is a constantly evolving, reactive company, ready to take care of the hygiene of the environment and the quality of people’s lives. It is always guided in its engi- neering activities by the search for quality and design. New divisions have been added over the years to offer products and services increasingly focused on the evolution of customer needs.
Fimap è azienda leader a livello nazionale e internazionale nella produzione di macchine professionali per la pulizia. Partendo da un’attenta analisi delle richieste specifiche dei clienti, Fimap concepisce i propri prodotti in modo innovativo riuscendo a offrire un servizio personalizzato e garanzia dei risultati.
BEST SELLER

FEATURES
Product name: CB-1 autonomous floor scrubber
Plus: A collaborative robot which allows personnel to have more time for more demanding and skilled jobs, increasing productivity.
Hygenia è una realtà in continua evoluzione, reattiva, pronta a prendersi cura dell’igiene degli ambienti e della qualità della vita delle persone, sempre guidata nella sua attività di engineering dalla ricerca di qualità e design. Nuove divisioni si sono aggiunte negli anni per offrire prodotti e servizi sempre più focalizzati sull’evoluzione dei bisogni della clientela.
BEST SELLER

FEATURES
Product name: HY-WELL
Plus: The new dosing systems dilute automatically and accurately the right dose of water and chimical detergent to obtain an efficient product with less wastage.

ICA Srl via Monviso, 31 12040 Corneliano d’Alba (CN) Tel.: +39 0173610250 www.icatissue.com
Operating on the national and international market for 40 years, ICA is a paper converting company specialized in Away-from-Home products and is committed to expanding its wide range of products in a perspective of constant innovation and focus on the environment to offer products that are performing, hygienic and sustainable.
Presente da 40 anni sul mercato nazionale e internazionale, ICA è un’azienda di trasformazione carta tissue, specializzata nella produzione di prodotti Away-from- Home. L'impegno dell'azienda è rivolto al costante ampliamento della gamma prodotti in un’ottica di continua innovazione e di attenzione per l’ambiente per offrire prodotti sempre più performanti, igienici e sostenibili.
BEST SELLER

FEATURES
Product name: Compact towel
Plus: It’s soft, absorbent and pratical with its 5x5 cm folds that make it the narrowest in its class and is the ideal solution for small spaces.
22 DIMENSIONE PULITO | 04/2024 COVER’S TRADE MARKS

IGEAX Srl
Via delle Querce 16 Z.I. Fenilrosso 46019, Viadana (MN) Tel. +39 0375 780798 www.igeax.com
IGEAX is the ideal partner for every cleaning need: solutions offered include everything from the Hygiene and Detectabile lines for the food sector to the Industrial line designed for commercial activities, through the Aricasa line intended for GDS and domestic use. The wide variety of items made in Italy allows you to get the most with the minimum effort.
IGEAX è il partner ideale per ogni esigenza di pulito: le soluzioni offerte spaziano dalle linee Hygiene e Detectabile per il settore alimentare alla linea Industrial per le attività commerciali, passando per i prodotti della linea Aricasa destinati alla GDS e all’utilizzo domestico. Gli innumerevoli articoli realizzati in Italia con materie prime di alta qualità permettono di ottenere il massimo con il minimo sforzo.
BEST SELLER

FEATURES
Product name: Brushes resistant to high temperatures Plus: Resistant up to 200°C, they effectively remove residues from hobs, grills, pans and hot surfaces in general.
Indupharma Srl Via Sorgaglia 40 35020 Arre (PD) Tel.: +39 049 8076144 www.indupharma.eu
Mr Shield PRO TECH is the line of cleaning, sanitizing, disinfecting and pest control products aimed at professional, industrial and Ho.Re.Ca. cleaning specialists looking for high-quality results. It comes from listening to users’ needs and draws on Indupharma’s manufacturing expertise to simplify daily work by solving specific problems.
Mr Shield PRO TECH è la linea di detergenti, igienizzanti, disinfettanti e disinfestanti che si rivolge agli specialisti delle pulizie professionali, industriali e Ho.Re.Ca. che cercano risultati di alta qualità. La gamma nasce dall’ascolto delle necessità degli utilizzatori e si avvale della competenza produttiva di Indupharma per semplificare il lavoro quotidiano risolvendo problematiche specifiche.
BEST SELLER

FEATURES
Product name: Strong Interior and Exterior Cleaner Plus: Concentrated detergent for all types of dirt. Use by hand or in a washer-dryer, without rinsing. HACCP-compliant.

Industrie Celtex Spa Via Trav. del Marginone 21/23 55015 Montecarlo (LU) Tel.: +39 0583 2741 www.industrieceltex.com
Industrie Celtex is a company specialised in the production of tissue, non-woven products and dispensing systems for the AFH market. A multinational company with 8 plants all over Europe and more than 500 employees, that adopts a sustainable vision throughout the entire production chain, ensuring quality and high-performance products while pursuing a reduced environmental impact.
Industrie Celtex è un’azienda specializzata nella produzione di referenze a uso igienico-sanitario in carta tissue, tessuto non tessuto e sistemi di dispensazione per il settore dell’AFH. Una multinazionale con 8 stabilimenti in tutta Europa e oltre 500 dipendenti, che in tutta la filiera produttiva adotta una visione sostenibile, garantendo qualità ed elevate performance dei prodotti.
BEST SELLER

FEATURES
Product name: Megamini E-Control Hands Towel Plus: No-touch dispensing system that delivers paper towels with the passage of the hand. The “stub roll” mechanism ensures constant supply.

Industrie Celtex Spa Via Trav. del Marginone 21/23
55015 Montecarlo (LU) Tel.: +39 0583 2741 www.industrieceltex.com
Industrie Celtex is a company specialised in the production of tissue, non-woven products and dispensing systems for the AFH market. A multinational company with 8 plants all over Europe and more than 500 employees, that adopts a sustainable vision throughout the entire production chain, ensuring quality and high-performance products while pursuing a reduced environmental impact.
Industrie Celtex è un’azienda specializzata nella produzione di referenze a uso igienico-sanitario in carta tissue, tessuto non tessuto e sistemi di dispensazione per il settore dell’AFH. Una multinazionale con 8 stabilimenti in tutta Europa e oltre 500 dipendenti, che in tutta la filiera produttiva adotta una visione sostenibile, garantendo qualità ed elevate performance dei prodotti.
BEST SELLER

FEATURES
Product name: Infibra Venus Plus: Venus is the range of fabric-effect quality table coordinates made from biodegradable and compostable airlaid. Napkins and table covers in vibrant colours.
23 DIMENSIONE PULITO | 04/2024 MARCHI DI COPERTINA

KROLL Srl
Via Luigi Mazzon 21
30020 Quarto d’Altino (VE)
Tel.: +39 0422 823794 www.kroll-amkro.com
Tradition and innovation at the service of daily hygiene with the maximum respect for the environment. Kroll has been operating in the cosmetics sector for more than 40 years producing Professional Hand Cleansing products, Liquid Soaps and Foam and Body Cleansers. Certified company 9001-14001, EMAS, products certified Ecolabel.
Tradizione e innovazione al servizio dell’igiene quotidiana nel massimo rispetto ambientale, questo è nel DNA di Kroll, azienda che da più di 40 anni opera nel settore della cosmetica ed in particolare nei prodotti Lavamani Professionali, Saponi Liquidi e Foam, Detergenti per il Corpo e Creme protettive per Mani. Azienda certificata 9001 –14001, EMAS, prodotti certificati Ecolabel IT 030/001.
BEST SELLER

FEATURES
Product name: Ecolabel Line IT/030/001
Plus: The first certified cosmetics line for hand and body hygiene. The complete line of liquid and foam detergents for the Ho.Re.Ca.
Lucart Spa
Zona Industriale
55023 Diecimo (LU) Tel.: +39 0583 83701 www.lucartprofessional.com
Lucart Professional is the reference brand for the Away From Home market of Lucart, a multinational Italian industrial group founded in 1953. Lucart Professional is able to bring concrete and tangible sustainability to the Away from Home sector, offering operators in the sector innovative solutions for hygiene away from home, ranging from tissue products to dispensing systems to soaps.
Lucart Professional è il marchio di riferimento per il mercato Away From Home di Lucart, gruppo industriale italiano di respiro multinazionale nato nel 1953. Lucart Professional è in grado di portare la sostenibilità concreta e tangibile nel settore Away from Home, proponendo agli operatori del settore soluzioni innovative per l’igiene fuori casa, che spaziano dai prodotti in carta tissue, ai sistemi di dispensazione fino ai saponi.
BEST SELLER

FEATURES
Product name: ECONATURAL FLOW
Plus: FLOW is the new range of dispensers with an exclusive patented design, made from recycled beverage cartons.

Mar Plast Spa
Via A. De Gasperi, 7 42010 Rio Saliceto (RE)
Tel.: +39 0522 699 200 www.marplast.it
Mar Plast represents a leader company in the sector of bathroom accessories for public environments, offering a wide range of products for comfort and functionality. All stages, from design to production, are managed internally, ensuring total control and quality for a Made in Italy exported to over 45 countries around the world.
Mar Plast nasce nel 1968 e da oltre 50 anni l’azienda rappresenta un punto di riferimento nel settore degli accessori bagno per ambienti pubblici, offrendo una vasta gamma di prodotti per comfort e funzionalità. Tutte le fasi, dal design alla produzione, sono gestite internamente, garantendo controllo e qualità totali per un Made in Italy esportato in oltre 45 paesi al mondo.
BEST SELLER

FEATURES
Product name: art. 924
Plus: Refilling soap dispenser with photocell activation, it ensures maximum hygiene and prevents product wastes.

MK Spa
Via Ciro Menotti, 77 20017 Rho (MI)
Tel.: +39 02 93504187 www.mkspa.com
MK is an Italian company dedicated to developing innovative formulas that can make the places where we live cleaner, safer and more pleasant. Marka, brand of MK spa, has created Sistema Detergenza, Sistema Igiene e Sistema Ambiente: three ranges with products designed and formulated for guaranteeing Professional Deep Protection in all environments and contexts.
MK è un’azienda italiana focalizzata sulla ricerca di formule innovative per rendere i luoghi in cui viviamo più puliti, piacevoli e sicuri. Marka, brand di MK spa, ha creato Sistema Detergenza, Sistema Igiene e Sistema Ambiente: tre gamme con prodotti studiati e formulati per soddisfare ogni esigenza del cliente, garantendo una Protezione Profonda Professionale in tutti gli ambienti e contesti.
BEST SELLER

FEATURES
Product name:
LVS HW OVER 50
Plus: Liquid dishwasher detergent for extremely hard water (>50 °F). Prevents the formation of deposits and incrustations.
24 DIMENSIONE PULITO | 04/2024 COVER’S TRADE MARKS

MP-HT Srl
Via Tamburin, 19
35010 Limena (PD)
Tel.: +39 049 7968360 www.mp-ht.it
MP-HT is an Italian company that designs and produces sweeper machines with high technology systems, low environmental impact, easy to maintain and resistant. The continuous commitment to research and innovation allowed the Company to offer reliable cleaning solutions that improve the operator’s working conditions.
MP-HT è un’azienda italiana che progetta e produce spazzatrici – per il settore industriale e urbano - altamente tecnologiche, a basso impatto ambientale, di facile manutenzione e resistenti. Fin dal principio l’Azienda si impegna costantemente in progetti di ricerca e sviluppo, ciò le permette di offrire soluzioni di pulizia affidabili e di facile gestione, volte a migliorare le condizioni di lavoro dell’operatore.
BEST SELLER

FEATURES
Product name: AGILE MAX 109
Plus: A ride-on sweeper powered by a three-phase AC electric Motor. It is extremely manoeuvrable for faster and more practical cleaning operations.

Orma Srl
Via A. Chiribiri 2
10028 Trofarello (TO)
Tel.: +39 011 6499064 www.ormatorino.com
For over 40 years, Orma has been the reference point for pesticide control and environmental hygiene. Always oriented to innovation and the highest excellence, Orma guarantees professionalism, quality and well-being to all operators and their customers. Download the complete catalogue on www.ormatorino.com
Da oltre 40 anni, Orma è il punto di riferimento nel Pest Control e nell’igiene degli ambienti e supporta i propri clienti con prodotti e servizi capaci di offrire soluzioni efficaci per tutte le necessità.Orientata all’innovazione e alla massima eccellenza, Orma è garanzia di professionalità, qualità e benessere per tutti gli operatori del settore e per i loro clienti. Catalogo completo: www.ormatorino.com
SELLER

FEATURES
Product name: AIR Contol System
Plus: Automatic aerosol dispenser and pyrethrum-based Air Control S insecticide spray can for immediate action on flying insects.
Paperdi Srl Via Appia Antica 53 81020 S. Nicola La Strada (CE) Tel.: +39 0823 490011 www.paperdi.it
Paperdi has more than 30 years’ experience in the tissue field and in the market for the production of paper for hygienic and food use. Constant technological research and commitment to a sustainable development model allow Paperdi to offer a quality products, from paper rolls to medical sheets, from towels to toilet paper to napkins, for both domestic and professional use.
Paperdi vanta oltre 30 anni di esperienza in ambito tissue e racconta di un’azienda di spicco nel mercato della produzione di carta per uso igienico e alimentare. Costante ricerca tecnologica e impegno per un modello di sviluppo sostenibile permettono di offrire qualità grazie ad un’ampia gamma di prodotti, dalle bobine ai lenzuolini medici, dalle asciugamani alla carta igienica ai tovaglioli, sia per uso domestico che professionale.
BEST SELLER

FEATURES
Product name: V-folded hand towels
Plus: 100% sustainable and recyclable packaging, from sheets to paper packaging to cardboard. Format 21*25.

Sofidel Spa Via G. Lazzareschi 23 55016 Porcari LU Tel.: +39 05832681 www.sofidel.com
Papernet is the Sofidel Group brand for its Away-from-Home Tissue market range. The result is a range of products that stands out on the market for its ability to best meet any demand. Papernet chooses innovation, sustainability, and attention to every customer demand as strategic values, with the goal of creating a highly effective professional product.
Papernet è il marchio del Gruppo Sofidel per la gamma Away-from-Home del mercato Tissue. Il risultato è una gamma di prodotti che si distingue sul mercato per la sua capacità di saper soddisfare al meglio tutte le esigenze. Papernet sceglie l’innovazione, la sostenibilità e l’attenzione ad ogni bisogno dei clienti come valori strategici con l’obiettivo di un prodotto professionale di alta efficacia, realizzato nel rispetto dell’ ambiente e del risparmio energetico.
BEST SELLER

FEATURES
Product name: 411169 V-folded hand towels - Dissolve Tech
Plus: They dissolve in less than three minutes, ensuring both absorbency and strength for hand drying.
25 DIMENSIONE PULITO | 04/2024 MARCHI DI COPERTINA
BEST

Paredes Italia Spa
Via Scarsellini 119 16149 Genova
Tel.: +39 010 2362800 www.paredes.it
Paredes, 80 years on the professional hygiene market, has grown to 2 production sites and 16 commercial and logistic sites between France and Italy. Her story begins with the invention of autocut disposable hand drying systems to today’s themes of CSR. Choices and actions that have made Paredes become one of the leaders of the European hygiene market.
Paredes, 80 anni nel mercato dell’igiene professionale, oggi si presenta con 2 siti produttivi e 16 commerciali e logistici tra Francia e Italia. La sua storia inizia con l’invenzione del rotolo di carta monouso per scopi igienici e il dispenser a taglio automatico per asciugamani per proseguire verso temi sociali e ambientali.
Scelte e azioni che hanno fatto di Paredes il leader del mercato europeo dell’igiene.
BEST SELLER

FEATURES
Product name: Paredis Style Savonpak
Plus: Soap dispenser for hermetically sealed cartridges with anti-reflux teat - 900 and 1400ml. Transparent back to facilitate level control.

Polychim Srl
Via Fogazzaro 16
20092 Cinisello Balsamo (MI)
Tel + 39 02.66016908 www.polychim.it

RCM Spa Via Tiraboschi, 4 41043 Casinalbo (MO) Tel.: 059 515311 www.rcm.it
Since 1984 Polychim design and produce: detergents, additives, waxes and cosmetics for professional use. Over 250 formulations for kitchens, laundries, environments and surfaces, transport, industries, personal hygiene, even superconcentrated and ecological. Create product lines for cleaning distributors and give support and technical assistance before and after sales.
Dal 1984 Polychim progetta e produce: detergenti, additivi e ausiliari, cere e cosmetici a uso professionale. Oltre 250 formulati per cucine, lavanderie, ambienti e superfici, trasporti, industrie, igiene della persona, anche superconcentrati ed ecologici. L’azienda crea linee di prodotto “ad hoc” per distributori del cleaning, offre supporto e assistenza tecnica pre e post vendita.
BEST SELLER
FEATURES

Product name: VET ROSSO Plus: Ready-to-use cleaner for inks and markers, effective and without danger classifications. Packaging: 12 x 750 ml
RCM (Raimondi Costruzioni Meccaniche) Spa has been manufacturing and distributing industrial and urban cleaning machinery around the world since 1967. RCM was one of Italy’s first companies to specialize in the cleaning sector. The company was established in Modena, a city that reflects RCM’s entrepreneurial spirit and vocation with a solid family in business.
Dal 1967 RCM progetta, produce e distribuisce in tutto il mondo con una vasta rete commerciale, macchine per la pulizia industriale e urbana. RCM Spa è stata una delle prime aziende italiane produttrici nel settore del cleaning, nata e cresciuta a Modena, al centro di un territorio caratterizzato da un forte spirito imprenditoriale con vocazione alla Meccanica di qualità e all’innovazione.
BEST SELLER

FEATURES
Product name: RCM SUPRA Plus: Strong and reliable, suitable for heavy duties. Fully electric, very user friendly. Available in 2 versions: manual dump and hydraulic high dump.

RG Strumenti Srl Via Monte Aquila, 24/a 43124 Corcagnano (PR) Tel.: +39 0521 631188 www.rgstrumenti.it
RG strumenti is a company that has been operating for over 10 years in the sale of scientific instrumentation for analysis laboratories in the food and pharmaceutical industry. RG Strumenti’s strengths lie in its in-depth knowledge of the instrumentation on offer, its attention to customer needs, and therefore its ability to provide the suitable instrumentation for specific requirements.
RG strumenti è un’azienda che opera da oltre 10 anni nel settore della vendita della strumentazione scientifica per i laboratori d’analisi nell’industria alimentare e farmaceutica. I punti di forza di RG Strumenti sono l’approfondita conoscenza della strumentazione proposta, l’attenzione alle esigenze del cliente, e quindi la capacità di fornire all’interlocutore la strumentazione più idonea alle specifiche necessità.
BEST SELLER

FEATURES
Product name: Bioluminometro EnSure TOUCH Plus: Tool for immediate verification of the hygiene level of a surface. Ideal for daily cleaning monitoring.
26 DIMENSIONE PULITO | 04/2024 COVER’S TRADE MARKS
Rosiwit Technology
Bid C17, Zidong international park Nanjing, China
Tel: +89 025 82232293 www.rosiwit.com
Rosiwit Cobotics is a leading provider of cleaning cobotics solutions. Its dedicated team of over 100 R&D experts has experience in developing highly successful service robots that are currently leading the market. Its team members hail from prestigious QS 100 universities, and invests 60% of its budget into R&D to ensure the latest and the innovative technologies&solutions to the clients’ needs.
Rosiwit Cobotics è fornitore leader di soluzioni cobot per la pulizia. Il suo team dedicato, composto da oltre 100 esperti, vanta un’esperienza nello sviluppo di robot di servizio. I membri del team provengono da prestigiose università e il 60% del budget viene investito in R&S per garantire tecnologie e soluzioni innovative per soddisfare le esigenze dei clienti.
BEST SELLER

FEATURES
Product name: Titan 810
Plus: A professional industrial cleaning robot focused on large scene floor like warehouse, logistics and parkings.

Rubino Chem Srl Via Vigili del Fuoco Caduti in Servizio 14/s 70026 Modugno (BA) Tel: + 39 080 5035348 www.rubinochem.it
Rubino Chem is an Italian company that designs and manufactures cleaning and disinfectant products for both professional and domestic use, operating nationally and internationally since 1960. Through its R&D activities, it offers innovative solutions formulated with high-quality raw materials while also paying attention to environmental issues.
Rubino Chem è un’azienda italiana che progetta e produce soluzioni detergenti e disinfettanti per la pulizia professionale e domestica, operando a livello nazionale e internazionale dal 1960. Grazie alla sua attività di Ricerca e Sviluppo, offre prodotti innovativi formulati con materie prime di alta qualità, che rispondono alle esigenze del mercato e con un occhio di riguardo per l’ambiente.
BEST SELLER

Quine Srl via G. Spadolini, 7 20141 Milano (MI) Tel.: +39 02881841 www.dimensionepulito.it
For 33 years, the magazine Dimensione Pulito has been a point of reference for the professional cleaning and environmental sanitation industry. In addition to technical articles, interviews with key players, news and in-depth columns, it produces industry analysis and studies. The magazine is also available and searchable in digital format on any electronic media.

national monographs, in English or bilingual, address issues affecting professional cleaning on a European and global level, as well as promoting the Italian professional cleaning market internationally.
FEATURES

Product name: HiMiX – Protection 24H Plus: Multipurpose cleaner that removes germs and bacteria for up to 24-hour protection. H.A.C.C.P. compliant.
Dimensione Pulito è la rivista che, da 33 anni, è punto di riferimento per il settore del cleaning professionale e della sanificazione ambientale. Oltre ad articoli tecnici, interviste ai protagonisti, rubriche di attualità e approfondimento, Dimensione Pulito realizza analisi e studi di settore. Il magazine è disponibile e consultabile anche in formato digitale su qualsiasi supporto elettronico.


Le monografie internazionali di Dimensione Pulito, in lingua inglese o bilingue, affrontano tematiche che riguardano la pulizia professionale a livello europeo e mondiale, oltre a promuovere a livello internazionale il mercato italiano della pulizia professionale.





27 DIMENSIONE PULITO | 04/2024 MARCHI DI COPERTINA
Monthly magazine for industrial sanitization and environmental hygien Mont h y g azine fo in du strial saniti ation d envi onmental h y gien Let’s talk about Let’s talk about The Identity range of unique dispensers, a new collection of certified, dermatologically-tested soaps. Identity Soap 1000 offers a total solution with sustainable, delicate and fragrant products for optimal hygiene. 100% Made in Lucart. A range of “Made in Lucart” soaps designed for any situation. THE COMPLETE HYGIENE SOLUTION Monthly magazine for industrial sanitization and environmental hygienMont h y azine fo in du strial saniti ation envi onmental h y gien Let s talk about Let’s Follow US dimensionepulito.it SEGURIDAD SAFETY Higiene en el Food & Beverage Hygiene in Food & Beverage TECNOLOGÍA TECHNOLOGY Digitalización en hostelería Digital tools in hospitality PANORAMA OUTLOOK Limpieza en el 2024 2024 trends in cleaning industry Soluzioni d’igiene di protezione professionale LET’S TALK ABOUT CLEANING SUPPLEMENT TO DIMENSIONE PULITO NO 2024 MACHINES A new environmental certification for scrubber driers Nuova certificazione ambientale per lavasciuga TECHNOLOGY Mobile robots and applications in cleaning industry Mobile robots eapplicazioninelcleaning IAQ Indoor environments and cleaning effectiveness Valutare l’efficacia di pulizia in ambiente indoor DIMENSIONE PULITO MARZO 2024 Via Mazzon, 21 30020 Quarto d’Altino (VE) Italy Innovazione, ecosostenibilità e benessere Abbiamo creduto per primi nella certificazione Ecolabel perché nostri standard ne rispettavano già principi. nostri prodotti sono la soluzione migliore per l’ambiente…. ….migliore per te.
4CleanPro. Environmentally friendly Scrubber Driers

4CleanPro has been present in the world of professional industrial cleaning for over 10 years and thanks to a group of people with twenty years of experience in the sector, it is always continuously looking for innovations in order to adapt to an increasingly demanding and constantly evolving market. It is for this reason that 4CleanPro dedicates a lot of energy to the creation of new products or their technological updating, trying to comply with ecological requests while respecting current environmental problems.
This is also how the latest machine we created was born: Mira Ergo. It is completely revised compared to the Mira 40 in the upper part where all the new features are concentrated. The design offers a new handle that supports the recovery tank. The dashboard, in-
when the water reaches the maximum level. The lower part of the machine, however, is un changed and features exactly the same com ponents as the previous version.

stead of the bulky rotational handle, has been replaced by the traditional 32 mm diameter tubular handle in AISI 304 stainless steel. The dashboard with the handle is instead a double shell with the grip of the single-brush type handle, and offers a greater lever arm thus making driving the machine lighter. At the bottom of the handle there is a 5 liter recovery tank that is easy and safe to release and empty.
The filter and float system is the traditional steel mesh cage with balls which will then plug the suction pipe
The result is therefore a machine that is lighter to drive due to the lowering of the center of gravity of the handle unit, more ergonom ic (where the name ERGO comes from) with the single brush handle, more reliable with the new 5 liter capacity recovery water tank and especially the direct connection of the suction system hose directly inserted into the tank therefore without gasket and without closing hook as well as the new net cage float system with balls. Efficiency remains at an excellent level also because the batteries and motors are the same as the previous model and with a 330 watt suction motor and 2 brush motors of 120 watts each. It is very important to underline that all the main spare parts are the same

as the previous version and therefore our distributors and assistance centers do not have to stock up on new spare parts given that all the engines and electronic boards are identical, as well as the entire range of accessories remains unchanged. Together with the Mira Ergo in 4CleanPro production you can find Mira 40, Mira Hepa, Amica and Gaia: an entire range capable, thanks to the specific characteristics of each of them, of solving all the problems related to cleaning and the mechanization of washing and sanitizing operations of the most varied sectors: civil, commerce, cleaning companies, industry, healthcare and transport.
sponsored content
4cleanpro.com


4CleanPro. Lavapavimenti a basso impatto ambientale

4CleanPro è presente ormai da oltre 10 anni nel mondo della pulizia industriale professionale e grazie a un gruppo di persone con esperienza ventennale nel settore, è sempre alla continua ricerca di innovazioni al fine di adattarsi a un mercato sempre più esigente e in continua evoluzione. È per questo motivo che l’azienda dedica molte energie alla realizzazione di nuovi prodotti o al loro aggiornamento tecnologico, cercando di accordarsi con le richieste ecologiche nel rispetto delle attuali problematiche ambientali. È nata così anche l’ultima macchina: Mira Ergo. Si presenta completamente rivisitata rispetto alla Mira 40 nella parte superiore dove sono concentrate tutte le novità. Il design offre un nuovo manico che supporta il serbatoio di recupero. Il cruscotto invece dell’ingombrante manico in rotazionale, è stato sostituito dal tradizionale manico
do l’acqua arriva al livello massimo. La parte inferiore della macchina invece è invariata e monta esattamente gli stessi componenti della ver sione precedente.

tubolare di 32 mm di diametro in acciaio inox AISI 304. Il cruscotto con l’impugnatura è invece un doppio guscio con la presa del manico del tipo monospazzola, e offre un maggior braccio di leva rendendo così più leggera la guida della macchina. Nella parte inferiore del manico si trova il serbatoio di recupero di ben 5 litri facile e sicuro da sganciare e svuotare. Il sistema di filtro e galleggiante è la tradizionale gabbia di retina d’acciaio con delle palline che andranno poi tappare il tubo d’aspirazione quan-
Il risultato è dunque una macchina più leggere alla guida dovuto all’abbassa mento del baricentro del gruppo manico, più ergono mica (dove il nome ERGO) con l’impugnatura a mono spazzola, più affidabile con il nuovo serbatoio di 5 litri di capacità dell›acqua di recupero e soprattutto il collegamento diretto del tubo del sistema d’aspirazione, direttamente inserito nel serbatoio quindi senza guarnizione e senza gancio di chiusura come anche il nuovo sistema di galleggiante a gabbia di rete con palline. L’efficienza rimane di ottimo livello anche perché le batterie e i motori sono gli stessi del modello precedente e con un motore d’aspirazione 330 watt e 2 motori spazzole di 120 watt ciascuno. Importantissimo sottolineare che

tutti i ricambi principali sono gli stessi della versione precedente e quindi i nostri distributori e centri assistenza non devono rifornirsi di nuovi ricambi dato che tutti i motori e le schede elettroniche sono identiche, come anche tutta la gamma di accessori rimane invariata. Insieme alla Mira Ergo nel catalogo 4CleanPro potete trovare Mira 40, Mira Hepa, Amica e Gaia: un intera gamma in grado grazie alle specifiche caratteristiche di ognuna di esse, di risolvere tutte le problematiche legate alla pulizia e alla meccanizzazione delle operazioni di lavaggio e sanificazione dei più svariati settori: civile, commercio, imprese di pulizia, industria, sanità e trasporti.
informazione pubblicitaria
4cleanpro.com
Developing a European culture of industrial cleaning
"We don't need less Europe, we need less European burden due to bureaucratic obstacles!" Interview with Laurent Westermeyr, secretary of FIDEN, Fédération Internationale des Entreprises de Nettoyage, which will hold its International Congress in Cagliari, Italy, from Sept. 19-22
Maurizio Pedrini
The cultural, professional and associational issues that FIDEN (Fédération Internationale des Entreprises de Nettoyage) is pursuing to give a voice to European cleaning and facility management companies in the EU are indeed many, complex, and highly and narrowly topical. From September 19 to 22, in Cagliari, Sardinia, Italy, Federation members will once again gather to hold their annual international congress to address the challenging topic of artificial intelligence as it relates to our industry. We met with Secretary Laurent Westermeyr to introduce FIDEN, talk about its plans and anticipate some information about the important event scheduled in our country. The FIDEN Secretariat is located in the center of Munich near Königsplatz near the Lenbachhaus art mu-
32 DIMENSIONE PULITO | 04/2024
EUROPEAN OBSERVATORY

seum. The team at Westermeyr´s side, which has been in charge of FIDEN since 1995, is multilingual and experienced in international affairs, thanks to its many activities abroad.
Can we first introduce FIDEN by explaining when it came into being, the goals it has set for itself, and what its identity and representativeness is currently in the European arena?
"FIDEN was founded in 1956 as a platform for commercial cleaning compa-
nies with a European orientation. This makes it one of the longest-running professional associations with a remarkable international background. At that time, the founding members came from Germany, Austria and Italy. Their idea, which is still relevant today, was to establish contacts with professional colleagues across national borders, exchange experiences, and give voice to the commercial cleaning industry as an important factor of economic development in Europe. This mission has not only led to joint business activities, but also to long-standing friendships across borders. Over the years, FIDEN has also developed into a platform for all companies working with and for the cleaning industry, as suppliers or service providers. Of course, building cleaning companies have also evolved and conquered new fields of business. Today, in fact, many companies operating in the field of facility management are members of FIDEN. Finally, I specify that FIDEN is not a political interest group, but sees itself as a community of entrepreneurs interested in all topics important to the building cleaning industry. As a think tank, FIDEN is concerned with current and

future developments, whether in the field of building technology, business management or corporate culture. Every year, the highlight is an international congress, which in 2024 will be held in Sardinia, September 19-22. Of course, we will also be pleased to welcome Italian companies that are not yet members of FIDEN."
FIDEN currently has an influential representation to the EU in Brussels and a permanent secretariat in Munich: what tasks are they in charge of and what activities do these two important entities perform?
"We follow the latest developments at the European level through our Brussels office. We are not so much interested in political participation - that's what FENI, an association representing national business organizations, is for - rather in finding out for our members what projects might have a direct impact on their business in the future. Our secretariat in Munich coordinates FIDEN's projects, helps establish direct contacts among members and serves as a point of reference for all our members' needs."
We are on the eve of an important meeting to elect the new EU leadership: what are the issues you care most about and your main demands?
“When we ask our members what issues matter most to them, one of the main problems - which has a negative impact on all business sectors and all countries - is excessive bureaucracy. It is true that Brussels promised many years ago to work to reduce it and even appointed a special representative, but - in our opinion - practically nothing has happened. It also doesn't help much if one regulation is abolished or simplified, if two new ones are created at the same time. Do not misunderstand me. Much of what the EU intended today facilitates the cross-border exchange of goods and services, but at
33 DIMENSIONE PULITO | 04/2024
From left to right Laurent Westermeyr, Hans Ziegle and Roberto De Zorzi, respectively secretary, president and vice-president of FIDEN
Laurent Westermeyr, FIDEN secretary

the same time systems have been established that impose enormous registration and reporting obligations on every company, be it large or small. Of course, smaller companies suffer even more. And what is often overlooked is that national legislators add additional burdens to those to be adopted by Brussels. We do not need less Europe, but less European burdens due to bureaucratic obstacles.”
We come to a topic that is particularly close to your heart: that of the development of a European culture of industrial cleaning. How much is this issue felt by associated companies and what initiatives are you carrying out to boost its growth?
“It is important to understand that in Europe there are still very different structures regarding companies and, in particular, training. In some countries it is mainly large companies that dominate the market, while in others there are many small companies. Added to this are the different quality and training standards. While there are countries that have a fixed training
system and corresponding professional qualifications, in others training is predominantly on a voluntary basis. This also has to do with the reputation of employees and their self-image. Those who have received a good education will also develop a different self-esteem and represent it to the outside world. All this improves the image of the entire profession and you are no longer the 'necessary evil' who does the cleaning. During the Coronavirus period, the perception of the importance of hygiene and cleanliness has certainly taken a step forward for our companies and our employees: suddenly these issues have jumped to the center of attention. I really want to hope that this sensitivity remains alive in the future too, to give us the opportunity to build a new culture of cleanliness in a European perspective on solid foundations."
Another topic that is very important to FIDEN is that of environmental sustainability: how can the association and the companies that are part of it concretely contribute to carrying out a balanced policy capable of reconciling economic needs with environmental ones?
“As I said at the beginning, we are not a political organization. We therefore have no direct influence on policy makers, although many of our members hold influential positions in national business associations. But we are a platform for everyone in the commercial cleaning industry, which means we are in constant dialogue with and with each other. This is the only way to achieve a reasonable balance between what the customer wants, what the commercial cleaning company needs, and what the industry is capable of producing. And this is especially true in the area of environmental sustainability. Our customers expect concrete steps from us, which we develop together with the manufacturers. Because both the responsibility for the environment and the price of our service must be fair. Ultimately, the customer must be willing to pay for it. In addition to the desire for greater cleanliness and hygiene, we also see that customers are willing to pay more for responsible use of resources. Above all, however, all this must be achievable in daily practice.”
In recent years you have promoted moments of meeting and exchange of experiences with your Congresses, which took place in various European countries: can we take stock of these experiences?
“Our Congresses have three main tasks: first, to provide our members
When we ask our members what issues matter most to them, one of the main problems - which has a negative impact on all business sectors and all countriesis excessive bureaucracy
34 DIMENSIONE PULITO | 04/2024
EUROPEAN OBSERVATORY
FIDEN the management team

with the latest information and developments first-hand and through recognized experts. Second, an association like ours needs a meeting at least once a year where members can exchange ideas in person. We missed this greatly during the break caused by the Coronavirus pandemic and the subsequent Congress in Mallorca in 2022 was characterized by great joy of meeting again, because our members have often known each other for decades and our conferences are an annual highlight for them. However, to be achieved, this objective also requires an appropriate context, which we offer thanks to different and interesting venues. And this is the third element. We use our contacts with local businesses to provide special impressions and insights. In Venice, for example, we had the opportunity to speak with
those responsible for the restoration and reclamation, after the fire at the La Fenice Theatre, a very interesting experience for our members also from a professional point of view. We all appreciate the possibilities of digital communication, but the personal aspect should not be overlooked. Our members confirm this every year with a growing number of participants.”
Therefore, your 2024 International Congress will be held in Sardinia, in Cagliari. Can we anticipate what themes will be at the center of the reflection and what are the expectations that FIDEN places on this event?
“The theme of this year's Congress will be: 'Generation Z against Artificial Intelligence: match or crash'. We have all understood that the new generations entering the world of work establish

different priorities for their professional and private lives. This requires employers to rethink and answer the question of how digitalisation and artificial intelligence can help reconcile the needs of employees and customers so that they not only survive as a business into the future, but also remain economically strong. We face these challenges and experience new developments every day. Our industry should also benefit. However, we must also keep in mind that people and their work on construction sites remain particularly important for our companies.”
We can take a quick look at the programs and initiatives you intend to carry out, also in reference to the great challenges awaiting cleaning companies: from digitalisation, to artificial intelligence, to innovation 5.0, to the training of professionals in a European key to safety at work. What can we say about it?
“I believe that the answers to the questions I asked at the beginning show the direction in which we need to think and work. Robotics, digitalisation and artificial intelligence on the one hand, protection of natural resources and sustainability on the other. However, people must be the focus. They must not become a mere means to an end. We must ensure that as many as possible are accompanied and supported in their abilities and objectives, because on a carousel that spins ever faster, many will find themselves first on the edge and then on the bottom. Therefore, one of our most important objectives is and remains to strengthen the reputation of our profession and our companies. This requires good training to achieve good results and, last but not least, positive communication about what we contribute to each individual's life. I thank you and your magazine for the opportunity to present our organization, FIDEN and our objectives to your readers.”
36 DIMENSIONE PULITO | 04/2024
EUROPEAN OBSERVATORY

Tenax: 100 % Electrical reliability and environmental protection
Tenax International is one of the player currently on the market to have been able to translate its electric vocation into a complete range of 100% fully electric (non-electrified) low voltage (less than 50 volt) street sweepers and washers. All the products in Tena-
x’s range were designed from their conception to be completely and exclusively electric. Tenax means 100% electric reliability; in fact, thanks to over twenty years of experience in the electric street sweeping sector and thanks to the over 1500 electric sweepers sold under its own brand in over 42
countries, it is able to guarantee high performances at all latitudes and offers tailor-made solutions designed to satisfy the needs of each customer.
For this reason, today, Tenax International boasts a partnership with the main European and non-European public and private com-
Tenax: Affidabilità 100 % elettrica e tutela dell’ambiente
Tenax International, è uno dei player attualmente sul mercato ad essere stato in grado di tradurre la propria vocazione elettrica in una gamma com-
pleta di spazzatrici e lavastrade 100% elettriche (non elettrificate) a basso voltaggio (inferiore a 50 volt). Tutte le spazzatrici Tenax, sono carat-
terizzate da un’elevata affidabilità e da un sistema di funzionamento 100% elettrico di nuovissima generazione. All’interno della gamma, s’inserisce
panies. All Tenax sweepers are characterized by high reliability and a latest generation 100% electric operating system. From now the range includes the innovative Electra 5.0 Life, the first new generation 5 m³ compact sweeper, capable of combining high performance and comfort.





l’innovativa Electra 5.0 Life, prima spazzatrice compatta di nuova generazione da 5 m³, capace di combinare performances e comfort elevati.




tenaxinternational.com
sponsored content Spazzatrici Stradali & Lavastrade 100% Elettriche 100% Electric street Sweepers & Flushers Tenax International S.p.A. - Via Balduina, 3 - 42010 Rio Saliceto (RE) Italy www.tenaxinternational.com
SVILUPPARE UNA CULTURA EUROPEA DELLA PULIZIA INDUSTRIALE
“Non abbiamo bisogno di meno Europa, ma di meno oneri europei dovuti a ostacoli burocratici!”. A tu per tu con Laurent Westermeyr, segretario della FIDEN, Fédération Internationale des Entreprises de Nettoyage, che dal 19 al 22 settembre terrà il suo Congresso Internazionale a Cagliari
Maurizio Pedrini
Sono davvero molteplici, complesse, di grande e stretta attualità del problematiche culturali, professionali e associative che la FIDEN (Fédération Internationale des Entreprises de Nettoyage) sta portando avanti per dar voce alle imprese di pulizia e facility management europee in ambito UE. Dal 19 al 22 settembre, in Sardegna, a Cagliari, gli associati alla Federazione si ritroveranno, ancora una volta, in Italia per tenere il loro annuale congresso internazionale, per affrontare la stimolante tematica dell’intelligenza artificiale riferita al nostro settore. Abbiamo incontrato il segretario Laurent Westermeyr per presentare FIDEN, parlare dei suoi progetti e anticipare qualche informazione sull’importante evento in programma nel nostro Paese. La Segreteria della FIDEN si trova nel centro di Monaco di Baviera nei pressi di Königsplatz vicino al museo d´arte Lenbachhaus. Il team al fianco di Westermeyr che, dal 1995 si occupa della FIDEN, è multilingue ed esperto in materia internazionale, grazie alle numerose attività svolte all’estero.
Possiamo presentare innanzitutto la FIDEN spiegando quando è nata, gli obiettivi che si è data e qual è attualmente la sua identità e rappresentatività in ambito europeo?
“La FIDEN (Fédération Internationale des Entreprises de Nettoyage) è stata fondata nel 1956 come piattaforma per le imprese di pulizia commerciale con orientamento europeo. Questo la rende una delle associazioni professionali più longeve, con un notevole background internazionale. All'epoca, i membri fondatori provenivano da Germania, Austria e Italia. La loro idea, che è ancora attuale, era quella di stabilire contatti con colleghi professionisti al di là dei confini nazionali, scambiare esperienze e dare voce al settore delle pulizie commerciali come importante fattore di sviluppo economico in Europa. Questa mission non ha portato solo ad attività imprenditoriali congiunte, ma anche ad amicizie di lunga data al di là di ogni confine. Nel corso degli anni, FIDEN si è anche trasfor-
mata in una piattaforma per tutte le aziende che lavorano con e per il settore di pulizia, come fornitori o prestatori di servizi. Naturalmente, anche le imprese di pulizia degli edifici si sono evolute e hanno conquistato nuovi campi di attività. Oggi, infatti, molte aziende che operano nel campo del facility management fanno parte di FIDEN. Preciso, infine, che FIDEN non è un gruppo di interesse politico, ma si considera una comunità di imprenditori interessati a tutti gli argomenti importanti per il settore della pulizia degli edifici. In qualità di think tank, FIDEN si occupa degli sviluppi attuali e futuri, sia nel campo della tecnologia degli edifici, della gestione aziendale o della cultura aziendale. Ogni anno, il momento clou è rappresentato da un congresso internazionale che nel 2024 si terrà in Sardegna, dal 19 al 22 settembre. Naturalmente, saremo lieti di accogliere anche le aziende italiane che non sono ancora membri della FIDEN.”
FIDEN attualmente può contare su un’autorevole rappresentanza presso l’UE a Bruxelles e su di un segretariato permanente a Monaco di Baviera: a quali compiti sono preposti e quali attività svolgono queste due importanti realtà?
“Seguiamo gli ultimi sviluppi a livello europeo attraverso il nostro ufficio di Bruxelles. Non siamo tanto interessati alla partecipazione politica - a questo serve FENI, un'associazione che rappresenta le organizzazioni imprenditoriali nazionali - quanto a scoprire, per i nostri membri, quali progetti potrebbero avere un impatto diretto sulla loro azienda in futuro. La nostra segreteria a Monaco coordina le progettualità di FIDEN, aiuta a stabilire contatti diretti tra i membri e funge da punto di riferimento per tutte le esigenze dei nostri associati.”
Siamo alla vigilia di un importante appuntamento per eleggere i nuovi vertici dell’UE: quali sono i temi che vi stanno maggiormente a cuore e le vostre principali richieste?
“Quando chiediamo ai nostri iscritti quali siano le questioni che stanno loro particolarmente a cuore, uno dei problemi principali - che ha un impatto negativo su tutti i settori di attività e su tutti i Paesi - è l'eccessiva burocrazia. È
vero che Bruxelles ha promesso molti anni fa di lavorare per ridurla e ha persino nominato un rappresentante speciale, ma - a nostro avviso - non è successo praticamente nulla. Inoltre, non è di grande aiuto se un regolamento viene abolito o semplificato, se ne vengono creati due nuovi allo stesso tempo. Non fraintendetemi. Gran parte di ciò che l'UE ha voluto, oggi facilita lo scambio transfrontaliero di beni e servizi, ma allo stesso tempo sono stati determinati sistemi che impongono enormi obblighi di registrazione e rendicontazione a ogni azienda, sia essa grande o piccola. Naturalmente, le aziende più piccole ne risentono ancora di più. E ciò che spesso viene trascurato è che i legislatori nazionali aggiungono ulteriori oneri a quelli che devono essere adottati da Bruxelles. Non abbiamo bisogno di meno Europa, ma di meno oneri europei dovuti a ostacoli burocratici.”
Veniamo a una tematica che vi sta particolarmente a cuore: quella dello sviluppo di una cultura europea della pulizia industriale: quanto è sentito questo tema dalle imprese associate e che iniziative state portando aventi per dare impulso alla sua crescita?
“È importante capire che in Europa esistono ancora strutture assai diverse per quanto riguarda le aziende e, in particolare, la formazione. In alcuni Paesi sono soprattutto le grandi aziende a dominare il mercato, mentre in altri ci sono molte piccole imprese. A questo si aggiungono i diversi standard di qualità e formazione. Mentre ci sono Paesi che hanno un sistema di formazione fisso e qualifiche professionali corrispondenti, in altri la formazione è prevalentemente su base volontaria. Questo ha anche a che fare con la reputazione dei dipendenti e la loro immagine di sé. Chi ha ricevuto una buona istruzione svilupperà anche una diversa autostima e la rappresenterà al mondo esterno. Tutto ciò migliora l'immagine dell'intera professione e tu non sei più il ‘male necessario’ che fa le pulizie. Durante il periodo del Coronavirus la percezione dell’importanza dell’igiene e della pulizia ha sicuramente fatto un passo avanti, per le nostre aziende e i nostri dipendenti: improvvisamente questi temi sono balzati al centro dell'attenzione. Voglio sperare davvero che questa sensibilità rimanga viva an-
38 DIMENSIONE PULITO | 04/2024
OSSERVATORIO EUROPEO

che in futuro, per darci la possibilità di costruire su solide fondamenta una nuova cultura del pulito in chiave europea.”
Un altro argomento assai sentito da FIDEN è quello della sostenibilità ambientale: come può concretamente contribuire l’associazione e le imprese che ne fanno parte a portare avanti un’equilibrata politica in grado di contemperare le esigenze economiche con quelle ambientali, senza inutili “fughe in avanti”?
“Come ho detto all'inizio, non siamo un'organizzazione politica. Pertanto non esercitiamo alcuna influenza diretta sui responsabili politici, anche se molti dei nostri membri ricoprono posizioni influenti nelle associazioni imprenditoriali nazionali. Ma siamo una piattaforma per tutti gli operatori del settore della pulizia commerciale, il che significa che siamo in costante dialogo con e tra di noi. Questo è l'unico modo per raggiungere un equilibrio ragionevole tra ciò che vuole il cliente, ciò di cui ha
Quando chiediamo ai nostri iscritti quali siano le questioni che stanno loro particolarmente a cuore, uno dei problemi principali - che ha un impatto negativo su tutti i settori di attività e su tutti i Paesi - è l'eccessiva burocrazia
bisogno l'impresa di pulizia commerciale e ciò che l'industria è in grado di produrre. E questo è particolarmente vero nell'area della sostenibilità ambientale. I nostri clienti si aspettano da noi passi concreti, che sviluppiamo insieme ai produttori. Perché sia la responsabilità per l'ambiente che il prezzo del nostro servizio devono essere giusti. In fin dei conti, il cliente deve essere disposto a pagare per questo. Oltre al desiderio di maggiore pulizia e igiene, vediamo anche che i clienti sono disposti a pagare di più per un uso responsabile delle risorse. Soprattutto, però, tutto questo deve essere realizzabile nella pratica quotidiana.”
In questi anni avete promosso momenti d’incontro e scambio di esperienze con i vostri Congressi, che si sono svolti in vari Paesi d’Europa: possiamo fare un bilancio di queste esperienze?
“I nostri Congressi hanno tre compiti principali: in primo luogo, fornire ai nostri membri le informazioni e gli sviluppi più recenti di prima mano e attraverso esperti riconosciuti. In secondo luogo, un'associazione come la nostra ha bisogno di un incontro almeno una volta all'anno in cui i membri possano scambiarsi idee di persona. Questo ci è mancato molto durante la pausa determinata dalla pandemia da Coronavirus e il successivo Congresso di Maiorca del 2022 è stato caratterizzato da una grande gioia di ritrovarsi, perché spesso i nostri membri si conoscono da decenni e le nostre conferenze sono per loro un highlight annuale. Tuttavia, questo obiettivo, per essere raggiunto, richiede anche un contesto appropriato, che noi offriamo grazie a sedi diverse e interessanti. E questo è il terzo elemento. Utilizziamo i nostri contatti con le aziende locali per fornire impressioni e approfondimenti speciali. A Venezia, ad esempio, abbiamo avuto la possibilità di parlare con i responsabili del restauro e della bonifica, dopo l'incendio del Teatro La Fenice, un'esperienza molto interessante per i nostri soci anche dal
punto di vista professionale. Tutti apprezziamo le possibilità della comunicazione digitale, ma l'aspetto personale non deve essere trascurato. I nostri soci lo confermano ogni anno con un numero crescente di partecipanti.”
Dunque in Sardegna, a Cagliari, si terrà il vostro Congresso Internazionale 2024. Possiamo anticipare quali saranno i temi al centro della riflessione e quali sono le aspettative che FIDEN ripone su questo evento?
“Il tema del Congresso di quest'anno sarà: ‘La Generazione Z contro l'Intelligenza Artificiale: match or crash’. Abbiamo capito tutti che le nuove generazioni che si affacciano al mondo del lavoro stabiliscono priorità diverse per la loro vita professionale e privata. Questo richiede che i datori di lavoro ripensino e rispondano alla domanda su come la digitalizzazione e l'intelligenza artificiale possano aiutare a conciliare le esigenze dei dipendenti e dei clienti in modo tale da non solo sopravvivere come azienda nel futuro, ma anche rimanere economicamente forti. Dobbiamo affrontare queste sfide e sperimentiamo nuovi sviluppi ogni giorno. Anche il nostro settore dovrebbe trarne beneficio. Tuttavia, dobbiamo anche tenere presente che le persone e il loro lavoro in cantiere rimangono particolarmente importanti per le nostre aziende.”
Possiamo dare un’occhiata, in rapida carrellata, ai programmi e alle iniziative che intendete portare avanti, anche in riferimento alle grandi sfide che attendono le imprese di pulizia: dalla digitalizzazione, all’intelligenza artificiale, all’innovazione 5.0, alla formazione delle figure professionali in chiave europea alla sicurezza sul lavoro. Cosa possiamo dire al riguardo?
“Credo che le risposte alle domande che ho posto all'inizio mostrino la direzione in cui dobbiamo pensare e lavorare. Robotica, digitalizzazione e intelligenza artificiale da un lato, protezione delle risorse naturali e sostenibilità dall'altro. Tuttavia, le persone devono essere al centro dell'interesse. Non devono diventare un mero mezzo per raggiungere un fine. Dobbiamo fare in modo che il maggior numero possibile di esse sia accompagnato e supportato nelle sue capacità e nei suoi obiettivi, perché su una giostra che gira sempre più velocemente, molti si ritroveranno prima sul bordo e poi sul fondo. Pertanto, uno dei nostri obiettivi più importanti è e rimane quello di rafforzare la reputazione della nostra professione e delle nostre aziende. Ciò richiede una buona formazione per ottenere buoni risultati e, ultimo ma non meno importante, una comunicazione positiva su ciò che contribuiamo alla vita di ogni individuo. Ringrazio lei, dottor Pedrini e la Rivista Dimensione Pulito, per l'opportunità di presentare la nostra organizzazione, la FIDEN e i nostri obiettivi ai vostri lettori.”
39 DIMENSIONE PULITO | 04/2024
Ghibli & Wirbel at Interclean Amsterdam

Ghibli & Wirbel will take part to Interclean to present its wide offer of professional cleaning machines developed and produced in their entirety within the manufacturing plant located in Northern Italy, including some brand new products! An innovative cordless dry vacuum cleaner will join this well-known range featured by sturdiness and high per-
formance.
Big news also for scrubber dryers, that will see the entry of a new ride-on model into the family of these professional cleaning machines!
Also, as usual, some of Ghibli & Wirbel’s most representative machines will be displayed, along with the latest products launched a few months ago: Royal 15
and Green Pro range
Royal 15 is the practical and ergonomic walk-behind scrubber dryer that, thanks to its 15-liter capacity and 385 mm cleaning width, guarantees a productivity up 1.540 m2/h and it has been specifically designed for cleaning small and medium-sized areas such as offices, hotels, restaurants, schools and small gathering spaces. The design is studied in every detail to ensure maximum comfort to the operator: the clean lines that define its compact structure and the use of practical compartments for the storage of hoses and cables help improve Royal’s maneuverability.
Also, the sturdy and extremely practical aluminum tiltable handle allows maximum maneuverability in tight spaces.
This walk-behind scrubber dryer ensures excellent cleaning results on all types of floors, even the most difficult ones (such as concrete, bolted, non-slip surfaces).
Green Pro is the complete range of professional cleaning machines made with recycled plastic. Vacuum cleaners, single discs and scrubber dryers declined in a green way featured by the same quality, reliability and performance of the standard products!
Ghibli & Wirbel offers a complete solution to satisfy all the needs of professional cleaning operators.
Royal 15 scrubber dryer

Ghibli & Wirbel partecipa a Interclean per presentare la sua ampia offerta di macchine per la pulizia professionale sviluppate e prodotte interamente nello stabilimento produttivo del nord Italia, compresi alcuni prodotti nuovissimi. Un innovativo aspiratore dry a batteria entrerà a far parte della rinomata gamma degli aspiratori, caratterizzata da robustezza e performance elevate. Grandi novità anche per le lavasciuga pavimenti che vedranno l’ingresso di un nuovo modello uomo a
bordo tra queste macchine per la pulizia professionale. Inoltre, come sempre, saranno esposte alcune delle macchine più rappresentative di Ghibli & Wirbel insieme ai prodotti lanciati negli ultimi mesi: Royal 15 e la gamma Green Pro. Royal 15 è la lavasciuga uomo a terra pratica ed ergonomica che, grazie ai 15 litri di capacità e ai 385 mm di pista di lavaggio, garantisce una produttività fino a 1.540 m2/h ed è stata specificamente concepita per pulire aree di piccole e medie dimensioni, come
uffici, hotel, ristoranti, scuole e piccoli spazi di aggregazione. Il design è studiato in ogni dettaglio per assicurare il massimo comfort all’operatore: le linee pulite che definiscono la struttura compatta e l’utilizzo di pratici scomparti per riporre tubi e cavi aiutano a migliorare la manovrabilità di Royal. Anche il maniglione in alluminio, pratico ed estremamente robusto, consente la massima maneggevolezza negli spazi stretti. Questa lavasciuga uomo a terra assicura risultati di pulizia ec-
cellenti su tutti i tipi di superfici, anche quelle più difficili (come cemento, bullonato e antiscivolo). Green Pro è la gamma completa di macchine per la pulizia professionale realizzata con plastica riciclata. Aspiratori, monospazzole e lavasciuga pavimenti declinati in una formula green caratterizzata dalla stessa qualità, affidabilità e performance dei prodotti standard. Ghibli & Wirbel offre una soluzione completa per soddisfare tutte le esigenze degli operatori del cleaning professionale.
sponsored content
ghibliwirbel.com
Ghibli & Wirbel a Interclean Amsterdam
Green Pro range
THE COMPACT SCRUBBER DRYER WITH AN INNOVATIVE AND TRULY UNIQUE

Royal 15 is the compact walk-behind scrubber dryer ideal for cleaning small and medium-sized surfaces such as stores, laboratories, offices and restaurants and which, thanks to its 15-liter capacity and 385 mm cleaning width, guarantees an output of up to 1.540 m2/h.
The meticulously thought-out design is tailored to make this machine extremely compact and easy to handle, while at the same time providing top-notch professional performance to ensure excellent cleaning results, even in the tightest spaces.

This scrubber dryer is the ideal machine for working on all types of floors, even the most difficult ones (such as concrete, bolted, non-slip surfaces), ensuring excellent cleaning results.

Ghibli & Wirbel S.p.A. Via Circonvallazione, 5 27020 Dorno PV - Italia P. +39 0382 848811 - F.+39 0382 84668 M. info@ghibliwirbel.com RIELLO INDUSTRIES GROUP 100% MADE IN ITALY WWW.GHIBLIWIRBEL.COM
DESIGN! ROYAL 15
Priorities for a competitive, sustainable and efficient industry

EFCI, the federation that gives voice to the cleaning and facility management industry in Europe intends to provide a precise framework for the new institutions to better guide their actions
Maurizio Pedrini

FACILITY MANAGEMENT
The eight priorities listed by EFCI cover a number of issues of fundamental importance to a sector, industrial cleaning, which within the European Union, can count on a turnover of 120 billion euros and about 3.7 million employees. Not to mention that more than 90 percent of cleaning companies in the EU employ between 1 and 49 people. The issues listed as pre-eminent that need to be addressed as soon as possible to ensure a balanced and profitable development for the sector range from the impact of public procurement regulations, with the need to review their rules, to the contribution that cleaning activities can make in supporting the environmental transition. The federation that gives voice to the Cleaning and Facility Management industry in Europe, through the voice of its president, Lorenzo Mattioli, says it is available to discuss with other representatives of the economy and society, as well as with current and upcoming members of the European Parliament and representatives of the European Commission on the points addressed in the document.
Not only in the immediate interest of the industry, but also for the benefit of all those Europeans who owe economic prosperity, social integration and personal well-being to the work provided every day by the workers in this valuable economic sector. But let us examine in detail the points addressed.
1The labor-intensive service industry contributes to economic development and social integration.
Among the many events that have shaped economic and social developments over the past five years,” it says, “the Covid pandemic has demonstrated the incredible contribution of the cleaning industry to the smooth functioning of our societies. Now that the urgency of the crisis gives way to the need to draw the right lessons and adapt to them, it is necessary to
turn the attention our work has received into a more structural recognition by policy that labor-intensive services are not a commodity, but a key component of overall economic activity. With demographic transformations and the emergence of new ways of working and living, a paradigm shift is needed to ensure that the work done by businesses can not only contribute to the creation of healthy, safe and pleasant environments in which people and economies can thrive, but also be perceived as equally conducive to economic growth, social stability and overall resilience as the rest of the service and manufacturing sector. Hence the request made to the EU’s political forces to embrace this reality and to reflect this awareness in the way the next European Commission will be structured by developing a specific and distinct portfolio dedicated to the labor-intensive services industry, reflected in the internal organization of EC services.
2
Manifesto for a competitive, sustainable and efficient cleaning and facility management industry


Integrating the hygiene dimension into EU public health policy.
The pandemic and the need to strengthen the EU’s ability to respond quickly to health threats led to the creation of the HERA and initiated a serious debate on the need to move forward in creating a European health union. Public health, it is argued, is increasingly becoming an EU competence, with new centralized responsibilities for procurement, disease control and emergency response. However, the EU approach lacks a significant dimension of outbreak prevention and control:
the provision of regular cleaning and sanitation services. Hence the call for the next European Commission to incorporate this in the future update of its public health policy, including by developing a system to ensure minimum criteria for Member States’ preparedness for public health emergencies that incorporate the provision of standard sanitation requirements, as well as the inclusion of cleaning services (and theirs actors) in emergency and continuity plans.
3
New rules for public procurement.
For the industrial cleaning sector, and many other labor-intensive service industries, public sector customers account for a significant share of turnover, in some cases as much as 50 percent. While procurement provisions are decided primarily at the national level, EU rules set the general framework within which member
43 DIMENSIONE PULITO | 04/2024
The voice of the cleaning and facility services industry in Europe
EFCI’S PRIORITIES AHEAD OF THE 2024 EU ELECTIONS
states can operate and can therefore already be drafted to ensure that some of the most impactful distortions in procurement practices are excluded from the outset. A revision is called for that reflects the specificities of labor-intensive service contracts and adequately reflects the current reality of more volatile and inflation-prone economic and market conditions: principles such as the requirement for price reviews in contracts awarded in the event of excessive price increases, or following changes in legislation that impact wages, should be clearly included in any proposed revision of the directive. Finally, the revision should include clear support for the professionalization of procurement agencies, to increase their ability to opt for innovative solutions and ensure the structural implementation of
the principle of the most economically advantageous offer, so as to guarantee the quality of the service provided.
4A more balanced approach to lawmaking and a break in the business regulatory framework.
If the EU is to continue to be a model for combining economic growth with social prosperity and equity, it is of paramount importance that the prerogatives of the Treaties regarding the distribution of competencies between the EU and member states are fully respected. In this context, it should be noted that a number of initiatives have been taken in the field of corporate reporting during the 2019-2024 term, creating a significant amount of new regulatory obligations, the real impact of which on business conduct is still
unknown. European companies need sufficient time to adapt to this new reality, and in general to all new regulations that have a significant impact on their business activities, and policymakers need time to assess the actual consequences - both in terms of the effectiveness of the policy measures and the burden on business - of their measures. In fact, from a general point of view, introducing new regulations without first thoroughly evaluating the effectiveness of measures already in place risks creating a confusing business environment, affecting the EU’s global competitiveness as an attractive place to create new opportunities for economic growth and prosperity.
5 Advancing toward a strategic environmental transition: accelerating change

44 DIMENSIONE PULITO | 04/2024
FACILITY MANAGEMENT
with business-friendly measures. The effects of climate change and global warming are the focus of the paper. We are facing a reality that affects our daily lives, everywhere in Europe and around the world. Accelerating our efforts toward a greener and more efficient way of producing and conducting our economic activity is a necessity; however, this must be done in full agreement and coordination with the business community, setting stricter environmental standards that are technically feasible and competitively-proof. It is also essential for policy to look without bias at all solutions by applying the principle of technology neutrality. The cleaning industry, in particular, is part of a value chain that includes the chemical industry, which produces detergents, and manufacturers of cleaning machines. It is concretely committed to reducing the overall carbon and resource footprint in its business. For example, by limiting water consumption, using greener cleaning products, and adopting new techniques, materials, and procedures, including in the organizational and logistical dimensions of its work.
6
Recognize the contribution of housekeeping and facility management to EE policy on building efficiency on waste management.
Action needs to be taken on the EU’s current building stock to make it more efficient, smarter, and greener: indeed, this is one of the pillars on which the European Green Deal is based and will be an important area of policy intervention in the next institutional cycle. Numerous goals have been set by the European Union, through various pieces of legislation (Energy Performance of Buildings Directive, Renovation Wave, etc.) that intervene on a variety of dimensions. Cleaning activities provide a privileged operational context for gathering information on the energy efficiency and general condition of

buildings and help transform existing buildings, making them smarter. In addition, the impact of greener and more sustainable cleaning practices on the overall GHG performance of buildings can be significant. Finally, waste sorting is mainly ensured by cleaning staff, who are the key link between consumers who generate waste and waste treatment companies, and are essential to ensure that recycling is carried out properly.
7
Labor and employment legislation cannot disregard real market conditions for economic operators.
During the current institutional term, several important pieces of EU legislation have been introduced in the social and employment fields. In developing its new social policy agenda, it is requested that the next European Commission b even more attentive to the comments raised by the social partners, viewing them as the most reliable witnesses to the market and employment realities in which the proposed regulations will operate. As the outgoing European Commission has repeatedly affirmed its strong commitment to strengthening EU social dialogue, actors in the next policy cycle are urged to continue to demonstrate this commitment in their practice. In the future, a review of social burdens should accompany
any new legislative proposal from the European Commission to ensure that the actual impacts on businesses are not forgotten, with particular attention to SMEs, whose definition at the European level should be revised to include criteria better suited to the specificity of labor-intensive ones.
8Facilitating training opportunities for all.
Despite being traditionally a labor-intensive sector, the cleaning and facility management industry is experiencing a major transition to an increasingly high level of technological development, requiring the acquisition of new skills and improved training opportunities. Acquiring new skills, especially in the field of green and digital transition - as evidenced by the ongoing EU-funded SK-CLEAN II project - and facilitating the recognition of informally acquired skills on the job contribute greatly to improving the attractiveness of a sector such as ours, which represents a first-class opportunity for many to find stable and legal employment. Cleaning enterprises need the right support from policymakers to integrate the training dimension as a new determinant component of their job retention policy, in cooperation with educational institutions, public and private employment services and workers’ organizations.
45 DIMENSIONE PULITO | 04/2024
DA EFCI LE PRIORITÀ PER UN’INDUSTRIA
COMPETITIVA, SOSTENIBILE ED EFFICIENTE
La Federazione che dà voce al comparto delle pulizie e del facility management in Europa intende fornire un preciso quadro di riferimento alle nuove istituzioni, in modo da orientarne al meglio l’azione
Maurizio Pedrini
Le otto priorità elencate da EFCI coprono una serie di temi di fondamentale importanza per un settore, quello delle pulizie industriali, che nell’ambito dell’Unione Europea, può contare su un fatturato di 120 miliardi di euro e circa 3,7 milioni di addetti. Senza contare che più del 90% delle imprese di pulizia nell’UE ha un numero di addetti compreso fra 1 e 49 persone. I temi indicati, come preminenti, da affrontare al più presto per garantire un equilibrato e proficuo sviluppo al settore vanno dall’impatto della normativa sugli appalti pubblici, con la necessità di rivederne le regole, al contributo che le attività di pulizie possono garantire nel sostenere la transizione ambientale. La Federazione che dà voce all’industria del Cleaning e del Facility Management in Europa, attraverso la voce del suo presidente, Lorenzo Mattioli, si dichiara disponibile a discutere con gli altri rappresentanti dell’economia e della società, oltre che con gli attuali e con i prossimi deputati al Parlamento europeo e ai rappresentanti della Commissione europea sui punti trattati nel documento. Non solamente nell’interesse immediato dell’industria, ma anche a beneficio di tutti quegli europei che devono prosperità economica, integrazione sociale e benessere personale al lavoro fornito ogni giorno dagli addetti a questo prezioso comparto economico. Ma esaminiamo nel dettaglio i punti affrontati.
1L’industria del servizi, ad alta intensità di manodopera, contribuisce allo sviluppo economico e all’integrazione sociale. Tra i molti eventi che hanno caratterizzato gli sviluppi economici e sociali degli ultimi cinque anni – si afferma – la pandemia da Covid ha dimostrato l’incredibile contributo dell’industria delle pulizie al regolare funzionamento delle nostre società. Ora che l’urgenza della crisi lascia spazio alla necessità di trarre le giuste lezioni e di adattarsi ad esse, è necessario trasformare l’attenzione che il nostro lavoro ha ricevuto in un riconoscimento più strutturale da parte della politica del fatto che i servizi ad alta intensità di manodopera non sono una merce,
ma una componente fondamentale dell’attività economica complessiva. Con le trasformazioni demografiche e l’emergere di nuove forme di lavoro e di vita, è necessario un cambiamento di paradigma per far sì che il lavoro svolto dalle imprese possa non solo contribuire alla creazione di ambienti sani, sicuri e piacevoli, in cui le persone e le economie possano prosperare, ma sia anche percepito come altrettanto favorevole alla crescita economica, alla stabilità sociale e alla resilienza globale del resto del settore terziario e manufatturiero. Da qui la richiesta avanzata alle forze politiche dell’UE di abbracciare questa realtà e di riflettere tale consapevolezza nel modo in cui sarà strutturata la prossima Commissione europea, elabo -
rando un portafoglio specifico e distinto, dedicato all’industria dei servizi ad alta intensità di manodopera, che si rifletta nell’organizzazione interna dei servizi della CE.
2Integrare la dimensione dell’igiene nella politica di salute pubblica dell’UE. La pandemia e la necessità di rafforzare la capacità dell’UE di reagire rapidamente alle minacce sanitarie hanno portato alla creazione dell’HERA e hanno avviato un serio dibattito sulla necessità di progredire nella creazione di un’unione sanitaria europea. La salute pubblica, si afferma, sta diventando sempre più una competenza dell’UE, con nuove responsabilità centralizzate in termini di approvvigionamento,

46 DIMENSIONE PULITO | 04/2024
FACILITY MANAGEMENT
Discover MP-HT’s new advanced sweepers at Interclean

From May 14th to 17th, MPHT will be at Interclean to present two fully evolved ride-on sweepers.
The new machinery boasts technologically advanced systems and embodies MP-HT’s core objectives: building collaborative sweepers, designed to increase
productivity, simplify management, and promote social and environmental benefits simultaneously.
Among the new features is the adoption of electrical components with a lower voltage, at 24V instead of the 36V more commonly used in machines of this size.
Scopri le nuove spazzatrici evolute di MP-Ht a Interclean
Dal 14 al 17 Maggio, MP-HT sarà a Interclean e presenterà due nuove spazzatrici uomo a bordo completamente evolute. Tra le novità c’è l’adozione di com-
ponenti elettrici con un voltaggio inferiore, a 24V anziché i 36V più comunemente usati in macchine di queste dimensioni. Una scelta per una maggiore
semplicità d’uso, flessibilità di gestione e per costi inferiori. Un’azienda impegnata non solo verso l’innovazione, ma anche verso la sostenibilità e il be-



A choice for greater ease of use, management flexibility and cost reduction.
A company committed not only to innovation but also to sustainability and the wellbeing of people. Visit MPHT’s stand at booth 7, stand 425, for a firsthand experience of the new sweepers.
nessere delle persone. Visita lo stand di MP-HT al padiglione 7, stand 425, per vivere in anteprima l’esperienza delle nuove spazzatrici.


mp-ht.it
sponsored content
RELIABLE SWEEPERS, MADE TO LAST. www.mp-ht.it MP-HT S.r.l. | Via Tamburin, 19 35010 Limena (Padua) - Italy | +39 049 796 8360
controllo delle malattie e reazione alle emergenze. Tuttavia, l’approccio dell’UE manca di una dimensione significativa della prevenzione e del controllo delle epidemie: la fornitura di servizi regolari di pulizia e sanificazione. Da qui la richiesta alla prossima Commissione europea di integrare questo aspetto nel futuro aggiornamento della sua politica di salute pubblica, anche sviluppando un sistema per garantire criteri minimi per la preparazione alle emergenze sanitarie degli Stati membri che integrino la fornitura di requisiti standard di sanificazione, nonché l’inclusione dei servizi di pulizia (e degli attori) nei piani di emergenza e continuità.
3Nuove regole per gli appalti pubblici. Per il settore delle pulizie industriali, e per molte altre industrie di servizi ad alta intensità di manodopera i clienti del settore pubblico rappresentano una quota significativa del fatturato, in alcuni casi pari al 50%. Mentre le disposizioni in materia di appalti sono decise principalmente a livello nazionale, le norme dell’UE definiscono il quadro generale in cui gli Stati membri possono operare e possono quindi già essere elaborate in maniera tale da garantire che alcune delle distorsioni più impattanti nelle pratiche di appalto siano escluse fin dall’inizio. Si chiede una revisione che rifletta le specificità degli appalti di servizi ad alta intensità di manodopera e rispecchi adeguatamente l’attuale realtà di condizioni economiche e di mercato più volatili e soggette all’inflazione: principi come l’obbligo di revisione dei prezzi negli appalti aggiudicati in caso di aumenti eccessivi dei prezzi, o in seguito a modifiche della legislazione che hanno un impatto sui salari, dovrebbero essere chiaramente inclusi in qualsiasi proposta di revisione della direttiva. Infine, la revisione deve includere un chiaro sostegno alla professionalizzazione delle agenzie di appalto, per aumentare la loro capacità di optare per soluzioni innovative e garantire l’attuazione strutturale del principio dell’offerta economicamente più vantaggiosa, in modo da garantire la qualità del servizio fornito.
4Un approccio più equilibrato all’attività legislativa e una pausa nel quadro normativo delle imprese.
Se l’UE deve continuare a rappresentare un modello per combinare la crescita economica con la prosperità sociale e l’equità, è di fondamentale importanza che le prerogative dei Trattati relative alla distribuzione delle competenze tra l’Unione europea e gli Stati membri siano pienamente rispettate. In questo contesto, va notato che nel corso del mandato 2019-2024 sono state adottate diverse iniziative nel campo della rendicontazione per le imprese, creando una significativa quantità di nuovi obblighi normativi, il cui impatto reale sulla condotta delle imprese è ancora sconosciuto. Le aziende europee hanno bisogno di un tempo sufficiente per adattarsi a questa nuova realtà, e in generale a
tutte le nuove normative che hanno un impatto significativo sulle loro attività economiche, e i responsabili politici hanno bisogno di tempo per valutare le conseguenze effettive - sia in termini di efficacia delle misure politiche che di oneri per le imprese - delle loro misure. Da un punto di vista generale, infatti l’introduzione di nuove norme senza aver prima valutato a fondo l’efficacia delle misure già in precedenza, rischia di creare un ambiente imprenditoriale confuso, incidendo sulla competitività globale dell’UE come luogo attraente per creare nuove opportunità di crescita economica e prosperità.
5Avanzare verso una transizione ambientale strategica: accelerare il cambiamento con misure favorevoli alle imprese. Gli effetti del cambiamento climatico e del riscaldamento globale sono al centro dell’attenzione del documento. Siamo di fronte ad una realtà che influenza la nostra vita quotidiana, ovunque in Europa e nel mondo. Accelerare i nostri sforzi verso un modo più ecologico ed efficiente di produrre e svolgere la nostra attività economica è una necessità; tuttavia ciò deve essere fatto in pieno accordo e coordinamento con la comunità imprenditoriale, stabilendo standard ambientali più severi, che siano tecnicamente fattibili e a prova di competitività. È inoltre essenziale che la politica guardi senza preconcetti a tutte le soluzioni applicando il principio della neutralità tecnologica. L’industria delle pulizie, in particolare, fa parte di una catena di valore che comprende l’industria chimica, produttrice di detergenti, e i produttori di macchine per la pulizia. Essa è impegnata concretamente a ridurre l’impronta di carbonio e di risorse complessive nella sua attività. Ad esempio limitando il consumo di acqua, ricorrendo a prodotti per la pulizia più ecologici e adottando nuove tecniche, materiali e procedure, anche nella dimensione organizzativa e logistica del suo lavoro.
6Riconoscere il contributo delle pulizie e del Facility Management alla politica dell’EE sull’efficienza degli edifici sulla gestione dei rifiuti.
Occorre intervenire sull’attuale patrimonio edilizio dell’UE per renderlo più efficiente, più smart e più verde: si tratta infatti di uno dei pilastri su cui si basa il Green Deal europeo e rappresenterà nel prossimo ciclo istituzionale un importante ambito di intervento politico. Numerosi obiettivi sono stati fissati dall’Unione Europea, attraverso diversi atti legislativi (Direttiva sul rendimento energetico degli edifici, Renovation Wave, ecc.) che intervengono su svariate dimensioni. Le attività di pulizie offrono un contesto operativo privilegiato per la raccolta di informazioni sull’efficienza energetica e sullo stato generale degli edifici e contribuiscono a trasformare gli edifici esistenti, rendendoli più smart. Inoltre, l’impatto di pratiche di pulizia più ecologiche e sostenibili
sulle prestazioni complessive delle emissioni di gas serra degli edifici può essere significativo. Infine, la differenziazione dei rifiuti è garantita principalmente dal personale addetto alle pulizie, che rappresenta il collegamento fondamentale tra i consumatori che producono rifiuti e le imprese di trattamento degli stessi, ed è essenziale per garantire che il riciclaggio venga effettuato correttamente.
7La legislazione in materia di lavoro e occupazione non può prescindere dalle reali condizioni di mercato per gli operatori economici. Nel corso dell’attuale mandato istituzionale, sono stati introdotti diversi importanti atti legislativi dell’UE in campo sociale e occupazionale. Nell’elaborare la sua nuova agenda di politica sociale, si chiede che la prossima Commissione europea sia ancora più attenta alle osservazioni sollevate dalle parti sociali, considerandole come i testimoni più affidabili della realtà del mercato e dell’occupazione in cui opererà la regolamentazione proposta. Poiché la Commissione europea uscente ha ripetutamente affermato il suo forte impegno per il rafforzamento del dialogo sociale dell’UE, si invitano gli attori del prossimo ciclo politico a continuare a dimostrare tale impegno nella loro pratica. In futuro, una verifica degli oneri sociali dovrebbe accompagnare ogni nuova proposta legislativa della Commissione europea, per garantire che non vengano dimenticati gli effettivi impatti sulle imprese, con particolare attenzione alle PMI, la cui definizione a livello europeo dovrebbe essere rivista per includere criteri più adeguati alla specificità di quelle ad alta intensità di manodopera.
8Facilitare le opportunità di formazione per tutti.
Nonostante sia tradizionalmente un settore ad alta intensità di manodopera, l’industria delle pulizie e del Facility Management sta conoscendo una transizione importante verso un livello di sviluppo tecnologico sempre più elevato, che richiede l’acquisizione di nuove competenze e il miglioramento delle opportunità di formazione. L’acquisizione di nuove competenze, soprattutto nel campo della transizione verde e digitale - come dimostra il progetto SK-CLEAN II attualmente in corso, finanziato dall’UE - e la facilitazione del riconoscimento delle competenze acquisite in modo informale sul lavoro contribuiscono notevolmente a migliorare l’attrattiva di un settore come il nostro, che rappresenta per molti un’opportunità di primo livello per trovare un’occupazione stabile e legale. Le imprese del settore delle pulizie hanno bisogno del giusto sostegno da parte dei politici per integrare la dimensione della formazione come una nuova componente determinante della loro politica di mantenimento del lavoro, in collaborazione con gli istituti di istruzione, i servizi per l’impiego pubblici e privati e le organizzazioni dei lavoratori.t
48 DIMENSIONE PULITO | 04/2024
FACILITY MANAGEMENT
DULEVO. A Step into the Future of Industrial Innovation with Kronos

Dulevo International SpA, founded in 1976, is a leading manufacturer of street and industrial sweepers known for their high cleaning efficiency, particularly recognized for use in toughest conditions. With a focus on sustainability, thanks to their mechanical-suction-filtering technology, Dulevo machines lower water consumption, minimize dust
emissions and offer low or no exhaust emissions. Recognizing its commitment to sustainability and development, the Fayat Group, a French player in the construction industry, acquired Dulevo in 2021 with the intention of revitalizing the industrial sweeper business as well. The new business development manager for the industrial line,
Amaury La Fonta, tells us about Dulevo’s renewed commitment to the sector: “Joining Dulevo from the automotive industry in 2023, I led the strategic planning to strengthen the distribution network and revitalize the product range. This effort led to the presentation of the Kronos project at this edition of Interclean. This concept, which will be previewed at the event, embodies Dulevo’s vision for the future, with a focus on sustainability, efficiency and cutting-edge technology. Equipped with advanced features such as an ergonomic cockpit, a high-tech dashboard, and the possibility of autonomous driving, Kronos shows Dulevo’s commitment to excellence and continuous innovation. Although Kronos is not yet a production-ready proto-
type, it serves as a demonstration of Dulevo’s vision, with plans to introduce revised end products by 2025. The feedback gathered at Interclean will help refine the rearrangement of the entire range.”


Dulevo International SpA, fondata nel 1976, è leader nella produzione di spazzatrici stradali e industriali note per la loro elevata efficienza di pulizia, particolarmente riconosciute per l’impiego nelle condizioni più gravose. Con un focus sulla sostenibilità, grazie alla loro tecnologia meccanica-aspirante-filtrante, le macchine Dulevo abbattono il consumo di acqua, riducono al minimo le emissioni di polveri e offrono emissioni di scarico basse o nulle. Rico-
noscendo il suo impegno per la sostenibilità e lo sviluppo, il Gruppo Fayat, un protagonista francese nel settore delle costruzioni, ha acquisito Dulevo nel 2021, con l’intenzione di rilanciare anche il comparto delle spazzatrici industriali. Il nuovo responsabile dello sviluppo commerciale della linea industriale, Amaury La Fonta, ci racconta il rinnovato impegno di Dulevo nel settore: “Entrando a far parte di Dulevo dall’industria automobilistica nel 2023,
ho guidato la pianificazione strategica per rafforzare la rete di distribuzione e rivitalizzare la gamma di prodotti. Questo sforzo ha portato alla presentazione del progetto Kronos in questa edizione di Interclean. Questo concept, che sarà presentato in anteprima durante l’evento, incarna la visione di Dulevo per il futuro, con un’attenzione particolare alla sostenibilità, all’efficienza e alla tecnologia all’avanguardia. Dotato di caratteristiche avanzate
come un cockpit ergonomico, un cruscotto high-tech e la possibilità di guida autonoma, Kronos mostra l’impegno di Dulevo per l’eccellenza e l’innovazione continua. Sebbene Kronos non sia ancora un prototipo pronto per la produzione, serve come dimostrazione della visione di Dulevo, con intenzione di introdurre prodotti finali rivisitati entro il 2025. I feedback raccolti ad Interclean aiuteranno a perfezionare il riassetto dell’intera gamma.”
sponsored content
dulevo.com
DULEVO. Un Salto nel Futuro dell’Innovazione Industriale con Kronos
Amaury La Fonta, Indoor Business Line Manager
Italian Golden Suppliers
On the eve of the opening of Interclean 2024, scheduled to take place in Amsterdam from Tuesday, May 14, to Friday, May 17, we met with Giuseppe Riello, president of AFIDAMP, to recount the "journey" to discover Italian companies
Maurizio Pedrini
Astrong, dynamic and green-oriented production sector, fully aware of its relevance to the Italian economy.
This is the positive perception offered by the professional cleaning sector, which is still growing, on the eve of the opening of Interclean 2024, the great international showcase in Amsterdam that has always seen made in Italy and its companies as the absolute protagonists of the great exhibition showcase. On the eve of this highly anticipated event, we interviewed Giuseppe Riello, president of AFIDAMP, the Association of Italian Manufacturers and Distributors of Machines, Products and Tools for Professional Cleaning, which at this edition intends to make our manufacturers even more protagonists with a major communication project for our exhibitors.
Interclean has always represented the most important event for Italian
manufacturers of professional hygiene technologies. With what initiatives and expectations will AFIDAMP be present at this international showcase?
"The Dutch event constitutes an important stage for all Italian companies in the cleaning sector. Suffice it to say that our country is the first represented at the fair in terms of number of exhibiting companies, 144, and square meters occupied, more than 9,000. It is therefore essential that our association be present with projects and initiatives that know how to promote the Italian presence at the fair and

50 DIMENSIONE PULITO | 04/2024
MADE IN ITALY
give even greater value to a sector that represents a spearhead for our economy. For the 2024 edition AFIDAMP has been working on an important project for the benefit of all Italian companies present. A project that sees the significant involvement of the ICE Agency, with which we have built a communication path that will guide visitors, from the moment they enter the fair, to discover the Italian companies present. The formula, named Italian Golden Suppliers, allows to generate a virtuous path that highlights and enhances the Italian companies in the cleaning sector, through dedicated materials. This work is the result of the association's commitment and the action of its International Affairs Working Group, which has directed state funding to our sector. Italian visitors and exhibitors will also have at their disposal a Lounge on the second floor on the Balcony between Hall 1 and 5, also managed by AFIDAMP and the ICE Agency, which is intended to be a place to meet, exchange information, network and do business. Let us also not forget that AFIDAMP will also be present with its usual institutional desk in the area dedicated to associations, in Hall 03."
 Giuseppe Riello, president of AFIDAMP
Giuseppe Riello, president of AFIDAMP
The professional cleaning market seems to have finally left the troubled pandemic period behind, but it is now facing a very difficult macroeconomic picture because of the war scenarios. What is your analysis of the present and outlook?
"Precisely the International Affairs Working Group is very active in this direction, through constant monitoring of the international situation, the response of foreign markets and the opportunities to be developed. The relationship built with Agenzia ICE allows us to work effectively in this direction. In fact, AFIDAMP has submitted its development strategy to the Agency in order to obtain funding for the sector on future international projects. We also participate in the Tables of MAECI (Ministry of Foreign Affairs and International Cooperation), moments of confrontation with the Ministry itself and with other industrial associations to define a proper export strategy and presence in the main markets of interest for our country. Among the issues we address are the need to facilitate market access by member companies, analysis of target countries on which manufacturers are asking for insights and data, and development opportunities in African markets."
Let's come to export, a topic that has always seen the made-in-Italy product in the sector as a protagonist, thanks to the extraordinary dynamism and resourcefulness of our companies: do you think our production is still competitive?
Based on what assumptions?
“Italian companies in the professional cleaning sector have always been excellent at an international level, with export shares increasing year after year, despite the difficulties. A sign that the quality they know how to produce is recognized and appreciated. Our country today represents the third largest supplier in the world, precisely

because our companies also know how to be versatile, adapting very quickly to the changes imposed by international scenarios, without losing quality. Furthermore, as we well know, they are particularly attentive to environmental
Italy is the first country represented at the fair in terms of number of exhibiting companies, 144, and occupied square meters, over 9,000. It is therefore essential that our association is present with projects and initiatives that can promote the Italian presence at the fair and give even greater value to a sector that represents a spearhead for our economy
51 DIMENSIONE PULITO | 04/2024
issues and know how to respond quickly to Europe's requests in this direction, adapting their production, demonstrating that they understand the competitive advantage linked to the ecological transition. A clear example of this is the Product Category Rule for scrubbing machines, strongly desired and drawn up by AFIDAMP, which allows manufacturing companies in the sector to start a product certification process according to the Made Green in Italy scheme. A very important step which, for the first time ever, allows us to objectively demonstrate the environmental impact of these machines".
So, can we be quite calm because Italian production is destined to remain competitive in the global market, also thanks to green cleaning?
“Of course we are still extremely competitive and I am convinced that we will be so in the future too: in the
years to come our industries will be called upon to make great efforts and considerable economic investments to face truly fierce competition and the emerging needs of increasingly attentive and selective markets . In particular, we will have to focus maximum attention on green cleaning. Also because regulations, large international players and customer demand itself require production that makes the best use of recycled plastics and tools, which are fully sustainable. Over the last decade, ecological sensitivity has grown enormously and the effort required of our producers to combine cleanliness and environmental protection has become increasingly concrete and pressing. The acronym ESG (Environmental, Sustainability, Governance) appears destined to become increasingly popular and is already characterizing the strategies and communication of companies and organizations in many different sectors, including ours. The categorical imperative is that of the circular economy which postulates the recovery and recycling of water and materials. All this, however, with a view to the socalled ecological transition which has a cost and we will have to understand as soon as possible how many companies within our sector will actually be able to access this new form of production and distribution."
Among the problems that most distress industrialists in the sector are undoubtedly those of ac -
cess to energy resources and raw materials, especially rare ones. What strategies should be adopted, in the short, medium term?
“Collaboration with institutions and the ability, at association level, to make their requests and needs understood are of fundamental importance. In this direction, in fact, we have been operating for some time in close synergy with the ICE Agency and with the MAECI, making the voice of a strong and representative sector heard for the economy of the entire country.
The growth that AFIDAMP is having allows us to be more representative in the most important contexts in Italy and Europe and we are also working on this issue.”
What is the secret of an association like AFIDAMP, certainly capable of best representing the interests and expectations of its members?
“I think that the strength of an association is given by its ability to be an interpreter and voice for the companies it represents, to gather their main needs and know how to translate them into activities and projects for common growth. This is generally the strategy that must be adopted, making an associative body truly representative of the needs of its members. It is precisely starting from the analysis of the needs of the members that we have started a project which is close to the final phase: the establishment of a new working group dedicated to services, made up of supplier partners capable of providing new services to the members, some included in the membership fee for others in agreement. The aim is to facilitate the paths of penetration towards new markets, to provide different growth prospects and create new business opportunities, responding perfectly to the mission of the association, aimed at raising the quality of the market and spreading our Made in Italy in the world."
52 DIMENSIONE PULITO | 04/2024
MADE IN ITALY
Clean air gives us life, let’s not forget that

RCM sweepers are the ideal solution to clean surfaces reducing the pollution in the air we breathe. Because of innovative technology, they assure high cleaning efficiency, minimizing dust dispersal in the environment. Equipped with advanced-material filters and powerful suction systems, RCM sweepers efficiently collect and retain particles preventing them to be released into the air. This way,
the cleaning process becomes not only more efficient, but also healthier for everyone nearby.
In particular, the applications used on RCM sweepers include:
Suction on the side brushes: The Dust Buster system prevents small dust particles to be raised by the side brushes while rotating, improving the cleaning performance and operator comfort.

Large filtering surface: One of the largest filtering surfaces in the market segment, and sack or cartridge filters to ensure perfect dust vacuuming.
Filters cleaning: Filters are easily cleaned by pressing a button and, for exceptional cleaning (every 200 hours), filters can be cleaned without being removed, quickly and without getting dirty, using a simple vacuum cleaner and the provided special tool.
Vacuum on hopper: The dust raised during the hopper discharge (hydraulic dumping) is vacuumed up by the same filtering system used during sweeping. It doesn’t pollute the air, especially indoors.
So, next time you need to clean the floor from debris and dust, make sure you use an RCM sweeper to guarantee a clean and healthy environment for you and for others persons.
Le motoscope RCM rappresentano la soluzione ideale per pulire i pavimenti senza inquinare l’aria che respiriamo. Grazie alla loro tecnologia innovativa, garantiscono un’efficienza di pulizia superiore, riducendo al minimo la dispersione di polveri nell’ambiente. Dotate di filtri avanzati e sistemi di aspirazione potenti, le motoscope RCM catturano efficacemente le particelle di sporco senza rilasciarle nell’aria. In questo modo, il
processo di pulizia diventa non solo più efficace, ma anche più sano per chiunque si trovi nei paraggi. Nello specifico, le applicazioni utilizzate sulle motoscope RCM includono: Aspirazione sulle spazzole lateriali: Dust Buster elimina la polvere più sottile sollevata dalle spazzole laterali quando sono in azione migliorando il grado di pulizia dell’ambiente e il confort dell’operatore. Grande superficie filtrante: Una superfi-
cie filtrante tra le maggiori nel suo segmento di mercato e filtri a tasche o a cartuccia per assicurare una perfetta aspirazione della polvere in ogni situazione. Pulizia filtri: I filtri normalmente si puliscono premendo un pulsante ma per la pulizia straordinaria (ogni 200 ore) i filtri si puliscono senza doverli smontare, con rapidità e senza sporcarsi, grazie a un tubo speciale in dotazione a un semplice aspirapolvere.
Aspirazione sul contenitore: La polvere che si solleva durante lo scarico del contenitore (scarico alto), viene aspirata dallo stesso apparato filtrante che funziona durante lo spazzamento. Non inquina l’aria specialmente negli ambienti chiusi. Quindi, la prossima volta che devi pulire un pavimento, assicurati di utilizzare una motoscopa RCM per garantire un ambiente pulito e salutare per te e per gli altri.
sponsored content
rcm.it
L’aria pulita ci dà vita, non dimentichiamolo
RCM DUEMILA Sweeper
RCM MILLE Sweeper
Piccola, funzionale e performante!
La famiglia delle macchine Adiatek si amplia: coral 50 è la lavasciuga industriale uomo a bordo più piccola e compatta della gamma Adiatek! Il design ricercato, l’ergonomia di guida e l’elevata efficacia di pulizia contraddistinguono questa macchina sul mercato. La produttività, la semplicità d’utilizzo e la maneggevolezza rendono questa lavasciuga particolarmente adatta alla pulizia dei pavimenti di spazi stretti e ingombrati come supermercati, piccolamedia industria, magazzini, scuole e palestre!

www.adiatek.com
Tergipavimento nuovo e funzionale: il tergipavimento, posizionato appena dietro alla spazzola, ruota insieme alla macchina, garantendo un’alta qualità di pulizia e di asciugatura, anche in curva. Grazie al nuovo sistema sgancio rapido, la manutenzione è semplice ed efficace!
360° di sterzata: grazie alle dimensioni ridotte e all’agilità di sterzata, la macchina è in grado di ruotare su sé stessa.
La nuova lavasciuga coral 50!
In esclusiva a ISSA Interclean Amsterdam



• Sistema sgancio-rapido
• Design innovativo ed ergonomico
• Semplicità e comodità di guida
• Silenziosità e alte performance
• Elevata produttività
La lavasciuga coral 50 si differenzia sul mercato per la grande e comoda plancia comandi.
Adiatek, da sempre, punta sull’ergonomia, garantita anche da un’interfaccia d’uso semplice e intuitiva, con i principali comandi a portata di mano.
1335x702x1216: le dimensioni compatte rendono coral 50 particolarmente agile, nonché funzionale e adatta ad ambienti di lavoro ristretti.

ITALIAN GOLDEN SUPPLIERS
Alla vigilia dell’apertura di Interclean 2024, in programma ad Amsterdam da martedì 14 a venerdì 17 maggio, abbiamo incontrato Giuseppe Riello, presidente di AFIDAMP per raccontare il “viaggio” alla scoperta delle aziende italiane
Maurizio Pedrini
Un settore produttivo forte, dinamico e proiettato al green, pienamente consapevole della sua rilevanza per l’economia italiana. È questa la positiva percezione che offre il comparto della pulizia professionale, ancora in crescita, alla vigilia dell’apertura di Interclean 2024, la grande vetrina internazionale che ad Amsterdam vede da sempre il made in Italy e le sue aziende protagonisti assoluti della grande vetrina espositiva. Alla vigilia di questo attesissimo evento, abbiamo intervistato Giuseppe Riello, presidente di AFIDAMP, l’Associazione dei Fabbricanti e Distributori Italiani di Macchine, Prodotti e Attrezzi per la Pulizia Professionale e l'Igiene degli ambienti che a questa edizione intende rendere ancor più protagonisti i nostri produttori con un grande progetto di comunicazione per i nostri espositori.
Da sempre Interclean rappresenta l’appuntamento più importante per i produttori italiani di tecnologie per l’igiene professionale. Con quali iniziative e aspettative AFIDAMP sarà presente a questa vetrina internazionale?
“La manifestazione olandese costituisce un palcoscenico importante per tutte le aziende
italiane del comparto del cleaning. Basti pensare che il nostro Paese è il primo rappresentato in fiera per numero di aziende espositrici, 144, e di metri quadri occupati, oltre 9.000. È quindi fondamentale che la nostra associazione sia presente con progetti e iniziative che sappiano promuovere la presenza italiana in fiera e dare ancora maggior valore a un settore che rappresenta una punta di diamante per la nostra economia. Per l’edizione 2024 AFIDAMP ha lavorato a un progetto importante a favore di tutte le imprese italiane presenti. Progetto che vede il significativo coinvolgimento dell’Agenzia ICE, con la quale abbiamo costruito un percorso di comunicazione che guiderà i visitatori, fin dall’ingresso in fiera, alla scoperta delle aziende italiane presenti. La formula, che prende il nome di Italian Golden Suppliers, permette di generare un percorso virtuoso che evidenzia e valorizza le aziende italiane del comparto del cleaning, attraverso materiali dedicati. Questo lavoro è frutto dell’impegno dell’associazione e dell’azione del proprio Gruppo di Lavoro Affari Internazionali che ha indirizzato i finanziamenti dello Stato verso il nostro settore. Visitatori ed espositori italiani avranno inoltre a disposizione una Lounge al primo piano sul Balcony tra la Hall 1 e la 5, gestita sempre da AFIDAMP e Agenzia ICE, che vuole essere un luogo di incontro, di scambio di informazioni, di networking e di business. Non dimentichia-
mo poi che AFIDAMP sarà presente anche con il consueto desk istituzionale nell’area dedicata alle associazioni, nella Hall 03.”
Il mercato del professional cleaning sembra definitivamente aver lasciato alle spalle il tormentato periodo della pandemia, ma si trova adesso a dover fare i conti con un quadro macroeconomico assai difficile, a causa degli scenari di guerra. Qual è la sua analisi del presente e delle prospettive?
“Proprio il Gruppo di Lavoro Affari Internazionali è molto attivo in questa direzione, attraverso un costante monitoraggio della situazione internazionale, della risposta dei mercati esteri e delle opportunità da sviluppare. La relazione costruita con Agenzia ICE ci permette di lavorare in maniera efficace in questa direzione. AFIDAMP ha infatti sottoposto all’Agenzia la propria strategia di sviluppo, al fine di ottenere finanziamenti per il comparto su progetti futuri internazionali. Partecipiamo inoltre ai Tavoli del MAECI (Ministero degli Affari Esteri e della Cooperazione Internazionale), momenti di confronto con il Ministero stesso e con altre associazioni industriali per definire una corretta strategia di esportazione e di presenza sui principali mercati di interesse per il nostro Paese. Tra le tematiche che affrontiamo la necessità di agevolare l’accesso ai mercati da parte delle aziende associate, l’analisi dei paesi-target

56
MADE IN ITALY

su cui i fabbricanti chiedono approfondimenti e dati e le opportunità di sviluppo sui mercati africani.”
Veniamo all’export, un tema che ha visto sempre il prodotto made in Italy del settore protagonista, grazie alla straordinaria dinamicità e intraprendenza delle nostre aziende: ritiene che la nostra produzione sia ancora competitiva? In base a quali presupposti?
“Le aziende italiane del settore del cleaning professionale sono da sempre un’eccellenza a livello internazionale, con quote di esportazione che aumentano di anno in anno, nonostante le difficoltà. Segno che la qualità che sanno produrre viene riconosciuta e apprezzata. Il nostro Paese rappresenta oggi il terzo fornitore al mondo, proprio perché le nostre imprese sanno anche essere versatili, si adattano con grande rapidità ai cambiamenti imposti dagli scenari internazionali, senza perdere in qualità. Inoltre, come ben sappiamo, sono particolarmente attente alle tematiche ambientali e sanno rispondere con rapidità alle richieste dell’Europa in questa direzione, adeguando la propria produzione, dimostrando di comprendere il vantaggio competitivo legato alla transizione ecologica. Ne è un chiaro esempio la Regola di Categoria di Prodotto per le Macchine Lavasciuga pavimenti, fortemente voluta e redatta da AFIDAMP, che consente alle aziende produttrici del settore, di avviare un processo di certificazione di prodotto secondo lo schema Made Green in Italy. Un passaggio importantissimo che, per la prima volta in assoluto, permette di dimostrare in modo oggettivo l’impatto ambientale di queste macchine”.
Quindi, possiamo stare abbastanza tranquilli perché la produzione italiana è destinata a rimanere ancora competitiva nel mercato globale, anche grazie al green cleaning?
“Certo siamo ancora estremamente competitivi e sono convinto che lo saremo anche in futuro: negli anni a venire le nostre industrie saranno chiamate a compiere grossi sforzi e notevoli investimenti economici per affrontare una concorrenza davvero agguerrita e le esigenze emergenti di mercati sempre più attenti e selettivi. In particolare, dovremo concentrare la massima attenzione verso il green cleaning. Anche perché le normative, i grandi players internazionali e la domanda stessa della clientela impongono produzioni che impieghino al meglio plastiche e strumenti riciclati, che siano pienamente sostenibili. Nell’ultimo decennio la sensibilità ecologica è cresciuta enormemente e lo sforzo richiesto ai nostri produttori per coniugare pulizia e salvaguardia dell’ambiente è divenuto sempre più concreto e pressante. L’acronimo ESG (Environmental, Sustainability, Governance) appare destinato a diventare sempre più popolare e sta già caratterizzando

le strategie e la comunicazione di aziende e organizzazioni di tanti e diversi settori, compreso il nostro. L’imperativo categorico è quello dell’economia circolare che postula il recupero e riciclo delle acque e dei materiali. Tutto questo, però, nell’ottica della cosiddetta transizione ecologica che ha un costo e dovremo al più presto capire quante aziende, all’interno del nostro comparto, potranno effettivamente essere in grado di accedere a questa nuova forma di produzione e distribuzione.”
Fra i problemi che angustiano maggiormente gli industriali del comparto, ci sono senz’altro quelli dell’accesso alle risorse energetiche e alle materie prime, specialmente rare. Quali strategie andrebbero adottate, a breve, medio termine?
“Di fondamentale importanza è la collaborazione con le istituzioni e la capacità, a livello di associazione, di fare comprendere le proprie richieste e le proprie necessità. In questa direzione, appunto, operiamo da tempo in stretta sinergia con Agenzia ICE e con il MAECI, facendo sentire la voce di un comparto forte e rappresentativo per l’economia dell’intero Paese. La crescita che AFIDAMP sta avendo ci permette di essere più rappresentativi nei contesti di maggiore rilievo in Italia e in Europa e anche
su questo tema stiamo lavorando.”
Qual è il segreto di un’associazione come AFIDAMP, capace certamente di rappresentare al meglio gli interessi e le aspettative dei propri associati?
“Penso che la forza di un’associazione è data dalla capacità di essere interprete e voce per le aziende che rappresenta, di raccogliere da loro le esigenze principali e di saperle tradurre in attività e progetti di crescita comune. È questa in generale la strategia che va adottata, rendere un organismo associativo realmente rappresentativo delle esigenze dei propri soci. È proprio partendo dall’analisi delle esigenze degli associati che abbiamo avviato un progetto che è prossimo alla fase conclusiva: la costituzione di un nuovo gruppo di lavoro dedicato ai servizi, composto da partner fornitori in grado di erogare agli associati nuovi servizi, alcuni compresi nella quota associativa altri in convenzione. Il fine è quello di agevolare le vie di penetrazione verso nuovi mercati, di fornire diverse prospettive di crescita e realizzare nuove opportunità di business rispondendo perfettamente alla mission dell’associazione, tesa all’innalzamento qualitativo del mercato e alla diffusione del nostro Made in Italy nel mondo.”
58 DIMENSIONE PULITO | 04/2024
MADE IN ITALY
Comac: 50 years of innovations in professional floor cleaning
Comac celebrates its 50th anniversary this year, a great achievement that highlights many years of excellence and innovation in the professional cleaning sector. Since 1974, Comac has been able to face many challenges, from the changing of market to the evolution of sales techniques, establishing a strong and solid link with customers and suppliers.
Over the years, large investments have been made in research and development, which have allowed Comac to design SELF.Y , the company’s great proposal for autonomous cleaning. Designed to be a collaborative and intelligent cleaning partner that combines performance and productivity to take
cleaning operations to the next level. SELF.Y knows how to adapt best to every situation and integrates perfectly into the team dedicated to the maintenance of the environments, detecting people and obstacles that are on his track to offer effective and effortless cleaning. Perfect combination of performance SELF.Y works in complete autonomy and safety, taking cleaning operations to a higher level.
To maintain the high quality standards of the company and continue to meet the changing needs of the market, Comac has designed Combimac, a new combined machine, which is born from the union on a single frame of all the knowledge of Comac re-
garding scrubbing machines and sweepers
Able to combine the characteristics of a floor scrubber with those of industrial sweepers, Combimac offers high performance in terms of cleaning efficiency and ergonomics, increasing productivity.
These new projects are just an example of Comac’s ongoing commitment to innovation, but they also represent a constant affirmation of the company’s desire to evolve and continue to grow over the years, responding to the needs of cleaning professionals.

Comac: cinquant’anni di innovazioni nella pulizia professionale dei pavimenti
Comac celebra quest’anno il suo cinquantesimo anniversario, un grande traguardo che mette in risalto i numerosi anni di eccellenza e innovazione nel settore della pulizia professionale. Dal 1974 Comac è stata capace di affrontare molte sfide, dal cambiamento del mercato, all’evoluzione delle tecniche di vendita, instaurando un legame forte e solido con clienti e fornitori. Nel corso degli anni sono stati effettuati grandi investimenti in ricerca e sviluppo, che hanno permesso a Comac di proget-
tare SELF.Y, la grande proposta dell’azienda per la pulizia autonoma. Pensato per essere un compagno di pulizia collaborativo e intelligente, è capace di combinare prestazioni e produttività per innalzare il livello degli interventi. SELF.Y sa adattarsi al meglio a ogni situazione e integrarsi perfettamente nel team dedicato alla manutenzione degli ambienti, rilevando persone e ostacoli che si trovano sulla sua pista di lavoro per offrire una pulizia efficace e senza sforzo. Perfetta
combinazione di rendimento e performance, SELF.Y lavora in completa autonomia e sicurezza, portando le operazioni di pulizia a un livello superiore. Per mantenere gli elevati standard qualitativi aziendali, e continuare a soddisfare le mutevoli esigenze del mercato, è stata progettata anche Combimac, una nuova macchina combinata, che nasce dall’unione su un unico telaio di tutte le conoscenze di Comac in merito a lavasciuga pavimenti e spazzatrici. Capace
di fondere in un solo modello le caratteristiche delle lavasciuga pavimenti con quelle delle spazzatrici, Combimac offre elevate prestazioni in termini di pulizia, efficienza ed ergonomia raddoppiando la produttività. Questi nuovi progetti sono solo un esempio del continuo impegno di Comac verso l’innovazione, ma rappresentano anche un’affermazione costante del desiderio dell’azienda di evolversi e continuare a crescere negli anni rispondendo alle esigenze dei professionisti del pulito.
informazione pubblicitaria
comac.it
ICA. Constant innovation and focus on the environment
Operating on the national and international market for 40 years, ICA is a paper converting company specialized in Away-from-Home products. The company is committed to constantly expanding its wide range of products in a perspective of constant innovation and focus on the environment to offer products that are more and more perfor-
ming, hygienic, and sustainable. Over the past few years, the company continued to pursue quality, as the certifications it obtained prove.
ICA presents the compact collection with dispensers : the ideal solution for washrooms where space is limited. Our 2-ply compact towel is soft, absor-
bent and above all practical with its 5 x 5 cm folds that make it the narrowest in its class. Its dispenser is only 8 cm deep so it is the ideal solution for bathrooms and work areas where space is limited and where the installation of a traditional dispenser would undermine the functionality and liveability of the environment. The 5-fold desi-


gn also promotes hygiene by offering a single sheet dispensing, where users only touch the sheet they take. Our two-ply pure pulp compact toilet paper is suitable for demanding high traffic washrooms. Its small core (only 2,5 cm diameter), its compactness and its double-capacity dispenser reduce run-outs and refills.

ICA. Innovazione continua e attenzione per l’ambiente
Presente da 40 anni sul mercato nazionale ed internazionale, ICA è un’azienda di trasformazione carta tissue, specializzata nella produzione di prodotti Away-from- Home. L’impegno dell’azienda è rivolto al costante ampliamento della gamma prodotti in un’ottica di continua innovazione e di particolare attenzione per l’ambiente per offrire prodotti sempre più performanti, igienici e sosteni-
bili. Negli ultimi anni, l’azienda ha continuato a perseguire la strada della qualità. Ne sono testimoni le certificazioni che, anno dopo anno, vengono conseguite.
ICA presenta i compatti con dispenser : la soluzione ideale per servizi igienici e toilette dagli spazi ridotti. Il compact towel è morbido, assorbente e soprattutto pratico con le sue 5 pieghe da 5 cm che
lo rendono il più stretto della categoria. Il suo dispenser è profondo solo 8 cm ed è la soluzione ideale per tutti i servizi igienici e le aree di lavoro in cui lo spazio è limitato e in cui l’installazione di un dispenser tradizionale andrebbe a minare la funzionalità e la vivibilità dell’ambiente. Il design a cinque pieghe promuove anche l’igiene tramite l’erogazione singola grazie alla quale si toc-
ca solo il foglietto che si usa. L’igienica compatta, in pura cellulosa a due veli, è particolarmente adatta per le aree bagno ad alta affluenza. L’anima di dimensioni ridotte (solo 2,5 cm), la compattezza del rotolo e il dispenser dedicato a doppia capacità comportano un minor rischio di esaurimento della carta, riducendo la frequenza di ricarica e manutenzione.
sponsored content
icatissue.com




New procurement code and minimum wage
The
entry into force of the New Procurement Code will have to be accompanied by a comprehensive reform of public administration.
An interview with Andrea Laguardia, National Director of Legacoop Produzione e Servizi
Maurizio Pedrini
The new Procurement Code has now been in force for a year, but there is no shortage of open issues to be addressed and resolved in order to implement it: there is a need for more qualified stations that are up to the new tasks of an important measure, which introduces for the first time a series of principles in the preamble to the Code, as if to enshrine a solemn declaration of intent that the legislature considers fundamental to its implementation. We met with Andrea Laguardia, National Director of Legacoop Produzione e Servizi, to talk about this and other issues at the center of attention in the cleaning sector.
Has the New Procurement Code changed the procurement paradigm that the public administration is required to follow? Can we briefly analyze its most qualifying contents?
"The most relevant change of course from the past is undoubtedly contained in the first part, from article
one to twelve, in which the general reference principles are defined, by which the subsequent norms are inspired. In particular, the two that deserve the most attention concern trust and result, which, precisely by the express provision of the legislature become equally substantial interpretive principles of reference, to be applied
therefore consistently in all the rules of the Code. This means that, once in court, the judge to make a decision with respect to a possible case will have a yardstick, verifying the controversy precisely through the principles themselves. In essence, where the standard fails to regulate controversies, the judge will act with that fundamental refer-
 Andrea Laguardia, National Director of Legacoop Produzione e Servizi
Andrea Laguardia, National Director of Legacoop Produzione e Servizi
62 DIMENSIONE PULITO | 04/2024
SERVICE INDUSTRY

ence source in mind. I would say that this is the real, great innovation of the New Procurement Code. A year after its implementation, principles are beginning to be applied in some of the rulings that TARs are issuing in certain parts of Italy. The most interesting aspect, for the business world and for the market of reference, is the principle of the result, in fact while the old Codein fact - regulated competition, relying precisely on this inspiring concept, now the approach of the Legislator has radically changed: with the New Procurement Code, the public administration, through public tenders, must direct the purchase of goods and services oriented to the achievement of a result."
Isn't there a risk of a repetition of the classic dissociation, which is very common in our country, between very good legislation and inadequacy - sometimes very serious - in compliance when it comes to enforcement?
"Indeed, sometimes in Italy people think to solve all issues through the sometimes sudden issuance of new codes. In the case of the Procurement Code, it must be said that the previous one dates back to 2016, so not many years had passed. It is clear that this measure, while valuable, is not enough to solve the long-standing problem of public procurement. I sincerely believe that the main problem lies in the Public Administration and the overall reform that should affect it to make it more receptive to innovation and more efficient. We are in fact talking about thousands of contracting stations, too many, because in recent years there has never been a real reform of them with the provision of reductions or aggregations. There is also a problem related to the dedicated staff in the contracting stations, which is certainly fewer in number than needed, but also of continuous training of these figures. Finally, I do not hide from you the difficulties inherent in getting the
New Procurement Code to fit into an administrative structure that has always remained the same, with the risk of thwarting the results and objectives set. So, welcome the Code, but it will have to be accompanied by a comprehensive reform of the PA."
There is no shortage of positive examples, however, that provide a benchmark to follow?
"There are really virtuous regional purchasing centers that are working well: I'm thinking of Tuscany, Emilia Romagna, but also other regions. Where there has been investment in purchasing specialization, there have been much better results. In fact, one of the most important critical issues we note in the current Procurement Code is the issue of price revision in the service sector, which has not yet been resolved. The Procurement Code has included a rule that obliges contracting stations to revise them if ISTAT increases exceed a certain threshold.
63 DIMENSIONE PULITO | 04/2024
But the most important thing to highlight is that the indices with which to calculate the rebalancing of PA contracts have yet to be defined. In this regard, intensive work is underway at the Ministry of Infrastructure involving all employer associations and including us as well. The indices are being defined here. As Legacoop Produzione e Servizi we hoped for work with a quick turnaround time, and it is to the Ministry's credit that it has put a lot of effort into this, so much so that there are almost weekly meetings. I believe that the necessary conditions are in place so that within a short time the work can be successfully concluded, with the issuance of the necessary decrees defining the indices. In some cases until now the increases were identified with standard ISTAT indices; from tomorrow - on the other hand - we count on being able to apply new indices: I am thinking first of all of catering, but also of multiservices, with respect to which we have identified weighted indices, which also cover the increase in labor costs, which, as we well know, in labor-intensive sectors is the dominant part. Ultimately, we count on the current operational criticality being overcome soon: there is an innovative norm but, to date, we do not see its concrete effects on the market because some implementing provisions are still missing."
Health care, now under indictment for shortcomings in service delivery, is undoubtedly a prime area for application of the New Procurement Code: under what conditions?
"In fact, health care is the real test case, in the sense that procurement in health care facilities is the best example to speak of both critical but also particularly positive examples. This, in fact, is the sector in which one can best see for oneself the effectiveness and efficiency of the calls for tenders that are issued. Of course, I am speaking first and foremost about the cleaning

sector: the ONBSI, (National Bilateral Body for Cleaning and Integrated Services), recently finished an interesting study on hospital infections, which can be found posted on its website. This complex investigation, carried out thanks to a scientific committee of absolute value, has shown that where health care facilities invest in highly professionalized cleaning services, including the use of new technologies, there is a considerable reduction in care-related infections in those facilities, which, I would remind you, do the same damage each year as the SARS CoV 2 pandemic, resulting in a high number of deaths in hospitals, with significant costs borne by the National Health Service. So by investing in cleaning and sanitation, we certainly contribute to reducing ICAs. Another issue, in my opinion, which is of fundamental importance for healthcare facilities, is to find ways to specialize tenders. I will try to explain myself further. Currently, the Procurement Code is an offspring of the public works culture, so it fails to intercept, through regulations, all the specificities of commodity sectors. In particular, it is unable to capture the needs of healthcare facilities. It is therefore necessary to accompany the tender process - as is the case in public tenders - with guidelines. Legacoop contrib -
uted to the development of guidelines prepared by ANMDO, the National Association of Hospital Management Doctors, which were published and subsequently approved by the National Institute of Health. In them, the standards and related controls of how cleaning services within health care facilities should be approached are clearly defined. Having certified standards as a point of reference means, first and foremost, better qualifying the market: only companies that guarantee a certain level can be submitted to those tenders and, in more advanced cases - as is happening in certain territories - to make value-oriented tenders. Which means that you don't just buy a cleaning service, but a service that can restore value to the facility. For example, a tender of this kind, involving a reduction in hospital infections, will result in the purchase of such a service with the specific goal of lowering, by a certain percentage, hospital infections. This gives rise to a very close relationship between the healthcare facility and those who perform certain cleaning services, with the result that they are fully integrated into the management of a given healthcare facility. In this context, in fact, cleaning cannot be seen as a mere commodity, but must form a whole with other hospital activities."
64 DIMENSIONE PULITO | 04/2024
SERVICE INDUSTRY
Essecinque offre tutti gli articoli per la pulizia in cotone e nelle altre fibre tessili, assieme alle attrezzature correlate.
Essecinque offers all the articles of cotton and other textile fibers with the related equipment.



di nuovi prodotti Research and development of new products



Partnership internazionali


International partnerships


65 DIMENSIONE PULITO | 04/2024
Personalizzazione del prodotto Product customization
Ricerca
Passion for cleaning. www.essecinque.net
A very hot-button issue in the sector is that of wages and the lack of consideration for the valuable work done by cleaners. This is not the case with cooperatives under Legacoop, nor with companies that operate under pay scales, but the fact is that cleaners are too often underpaid. Recently the debate on the minimum wage has been reopened: what do you think?
"The problem, as you rightly said, does not concern healthy enterprises, which operate within the labor contract. On the issue of the minimum wage we have taken an official position, expressing it in a substantial position paper, more than thirty pages long, which
can be read on our website. We believe that the minimum wage is one of the tools that can guarantee an increase in workers' wages, but not very effective if not accompanied by other reforms. Just think, if we continue to have tenders that are on the low end or that involve a few hours of work, there would certainly not be any minimum wage capable of guaranteeing adequate pay for workers. Instead, in my opinion, the real issue is to adequately grow the value of our markets by investing more."
It is already time to think about the next contract renewal, which will have to address many important issues, such as job training, occu-
pational safety and the advent of artificial intelligence…
"The current category contract will expire in July 2025, so we are well ahead of any predictions. We are waiting for the unions' platform, which should arrive within this year, and then we will start the discussion with the willingness of the social partners not to take, as was the case with the last renewal, a good eight years before reaching an agreement. I believe that both companies and trade unions, at this time of continuing uncertainties plaguing the planet, due to price changes, wars and various international turmoil, must seriously demonstrate maturity and willingness to renew contracts quickly."
SERVIZI
NUOVO CODICE DEGLI APPALTI E SALARIO MINIMO
L’entrata in vigore del Nuovo Codice degli Appalti dovrà essere accompagnata da una riforma complessiva della Pubblica Amministrazione. A colloquio con Andrea Laguardia, Direttore Nazionale Legacoop Produzione e Servizi
Maurizio Pedrini
Il nuovo Codice degli Appalti è ormai in vigore da un anno, ma non mancano le questione aperte da affrontare e risolvere per dargli attuazione: vi è la necessità di avere stazioni più qualificate e all’altezza dei nuovi compiti di un provvedimento importante, che introduce per la prima volta una serie di principi in premessa al Codice, quasi a voler sancire una solenne dichiarazione di intenti che il legislatore considera fondamentali per la sua applicazione. Abbiamo incontrato Andrea Laguardia, Direttore Nazionale di Legacoop Produzione e Servizi per parlare di questo e di altri temi al centro dell’attenzione nel settore delle pulizie.
Il Nuovo Codice degli Appalti ha cambiato il paradigma degli acquisti che la pubblica Amministrazione è chiamata a seguire? Possiamo analizzarne brevemente i contenuti maggiormente qualificanti?
“Il cambio di rotta rispetto al passato più rilevante è contenuto senz’altro nella prima parte, dall’articolo uno al dodici, in cui vengono definiti i principi generali di riferimento ai quali si ispirano le norme successive. In particolare, i due che meritano maggiore attenzione riguardano la fiducia e il risultato che, proprio per espressa previsione del legislatore diventano altrettanto sostanziali principi interpretativi di riferimento, da applicare perciò coerentemente in tutte le norme del Codice. Questo significa che, una volta in giudizio, il giudice per prendere una decisione rispetto ad un’eventuale causa, avrà un metro di giudizio, verificando il contenzioso proprio attraverso i principi stessi. In buona sostanza, laddove la norma non riesca a regolare il contenzioso, il giudice agirà tenendo presente tale fondamentale fonte di riferimento. Direi che è questa la vera, grande novità del Nuovo Codice degli Appalti. A un anno dalla sua messa in atto, si cominciano applicati i principi in qualche sentenza che in certe parti d’Italia i TAR stanno emettendo. L’aspetto più interessante, per il mondo delle imprese e per il
mercato di riferimento, è il principio del risultato, infatti mentre il vecchio Codice - di fatto - normava la concorrenza, basandosi proprio su questo concetto ispiratore, adesso è cambiato radicalmente l’approccio del Legislatore: con il Nuovo Codice degli Appalti la pubblica amministrazione, attraverso le gare pubbliche, deve orientare l’acquisto di beni e servizi orientati all’ottenimento di un risultato.”
Non c’è il rischio che si ripeta la classica dissociazione, assai frequente nel nostro Paese, tra una legislazione assai valida e l’inadeguatezza - talvolta gravissima - nel rispetto della stessa quando si tratta di applicare la normativa?
“In effetti, a volte in Italia si pensa di risolvere tutte le problematiche attraverso l’emanazione, a volte repentina, di nuovi codici. Nel caso del Codice degli Appalti, va detto che il precedente risale al 2016 e non erano dunque passati tanti anni. È evidente che non è sufficiente questo pur prezioso provvedimento, per risolvere l’annosa problematica degli appalti pubblici. Ritengo,
DETERGENT MARKET
66 DIMENSIONE PULITO | 04/2024
let ' s go green



PL A S T I C A R ICI C L ATA per un bagno eco-friendly
V E R N IC I AT U R A A D ACQ UA sicura e d e co s o stenibil e
RECYCLED PLASTIC for an eco-friendly bathroom GA M M A CO M PL E TA di a cce s s o ri p er l’igien e
WATER BASED PAINTING safe and eco -sustainable

COMPLETE RANGE of hygiene accessories

SKIN
LINE A
MAR PL AST S.p.A . | +39 0522 699200 | www.marplas t.it | D I SPENSERS
ACCESSOR IE S
&
sinceramente, che il problema principale risieda nella Pubblica Amministrazione e nella riforma complessiva che dovrebbe interessarla per renderla maggiormente recettiva dell’innovazione e più efficiente. Parliamo infatti di migliaia di stazioni appaltanti, troppe, perché in questi anni non c’è mai stata una vera riforma delle stesse con la previsione di riduzioni o aggregazioni. C’è inoltre un problema relativo al personale dedicato nelle stazioni appaltanti, che è sicuramente in numero inferiore rispetto alla necessità, ma anche di formazione continua di queste figure. Non le nascondo, infine, le difficoltà insite nel far calare il Nuovo Codice degli Appalti in una struttura amministrativa che è rimasta sempre la stessa, col rischio di vanificare i risultati e gli obiettivi prefissati. Dunque, ben venga il Codice, ma dovrà essere accompagnato da una riforma complessiva della PA.”
Gli esempi positivi, che rappresentano un punto di riferimento da seguire, comunque, non mancano?
“Esistono centrali di acquisto regionali davvero virtuose, che stanno funzionando bene: penso alla Toscana, all’Emilia Romagna, ma anche ad altre Regioni. Laddove si è investito sulla specializzazione degli acquisti, si sono ottenuti dei risultati decisamente migliori. In realtà una delle criticità più importanti che rileviamo nell’attuale Codice degli Appalti è il tema della revisione dei prezzi nel settore dei servizi, che non è stato ancora risolto. Il Codice degli Appalti ha previsto una norma che obbliga le stazioni appaltanti a rivederli nel caso gli aumenti ISTAT superino una determinata soglia. Ma la cosa più importante da evidenziare è che devono ancora essere definiti gli indici con cui calcolare il riequilibro dei contratti con la PA. Al riguardo, è in corso un’intensa attività presso il Ministero delle Infrastrutture che coinvolge tutte le associazioni datoriali e comprende pure noi. In questa sede si stanno definendo gli indici. Come Legacoop Produzione e Servizi auspicavamo un lavoro con tempi veloci e va riconosciuto al Ministero il merito di essersi impegnato parecchio in questa direzione, tant’è che si susseguono riunioni quasi settimanali. Ritengo che vi siano i necessari presupposti per far sì che entro breve tempo il lavoro possa concludersi positivamente, con l’emanazione dei necessari decreti che definiscano gli indici. In alcuni casi fino ad oggi gli aumenti erano individuati con indici standard ISTAT; da domani - invece - contiamo di poter applicare degli indici nuovi: penso anzitutto alla ristorazione, ma anche al multiservizi, rispetto al quale abbiamo individuato degli indici ponderati, i quali contemplano anche l’aumento del costo lavoro che, come ben sappiamo, nei settori labour intensive rappresenta la parte dominante. In definitiva, contiamo venga presto superata l’attuale criticità operativa: c’è una norma innovativa ma, a tutt’oggi non ne vediamo gli
effetti concreti sul mercato perché mancano ancora alcune disposizioni attuative”.
La sanità, oggi sotto accusa per la carenze nell’erogazione dei servizi, rappresenta un terreno di applicazione senz’altro privilegiato del Nuovo Codice degli Appalti: a quali condizioni?
“In effetti, la sanità costituisce il vero banco di prova, nel senso che gli appalti nelle strutture sanitarie rappresentano l’esempio migliore per parlare sia di criticità ma anche di esempi particolarmente positivi. Questo, infatti, è il settore in cui meglio si può verificare con mano l’efficacia e l’efficienza dei bandi di gara che vengono emanati. Ovviamente parlo in primis del comparto delle pulizie: l’ONBSI, Organismo Nazionale Bilaterale Servizi di Pulizia, Servizi Integrati/Multiservizi, ha di recente terminato un’interessante ricerca sulle infezioni ospedaliere, che si trova pubblicata sul suo sito. Da questa complessa indagine, effettuata grazie ad un comitato scientifico di assoluto valore, è emerso che laddove le strutture sanitarie investono in servizi di pulizia altamente professionalizzati, con l’impiego anche di nuove tecnologie, nelle stesse si abbattono considerevolmente le infezioni correlate all’assistenza che, lo ricordo, fanno ogni anno gli stessi danni provocati dalla pandemia SARS CoV 2, comportando un elevato numero di decessi negli ospedali, con costi rilevanti a carico del Servizio Sanitario Nazionale. Quindi, investendo in pulizia e sanificazione, contribuiamo certamente a ridurre le ICA. Un altro tema, a mio avviso, di fondamentale importanza per le strutture sanitarie, è quello di trovare delle forme atte a specializzare le gare d’appalto. Provo a spiegarmi meglio. Attualmente il Codice degli Appalti è figlio della cultura dei lavori pubblici, quindi non riesce a intercettare, attraverso le norme, tutte le specificità dei settori merceologici. In particolare, non è in grado di cogliere le necessità delle strutture sanitarie. È dunque necessario accompagnare il percorso di garacome avviene nella gare pubbliche - con delle linee guida. Legacoop ha dato il suo apporto alla definizione delle linee guida predisposte da ANMDO, l’Associazione Nazionale Medici Direzioni Ospedaliere, che sono state pubblicate e successivamente approvate dall’Istituto Superiore della Sanità. In esse vengono chiaramente definiti gli standard e i relativi controlli di come devono essere affrontati i servizi di pulizia all’interno delle strutture sanitarie. Avere degli standard certificati quale punto di riferimento, significa anzitutto qualificare meglio il mercato: si possono presentare a quelle gare solo le imprese che garantiscono un certo livello e, nei casi più evoluti - come sta avvenendo in certi territori - fare delle gare orientate al valore. Il che significa che non si acquista solo un servizio di pulizie, bensì un servizio capace di restituire valore alla strut-
tura. Per esempio, una gara di questo tipo, che preveda una riduzione delle infezioni ospedaliere, comporterà l’acquisto di tale servizio con il preciso obiettivo di abbattere, di una certa percentuale, le infezioni ospedaliere. Da qui nasce un rapporto molto stretto tra la struttura sanitaria e chi esegue determinati servizi di pulizia, col risultato di integrarli pienamente nell’ambito della gestione di una determinata struttura sanitaria. In tale contesto, infatti, le pulizie non possono essere viste come una semplice commodity, ma devono costituire un tutt’uno con le altre attività ospedaliere.”
Un tasto assai dolente nel settore è quello delle retribuzioni e della scarsa considerazione del prezioso lavoro svolto dagli addetti alle pulizie. Non è il caso delle cooperative che fanno capo a Legacoop, né delle aziende che operano rispettando le tabelle salariali, ma sta di fatto che i pulitori troppo spesso sono sottopagati. Di recente si è riaperto il dibattito sul salario minimo: cosa ne pensa?
“Il problema, come giustamente lei diceva, non riguarda le imprese sane, che operano nel rispetto del contratto di lavoro. Sulla questione del salario minimo abbiamo assunto una posizione ufficiale, esprimendola in un corposo position paper, di più di trenta pagine, che si può leggere sul nostro sito. Riteniamo che il salario minimo sia uno degli strumenti in grado di garantire l’aumento delle paghe dei lavoratori, ma poco efficace se non accompagnato da altre riforme. Pensi solo che, se continuassimo a fare delle gare al massimo ribasso o che prevedano poche ore di lavoro, non esisterebbe certamente alcun salario minimo capace di garantire un’adeguata retribuzione alle maestranze. Invece, a parer mio, il vero nodo da sciogliere è quello di far crescere adeguatamente il valore dei nostri mercati, investendo di più.”
È già tempo di pensare al prossimo rinnovo contrattuale che dovrà affrontare molti aspetti importanti, come la formazione professionale, la sicurezza sul lavoro e l’avvento dell’intelligenza artificiale. Ci state pensando?
“L’attuale contratto di categoria scadrà a luglio del 2025, quindi siamo in largo anticipo rispetto ad eventuali previsioni. Stiamo attendendo la piattaforma dei sindacati, che dovrebbe arrivare entro quest’anno, poi avvieremo la discussione con la volontà delle parti sociali di non impiegare, come avvenuto in occasione dell’ultimo rinnovo, ben otto anni prima di giungere ad un’intesa. Credo che sia le imprese che i sindacati, in questo momento di continue incertezze che affliggono il pianeta, a causa delle variazioni dei prezzi, delle guerre e delle varie turbolenze internazionali, debbano seriamente dimostrare la maturità e la volontà di rinnovare i contratti in tempi brevi.”
68 DIMENSIONE PULITO | 04/2024 SERVIZI
Paredes. A history started 80 years ago
Paredes’ transformation began in 2017 with a new management, ably led by Francois Thuilleur, who launched an ambitious restructuration plan. Their growth since then has been
constant and is set to continue with their new development plan Cap N°1, whose goal is to become one of the top three of the European professional hygiene market.


Paredes has celebrated 80 years of service to the professional hygiene market having grown from a family business to a Group of €220 million turnover, 650 collaborators, 2 production sites and 16 commercial and logistic sites spread between France and Italy. Their history contains important milestones such as the invention of the first single-use, paper roll for hygienic purposes and the first auto cut dispenser for hand towels. The modernisation of their commercial activities include the development of their e-shop that, paired with experts divided by client sector to consult on the most appropriate solutions for their clientele, is garnering considerable success. Paredes has always been an active spokesperson for

social and environmental issues since the launch of its Eco Attitude in 1995. These solid foundations have been built upon with the adhesion to the UN Global Compact in 2017, a Platinum EcoVadis Sustainability Rating, Social Accountability and Carbon Footprint certification for its products, to name but a few of its CSR initiatives. This development has launched Paredes to the position of modern front-runner on the European hygiene market. In fact, its development over the next few years will reach further afield; the Group is currently opening up the Swiss, German and Benelux markets. Paredes has come a long way since its birth and their client-centric approach is greatly appreciated and looks set to confirm its growth in the years to come.
La trasformazione di Paredes è iniziata nel 2017 con un nuovo management, abilmente guidato da Francois Thuilleur, che ha avviato un ambizioso piano di ristrutturazione. Da allora la crescita è stata costante ed è destinata a continuare grazie al piano di sviluppo Cap N°1, il cui obiettivo è quello di far diventare Paredes una delle prime tre aziende del mercato europeo dell’igiene professionale. L’azienda ha da poco festeggiato 80 anni di servizio
nel mercato dell’igiene professionale, passando da una dimensione familiare a un Gruppo con 220 milioni di euro di fatturato, 650 collaboratori, 2 siti produttivi e 16 siti commerciali e logistici distribuiti tra Francia e Italia. La sua storia contiene importanti pietre miliari come l’invenzione del primo rotolo di carta monouso per scopi igienici e il primo dispenser a taglio automatico per asciugamani. Uno sviluppo che comprende la creazione dell’e-shop che, con
la presenza di esperti suddivisi per settore di clientela per consigliare le soluzioni più adatte alla clientela, sta riscuotendo un notevole successo. Da non dimenticare che Paredes è sempre stato portavoce attivo di tematiche sociali e ambientali, fin dal lancio della sua Eco Attitude nel 1995. Queste solide fondamenta sono state sviluppate con l’adesione al Global Compact delle Nazioni Unite nel 2017, un rating di sostenibilità EcoVadis di platino, la certificazione di responsa-
bilità sociale e di impronta di carbonio per i suoi prodotti, per citare solo alcune delle sue iniziative di RSI. Percorso che ha portato Paredes nella posizione di leader del mercato europeo dell’igiene: il Gruppo sta attualmente aprendo i mercati svizzero, tedesco e del Benelux. Paredes ha fatto molta strada dalla sua nascita e il suo approccio incentrato sul cliente è molto apprezzato e sembra destinato a confermare la sua crescita negli anni a venire.
sponsored content
paredes.fr | paredes.it
Paredes. Una storia iniziata 80 anni fa
Innovations that change cleaning
Maximising hygiene, minimising effort and optimising processes: at Interclean 2024 TTS will present three highly innovative solutions that prevent cross-contamination and operator fatigue and make cleaning operations highly efficient.
POCKETY DOES IT ALL
Pockety is the innovative touch-free mop release system designed to dispose of mops without contact with dirt, viruses and bacteria, ensuring a high level of hygiene and cross-contamination control. The operator no longer has to touch the dirty fibres to release the mops, nor does he have to constantly bend over to pick them up from the floor after removing them: he simply slides the frame out of the lid to immediately remove the used mop, which is then collected in the bag located inside the bucket.
Pockety is compatible with the entire range of TTS mops with pockets , washable and disposable: the operator can thus use the most appropriate mop for the type of surface to be treated and the degree of dirt present.
WIZ WRINGS FOR YOU
Wiz is the plate wringer
that wrings out 10 to 20% more than conventional wringers, reducing the drying time of the floor. It is equipped with an innovati ve adjustment system that allows the mop moisture to be adjusted according to specific needs and kept constant at each wringing, therefore the end result is not dependent on the strength of the operator who simply has to accom pany the lever to the end of its stroke to immediately eliminate excess water. No matter which mop you use or which wringing in tensity you set, Wiz always requires half the effort compared to conventional wringers: tests show a duction in effort of 50 to 70 per cent , resulting in a lower risk of injury and mu scle pain.
LAMPO CHANGES CLEANING
Lampo is the first diate attach and detach system that allows one handle to be used for all ordinary and extraordinary operations: thanks to the Jack adapter for handles and poles, any tool can be attached in an instant , greatly improving the cleaning process.

ding any hand contact with potentially contaminated surfaces.
The Plug device for Nickita and Magic allows the frames to be unhooked directly on the trolley , avoi-
Reducing the number of handles and placing the frames back in place ensures a trolley free of all those obstacles that slow down and make operation
difficult. Furthermore, it is finally possible to fully equip even the most compact trolley , so that it becomes a complete cleaning station with everything needed for any cleaning task, planned or unplanned.
sponsored content


Innovazioni che rivoluzionano la pulizia
Massimizzare l’igiene, minimizzare gli sforzi e ottimizzare i processi: TTS presenterà a Interclean 2024 tre soluzioni altamente innovative che prevengono la contaminazione crociata e l’affaticamento dell’operatore e rendono altamente efficienti le operazioni di pulizia.
Pockety pensa a tutto
Pockety è l’esclusivo sistema per lo sgancio touch-free dei ricambi che permette di dismetterli senza entrare in contatto con sporco, virus e batteri, assicurando un alto livello di igiene e il controllo della contaminazione crociata. L’operatore non è più costretto a toccare le fibre sporche per sganciare i ricambi né deve piegarsi in continuazione per raccoglierli dal
pavimento dopo averli rimossi: è sufficiente sfilare il telaio dal coperchio per rimuovere immediatamente il ricambio usato che viene raccolto nell’apposito sacco a rete posizionato all’interno del secchio.
Pockety è compatibile con l’intera gamma di ricambi TTS con tasche, lavabili e usa e getta: l’operatore può così utilizzare il ricambio più adeguato al tipo di superficie da trattare e al grado di sporco presente.
Wiz strizza per te Wiz è lo strizzatore a piastra che strizza dal 10 al 20% in più rispetto agli strizzatori tradizionali, riducendo il tempo di asciugatura del pavimento. È dotato di un innovativo sistema di regolazione che consente di variare l’umidità del ricambio
secondo le specifiche esigenze e mantenerla costante a ogni strizzatura, slegando quindi il risultato finale dalla forza dell’operatore che deve semplicemente accompagnare la leva fino a fine corsa per eliminare subito l’acqua in eccesso. Non importa quale ricambio si utilizza o quale intensità di strizzaggio si imposta, Wiz richiede sempre metà degli sforzi rispetto agli strizzatori tradizionali: i test condotti evidenziano una riduzione dello sforzo dal 50 al 70% che si traduce in un minor rischio di infortuni e dolori muscolari.
Lampo svolta la pulizia Lampo è il primo sistema di aggancio e sgancio immediato che permette di usare un solo manico per tutte le operazioni
ordinarie e straordinarie: grazie all’adattatore Jack per manici e aste è possibile agganciare in un attimo qualsiasi attrezzo, migliorando notevolmente il processo di pulizia.
Il dispositivo Plug per Nickita e Magic permette invece di sganciare i telai direttamente sul carrello, evitando ogni contatto delle mani con superfici potenzialmente contaminate. Riducendo il numero di manici e posizionando i telai al loro posto, si assicura un carrello libero da ostacoli che rallentano e rendono difficile l’operatività. Inoltre, è finalmente possibile attrezzare al massimo anche il carrello più compatto ottenendo una stazione di pulizia completa di tutto il necessario per qualsiasi intervento di pulizia, pianificato o meno.
ttsystem.com
Corporate sustainability reporting
EU rules require large corporations and listed companies to publish regular reports on the social and environmental risks they face and the impact of their activities on people and the environment
Cristina Cardinali

72 DIMENSIONE PULITO | 04/2024
REGULATION

EU law requires all large companies and all listed companies (with the exception of listed microenterprises) to disclose information about what they consider to be the risks and opportunities arising from social and environmental issues and the impact of their activities on people and the environment.
This helps investors, civil society organizations, consumers, and other interested parties assess the sustainability performance of companies as part of the European Green Deal.
THE CORPORATE SUSTAINABILITY REPORTING DIRECTIVE
On January 5, 2023, the Corporate Sustainability Reporting Directive (CSRD) came into effect. It modernizes and strengthens the standards for social and environmental information that companies must provide. A broader set of large companies, as well as listed SMEs, will now be required to report on sustainability. Some non-EU companies will also have to report if they
generate more than 150 million euros in the EU market.
The new rules will ensure that investors and other stakeholders have access to the information they need to assess companies' impacts on people and the environment, and that investors can assess the financial risks and opportunities arising from climate change and other sustainability issues. Finally, it will reduce reporting costs for companies in the medium to long term by harmonizing the information that must be provided.
The first companies will have to apply the new rules for the first time in fiscal year 2024, for reports published in 2025. Companies subject to CSRD will have to report according to the European Sustainability Reporting Standards (ESRS). The standards are developed in draft form by EFRAG, formerly known as the European Financial Reporting Advisory Group, an independent body that brings together various stakeholders.
The first set of ESRS was published in the Official Journal on December 22, 2023 in the form of a delegated regulation. These standards apply to companies within the scope of CSRD regardless of the sector in which they operate. They are adapted to EU policies, building on and contributing to international standardization initiatives.
CSRD also requires assurances on sustainability information reported by companies and will provide the digital taxonomy of sustainability information.
ITALIAN COMPANIES
In order to gain a better understanding of the new European provisions on the subject and their impact on Italian companies AFIDAMP organized on February 13 the webinar "Upcoming obligations for EU companies: European Taxonomy on Sustainable Finance and Sustainability Report." An important moment of information to iden-
tify the obligations introduced by the Regulation (EU) 2020852/ and its Delegated Acts and the EU CSRD Directive 2464/2022. Leading the webinar was Nicola Fabbri of Ergo srl, a spin-off of the Scuola Superiore Sant'Anna of Pisa, who highlighted how the regulation and the directive will soon involve many companies. In fact, the directive will be mandatory from January 1, 2026 for companies that fall into at least two of the following parameters: more than 250 employees, a turnover of more than 40 million, balance sheet of 20 million. It will therefore also involve many Italian companies in the Professional Cleaning sector. The taxonomy remained for several years reserved for the area of finance, but the regulation, approved in 2020 has touched all areas of business, highlighting that a green transition process means not only introducing changes, but also making sustainable investments. Taxonomy, as Fabbri explained, helps precisely along this path because it consists of a system of clear definitions related to environmentally sustainable economic activities, becoming a tool available to investors and companies to make informed investment decisions with the aim of establishing the degree of sustainability of an investment. It therefore represents an opportunity that companies must seize, both in terms of structuring and work ethics, and in terms of their own "green" evolution, gaining the awareness that it will increasingly be the clients themselves who will demand and demand compliance with these requirements, in calls for tenders and in the definition of projects. In addition, the taxonomy now closely affects companies, and not only finance, precisely because every company must be financed and its financiers include banks, which are obliged to report according to the taxonomy, and the state, which with the PNRR has adopted the principles of the taxonomy, which have been declined in the MEF Operational Guide. And
73 DIMENSIONE PULITO | 04/2024
Stefania Verrienti, director of AFIDAMP
yet the same principles of the taxonomy are also applied to CSRD. In this sense, the taxonomy is closely integrated with the very CSRD Directive, which in fact has the same objectives with regard to the environmental factors that companies must comply with: climate change mitigation, including greenhouse gas emissions; climate change adaptation; water and marine resource enhancement; resource use and circular economy; pollution prevention; and safeguarding biodiversity and ecosystems.
A path that represents a great opportunity for many companies at this stage to change in order to grow in the market at the national and European level.
The webinar concluded with a focus on the Made Green in Italy (MGI) label highlighting how this is not just a certification, but a much more articulated improvement path than a CFO or CFP because it uses sixteen impact categories, with a normalization and weighing mechanism that allows all categories to be aggregated and the three most important ones to be chosen. In addition, a key point, a comparison is made with an industry benchmark that is reviewed every four years.
The guidance introduced by the CSRD Directive, the MGI label and the Taxonomy Regulation are therefore important monitoring tools. However, to make the best use of them and for them to become a real opportunity for companies, it is important that, as of now, companies build their own environmental strategy. "Having a comprehensive strategic approach," concluded Nicola Fabbri, "allows you to build a plan that takes into account different factors while staying abreast of changes, having the time to collect necessary data and information, introduce new technologies and plan your investments.
AFIDAMP is a recognized reality and an important point of reference and help for its members and all players in the

Professional Cleaning sector. The Association's initiatives are numerous, from its increasing presence at institutional tables to its collaboration with universities and consulting firms to offer informational and operational support. We asked Stefania Verrienti, director of AFIDAMP, how the Italian Professional Cleaning sector is reacting to the mandatory European requirements.
Climate strategy is increasingly becoming part of every company's growth project. In your opinion, is the Italian industry ready to deal with this important and overdue transition?
"Italian companies in the cleaning industry have a very careful and responsible attitude toward environmental compliance and ecological transition. Keep in mind that, although it is not yet mandatory for them, many of our members already have a Sustainability Report. In Italy many steps have already been taken, particularly thanks to CAM, which has acted as a driving force. Our country is also far ahead on the Ecolabel front: for example, in the detergent sector there are now already 464 companies (out of a total of 2,000 at the European level) that have at least one Ecolabel-certified product. These steps indicate an important attention to what the European Community requires, a constant commitment
to invest in reducing its impact on the environment and a positive attitude of great sensitivity and respect for the future of our planet."
Can you tell us about AFIDAMP's strategic action, which today is increasingly geared toward seizing new opportunities for Italian industry growth in foreign markets?
"AFIDAMP has grown a lot in recent years and is still growing, consequently acquiring a fundamental role in the most important Italian and European institutional tables. Our strategic action is aimed at making the voice of our associates heard loud and clear, both in the definition of new European regulations that affect the sector and to ensure our presence in foreign markets. In this direction, the work we are carrying out with Agenzia ICE and MAECI - Ministry of Foreign Affairs and International Cooperationshould be pointed out, allowing us to enhance and direct the presence of our companies in terms of exports. In this period we are often summoned by MAECI to working and dialogue tables between Italian and African associations, where all participants are called upon to directly confront the real needs of the economic operators they represent and thus encourage the creation of new business opportunities in a logic of mutually beneficial cooperation."
74 DIMENSIONE PULITO | 04/2024
REGULATION

Fimap presents its new EMx super-green scrubbing machine

EMx is Fimap’s compact scrubbing machine designed to become the most cost-effective and ecological choice in the small machine segment. With a working width between 43 and 50 cm, and 3 types of brush head (disc, cylindrical or orbital), it satisfies almost every need of
an extensive part of the professional cleaning market. EMx aims to offer the best options, particularly in terms of eco-friendly equipment, for which there are various solutions. The most revolutionary one is undoubtedly the AQUÆ® technology, for cleaning without chemical
detergents. It transforms normal softened tap water into a cleaning and sanitising solution with a hypochlorous acid base. With this technology, EMx can clean about 90% of the places it is intended for, without any need for chemical detergents. The ecological focus continues
with the recycled plastic tanks, certified as ReMade in Italy. The recycled material used is exclusive to Fimap and guarantees the same durability and reliability as new plastics. EMx can help keep the work areas even healthier thanks to the use of the Hepa filter. To perfect the control of the environmental impact, the winning key is to include the remote monitoring system FFM –Fimap Fleet Management
Apart from providing real time data about consumption and the working mode, so the supervisor can ensure there is no waste or incorrect use for the cleaning job in hand, it also records the CO2 emissions produced by each single model of the fleet. This information is vital for those wanting to reduce or even eliminate the negative impact of their work.
EMx di Fimap è la compatta lavasciuga pavimenti pensata per diventare la scelta più conveniente ed ecologica per il segmento delle piccole. Con una larghezza di lavoro tra i 43 e i 50 cm e ben 3 tipi di basamento, a disco, a rullo e orbitale, è in grado di soddisfare praticamente qualsiasi esigenza in una fetta molto ampia del mercato delle pulizie professionali. È stata concepita per offrire il massimo delle possibilità specialmente in termini di dota-
zioni green, per cui sono state sviluppate diverse soluzioni. La più rivoluzionaria è sicuramente la tecnologia AQUÆ®, per pulire senza detergenti chimici. Trasforma la comune acqua di rubinetto addolcita in una soluzione pulente ed igienizzante a base di acido ipocloroso. Con questa tecnologia, EMx è in grado di pulire circa il 90% degli ambienti a cui è destinata, senza ricorrere a detergenti chimici. L’allestimento ecologico continua con
i serbatoi in plastica riciclata, certificata ReMade in Italy. Il materiale riciclato impiegato è ad uso esclusivo di Fimap e garantisce le stesse caratteristiche di resistenza ed affidabilità delle plastiche nuove. EMx può contribuire a rendere i luoghi che sta pulendo ancora più salubri con la selezione del filtro Hepa
Per perfezionare il controllo sull’impatto ambientale, la chiave vincente è includere il sistema di monitoraggio da
remoto FFM – Fimap Fleet Management. Oltre a fornire in tempo reale i dati relativi ai consumi e alla modalità d’uso che permettono di accertarsi che non si verifichino sprechi o utilizzi inadeguati al piano di pulizia, registra anche le emissioni di CO2 prodotte da ogni singolo modello della flotta. Una consapevolezza necessaria per chi vuole intraprendere azioni per ridurre o addirittura neutralizzare l’impatto delle proprie attività.
sponsored content
fimap.com
Fimap racconta la nuova lavasciuga pavimenti super green EMx
REPORTING DI SOSTENIBILITÀ AZIENDALE
Le norme dell’UE impongono alle grandi società e alle società quotate di pubblicare rapporti regolari sui rischi sociali e ambientali che devono affrontare e sull’impatto delle loro attività sulle persone e sull’ambiente
applicano alle aziende che rientrano nel campo di applicazione della CSRD indipendentemente dal settore in cui operano. Sono adattati alle politiche dell’UE, basandosi e contribuendo alle iniziative di standardizzazione internazionale.
Il diritto dell’UE impone a tutte le grandi società e a tutte le società quotate (ad eccezione delle microimprese quotate) di divulgare informazioni su quelli che considerano i rischi e le opportunità derivanti da questioni sociali e ambientali e sull’impatto delle loro attività sulle persone e sull’ambiente.
Ciò aiuta gli investitori, le organizzazioni della società civile, i consumatori e le altre parti interessate a valutare le prestazioni di sostenibilità delle aziende, come parte del Green Deal europeo.
La Direttiva sul reporting di sostenibilità aziendale
Il 5 gennaio 2023 è entrata in vigore la Direttiva Corporate Sustainability Reporting (CSRD). Modernizza e rafforza le norme relative alle informazioni sociali e ambientali che le aziende devono fornire. Un insieme più ampio di grandi aziende, nonché di PMI quotate, sarà ora tenuto a rendicontare sulla sostenibilità. Anche alcune aziende extra-UE dovranno dichiarare se generano oltre 150 milioni di euro sul mercato dell’UE. Le nuove regole garantiranno che gli investitori e le altre parti interessate abbiano accesso alle informazioni di cui hanno bisogno per valutare l’impatto delle aziende sulle persone e sull’ambiente e che gli investitori possano valutare i rischi e le opportunità finanziari derivanti dai cambiamenti climatici e da altre questioni di sostenibilità. Infine, si ridurranno i costi di rendicontazione per le imprese nel medio-lungo termine armonizzando le informazioni da fornire.
Le prime aziende dovranno applicare le nuove regole per la prima volta nell’anno finanziario 2024, per i report pubblicati nel 2025. Le aziende soggette alla CSRD dovranno rendicontare secondo gli European Sustainability Reporting Standards (ESRS). Gli standard sono sviluppati in forma di bozza dall'EFRAG, precedentemente noto come European Financial Reporting Advisory Group, un organismo indipendente che riunisce diverse parti interessate. La prima serie di ESRS è stata pubblicata nella Gazzetta Ufficiale il 22 dicembre 2023 sotto forma di regolamento delegato. Questi standard si
La CSRD richiede inoltre garanzie sulle informazioni sulla sostenibilità comunicate dalle aziende e fornirà la tassonomia digitale delle informazioni sulla sostenibilità.
Le aziende italiane
Per far comprendere meglio le nuove disposizioni europee in materia e il loro impatto sulle aziende italiane AFIDAMP ha organizzato lo scorso 13 febbraio il webinar “I prossimi obblighi per le aziende EU: Tassonomia Europea sulla finanza sostenibile e Bilancio di Sostenibilità”. Un importante momento di informazione per identificare gli obblighi introdotti dal Regolamento UE852/2020 e dai suoi Atti Delegati e dalla Direttiva UE CSRD 2464/2022. A condurre il webinar Nicola Fabbri di Ergo srl, spin off della Scuola Superiore Sant’Anna di Pisa, che ha evidenziato come il regolamento e la direttiva coinvolgeranno presto molte aziende. La direttiva sarà infatti obbligatoria dal 1 gennaio 2026 per le aziende che rientrino in almeno due dei seguenti parametri: oltre 250 dipendenti, un
fatturato superiore a 40 milioni, stato patrimoniale di 20 milioni. Coinvolgerà quindi anche molte imprese italiane del settore del Cleaning Professionale. La tassonomia è rimasta per diversi anni riservata all’ambito della finanza, ma il regolamento, approvato nel 2020 ha toccato tutti gli ambiti delle imprese, evidenziando come un processo di transizione ecologica non significhi solo introdurre dei cambiamenti, ma anche effettuare degli investimenti sostenibili. La tassonomia, come ha spiegato Fabbri, aiuta proprio in questo percorso perché consiste in un sistema di chiare definizioni relative alle attività economiche ambientalmente sostenibili, diventando uno strumento a disposizione degli investitori e delle aziende per effettuare decisioni di investimento consapevoli con lo scopo di stabilire il grado di sostenibilità di un investimento. Rappresenta quindi un’opportunità che le aziende devono cogliere, sia in termini di strutturazione ed etica del lavoro, sia per quanto riguarda la propria evoluzione “green”, acquisendo la consapevolezza che saranno sempre più i clienti stessi a richiedere e pretendere il rispetto di tali requisiti, nei bandi di gara e nella definizione dei progetti. Inoltre la tassonomia riguarda ormai da vicino le aziende, e non solo la finanza, proprio perché ogni impresa deve essere finanziata e tra i suoi finanziatori ci sono

76 DIMENSIONE PULITO | 04/2024
Cristina Cardinali
NORMATIVA

le banche, che hanno l’obbligo di rendicontare in base alla tassonomia e lo Stato, che con il PNRR ha adottato i principi della tassonomia, che sono stati declinati nella Guida Operativa del MEF. E ancora gli stessi principi della tassonomia sono applicati anche alla CSRD. In questo senso la tassonomia è strettamente integrata proprio con la Direttiva CSRD, che ha di fatto gli stessi obiettivi per quanto riguarda i fattori ambientali che le aziende devono rispettare: la mitigazione dei cambiamenti climatici, anche per quanto riguarda le emissioni di gas a effetto serra; l’adattamento ai cambiamenti climatici; la valorizzazione delle risorse idriche e marine; l’uso delle risorse e l’economia circolare; la prevenzione dell’inquinamento; la salvaguardia della biodiversità e degli ecosistemi.
Un percorso che rappresenta per molte aziende, in questa fase, una grande opportunità di cambiamento per crescere sul mercato a livello nazionale ed europeo.
Il webinar si è concluso con un focus sul marchio Made Green in Italy (MGI) evidenziando come questo non sia una semplice certificazione, bensì un percorso di miglioramento molto più articolato rispetto a una CFO o a una CFP perché usa sedici categorie di impatto, con un meccanismo di normalizzazione e pesatura che consente di aggregare tutte le categorie e di scegliere le tre più importanti. Inoltre, punto fondamentale, viene fatto un confronto con un benchmark di settore che viene rivisto ogni quattro anni.
Le indicazioni introdotte dalla Direttiva CSRD, dal marchio MGI e dal Regolamento sulla Tassonomia rappresentano quindi strumenti di monitoraggio importanti. Per utilizzarli al meglio e perché diventino una vera opportunità
per le imprese è però importante che, fin da ora, le imprese costruiscano una propria strategia ambientale. “Avere un approccio strategico globale - ha concluso Nicola Fabbri - permette di costruire un piano che tenga conto dei diversi fattori restando al passo con i cambiamenti, avendo il tempo di raccogliere dati e informazioni necessarie, di introdurre nuove tecnologie e di pianificare i propri investimenti”.
AFIDAMP è una realtà riconosciuta e un punto di riferimento e aiuto importante per i suoi associati e per tutti i protagonisti del settore del Cleaning Professionale. Numerose le iniziative dell'Associazione, dalla presenza sempre più massiccia nei tavoli istituzionali, alla collaborazione con Università e società di consulenza per offrire un supporto informativo e operativo. Abbiamo chiesto a Stefania Verrienti, direttore di AFIDAMP, come il comparto del Cleaning Professionale italiano stia reagendo alle cogenti richieste europee.
La strategia climatica diventa sempre più parte del progetto di crescita di ogni azienda. A suo parere il comparto italiano è pronto per affrontare questo importante e improcrastinabile passaggio?
“Le imprese italiane del comparto del cleaning hanno un atteggiamento molto attento e responsabile nei confronti del rispetto dell’ambiente e della transizione ecologica. Tenga conto che, pur non essendo per loro ancora cogente, molti nostri associati hanno già un Bilancio di Sostenibilità. In Italia molti passi sono stati già fatti, in particolare grazie ai CAM che ha agito da volano. Il nostro Paese è inoltre molto avanti sul fronte Ecolabel: ad esempio
nel settore della detergenza sono ad oggi già 464 le aziende (su un totale di 2000 a livello europeo) che hanno almeno un prodotto certificato Ecolabel. Questi passaggi sono indice di un’attenzione importante a quanto richiesto dalla Comunità Europea, di un impegno costante a investire per ridurre il proprio impatto sull’ambiente e a un atteggiamento positivo di grande sensibilità e di rispetto per il futuro del nostro pianeta.”
Ci può raccontare l’azione strategica di AFIDAMP che oggi è orientata sempre più a cogliere nuove opportunità di crescita dell’industria italiana nei mercati esteri? “AFIDAMP è cresciuta molto in questi anni e ancora sta crescendo, acquisendo di conseguenza un ruolo fondamentale nei più importanti tavoli istituzionali italiani ed europei. La nostra azione strategica è volta a far sentire forte e chiara la voce dei nostri associati, sia nella definizione di nuove normative europee che riguardano il settore, sia per garantire la presenza sui mercati esteri. In questa direzione va segnalato il lavoro che stiamo portando avanti con Agenzia ICE e con il MAECI – Ministero degli Esteri e della Cooperazione Internazionale -, che ci permettono di valorizzare e indirizzare la presenza delle nostre imprese in termini di esportazioni. In questo periodo siamo spesso convocati dal MAECI a dei tavoli di lavoro e di dialogo tra associazioni italiane ed africane, in cui tutti i partecipanti sono chiamati a confrontarsi in maniera diretta sulle reali esigenze degli operatori economici da esse rappresentati e favorire, così, la creazione di nuove opportunità di business in una logica di cooperazione reciprocamente vantaggiosa.”
77 DIMENSIONE PULITO | 04/2024
SYNCLEAN. 30 years serving customers
Synclean celebrates three decades of extraordinary success, during which the company has provided a wide range of solutions and solved numerous problems in the industrial cleaning sector. Whether you’re a repairer, a distributor, or a business, Synclean has been committed to ensuring access to all the multi-brand spare parts necessary for cleaning machines. But let’s start from the origins by illustrating the company’s evolution.
Synclean’s founder, Vincenzo Savoldi, with a background in the manufacturing industry, had an insight: he understood that finding spare parts after purchase is not always an easy process. Thanks to his strong relationships with suppliers and extensive experience in the industry, he created the
world’s first extensive database that catalogues the connections between various articles and machines. Whether it’s a scrubber dryers, a sweeper, a vacuum cleaner, a high pressure machines, or a single disc, Synclean has carefully preserved the exploded view. This information has been integrated to provide a comprehensive service, which includes both the supply of new machines and spare parts, trolleys, chemicals, cloths, and much more Over time, with the expansion of customers’ machine fleets and brand diversification, the market has evolved, and Synclean’s website has become a benchmark in the industry, often imitated but never equaled. On the occasion of its thirtieth anniversary, Synclean is launching a new website with e-com-




merce functionality, making it easier to select and order from thousands of items. The products on the website are ready for shipping, with a catalog that includes 23,000 motors, 10,000 squeegee rubbers, kilometers of hoses, hundreds of wheels, brushes, floor pads, batteries, and chargers. Synclean offers the best market conditions and exceptional shipping times, ensuring that our customers have a unique reference point for all their professional cleaning needs. Visit the web site syncleanservice.com and request registration. The sales representatives will be happy to contact you soon to provide information on discounts and access credentials. If you can’t find what you need, you can send a photo of the aluminum label on your machine, and Synclean’s team will take care of the rest.
From today, Synclean also offers a range of machines branded SYNCLEAN, representing the selection of the best proposals on the market, characterized by innovative design and eye-catching colors, without compromising exclusively professional performance. The wide range of products includes the renowned scrubber dryer, the latest floor scrubbers, and reliable vacuum cleaners. The Synclean team looks forward to seeing you at Interclean Amsterdam, 14-17 May, at booth 3.116, where a grand celebration will be held throughout the event.

sponsored content
syncleanservice.com


SYNCLEAN. 30 anni al servizio dei clienti
Synclean celebra tre decenni di straordinari successi, durante i quali l’azienda ha fornito una vasta gamma di soluzioni e risolto numerosi problemi nel settore della pulizia industriale. Sia che si tratti di un riparatore, un rivenditore o un’impresa, Synclean si è impegnata a garantire l’accesso a tutti i ricambi multimarca necessari per le macchine di pulizia. Ma partiamo dalle origini illustrando l’evoluzione dell’azienda.
Il fondatore di Synclean, Vincenzo Savoldi, con un background nel mondo della produzione, ha avuto un’illuminazione: ha compreso che la ricerca dei ricambi dopo l’acquisto non è sempre un processo agevole. Grazie ai suoi solidi rapporti con i fornitori e alla sua ampia esperienza nel settore, ha creato il primo vasto database
mondiale che cataloga i collegamenti tra i vari articoli e le macchine. Che si tratti di una lavapavimenti, una spazzatrice, un aspirapolvere, un’idropulitrice o una monospazzola, Synclean ha conservato con cura gli schemi di montaggio. Queste informazioni sono state integrate per offrire un servizio completo, che include sia la fornitura di macchine nuove che di ricambi, carrelli, prodotti chimici, panni e molto altro
Nel corso del tempo, con l’espansione del parco macchine dei clienti e la diversificazione dei marchi, il mercato si è evoluto e il sito web di Synclean è diventato un punto di riferimento nel settore, spesso imitato ma mai eguagliato. In occasione del trentesimo anniversario, Synclean lancia un nuovo sito dotato di funzionalità di




e-commerce, rendendo più agevole la selezione e l’ordine tra migliaia di articoli. I prodotti presenti sul sito sono pronti per la spedizione, con un catalogo che comprende 23.000 motori, 10.000 gomme tergipavimento, chilometri di tubi, centinaia di ruote, spazzole, dischi abrasivi, batterie e caricatori. Synclean offre le migliori condizioni di mercato e tempi di spedizione eccezionali, garantendo ai clienti un punto di riferimento unico per tutte le esigenze di pulizia professionale. Visita il sito web syncleanservice.com e richiedi la registrazione. I commerciali vi contatteranno subito per fornirvi informazioni sulla scontistica e le credenziali di accesso. Se non trovate ciò di cui avete bisogno, inviate una foto dell’etichetta in alluminio sulla vostra macchina e il team Synclean si occuperà del resto.
Da oggi, Synclean offre anche una gamma di macchine a marchio SYNCLEAN, che rappresentano la selezione delle migliori proposte sul mercato, caratterizzate da un design innovativo e colori accattivanti, senza compromettere le prestazioni esclusivamente professionali. L’ampia gamma di prodotti include la rinomata monospazzola, le nuovissime lavapavimenti e gli affidabili aspirapolvere.
Il team Synclean vi aspetta a Interclean Amsterdam, dal 14 al 17 maggio, presso lo stand 3.116, dove si terrà una grande festa per tutta la durata dell’evento.

informazione pubblicitaria
syncleanservice.com
Cleaning as a science
Our magazine Dimensione Pulito has been collaborating for years with CIRI, a U.S. institute which aims to raise awareness of the importance of effective cleaning through scientific research
Cristina Cardinali
Faced with the challenges posed by the historical moment in which we live, it is increasingly important to bring forward synergies that help outline and spread the culture of cleanliness, with the aim of generating optimal behavior. Civil society and institutions have developed a different attitude towards the professional cleaning production sector after the dramatic pandemic that shocked the entire world, bringing to everyone's attention the importance of cleaning for the protection of our health.
THE INSTITUTE
Founded in 2005, CIRI serves the cleaning and disaster restoration industries in several ways. The seed for what gave birth to CIRI (Cleaning Industry Research Institute) was a 1994 book written by Dr. Michael A. Berry, a U.S. Environmental Protection Agency official tasked with uncovering the cause of what was then a new phenomenon called “Sick Building Syndrome.” The book, entitled Protecting the Built Environment: Cleaning for Health, was a prescription for what his investigation uncovered:

82 DIMENSIONE PULITO | 04/2024
OVERSEAS COLLABORATION

buildings too often were poorly cleaned. It was necessary to rethink the ways in which cleaning operations were performed, following two leading principles: remove soil, don’t spread it around; remove the source of odor, don’t cover it up with scents. Berry’s message about the importance of effective cleaning to protect and enhance human health was well received by certain cleaning industry leaders, and they birthed CIRI. The institute was established in 2005 with the express purpose of bringing measurement and high-performance to the practice of cleaning.
In its early years, CIRI set about the process of discovering the best and most practical ways to measure cleaning effectiveness. Among scientific methods, a process that measured adenosine triphosphate, commonly called ATP, was found to be the most useful and it was selected as the foundational measurement method used to evaluate cleaning performance in the “Cleaning Standard for K-12 Schools” a joint effort of CIRI and what was then the International Sanitary Supply Association, now known as the ISSA.
A GUIDE FOR THE CLEANING SECTOR
CIRI serves the cleaning industry in other ways as well. CIRI is known for its “CIRI Science Symposiums” that feature
experts and new research in cleaning, disinfection, remediation and disaster restoration practices. In 2018 CIRI began publishing the industry’s first and only peer-reviewed journal, the Journal of Cleaning Science, or JCS. It features in-depth, peer-reviewed papers on such diverse topics as wildfire assessment, aerosol surface disinfection, and key characteristics of high-performance cleaning. Our magazine, Dimensione Pulito, has repeatedly published these articles on its pages, recognizing their scientific nature and the usefulness of a constructive comparison with overseas experiences to increase, share and spread the culture of cleanliness. As one might expect, the COVID pandemic resulted in a surge of interest in the work CIRI does. CIRI’s first virtual symposium in late March 2020, was attended by nearly 1,100 cleaning professionals from four continents. This was followed in 2020 and 2021 by a series of well-attended follow-up webinars that provided updated information as our knowledge and understanding of COVID evolved. On a continuing basis CIRI provides technically objective and validated information - including guidance documents - to the industries it serves. In addition, CIRI’s website hosts a variety of technical and research papers

WHAT IS THE CIRI
The Cleaning Industry Research Institute is a nonprofit corporation based in Albany, NY, founded to advance science in the cleaning industry and its affiliations. Through scientific research, CIRI raises awareness of the importance of effective cleaning and seeks to convey this message by implementing strategies such as promoting cleaning designed to preserve health and control infections, communicating the results of research based on cleaning techniques and practices effective cleaning, promoting the importance of cleaning, restoration and maintenance operations in preserving public health and hygiene.
available to the public. The post-COVID world is different from the world prior to the pandemic. The enormous importance of cleaning for health identified by Dr. Berry’s book nearly three decades ago is better understood and appreciated by the public at large. The cleaning industry has an opportunity - and an obligation - to step up its game and provide consistently high levels of cleaning performance. CIRI’s place in this is reflected in its statement of purpose: “Working with and through its members, CIRI communicates unbiased, peer-reviewed technical information and research about the science of cleaning or restoration of the indoor environment to all interested stakeholders”.
as editor and publisher of the Journal of Cleaning Science.
CIRI has spearheaded initiatives to develop and provide the industry with cleaning-effectiveness testing protocols.
83 DIMENSIONE PULITO | 04/2024
John Downey, a veteran of more than 45 years in the cleaning industry, is the past chairman of the Cleaning Industry Research Institute. He also served
WHAT IS THE IICRC?

The IICRC is the Institute of Inspection Cleaning and Restoration Certification, a non-profit organization for the Inspection, Cleaning, and Restoration Industries.
The IICRC, originally named the International Institute of Carpet and Upholstery Cleaning Inc. (IICUC), was founded in 1972 by Ed York.
Cleaning organizations will be able to use these protocols to determine and improve the effectiveness of their methods and procedures. CIRI began rolling out these lab and field verified “how-to” protocols in the first half of 2023. In the meantime, some sectors in the U.S. - especially healthcare, long-term care, education and transportation - have already taken the initiative to verify cleaning effectiveness. Tools such as rapid ATP monitoring, blacklight indicator marking, and white glove tests are providing useful information and validation of cleaning effectiveness.
NEXT STEPS
“Only science can see”. CIRI’s strong belief in this credo represents a major shift
Since starting in 1972, the IICRC has evolved into a global organization with more than 49,000 active Certified Technicians and more than 6,500 Certified Firms around the world.
The IICRC is managed by its Board of Directors, which is comprised of 15 industry leaders elected by the IICRC’s Shareholders. The Board of Directors’
function is to represent the various interests of the applicants while leading the direction of the organization. The Board of Directors meets four times per year and is tasked with the responsibility of helping shape future policies of the organization and uphold the standards that help shape the industry.
in how the cleaning industry views the future. It also emphasizes the need for high performance cleaning for health, hygiene and appearance. Evidence shows that cleaning service personnel — no matter how well trained — cannot determine a surface’s cleanliness simply by visually inspecting it. Only science-based cleaning standards can make that determination and CIRI has led the way in establishing those standards. The Institute has laid the groundwork for developing the basic science for measuring and establishing methods for quantifying cleanliness.
John Downey, chairman of CIRI, a few weeks ago announced to us that the Institute of Inspection, Cleaning & Restoration Certification (IICRC) has taken

over administration of CIRI, in order to help CIRI reach its potential.
The paperwork that transitioned CIRI to administrative control by the IICRC was recently finalized. John Downey will be working with the IICRC during a short transition period. We thank him for his valuable work and we wish him all the best.
CONCLUSIONS
Our sector, all over the world, is called to face great changes. I would like to conclude this article with the words of Jim Harris, chair of the Journal of Cleaning Science at that time, who in an editorial of the summer 2019 issue wrote…”CIRI provides industry leaders with a unique and objective scientific perspective of what is fundamental: the what, why and how of the clean and cleaning. More and more industry leaders recognize it…. After all, the company or organization leaders are the key to industry development. Each runs a cleaning organization. And change begins with them or it doesn’t. As important as CIRI is, nothing changes unless the information is put into practice: from management to sales; to the frontline worker swinging a mop, scrubbing a rag, or wiping down soot-covered walls. The last group mentioned, the frontline workers, are the most important yet the least likely to be reached. They are the face of our companies and of the industry”.
84 DIMENSIONE PULITO | 04/2024
OVERSEAS COLLABORATION
Filmop for sparkling glass
Glass cleaning has a new ally at its side: Clarus-W Prime fixed polypropylene holder is characterised by many grooves that fill with cleaning solution and then gradually release it, thus ensuring long-lasting cleaning. The holder combines with the Filmop window washers to provide greatly improved performance compared to traditional sponges.
The range includes washer heads with short or long yarn and versions with abrasive fibre, ensuring in all cases excellent collection capacity and
long washing autonomy. Filmop offers a new tool for glass drying too: the Gloss-W Superior window squeegee has been designed to ensure effective cleaning as well as maximum efficiency. The rubber blade dries the surface with the first wipe, saving time and costs. High precision is provided by the perfectly linear cut made with advanced technology, resulting in a surface free of imperfections. The handgrip design allows uniform pressure to be exerted over the entire length of the blade, re-
sulting in complete and residue-free drying. Filmop window squeegee and fixed holder can be used manually or in combination with handles and poles thanks to Uni-Connect: the unique system connects instantly and safely the entire range of professional cleaning equipment, keeping them in place during operations and thus preventing dangerous disengagement. Thanks to Uni-Connect, operators can quickly switch from one tool to another easily cleaning any surface, even the highest or hard-to-reach one.









filmop.com
sponsored content Come and visit us in Amsterdam from 14 to 17 May 2024 STAND No. 01.311 www.filmop.com Clarus-W Removes and traps stubborn dirt, ensuring large surface coverage Gloss-W Wipes the surface perfectly in a single pass, leaving no residue or streaks Unveiling the true beauty of glass
LA SCIENZA DEL PULITO
Dimensione Pulito collabora da anni con CIRI, un istituto statunitense che mira a sensibilizzare l'opinione pubblica sull'importanza di una pulizia efficace attraverso la ricerca scientifica
Cristina Cardinali
Di fronte alle sfide poste dal momento storico in cui viviamo, è sempre più importante portare avanti sinergie che aiutino a delineare e diffondere la cultura del pulito, con l'obiettivo di generare comportamenti ottimali. La società civile e le istituzioni hanno sviluppato un diverso atteggiamento nei confronti del settore produttivo della pulizia professionale dopo la drammatica pandemia che ha sconvolto il mondo intero, portando all'attenzione di tutti l'importanza della pulizia per la tutela della nostra salute.
L’istituto
Fondato nel 2005, CIRI è al servizio del settore delle pulizie e del ripristino in diversi modi. Il seme che ha dato vita al CIRI (Cleaning Industry Research Institute) è stato un libro del 1994 scritto dal dottor Michael A. Berry, un funzionario dell'Agenzia per la Protezione dell'Ambiente degli Stati Uniti incaricato di scoprire le cause di quello che allora era un nuovo fenomeno chiamato "Sindrome dell'Edificio Malato". Il libro, intitolato Proteggere l'ambiente costruito: Cleaning for Health, era una ricetta per ciò che la sua indagine aveva scoperto: gli edifici erano troppo spesso mal puliti. Era necessario ripensare le modalità di esecuzione delle operazioni di pulizia, seguendo due principi fondamentali: rimuovere lo sporco, non spargerlo in giro; rimuovere la fonte di odore, non coprirla con profumi. Il messaggio di Berry sull'importanza di una pulizia efficace per proteggere e migliorare la salute umana è stato ben accolto da alcuni leader dell'industria della pulizia, che hanno dato vita al CIRI. L'istituto è stato fondato nel 2005 con l'obiettivo esplicito di portare la misurazione dei risultati e le alte prestazioni nella pratica della pulizia. Nei primi anni di attività, CIRI si è dedicato alla scoperta dei metodi migliori e più pratici per misurare l'efficacia della pulizia. Tra i metodi scientifici, un processo di misurazione dell'adenosina trifosfato, comunemente chiamata ATP, si è rivelato il più utile ed è stato scelto come metodo di misurazione fondamentale per valutare le prestazioni di pulizia nel "Cleaning Standard for K-12 Schools", uno sforzo congiunto del CIRI e di quella che allora era l'International Sanitary Supply Association, oggi nota come ISSA.
Una guida per il settore della pulizia CIRI serve l'industria della pulizia anche in altri
modi. CIRI è noto per i suoi "Simposi scientifici che presentano esperti e nuove ricerche sulle pratiche di pulizia, disinfezione, bonifica e ripristino. Nel 2018 CIRI ha iniziato a pubblicare la prima e unica rivista del settore sottoposta a revisione paritaria, il Journal of Cleaning Science, o JCS. Presenta articoli approfonditi e sottoposti a peer review su argomenti diversi come la valutazione degli incendi, la disinfezione delle superfici con aerosol e i requisiti chiave della pulizia ad alte prestazioni. La nostra rivista, Dimensione Pulito, ha più volte diffuso questi articoli sulle sue pagine, riconoscendone il carattere scientifico e l'utilità di un confronto costruttivo con le esperienze d’oltreoceano per accrescere, condividere e diffondere la cultura del pulito. Come ci si poteva aspettare, la pandemia COVID ha provocato un aumento dell'interesse per il lavoro svolto dal CIRI. Il primo simposio virtuale del CIRI, a fine marzo 2020, ha visto la partecipazione di quasi 1.100 professionisti della pulizia provenienti da quattro continenti. Nel 2020 e nel 2021 è stato seguito da una serie di webinar ben frequentati che hanno fornito informazioni aggiornate in base all'evoluzione delle conoscenze e della comprensione del COVID. CIRI fornisce costantemente all'industria del cleaning informazioni tecnicamente obiettive e convalidate, compresi documenti di orientamento. Inoltre, il sito web del CIRI ospita una serie di documenti tecnici e di ricerca disponibili al pubblico. Il mondo post-COVID è diverso da quello precedente alla pandemia. L'enorme importanza della pulizia per la salute, identificata dal libro del Dr. Berry quasi tre decenni fa, è meglio compresa e apprezzata dal pubblico in generale. L'industria delle pulizie ha l'opportunità - e l'obbligo - di fare un salto di qualità e di fornire livelli costantemente elevati di prestazioni di pulizia. Il ruolo del CIRI in questo contesto si riflette nella sua dichiarazione di intenti: "Lavorando con e attraverso i suoi membri, CIRI comunica informazioni tecniche e ricerche imparziali, sottoposte a revisione paritaria, sulla scienza della pulizia o del risanamento degli ambienti interni a tutte le parti interessate". CIRI ha promosso iniziative per sviluppare e fornire al settore protocolli di verifica dell'efficacia della pulizia. Le organizzazioni di pulizia potranno utilizzare questi protocolli per determinare e migliorare l'efficacia dei loro metodi e procedure. CIRI ha iniziato a distribuire questi protocolli "how-to" verificati in laboratorio e sul campo nella prima metà del 2023. Nel frattempo, alcuni settori degli Stati Uniti - in particolare sanità, assistenza a lungo termine, istruzione e trasporti - hanno già preso l'iniziativa di verificare l'effica-
cia della pulizia. Strumenti come il monitoraggio rapido dell'ATP, la marcatura con indicatore a luce nera e i test con i guanti bianchi stanno fornendo informazioni utili e la convalida dell'efficacia della pulizia.
Prossimi passi
"Solo la scienza può vedere". La forte convinzione del CIRI in questo credo rappresenta un cambiamento importante nel modo in cui l'industria della pulizia guarda al futuro. Inoltre, sottolinea la necessità di una pulizia ad alte prestazioni per la salute, l'igiene e l'aspetto estetico. È dimostrato che il personale dei servizi di pulizia, per quanto ben addestrato, non è in grado di determinare la pulizia di una superficie semplicemente con un'ispezione visiva. Solo gli standard di pulizia basati sulla scienza possono determinare questo aspetto e CIRI ha aperto la strada alla definizione di tali standard. L'Istituto ha gettato le basi per lo sviluppo della scienza di base per la misurazione e la definizione di metodi per quantificare la pulizia. John Downey, presidente del CIRI, qualche settimana fa ci ha annunciato che l'Institute of Inspection, Cleaning & Restoration Certification (IICRC) ha assunto la gestione del CIRI, per aiutarlo a raggiungere il suo potenziale. Le pratiche per il passaggio al controllo amministrativo dell'IICRC sono state finalizzate recentemente. John Downey lavorerà con l'IICRC durante un breve periodo di transizione. A lui un sentito ringraziamento per il suo prezioso lavoro e i nostri migliori auguri.
In conclusione
Il nostro settore, in tutto il mondo, è chiamato ad affrontare grandi cambiamenti. Vorrei concludere questo articolo con le parole di Jim Harris, presidente del Journal of Cleaning Science, che in un editoriale del numero dell'estate 2019 ha scritto: "CIRI fornisce ai leader del settore una prospettiva scientifica unica e obiettiva su ciò che è fondamentale: il cosa, il perché e il come del pulito e della pulizia. Sempre più leader del settore lo riconoscono... Dopo tutto, i leader aziendali o organizzativi sono la chiave dello sviluppo del settore. Ognuno di loro gestisce un'organizzazione di pulizia. E il cambiamento inizia con loro o non inizia. Per quanto CIRI sia importante, non cambia nulla se le informazioni non vengono messe in pratica: dalla direzione alle vendite, fino a chi lavora in prima linea a chi usa il mop, a chi lava i pavimenti o pulisce le superfici. L'ultimo gruppo menzionato, quello dei lavoratori in prima linea, è il più importante e il più difficile da raggiungere. Sono il volto delle nostre aziende e del settore".
86 DIMENSIONE PULITO | 04/2024
COLLABORAZIONE OLTREOCEANO
E-Tissue: the “First-Gen” recycled paper from pre-consumer material

E-Tissue is the “First-Gen” recycled paper that recovers pure pulp fibres and kraft offcuts from the manufacturing process at their pre-consumer phase, thus respecting the environment without compromising on performance. The unique production process gives
life to a natural paper, pleasant to the touch and smell, even when wet. With zero added brighteners, E-Tissue preserves the strength and resistance of the raw material it comes from. The perfect balance between high quality and sustainability.
E-Tissue offers a wide ran-
ge of products to meet the main needs of the professional operators. From hand towels, folded and rolls, able to mix absorbency and resistance for the greatest efficiency, to industrial rolls,
traffic sites. The patented Flutech® technology allows all E-Tissue toilet paper to rapidly dissolve in water in 15 seconds, avoiding clogged pipes and unexpected plumbing costs. A comple-

which suit all the hygiene and cleaning needs of the AFH market, thanks to their flexibility and versatility. Toilet paper solutions complete the assorment; from single wrapped, designed to add a touch of simple but elegant style to hotel bathrooms and other hospitality venues, to interfolded and jumbo, ideal for high
te line, 100% ecologic and certified EU Ecolabel and PEFC.
E-Tissue: recycled solutions as strong yet delicate as pure pulp paper.

Dal recupero degli sfridi di lavorazione della pura cellulosa e del kraft, entrambi derivanti da materiale pre-consumo, nasce E-Tissue, il riciclato di “prima generazione” che sostiene l’ambiente senza compromessi sulla performance. L’esclusivo processo produttivo dà vita a una carta naturale, gradevole al tatto e all’olfatto, anche da bagnata.
Priva di sbiancanti ottici aggiunti, E-Tissue preserva la forza e la resistenza della materia prima da cui trae origine. Il connubio perfetto tra prestazioni eccellenti e sostenibilità. Un’ampia gamma di prodotti che soddisfa le principali esigenze del mercato professionale. Dagli asciugamani, piegati e a rotolo, capaci di sommare assorbenza e resisten-
za per la massima efficienza, alle bobine industriali, che, con la loro versatilità e trasversalità si adattano alle diverse necessità di igiene e pulizia del mondo AFH. A completamento, le carte igieniche, che variano dalla monofascettata, perfetta per arredare con semplicità ed eleganza i bagni di hotel e strutture ricettive, alla interfogliata e jumbo, ideali
per locali ad alta affluenza. Tutte le carte igieniche E-Tissue grazie alla speciale tecnologia Flutech® garantiscono una rapida spappolabilità in 15 secondi, prevenendo intasamenti e costi idraulici imprevisti. Una linea completa, 100% ecologica e certificata EU Ecolabel e PEFC. E-Tissue: la carta riciclata forte e delicata come una pura cellulosa.
sponsored content
industrieceltex.com
E-Tissue: il riciclato di “prima generazione” da materiale pre-consumo
Kroll, leader in the production of professional hand washing and soaps
Kroll, Italian leading manufacturer of professional soaps and hand cleaners for industry, craftsmanship, automotive, DIY and Ho.Re.Ca. it was founded in 1979 and it has always stood out for the quality of the products made with innovative and certified formulations.
For over 20 years the com-
pany has been certified UNI EN ISO 9001 and 14001, it was the first Italian Cosmetics Company to achieve the recognition of the European Community EMAS and the environmental quality label “ECOLABEL IT/030/001”.
Kroll’s offer consists of a wide range of products for the hygiene of hands and
body, safe for those who use them and the environment. Kroll’s team is made up of highly qualified personnel able to provide innovative services and technical advice to propose high quality and customized solutions. We can certainly say that Kroll is a reliable partner for distributors who address
large-scale industry, small craft businesses, public authorities and all accommodation facilities.
Once again this year Kroll will be present at the Interclean Fair in Amsterdam at stand 11.105 and it will be another opportunity to discover the latest innovations.

Kroll, azienda italiana leader nella produzione di detergenti e saponi professionali per l’industria, l’artigianato, automotive, fai da te ed Ho.Re.Ca. è stata fondata nel 1979 e si distingue da sempre per la qualità dei suoi prodotti realizzati con formulazioni innovative e certificate. Da oltre 20 anni l’azienda è
certificata UNI EN ISO 9001 e 14001, è stata la prima Azienda Cosmetica Italiana ad aver ottenuto sia il riconoscimento della Comunità Europea EMAS sia il marchio di qualità ecologica “ECOLABEL IT/030/001”.
L’offerta di Kroll si compone da un’ampia gamma di prodotti per l’igiene di mani e corpo, si-
curi per chi li utilizza e per l’ambiente.
Il team di Kroll è composto da personale altamente qualificato in grado di fornire un servizio di assistenza e consulenza tecnica all’avanguardia per proporre soluzioni di alta qualità e personalizzate. Possiamo certamente affermare che Kroll è un partner
affidabile per i distributori che si rivolgono alla grande industria, alle piccole attività artigianali, agli enti pubblici e a tutte le strutture ricettive. Anche quest’anno Kroll sarà presente alla Fiera Interclean di Amsterdam presso lo stand 11.105 e sarà un’ulteriore occasione per scoprire le ultime novità.
sponsored content
kroll-amkro.com
Kroll, leader nella produzione di lavamani e saponi professionali

Abbiamo creduto per primi nella certificazione Ecolabel perché i nostri standard ne rispettavano già i principi.
I nostri prodotti sono la soluzione migliore per l’ambiente…. ….migliore per te.



® S.r.l. Via Mazzon, 21 • 30020 Quarto d’Altino (VE) Italy Ph. +39.0422.823794 • kroll@kroll-amkro.com kroll-amkro.com francesconardocomunicativo.com
Innovazione, ecosostenibilità e benessere
EU Ecolabel: IT/030/001
Cerved
|
Prodotti P er la detergenza
Service, a winning weapon
COVID-19, la riscoperta dell’importanza dell’IGIENE
Nel 2020 il valore della produzione italiana di prodotti per detergenza e pulizia è stato di 3,8 miliardi di euro
In a sector where product innovation is essential, the presence of major customers and support in terms of assistance, availability and training is the key that makes the difference. The market remains stable and eco-friendly choices are rewarded
a cura di Diletta Gaggia
Data processing Cerved Marketing Intelligence edited by David Migliori
La produzione italiana di prodotti per detergenza e pulizia è una delle più importanti in Europa. Nel 2020 il suo valore è stato di circa 3,8 miliardi di euro e, in controtendenza con l’andamento generale dell’economia, ha registrato un mode rato progresso (+3,1%) rispetto all’anno precedente, questo quanto emerge dallo Start Prodotti per la detergenza divulgato da Cerved a marzo 2021. Lo sviluppo è stato spinto essenzialmente dalla componente nazionale dei con sumi domestici che hanno beneficiato delle maggiori esigenze di igiene, puli zia e sanificazione imposte dal contra sto al contagio del virus Sars-CoV-2 e dalla centralità dell’ambiente domestico determinata da limitazioni agli sposta menti e chiusure. Il mercato professio nale invece risulta penalizzato dalle diffuse chiusure di luoghi pubblici e in particolare dalle difficoltà del comparto Ho.re.ca. Tra i segmenti principali, evi denziano maggiori progressi i prodotti per superfici, ma anche l’area del lavag gio stoviglie e gli additivi per bucato, mentre in termini di canali, gli speciali sti drug si sono dimostrati il format più vivace anche durante la pandemia. Le previsioni per il 2021 evidenziano deboli variazioni al ribasso del valore della pro duzione e dei consumi rispetto ai livelli elevati raggiunti nel 2020. L’evoluzione ancora incerta della crisi sanitaria sup-


DETERGENT MARKET
P
Cerved Market Intelligence: la piattaforma per conoscere i Mercati, davvero. Scrivici a info.marketingsolutions@cerved.com
If the competition between the big names necessarily also involves marketing and the launch of continuous new products, the vast majority of operators, especially in the professional products sector, have on their side the ability to meet the specific needs of customers, the possibility of working directly in contact with them and providing the continuous support required. Also important is the coverage of specific market niches where some Italian operators have always played a very important role. Having left the post-covid adjustment period behind, the market has been affected by the last two years of inflation which increased the costs of raw materials and limited sales by end buyers.
THE MARKET NUMBERS
The main economic data of the sector presented by Cerved in its analysis published in March this year, tell us that the world of detergents and cleaning products is a world which in 2023 - as a whole - is worth around 4.16 billion at a global level of production. An important figure even if, compared to 2022, down by 1%. The downsizing is probably due to greater attention to purchases by consumers who have lost part of their purchasing power. The generalized inflationary pressure and the consequent increases in raw materials and energy costs have had an impact and have also influenced the evolution of exports and imports. In fact, both items in 2023 have a negative
sign. The mitigation of current inflation bodes well for a short future characterized by stability. This is provided that the international scenario does not reserve any nasty surprises and global uncertainties do not translate into increases in raw material prices.
COMPANIES
AND THEIR STRATEGIES
There are approximately 630 companies currently active in the "Manufacture of soaps and detergents, cleaning and polishing products" sector, of which 68% are represented by joint-stock companies. They are mainly in Lombardy (30%), Campania (10%), Veneto and Emilia-Romagna (around 8%). There are only around fifty companies operating in the domestic channel, the others are companies operating in the market of products for professional and industrial use. The two large sectors into which the world of detergents is divided have some peculiar characteristics that differentiate them greatly. If you look at household products there are some multinational chemical companies that are present in Italy with production plants and commercial branches. It is not surprising that the concentration is consequently very high: the top four companies cover approximately 60% of the entire market. With some extreme cases such as the washing machine detergent sector in which the first three large ones (which are Procter & Gamble, Henkel and Reckitt Benckiser) control almost 90% of the sector.
Things become very different if we look at the professional and industrial market. Here the first two companies together have a share of around 25%. Behind them are a large number of operators with small shares, even below 2%. The competition between large multinationals is played above all on elements of differentiation and is supported by strong investments in product innovation and advertising. In the lower segments of the market and for less differentiated products, the fundamental variable is price. In partial denial of what has just been written, there are some very specialized market niches, as in the case of some specific treatments for fabrics, in which thanks to the "uniqueness" of the product, the price becomes a secondary variable in favor of the qualitative characteristics of the products. A peculiarity of the market for detergents for communities and professional use is the fact that in these cases the competition aims to cover larger customers, such as industrial laundries, canteens and so on. Here, service plays a fundamental role, in various forms: in terms of technical assistance in some cases, the supply of machinery on loan for use in others, but also support and training of employees. In any case, if large groups can count on strong marketing support, and on important investments both in terms of production and product innovation, Italian operators have responded intelligently by adopting various strategies over
91 DIMENSIONE PULITO | 04/2024
2020 2021 2022 2023 Var ‘23 2024 Var ‘24 2025 Var ‘25 Production (Mln €) 3.819 3.810 4.200 4.160 -1% 4.230 1,7% 4.285 1,3% Export (Mln €) 1.838 2.006 2.268 2.200 -3% 2.280 3,6% 2.335 2,4% Import (Mln €) 1.079 1.203 1.496 1.360 -9,1% 1.395 2,6% 1.440 3,2% Trade Balance (Mln €) 759 803 772 840 - 885 - 895Internal Market (Mln €) 3.060 3.007 3.428 3.320 -3,2% 3.345 0,8% 3.390 1,3% Export / Production 48,1% 52,7% 54,0% 52,9% - 53,9% - 54,5%Import / Market 35,3% 40,0% 43,6% 41,0% - 41,7% - 42,5% -
Tab. 1 - Market analysis (Source: Cerved processing on ISTAT data and other)qualified sources
the years to increase their degree of specialization. Among the policies adopted there is, for example, that of specializing in specific product niches (the Cerved study highlights, for
Tab. 2. Main national players (Source: Cerved)
example, the case of Realchimica, with the Chanteclair line of Marseille soaps and detergents and of Zobele, specialized in biocides); another strategy is to focus on the production for commercial brands of modern distribution (such as Dasty Italia, Deco, Deterplast, McBride, Pizzolotto), others, finally, have chosen to dedicate themselves exclusively to the production and marketing of detergents and detergents for professional uses and industrial.
TRENDS OF RECENT YEARS
2
3
4
4.1
5
Especially in the two-year period 2022-2023, with the growth of inflation, the price variable has taken on an important role in influencing market dynamics. The increase in prices induced by the sharp increases in the prices of raw materials and production factors, on the one hand, slowed down demand in terms of volumes, and on the other, led to growing attention to price. Consumption was driven by the washing sector, which also represents the most important share, with a growing weight of liquid products. The segment of dish detergents, laundry addi-
THREATS TO THE SECTOR
The Cerved study highlights the main critical areas. First and foremost is the growing attention to price by buyers given that inflation has caused losses in purchasing power. A second factor that threatens the serenity of the detergent sector is the volatility of raw material prices resulting from the uncertainty of the international political-economic framework. Even the possible introduction of the plastic tax in July 2024 could prove to be a new additional cost, while the need for high investments to support research & development and the launch of new products is cited as a further critical element to always take into consideration.
92 DIMENSIONE PULITO | 04/2024
DETERGENT MARKET Company Group Reference year Turnover (k €) Variation
Procter & Gamble Holdingsrl Procter & Gamble 2022 1.611.905 23,1%
Procter & Gamble Srl Procter & Gamble 2022 410.176 8,7%
Procter & Gamble
Spa Procter & Gamble 2022 109.902 -0,8%
1
1.1
1.2
Italia
Unilever
Mkt. operations Srl Unilever 2022 1.440.000 1,3%1.1
Italia
Henkel Italia Srl Henkel 2022 852.133 -2,4%
Henkel Italia
Srl Henkel 2022 80.215 1,3%
3.1
Operations
2022 448.411 -1,8%
Reckitt Benckiser Commercial (Italia) Srl Reckitt Benckiser
Reckitt Benckiser
Spa Reckitt Benckiser 2022 186.546 14,4%
Italia
Gruppo Desa Srl Gruppo Desa 2022 430.162 25,7% 5.1 Real-Chimica Srl Gruppo Desa 2022 199.987 8,0%
Its - Sisa Detergenti Srl Gruppo Desa 2022 164.031 44,4%
Si.ste.m. Srl Gruppo Desa 2022 87.478 30,0% 6 Bolton Manitoba Spa Bolton Group 2022 346.550 7,1% 6.1 Madel Spa Bolton Group 2022 88.835 1,2% 7 S.c. Johnson Italy Srl Sc. Johnson 2022 244.014 3,0% 8 Deco Industrie
Deco Industrie 2022 196.260 18,9% 9 Ecolab Holding Italy Srl Ecolab Bv 2022 149.339 20,5% 9.1 Ecolab Srl Ecolab Bv 2022 103.987 24,5% 10 Saci Industrie Spa 2022 122.624 30,1% 11 Diversey Spa Diversey France 2022 101.857 15,3% 12 Mcbride Spa Mcbride 2023 90.712 21,1% 13 Re.le.vi. Spa Proa Capital DeInversiones S.G.E.I.C.S.A 2022 81.861 6,2% 14 Stanhome Spa Società Benefit Stanhome International 2022 74.615 -10,8% 15 Colgate Palmolive Italia Srl Colgate Palmolive 2022 71.717 17,4% 16 Italchimica Srl Nfh Holding 2022 69.708 -0,3%
5.2
5.3
Società Cooperativa Per Azioni







Tab. 3. Main national players (field of business)
Business Field of business
1 Procter & Gamble Holdingsrl Cleansing. It also operates in other consumer goods sectors
1.1 Procter & Gamble Srl
Marketing of cleaning products. It also operates in other consumer goods sectors
1.2 Procter & Gamble Italia Spa Cleansing. It also operates in other consumer goods sectors
2 Unilever Italia Mkt.operations Srl
3 Henkel Italia Srl
Marketing of cleaning products. It also operates in other consumer goods sectors
Marketing of cleaning products
3.1 Henkel Italia Operations Srl Cleansing. It also operates in other consumer goods sectors
4 Reckitt Benckisercommercial (Italia) Srl
Marketing of home and laundry care and cleaning products. It also operates in other consumer goods sectors
4.1 Reckitt Benckiser Italia Spa Cleansing. It also operates in other consumer goods sectors
5 Gruppo Desa Srl Production of detergents and soaps
5.1 Real-Chimica Srl Marketing of cleaning products
5.2 Its - Sisa Detergenti Srl Detergents
5.3. Si.ste.m. Srl Detergents for home use
6 Bolton Manitoba Spa Specific products. It also operates in other consumer goods sectors
6.1 Madel Spa Detergents
7 S.c. Johnson Italy Srl Marketing of biocides, specific products
8 Deco Industrie Societa'cooperativa Per Azioni Detergents
9 Ecolab Holding Italy Srl Professional detergents
9.1 Ecolab Srl Professional detergents
10 Saci Industrie Spa Detergents
11 Diversey Spa Professional detergents
12 Mcbride Spa Detergents
13 Re.le.vi Spa Detergents
14 Stanhome Spa Società Benefit Marketing of detergent products, specific products
15 Colgate Palmolive Italia Srl Detergents
16 Italchimica Srl Professional and consumer detergents
tives (including basic products such as bleach) and insect products are also growing, the only segment with slight growth also in volume in the summer period. Consumers, despite maintaining a high attention to price, are increasingly attentive and aware of the quality of products in terms of clean-
ing efficiency and also environmental sustainability and these elements increasingly guide the purchasing choices of a growing part of buyers.
INCREASINGLY ECO-FRIENDLY
The trend is evident and increasingly marked. The need to reduce the im-
pact of the release of detergents into the environment has led to the creation and development of products with a composition that increases their biodegradability, also with the use of vegetable raw materials. Part of the research and development activity of companies in the sector is therefore directed towards compositions with a lower environmental impact, but also towards packaging that reduces the use of plastic: concentrated products, refills, draft products, etc. The dissemination and use of brands and certifications that guarantee compliance with specific standards are part of the same strategy. The most widespread is the European Ecological Quality mark, which is issued by the Ecolabel-Ecoaudit Committee and which classifies as "ecolabel" the most environmentally friendly products and therefore with the lowest environmental impact. When we talk about environmental impact, we must remember that this does not only concern the release into the environment of the chemical components of detergent products and the materials that make up the packaging but also the consumption of electricity in carrying out production activities.
THE REGULATIONS TO KNOW AND RESPECT
The production of detergents is subject to certain rules that regulate the chemical substances used in production processes. The general rules are contained in the European Detergent Regulation (648/2004/EC), which has been in force in Italy since 2005 and requires the total biodegradability of surfactants, in addition to the labeling of all substances belonging to specific classes and present in quantities. higher than 0.2%. The case of allergenic substances is different, as they must be indicated if the quantity exceeds even just 0.01%. An important novelty is the revision of the regulation which was proposed in April 2023 by the European Commission with the aim of
94 DIMENSIONE PULITO | 04/2024
MARKET
DETERGENT



14 15 16 17
DETERGENTS: SEGMENTATION
The Cerved study took into consideration companies whose main activity is the production of detergents and detergents for laundry, dishes and home cleaning, specific products for home cleaning, insecticides for domestic use, products intended for professional and industrial uses.
The sector can be segmented into 5 groups based on the intended use of the products:
1.detergents and adjuvants for clothing and fabrics (additives, bleaches, softeners, stain removers, etc.). It is the main sector and is worth, alone, over half of the entire market in value;
2.detergents and adjuvants for dishes (by hand, for dishwashers, rinse aids, etc.);
3.detergents and adjuvants for environments (detergents for large surfaces, toilets, drain cleaners, etc.); 4.biocides (insecticides etc.) for home use; 5.air fresheners.
But it's not enough. In turn, these groups also often contain market niches within them with products for specific uses (e.g. specific detergents for silver, steel, copper etc., ironing primers etc.). Taking end customers into consideration, approximately 70% of the market in value is represented by products for domestic use intended for mass consumption, while the remaining 30% is made up of products for professional operators (cleaning companies, catering, laundries, etc.).
simplifying the current rules and better protecting health and the environment in line with the objectives of the Green Deal and in favor of sustainable chemical substances. Among the revisions, some introduce rules for innovative products, such as detergents that contain microorganisms, others deal with new sustainable practices, such as selling detergents by refill. Among the planned innovations there is also digital labeling and the so-called product passport for detergents and surfactants. An important novelty is the revision of the regulation which was proposed in April 2023 by the European Commission with the aim of simplifying the current rules and better protecting health and the environment in line with the objectives of the Green Deal and in favor of sustainable chemical substances. Among the revisions, some introduce rules for innovative products, such as detergents that contain microorganisms, others deal with new sustainable practices, such as selling
detergents by refill. Among the planned innovations there is also digital labeling and the so-called product passport for detergents and surfactants.
A third fundamental body of legislation is constituted by the European Regulation on biocidal products (n. 528/2012/ EU) in force since 2013. It establishes the rules for the authorisation, plac-
ing on the market and use of biocidal products and products treated with these substances. In 2018, Delegated Regulation 2017/2100 was added, which regulates the presence of endocrine disruptors considered harmful to the hormonal system and which are contained in some categories of biocides.
Moving on to the individual regulations that have an impact on the sector, the Plastic tax has been talked about for years. Introduced for the first time with the 2020 Budget Law, as a transposition of a European directive, it would impose a tax of 0.45 euros for each kilogram of plastic material used. As is known, from extension to extension, the law has never come into force and, at the moment, has been postponed until 1 July 2024.
Finally, the obligation for environmental labeling of packaging has been in force since 2023. The Ministry of the Environment and Energy Security has published the "technical guidelines" to provide companies with indications, at an operational level, on the correct ways to fulfill the obligation. In practice, the label must provide all the information necessary for the correct disposal of the packaging: it must indicate the type of packaging used, the material it is made of, the reference family of the material and the type of collection to be carried out.

96 DIMENSIONE PULITO | 04/2024
DETERGENT MARKET
DUO SOLID
Ecological 2-in-1 dilution concept for automatic dishwashing
SAVINGS ON PRODUCT USE AND OPERATION COSTS
IMPROVED SAFETY
MAXIMIZED FLOOR SPACE
SUSTAINABLE DISHWASHING SOLUTION




THINK SAFE, CLEAN GREEN PROFESSIONAL HY GIENE
L’ARMA VINCENTE È IL SERVIZIO
In un settore dove l’innovazione di prodotto è imprescindibile, il presidio dei clienti maggiori e il supporto in termini di assistenza, disponibilità e formazione è la chiave di volta che fa la differenza. Il mercato si conferma stabile e le scelte ecocompatibili vengono premiate
Elaborazione dati Cerved Marketing Intelligence a cura di David Migliori
Se la competizione fra i grandi big si gioca necessariamente anche sul marketing e sul lancio di continue novità di prodotto, la grande maggioranza degli operatori, specialmente nel settore dei prodotti professionali, ha dalla propria parte la capacità di andare incontro alle esigenze specifiche dei clienti, la possibilità di operare direttamente a contatto con loro e di fornire il supporto continuo richiesto. Importante anche il presidio di specifiche nicchie di mercato dove alcuni operatori italiani svolgono da sempre un ruolo molto importante.
Lasciato alle spalle il periodo di assestamento post covid, il mercato ha risentito dell’ultimo biennio di inflazione che ha aumentato i costi delle materie prime e limitato le vendite da parte degli acquirenti finali.
I numeri del mercato I principali dati economici del settore presentati da Cerved nella sua analisi pubblicata a marzo di quest’anno, ci dicono che quello dei detergenti e dei prodotti per la pulizia è un mondo che nel 2023 - nel suo insieme vale circa 4,16 miliardi a livello di produzione. Una cifra importante anche se, rispetto al 2022, in calo dell’1%. Il ridimensionamento è dovuto probabilmente ad una maggiore attenzione agli acquisti da parte dei consumatori che hanno perso parte del loro potere di acquisto. La pressione inflazionistica generalizzata e i conseguenti aumenti delle materie prime e dei costi energetici, ha avuto un suo impatto e ha influenzato anche l’evoluzione di esportazioni e importazioni. Entrambe le voci nel 2023 presentano infatti un segno negativo. L’attenuamento dell’inflazione attuale fa ben sperare per un futuro a breve all’insegna della stabilità. Questo a condizione che lo scenario internazionale non riservi brutte sorprese e le incertezze a livello mondiale non si traducano in aumenti dei prezzi delle materie prime.
Le aziende e le loro strategie
Le imprese oggi attive nel settore della “Fabbricazione di saponi e detergenti, di prodotti per la pulizia e la lucidatura” sono circa 630, di cui il 68% è rappresentato da società di capitali. Sono soprattutto in Lombardia (30%), Campania (10%), Veneto ed Emilia-Romagna (intorno all’8%). Quelle che operano nel canale domestico sono solo una cinquantina, le altre sono aziende operanti nel mercato dei prodotti per uso professionale e industriale.
I due grandi settori in cui è diviso il mondo dei detergenti hanno alcune caratteristiche peculiari che li differenziano molto. Se si guarda ai prodotti per famiglie ci sono alcune imprese multinazionali chimiche che sono presenti in Italia con stabilimenti produttivi e filiali commerciali. Non stupisce che di conseguenza la concentrazione sia molto elevata: le prime quattro aziende coprono il 60% circa dell’intero mercato. Con alcuni casi limite come il comparto dei detersivi per lavatrice in cui le prime tre grandi (che sono Procter & Gamble, Henkel e Reckitt Benckiser) controllano quasi il 90% del settore.
Le cose si fanno assai diverse se guardiamo al mercato professionale e industriale. Qui le prime due imprese hanno insieme una quota di circa il 25%. Dietro di loro un gran numero di operatori con piccole quote, anche sotto al 2%.
La competizione tra le grandi multinazionali è giocata soprattutto sugli elementi di differenziazione ed è sostenuta da forti investimenti nell'innovazione di prodotto e nella pubblicità. Nelle fasce più basse di mercato e per i prodotti meno differenziati la variabile fondamentale è invece il prezzo. A parziale smentita di quanto appena scritto, esistono alcune nicchie di mercato molto specialistiche, come nel caso di alcuni trattamenti specifici per tessuti, nei quali grazie all'"unicità" del prodotto, il prezzo diventa una variabile secondaria a favore delle caratteristiche qualitative dei prodotti. Una peculiarità del mercato dei detergenti per comunità e per uso professionale è il fatto che in questi casi la competizione mira al presidio dei clienti di maggiori dimensioni, come le lavanderie industriali, le mense e così via. Qui a giocare un ruolo fondamentale è il servizio, sotto varie forme: in termini di assistenza tecnica in alcuni casi, di fornitura di macchinari in comodato d'uso in altri, ma anche di supporto e
formazione degli addetti. In ogni caso, se i grandi gruppi possono contare su un forte supporto di marketing, e su investimenti importanti sia a livello produttivo che di innovazione di prodotto, gli operatori italiani hanno risposto con intelligenza adottando negli anni diverse strategie per aumentare il loro grado di specializzazione. Tra le politiche adottate c’è ad esempio quella di specializzarsi in specifiche nicchie di prodotto (lo studio Cerved segnala ad esempio, il caso di Realchimica, con la linea di saponi e detergenti al sapone di Marsiglia Chanteclair e di Zobele, specializzata nei biocidi); un’altra strategia è quella di puntare sulla produzione per le marche commerciali della distribuzione moderna (come Dasty Italia, Deco, Deterplast, McBride, Pizzolotto), altri infine, hanno scelto di dedicarsi esclusivamente alla produzione e commercializzazione di detersivi e detergenti per usi professionali e industriali.
Le tendenze degli ultimi anni Soprattutto nel biennio 2022-2023, con la crescita dell’inflazione, la variabile prezzo ha assunto un ruolo rilevante nell’influenzare le dinamiche di mercato. L’aumento dei prezzi indotto dai forti rincari delle materie prime e dei fattori produttivi, da un lato ha frenato la domanda in termini di volumi, dall’altro ha de-
Le minacce al settore
Lo studio Cerved segnala quali sono le principali aree critiche per il settore. Al primo posto è segnalata la crescente attenzione al prezzo da parte degli acquirenti dato che l’inflazione ha causato perdite di potere d’acquisto. Un secondo fattore che minaccia la serenità del comparto dei detergenti è la volatilità dei prezzi delle materie prime conseguenti all’incertezza del quadro politico-economico internazionale. Anche la possibile introduzione della plastic tax a luglio 2024 potrebbe rivelarsi un nuovo costo aggiuntivo, mentre la necessità di investimenti elevati per sostenere ricerca&sviluppo ed il lancio di nuovi prodotti viene citata come ulteriore elemento critico da tenere sempre in considerazione.
98 DIMENSIONE PULITO | 04/2024
MERCATO DELLA DETERGENZA

terminato una crescente attenzione al prezzo. A trainare i consumi è stato il comparto del lavaggio che ne rappresenta anche la quota più importante, con un peso crescente dei prodotti liquidi. In crescita anche il segmento dei detersivi per stoviglie, gli additivi per bucato (tra cui anche prodotti basici come le candeggine) e i prodotti per insetti, unico segmento in lieve crescita anche in volume nel periodo estivo. I consumatori, nonostante mantengano un’elevata attenzione al prezzo, sono sempre più attenti e consapevoli rispetto alla qualità dei prodotti in termini di efficienza nella pulizia e anche di sostenibilità ambientale e questi elementi guidano sempre di più le scelte di acquisto di una parte crescente di acquirenti.
Sempre più ecocompatibili
La tendenza è evidente ed è sempre più marcata. L'esigenza di ridurre l'impatto dell'immissione dei detergenti nell'ambiente ha portato alla creazione e allo sviluppo di prodotti con una composizione che ne aumenta la biodegradabilità, anche con l'utilizzo di materie prime vegetali. Una parte dell'attività di ricerca e sviluppo delle aziende del settore si dirige quindi verso composizioni a minor impatto ambientale, ma anche di packaging che riducono l'utilizzo di plastica: prodotti concentrati, ricariche, prodotti alla spina, ecc. Fanno parte della stessa strategia la diffusione e l’utilizzo di marchi e certificazioni che garantiscono il rispetto di standard specifici. Il più diffuso è marchio Europeo di Qualità Ecologica, che viene rilasciato dal Comitato Ecolabel-Ecoaudit e che classifica come "ecolabel" i prodotti più ecocompatibili e quindi con il minor impatto ambientale. Quando si parla di impatto ambientale bisogna ricordarsi che questo non riguarda solo l'immissione nell'ambiente delle componenti chimiche dei prodotti detergenti e dei materiali che costituiscono il packaging ma anche i consumi di energia elettrica nello svolgimento dell'attività produttiva.
Le normative da conoscere e rispettare
La produzione di detergenti è soggetta ad alcune norme che regolamentano le sostanze chimiche utilizzate nei processi produttivi.
Le regole generali sono contenute nel Regolamento europeo sulla detergenza (648/2004/ CE), che è in vigore in Italia dal 2005 e impone la totale biodegradabilità dei tensioattivi, oltre all'etichettatura di tutte le sostanze appartenenti a specifiche classi e presenti in quantità superiori allo 0,2%. Diverso il caso delle sostanze allergeniche che invece devono essere obbligatoriamente indicate se la quantità supera anche solo lo 0,01%.
Una novità importante è la revisione del regolamento che è stata proposta ad aprile 2023 dalla Commissione europea con l’obiettivo di semplificare le attuali norme e proteggere meglio la salute e l’ambiente in linea con gli obiettivi del Green Deal e a favore di sostanze chimiche sostenibili. Tra le revisioni, alcune introducono regole per i prodotti innovativi, come i detergenti che contengono microrganismi, altre si occupano delle nuove pratiche sostenibili, come la vendita di detergenti mediante ricarica. Tra le novità previste c’è anche l’etichettatura digitale e il cosiddetto passaporto del prodotto per i detergenti e i tensioattivi.
Una seconda normativa di riferimento per il settore è data dal Regolamento europeo per la registrazione, valutazione e autorizzazione delle sostanze chimiche (Reach). In vigore dal 2007, impone l'obbligo di registrazione per le sostanze utilizzate nei processi produttivi. Come effetto pratico ha determinato una serie di obblighi burocratici per le imprese che le producono, ma non ha avuto ripercussioni significative sulle aziende del settore. Un terzo fondamentale corpus normativo è costituito dal Regolamento europeo sui biocidi (n. 528/2012/UE) in vigore dal 2013. Stabilisce le regole per l'autorizzazione, l’immissione sul mercato e l'uso dei biocidi e dei prodotti trattati con queste sostanze. Nel 2018 si è aggiunto il
Regolamento delegato 2017/2100, che disciplina la presenza degli interferenti endocrini ritenuti nocivi per il sistema ormonale e che sono contenuti in alcune categorie di biocidi. Passando invece alle singole norme che hanno un impatto sul settore, si parla da anni della Plastica tax. Introdotta una prima volta con la Legge di Bilancio del 2020, come recepimento di una direttiva europea, imporrebbe un'imposta di 0,45 euro per ogni chilogrammo di materia plastica utilizzata. Come è noto, di proroga in proroga, la legge non è mai entrata in vigore e, al momento, è stata rimandata al 1° luglio 2024.
Infine, dal 2023 è in vigore l'obbligo di etichettatura ambientale degli imballaggi. Il Ministero dell'Ambiente e della Sicurezza energetica ha pubblicato le "linee guida tecniche" per fornire alle aziende le indicazioni, a livello operativo, sulle corrette modalità per adempiere all'obbligo. In pratica l’etichetta deve fornire tutte le informazioni necessarie per il corretto smaltimento del packaging: deve indicare il tipo di imballaggio utilizzato, il materiale di cui è composto, la famiglia di riferimento del materiale e il tipo di raccolta da eseguire.
Detergenti: la segmentazione
Lo studio Cerved ha preso in considerazione le imprese la cui attività prevalente è la produzione di detersivi e detergenti per il bucato, per i piatti e per la pulizia della casa, prodotti specifici per la pulizia della casa, insetticidi per uso domestico, prodotti destinati ad usi professionali e industriali.
Il settore può essere segmentato in 5 gruppi in base alla destinazione d’uso dei prodotti:
1. detergenti e coadiuvanti per indumenti e tessuti (additivi, candeggine, ammorbidenti, smacchiatori, ecc.). E’ il settore principale e vale, da solo, oltre la metà dell’intero mercato in valore;
2. detergenti e coadiuvanti per stoviglie (a mano, per lavastoviglie, brillantanti, ecc.);
3. detergenti e coadiuvanti per ambienti (detergenti per grandi superfici, WC, disgorganti ecc);
4. biocidi (insetticidi ecc.) per uso domestico; 5. deodoranti per ambienti.
Ma non basta. A loro volta anche questi gruppi spesso contengono al loro interno delle nicchie di mercato con prodotti per usi specifici (es. detergenti specifici per argento, acciaio, rame etc, appretti per stiro etc.).
Prendendo invece in considerazione la clientela finale, circa il 70% del mercato in valore è rappresentato da prodotti per uso domestico destinati al largo consumo, mentre il restante 30% è costituito da prodotti per operatori professionali (imprese di pulizia, catering, lavanderie, ecc.).
99 DIMENSIONE PULITO | 04/2024
Private label specialists
Since 1984, the year of its establishment, Polychim srl has dedicated itself to the design and production of detergents, additives and auxiliaries for cleaning, sanitizing, waxes and cosmetics. The offer is aimed at dealers operating in the professional cleaning market, with a rich and diversified range of products:
• Kitchen line and mechanical dishwashing
• Manual and mechanical fabric washing line
• Cleaning and maintenance line for surfaces and environments
• Transport line
• Industrial sector line
• Hand washing and body hygiene line
• Biotechnology line.
Among the products available we find products with low environmental impact with CAM 2021 Conformity Certification, products with Ecolabel Certification, super-concentrated products to be used manually or with dosing or dilution systems. The formats offered are multiple and vary depending on the type of product:

Specialisti del Private Label
Dal 1984, anno della propria costituzione, Polychim srl si dedica alla progettazione e produzione di detersivi, detergenti, additivi e ausiliari per la detergenza, igienizzanti cere e cosmetici. L’offerta è rivolta ai dealer che operano nel mercato del cleaning professionale, con una gamma di prodotti ricca e diversificata:
• Linea cucine e lavaggio meccanico stoviglie
• Linea lavaggio manuale e meccanico dei tessuti
• Linea pulizia e manutenzione
di superfici ed ambienti
• Linea trasporti
• Linea settore industriale
• Linea lavamani ed igiene del corpo
• Linea biotecnologie.
Tra i prodotti disponibili troviamo prodotti a basso impatto ambientale con Certificazione di Conformità ai CAM 2021, prodotti con Certificazione Ecolabel, prodotti superconcentrati da utilizzare manualmente oppure con sistemi di dosaggio

starting from 20 and 40 ml single doses of concentrated products up to 60 L drums and 1000 L tanks for large users and automatic dosing systems.
A specialization of the company is the creation of “private label” products, an activity which can concern only the personalization of the label, an activity carried out internally by its own graphic designer, up to the development of “ad-hoc” products on a specific project and with dedicated and exclusive formulation and packaging.
In addition to the products, Polychim provides all the necessary technical support, prepares the documentation for customized products, the safety data sheets, manages notifications to the competent bodies, freeing customers from these tasks so that they can dedicate themselves more peacefully to the sales activity.
o diluizione. I formati proposti sono molteplici e variano in funzione del tipo di prodotto: si parte dalle monodosi da 20 e 40 ml dei prodotti concentrati fino ad arrivare ai fusti da 60 L ed alle cisternette da 1000 L per grandi utilizzatori e sistemi di dosaggio automatico. Una specializzazione dell’azienda è la creazione di prodotti in “private label”, attività che può riguardare la sola personalizzazione dell’etichetta, attività svolta internamente dal proprio
grafico, fino ad arrivare allo sviluppo di prodotti “ad-hoc” su specifico progetto e con formulazione e packaging dedicate ed esclusive. Oltre ai prodotti Polychim fornisce tutto il necessario supporto tecnico, predispone la documentazione dei prodotti personalizzati, le schede di sicurezza, gestisce le notifiche agli enti competenti, liberando i clienti da queste incombenze in modo che possano dedicarsi più serenamente all’attività di vendita.
sponsored content
polychim.it





750 ml ℮ organici, unti grassi, cibi cotti incrostati. Formula schiuma controllata adatta per pulizie manuali diluire acqua, passare sulle superfici con panni spugne, lasciare agire fino min. poi Passare con mop, frange, strofinaccio con lavapavimenti; risciacquare necessario. Impiego con EQUA FORTE un impatto limitato sull’ambiente acquatico. 10 kg ℮ GLI ECOLOGICI diluire secchio 20/30 ml prodotto per d’acqua. 5 L ℮ USO PROFESSIONALE pavidet GLI ECOLOGICI Provoca grave irritazione ocula -

The challenge of ecological transition
edited by Cristina Cardinali
Is it really possible to achieve Carbon Neutrality and move one's companies toward an environmentally conscious transformation by creating climate-positive actions? To delve into
this topic, at the H3i event held in Milan on March 5 and 6, AFIDAMP organized a conference dedicated to the theme "The Climate Strategy of Professional Detergents to Meet the Challenge of the Ecological Transition," an event designed to explore what paths companies can take, what the regulatory framework is, and how it is possible to identify not only a

PROFESSIONAL DETERGENT 102 DIMENSIONE PULITO | 04/2024
path in environmental protection, but a climate strategy, which will see companies in the sector work toward a true ecological transition.
The message of the need for all companies to face the future by setting up a real climate strategy right now, grafting environmentally friendly actions not only at the level of marketing and communication, but above all at the level of business, production and market presence, emerged very clearly from the meeting. In fact, climate strategy is not a stand-alone element, but part of every company's growth project. Actions that require the commitment of everyone in a careful team effort. Actions that respond to the European Green Deal and in which our country is always virtuous. Many steps, in fact, have already been taken in Italy, particularly thanks to CAM. Our country is far ahead on recycling, and on the Ecolabel front Italy also stands out. The two instruments together, CAM and Ecolabel, therefore mark the course toward what is
an ecological transition of businesses. Fundamental is for companies to understand what the way forward is, laying the groundwork for building measurable strategies, thinking from the beginning from a sustainability perspective, rethinking the ecodesign of products and designing all business activities toward a new green scheme. The green transition takes time and investment, which must also be sustainable; it requires necessary steps and implementation of regulations internally and, above all, control and attention to all steps. Fortunately, there are many
companies that have already taken this direction, since the development time is not short. According to a study covering the year 2023 (source_Mid Market Climate Transition Barometer), 11 percent of companies out of a sample of 700 have already started to develop strategies for sustainability and decreasing their environmental impact. The climate strategy should also help companies reduce their carbon footprint and offset emissions that could not be avoided by adapting how they produce and have a presence in the market.

LA SFIDA DELLA TRANSIZIONE ECOLOGICA
Èdavvero possibile raggiungere la Carbon Neutrality e fare evolvere le proprie aziende verso una trasformazione che tenga conto del rispetto dell’ambiente, creando azioni clima-positive? Per approfondire l’argomento, in occasione della manifestazione H3i che si è svolta a Milano il 5 e 6 marzo, AFIDAMP ha organizzato un convegno dedicato al tema “La strategia climatica della detergenza professionale per vincere la sfida della transizione ecologica”, un appuntamento ideato per esplorare quali sono le strade da percorrere per le aziende, quale il quadro normativo di riferimento e come sia possibile individuare non solo un percorso in tutela dell’ambiente, ma una strategia climatica, che veda le aziende del settore operare in vista di una vera e propria transizione ecologica.
Dall’incontro è emerso con grande chiarezza il messaggio della necessità per tutte le aziende di affrontare il futuro impostando fin da ora

una vera e propria strategia climatica, innestando azioni rispettose dell’ambiente non solo a livello di marketing e comunicazione, ma soprattutto a livello di business, di produzione e di presenza sul mercato. La strategia climatica non è infatti un elemento a sé stante, bensì parte del progetto di crescita di ogni azienda. Azioni che richiedono l’impegno di tutti in un attento gioco di squadra. Azioni che rispondo al Green Deal Europeo e nelle quali il nostro Paese è sempre virtuoso. Molti passi, infatti, sono stati già fatti in Italia, in particolare grazie ai CAM. Il nostro Paese è molto avanti sul tema del riciclo e anche sul fronte Ecolabel l’Italia si distingue. I due strumenti insieme, CAM ed Ecolabel, segnano quindi la rotta verso quella che è una transizione delle imprese in chiave ecologica. Fondamentale è che le aziende comprendano quali siano le modalità per procedere, mettendo le basi per costruire strategie misurabili, ragionando da subito in un’ottica di
sostenibilità, ripensando l’ecodesign dei prodotti e progettando tutte le attività aziendali verso un nuovo schema green.
La transizione ecologica, richiede tempo e investimenti, che devono anch’essi essere sostenibili; richiede passaggi necessari e implementazione di regolamenti al proprio interno e, soprattutto, controllo e attenzione a tutti i passaggi. Sono per fortuna molte le aziende che già hanno preso questa direzione, dato che i tempi di sviluppo non sono brevi. Secondo uno studio relativo all’anno 2023 (fonte_Mid Market Climate Transition Barometer), l’11% delle aziende su un campione di 700 ha già iniziato a sviluppare strategie per la sostenibilità e la diminuzione del loro impatto ambientale.
La strategia climatica deve inoltre aiutare le aziende a ridurre la propria impronta di carbonio e a compensare le emissioni che non è stato possibile evitare, adattando la propria modalità di produzione e di presenza sul mercato.
103 DIMENSIONE PULITO | 04/2024
Flies, mosquitos and air hygiene in a single solution
In support of the effective management of everyday environmental comfort, within its Hygiene line, Orma offers the unique and innovative solution for the control, well-being, and hygiene of virtually all types of enclosed spaces. It’s called the Air Control System, the automatic aerosol dispenser
that presents itself on the market as a revolution in instant air control: besides being an air freshener, it can also be an immediate and long-lasting insecticide and sanitizing agent. Usable with different spray canisters, it becomes an instant insecticide, environmental disinfectant, and more ge-
nerally, a deodorizer. Restaurants, bars, hotels, but also offices, gyms, public places—with the Air Control System, they can finally rid themselves, easily and instantly, of problems caused by insects such as flies and mosquitoes, thus ensuring their customers the highest level of tranqui-

Mosche, zanzare, igiene dell’aria: esiste un’unica soluzione
A supporto della gestione efficace del comfort degli ambienti quotidiani, all’interno della sua linea Igiene, Orma offre la soluzione unica e innovativa per il controllo, il benessere e l’igiene di pressoché tutte le tipologie di spazio chiuso. Si tratta di Air Control System, il diffusore aerosol automatico che si presenta sul mercato come rivoluzione nel controllo istantaneo dell’aria: oltre a profumatore d’am-
biente, può essere insetticida e igienizzante immediato e a lunga durata. Utilizzato con bombole spray differenti, diventa, infatti, insetticida istantaneo, disinfettante d’ambiente e più in generale deodorante. Ristoranti, bar, alberghi, ma anche uffici, palestre, luoghi pubblici, con Air Control System possono finalmente liberarsi, in modo semplice e veloce, dai problemi causati da insetti come mosche
e zanzare, garantendo così ai propri clienti il massimo livello di tranquillità e serenità ma anche di igiene dell’aria. Con Air Control System, si avrà sempre la certezza di ottenere, e così assicurare, il massimo livello di comfort perché: con bombole spray insetticida Air Control S garantisce immediata ed elevata efficacia quotidiana con rapido effetto abbattente e massima repellenza; con bom-
lity and serenity, as well as air hygiene. By using the Air Control System, you will always have the certainty of obtaining, and thus ensuring, the highest level of comfort because:
with Air Control S insecticide spray canisters, it guarantees immediate and high daily effectiveness with rapid knockdown effect and maximum repellency with Air Control Sanitizer disinfectant spray canisters, it ensures constant hygiene with Air Control Classic/ Plus deodorant spray canisters, it offers countless fragrances to choose from for maximum well-being Thanks to its three dispensing intervals, Air Control System is the simple and convenient solution to always offer excellence in air quality for everyday spaces.
bole spray disinfettante Air Contro Sanitizer è garanzia di igiene costante; con bombole spray deodorante Air Control Classic/Plus offre innumerevoli fragranze fra cui scegliere per il massimo benessere.
Grazie anche ai suoi tre intervalli di erogazione, Air Control System è così la soluzione semplice e comoda per offrire sempre l’eccellenza della qualità dell’aria degli spazi di ogni giorno.
sponsored content
ormatorino.com

INSECTICIDES
AIR CONTROL S®
DISTAIR S® WITH NATURAL PHYRETHRUM
CLASSIC® AND PLUS® Simple
DISINFECTANTS
AIR CONTROL SANITIZER®
VIRUSES - BACTERYA AND YEASTS
FRAGRANCES
AIR CONTROL
TWO TYPE OF CONCENTRATIONS
PRODUCTS AND SOLUTIONS MADE IN ITALY
effective solution www.ormatorino.com
and
Cleaning and sanitation in the workplace
Raise companies' awareness of cleaning and sanitizing processes as a standard practice to prevent occupational injuries and illnesses through a valuable guidance document
edited by Cristina Cardinali

106 DIMENSIONE PULITO | 04/2024
CLEANING COMPANIES
The publication La sanificazione nel post pandemia. La standardizzazione dei processi (Sanitation in the post-pandemic era. The standardization of processes), was created as part of the agreement between Inail and Confimi Industria, which aims to carry out information and training initiatives, aimed at promoting the values of the culture of health and safety in the workplace on specific issues that increase the knowledge and skills of professionals, companies and workers operating within the different production sectors.
Drafted with the contribution of AFIDAMP-Finco, members of Confimi, the publication is not mandatory, but is intended to be a guiding document on sanitization activities and is aimed at both employers who intend to carry out sanitization activities internally and cleaning companies to whom the service is outsourced.
Based on the guidance provided, the employer may draw up a work plan, assign tasks and responsibilities, define the frequency of cleaning, disinfection and sanitization activities, and make risk assessment based also on the specificity of each environment and the equipment used.
The document focuses exclusively on cleaning in the civil sector and, aiming to raise awareness among companies of the culture of cleanliness, promotes the adoption of cleaning and sanitizing processes as "standard" practice by going into the specifics of the choice of equipment to be used, the description of the methodologies to be followed, providing guidance on the proper management of cleaning, information on the appropriate use of machines, equipment and commonly used cleaning and disinfectant chemicals, operator training, monitoring of the result and a description of the possible risks that may arise from carrying out this activity. In fact, any choice made by the employer must, as always, be the result of a careful risk assessment, tak-
ing into account the many factors that affect how and how often each cleaning and disinfection action is implemented. In the final section it proposes a useful appendix that takes the form of a checklist for activities to be carried out in the different environments of working life.
The document, which is presented as a practical and easy-to-consult manual, also aims to spread knowledge of this topic across the board among workers, employers and among all prevention figures, hoping to be a reference to supplement the training courses dedicated to Prevention and Protection Service.
SANITATION
The dramatic experience during the Covid 19 pandemic highlighted an often underestimated problem: the fact that surfaces can be vehicles for pathogen transmission. This has been an outcome of no small consequence because it has made people aware that cleaning and sanitizing is a fundamental means of protecting health and preventing pathogenic microorganisms from proliferating on inanimate surfaces of living and working places. Sanitizing, in addition to encapsulating the concept of building maintenance and the maintenance of conditions of well-being and decorum, becomes therefore, a real preventive measure.
For the first time there has been serious discussion, even at the institutional level, of sanitization, which represents a "complex of procedures and operations" that includes cleaning activities and disinfection activities, which should be understood "as a set of interconnected activities."
It can undoubtedly be said that as long as people remember the sacrifices they faced during the Covid-19 pandemic and how it was possible to come out of it, thanks in part to the raising of cleanliness standards and the workers who made them possible, until then we will have an incredible weapon of pre-
vention at our disposal that will enable people to live in cleaner, safer, healthier and, as a result, better environments for the collective well-being.
PLANNING AND ORGANIZING SANITATION ACTIVITIES
The services covered by sanitation activities can be classified into the following types: ordinary, periodic, additional and extraordinary. The actual performance of all these activities, included in the Operational Plan of Activities, must be evidenced by an appropriate Report, prepared monthly and accepted by the Service Manager, necessary for subsequent reporting and billing. All activities must be carried out carefully and in a workmanlike manner with the use of suitable means and materials so as not to damage the floors, paints, furniture and anything else present in the environments subject to the activities.
Cleaning operations must be conducted by adequately trained personnel, equipped with the best professional equipment available, the most suitable materials to solve, from time to time, the different needs for intervention, aimed at ensuring the best conditions of hygiene of the environment to ensure a healthy performance of activities in full respect of the image of the Administration.
During the performance of activities, all measures prescribed to protect the health and safety of workers must be observed, as provided by Legislative Decree No. 81/08, as amended.
In general, all sanitization operations must be organized in such a way that they do not interfere with the normal activities of the places concerned. It will be the responsibility of the Service Manager to communicate the necessary information to the client when preparing the Operational Plan of Activities, the contractor will also cooperate in the implementation of protection and prevention measures in order to eliminate risks from interference,
107 DIMENSIONE PULITO | 04/2024

and will coordinate them with the client. The commissioning employer will prepare the Single Document for the Evaluation of Risks from Interference (DUVRI), which must be attached to the contract and will have to be adjusted according to function of the evolutions of the service provided (art 26 d.lgs. 81/08).
CONTROLLING THE RESULT
It is important to check the result of cleaning operations by making sure that the predetermined hygienic standards have been achieved. Checks will be both quantitative and qualitative. If the cleaning service has been entrusted to an outside company, it is good to first check the compliance of the equipment used with that defined in the contract: machinery, chemicals and other equipment indicated in the technical project. Through Process Control, the application of the procedures and operating instructions will be verified, as well as
the use of the instrumentation included in the specifications for service delivery. It should be carried out, at least monthly, by the person/office assigned for this task, preferably using a form, in which to record the outcomes of quality control in order to monitor the correspondence between the execution of activities and the requirements defined in the Technical Specifications and the Technical Project. The control may take place on a scheduled basis, on a random basis or on all areas involved, or following a report.
Failure to meet the levels defined for the judgment factors leads to the detection of a report.
The control of the execution of the activity indicated in the Operational Plan of Activities must result from an appropriate "Control Report" which consists of a monthly elaboration attesting, in addition to the daily controls, any Extraordinary Activity, any additional and/or supplementary activity required.
TOOLS FOR MONITORING ENVIRONMENTAL CLEANLINESS AND HYGIENE
In non-public environments usually the check of the hygienic level achieved is done by careful visual inspection. However, a visually clean surface may not even be so from a hygienic point of view. All of the monitoring described below is done in conjunction with audits of hygiene, on a periodic basis, in order to track self-control activities, intervene with any corrective and/or improvement actions, and ensure the effectiveness of surface sanitization treatments.
Rapid monitoring of environmental cleanliness. Rapid, visual monitoring of the degree of cleanliness of a surface can be carried out through the following methodologies:
- the monitoring of dust on non-walkable surfaces carried out with the Bacharach Scale;
- the dust monitoring on hard and resilient walkable surfaces carried out with the Bassoumeter;
- gloss monitoring on walkable surfaces carried out with the 3-corner Digital Glossmeter.
Rapid environmental hygiene monitoring. It can be carried out by two methodologies:
- Monitoring of the level of microbiological contamination of surfaces that is carried out with a portable instrument (Bioluminometer) capable of detecting the presence of ATP (adenosine triphosphate), a chemical molecule that provides energy in cellular processes; therefore, its presence, is an indication of microbial contamination.
- Monitoring performed with internationally recognized validated rapid kits to detect the presence of invisible organic residues (proteins, sugars and starches) on surfaces.
Source: La sanificazione nel post pandemia. La standardizzazione dei processi. Inail 2023; collana Salute e sicurezza.
108 DIMENSIONE PULITO | 04/2024
CLEANING COMPANIES


The new steam cleaner designed by STI for a bedbug free environment! Eliminate bedbugs and pests with superheated dry steam and without the use of pesticides! www.stindustry.it We will waiting for you Stand 05.203
Mr Shield PRO TECH: eight product lines aimed at revolutionizing the cleaning world
Indupharma, a leading company in the cleaning and pest control market, has recently introduced the first complete line of cleaning, sanitizing, disinfecting and pest control products targeted to professional, industrial and Ho.Re.Ca. cleaning specialists.
Mr Shield PRO TECH is a disruptive innovation, formulated and designed in Italy, by professionals for pro-
fessionals. Indeed, its wide range of products comes from a deep knowledge of the cleaning and pest control market, as well as the awareness of the specific problems and practical needs of professional cleaners.
The Mr Shield PRO TECH range consists of eight product lines that cater to all the needs of the professional cleaning sector and include both solutions designed for everyday use and formulations dedicated to
specific problems.
The detergent line is the heart of the offering, integrating a wide range of products for the care of floors, surfaces, dishes and technical equipment with a series of specific solutions designed for the food industry. Surface disinfectants, bactericides and virucides, available in both ready-to-use and concentrated modes, complete the offering.
Mr Shield PRO TECH also includes a wide range of
pest control and rodenticides, specially formulated to enable easy and safe use while ensuring professional results.
The Mr Shield PRO TECH range also includes a wide variety of complementary accessories, such as UV lamps for capturing flying insects, pumps, sprayers, and protective suits, designed to ensure optimal results and maximum safety and well-being during the use of the products.

Indupharma, azienda leader nel settore della detergenza e della disinfestazione, ha recentemente introdotto nel mercato la prima linea completa di prodotti detergenti, igienizzanti, disinfettanti e disinfestanti rivolta agli specialisti del settore pulizie professionali, industriali e Ho.Re.Ca.
Mr Shield PRO TECH è l’innovativo brand che offre la risposta più efficace per l’igiene e la cura degli ambienti, frutto della
capacità industriale di Indupharma e dell’expertise conseguita dall’azienda in seguito all’acquisizione di Italchimes nel 2022. Le otto linee di prodotti che compongono la gamma Mr Shield PRO TECH rispondono a tutte le necessità del settore delle pulizie professionali e includono sia soluzioni studiate per l’uso quotidiano che formulati dedicati alla risoluzione di problematiche specifiche. Il cuore dell’offerta è la linea dei
detergenti che integra un’ampia gamma di prodotti per la cura dei pavimenti, delle superfici, delle stoviglie e delle apparecchiature tecniche con una serie di soluzioni specifiche, studiate appositamente per l’industria alimentare. Completano l’offerta i disinfettanti per superfici, battericidi e virucidi, disponibili sia in modalità pronto uso che concentrati.
Mr Shield PRO TECH include anche un’ampia gamma di disin-
festanti e rodenticidi appositamente formulati per consentire un utilizzo facile e sicuro garantendo risultati professionali. La gamma Mr Shield PRO TECH inoltre comprende un’ampia offerta di accessori complementari, un ampio set di lampade UV per la cattura degli insetti volanti, pompe, spruzzatori e tute protettive, studiati per garantire risultati ottimali e la massima sicurezza e benessere durante l’utilizzo dei prodotti.
sponsored content
indupharma.eu
Mr Shield PRO TECH: otto linee di soluzioni per rivoluzionare il mondo delle pulizie


Discover
PULIZIA E SANIFICAZIONE
NEI LUOGHI DI
LAVORO
Sensibilizzare le aziende ai processi di pulizia e sanificazione come prassi standard di prevenzione dagli infortuni e dalle malattie sul lavoro attraverso un prezioso documento guida
a cura di Cristina Cardinali
La pubblicazione “La sanificazione nel post pandemia. La standardizzazione dei processi”, Inail 2023, collana Salute e sicurezza, nasce nell’ambito dell’accordo tra Inail e Confimi Industria che mira alla realizzazione di iniziative informative e formative, finalizzate alla promozione dei valori della cultura della salute e sicurezza nei luoghi di lavoro su specifiche tematiche che accrescano le conoscenze e le competenze dei professionisti, delle imprese e dei lavoratori che operano all’interno delle diverse realtà produttive.
Redatta con il contributo di AFIDAMP-Finco, aderenti a Confimi, la pubblicazione non ha carattere di obbligatorietà, ma vuole rappresentare un documento guida sulle attività di sanificazione e si rivolge sia ai datori di lavoro che intendono effettuare le attività di sanificazione internamente sia alle imprese di pulizia a cui viene esternalizzato il servizio. Sulla scorta delle indicazioni contenute, il datore di lavoro potrà redigere un piano di lavoro, attribuire compiti e responsabilità, definire la frequenza delle attività di pulizia, disinfezione e sanificazione, operare la valutazione dei rischi in base anche alla specificità di ogni ambiente e delle strumentazioni utilizzate.
Il documento si focalizza esclusivamente sulle pulizie in ambito civile e, puntando a sensibilizzare le aziende alla cultura del pulito, promuove l’adozione di processi di pulizia e sanificazione come prassi “standard” entrando nello specifico della scelta delle strumentazioni da utilizzare, nella descrizione delle metodologie da seguire, fornendo indicazioni per la corretta gestione delle pulizie, informazioni su un appropriato utilizzo delle macchine, delle attrezzature e dei prodotti chimici detergenti e disinfettanti comunemente utilizzati, nella formazione dell’operatore, nel controllo del risultato e nella descrizione dei possibili rischi che possono derivare dallo svolgere questa attività. Infatti, ogni scelta effettuata dal datore di lavoro deve essere, come sempre, frutto di un’attenta valutazione dei rischi, che tenga conto dei molteplici fattori che influiscono sulle modalità e sulla frequenza di attuazione di
ogni singola azione di pulizia e disinfezione. Nella sezione finale propone un’utile appendice che si pone sotto forma di check list per le attività da svolgere nei differenti ambienti della vita lavorativa.
Il documento, che si presenta come un manuale pratico e di facile consultazione, si pone altresì il fine di diffondere la conoscenza di questo tema in modo trasversale fra i lavoratori, i datori di lavoro e fra tutte le figure della prevenzione auspicando di essere un riferimento per integrare i percorsi formativi dedicati alla formazione dei SPP.
La sanificazione
La drammatica esperienza vissuta durante la pandemia da Covid 19 ha messo in evidenza un problema spesso sottovalutato: il fatto che le superfici possono essere veicolo di trasmissione di agenti patogeni. Questo è stato un esito di non poco conto perché ha reso le persone consapevoli che la pulizia e la sanificazione sono un mezzo fondamentale per tutelare la salute e impedire che microrganismi patogeni proliferino sulle superfici inanimate di luoghi di vita e di lavoro. Sanificare, oltre che racchiudere il concetto di manutenzione degli edifici e il mantenimento di condizioni di benessere e di decoro, diventa quindi, una vera e propria misura di prevenzione.
Per la prima volta si è parlato seriamente, anche a livello istituzionale, di sanificazione che rappresenta un “complesso di procedimenti e di operazioni” che comprende attività di pulizia e attività di disinfezione, che vanno intese “come un insieme di attività interconnesse tra di loro”. Si può senza dubbio affermare che, finché la gente ricorderà i sacrifici affrontati durante la pandemia da Covid-19 e di come sia stato possibile uscirne, grazie anche all’innalzamento degli standard di pulizia e ai lavoratori che li hanno resi possibili, fino ad allora avremo a disposizione un’incredibile arma di prevenzione che consentirà di vivere in ambienti più puliti, più sicuri, più sani e, di conseguenza, migliori per il benessere collettivo.
Pianificazione e organizzazione delle attività di sanificazione
Le prestazioni oggetto delle attività di sanificazione possono essere classificate nelle seguenti tipologie: ordinarie, di cadenza/periodiche, aggiuntive e straordinarie.
L’effettiva esecuzione di tutte queste attività, inserite nel Piano Operativo delle Attività, deve risultare da un apposito Verbale, predisposto mensilmente ed accettato dal Responsabile del Servizio, necessario alla successiva rendicontazione e fatturazione.
Tutte le attività devono essere effettuate accuratamente e a regola d’arte con l’impiego di mezzi e materiali idonei in modo da non danneggiare i pavimenti, le vernici, gli arredi e quant’altro presente negli ambienti oggetto delle attività. Le operazioni di pulizia devono essere condotte da personale adeguatamente formato, dotato delle migliori strumentazioni professionali disponibili, dei materiali più idonei a risolvere, di volta in volta, le diverse necessità d’intervento, finalizzate ad assicurare le migliori condizioni d’igiene dell’ambiente per garantire uno svolgimento sano delle attività nel pieno rispetto dell’immagine dell’Amministrazione. Durante lo svolgimento delle attività devono essere osservate, come disposto dal d.lgs. n. 81/08 e s.m.i., tutte le misure prescritte a tutela della salute e della sicurezza dei lavoratori. In generale tutte le operazioni di sanificazione devono essere organizzate in modo che non interferiscano con le normali attività dei luoghi interessati. Sarà cura del Responsabile

112 DIMENSIONE PULITO | 04/2024
IMPRESE DI PULIZIA
del Servizio comunicare le necessarie informazioni al committente in sede di predisposizione del Piano Operativo delle Attività, l’appaltatore coopererà, inoltre, all’attuazione delle misure di protezione e prevenzione al fine di eliminare i rischi da interferenze, e le coordinerà insieme al committente. Il datore di lavoro committente redige il Documento Unico di Valutazione dei Rischi da Interferenze (DUVRI) che deve essere allegato al contratto di appalto e dovrà essere adeguato in funzione delle evoluzioni del servizio fornito (art 26 d.lgs. 81/08).
Il controllo del risultato È importante controllare il risultato delle operazioni di pulizia accertandosi che siano stati raggiunti gli standard igienici prefissati. I controlli saranno sia di tipo sia quantitativo che qualitativo. Se il servizio di pulizia è stato affidato a una ditta esterna è bene verificare in primo luogo la rispondenza delle attrezzature utilizzate con quelle definite in fase di contratto: macchinari, prodotti chimici e altre strumentazioni indicate nel progetto tecnico.
Attraverso il Controllo di Processo verrà verificata l’applicazione delle procedure e delle istruzioni operative, nonché l’impiego della strumentazione inserita nel capitolato per l’erogazione del servizio. Dovrebbe essere svolto, almeno mensilmente, dalla persona/ufficio incaricati per tale compito, preferibilmente avvalendosi di una modulistica, in cui registrare gli esiti del controllo di qualità al fine di monitorare la corrispondenza tra l’esecuzione delle attività e i requisiti definiti nel Capitolato Tecnico e nel Progetto Tecnico. Il controllo potrà avvenire in maniera programmata, a campione o su tutte le aree interessate, o a seguito di una segnalazione.
Il mancato rispetto dei livelli definiti per i fattori di giudizio porta alla rilevazione di una segnalazione.
Il controllo dell’esecuzione dell’attività indicata nel Piano Operativo delle Attività deve risultare da un apposito “Verbale di Controllo” che consiste in un elaborato mensile attestante, oltre ai controlli giornalieri, ogni eventuale Attività Straordinaria, ogni eventuale attività aggiuntiva e/o integrativa richiesta.
Gli strumenti di controllo dei livelli di pulizia e igiene ambientale
In ambienti non pubblici solitamente il controllo del livello igienico raggiunto è fatto con un attento esame visivo. Tuttavia, una superficie visivamente pulita può anche non essere tale dal punto di vista igienico.
Tutti i monitoraggi di seguito descritti, si effettuano in concomitanza agli audit di igiene, con cadenza periodica, al fine di tracciare le attività di autocontrollo, intervenire con eventuali azioni correttive e/o di miglioramento e garantire l’efficacia dei trattamenti di sanificazione delle superfici.
Controllo rapido della pulizia ambientale. Un
monitoraggio rapido e visivo del grado di pulizia di una superficie può essere effettuato attraverso le seguenti metodologie:
- il monitoraggio della polvere sulle superfici non calpestabili effettuato con la Scala di Bacharach;
- il monitoraggio della polvere sulle superfici calpestabili dure e resilienti effettuato con il Bassoumetro;
- il monitoraggio della brillantezza sulle superfici calpestabili effettuato con il Glossmetro digitale a 3 angoli.
Controllo rapido dell’igiene ambientale. Può essere effettuato con due metodologie:
- Monitoraggio del livello di contaminazione
microbiologica delle superfici che viene effettuato con uno strumento portatile (Bioluminometro) in grado di rilevare la presenza di ATP (adenosin-trifosfato), molecola chimica che fornisce energia nei processi cellulari; pertanto, la sua presenza, è indice di contaminazione microbica.
- Monitoraggio effettuato con kit rapidi validati riconosciuti a livello internazionale per rilevare la presenza di residui organici invisibili (proteine, zuccheri e amidi) sulle superfici.
Fonte: La sanificazione nel post pandemia. La standardizzazione dei processi. Inail 2023; collana Salute e sicurezza.
Il mancato rispetto dei livelli definiti per i fattori di giudizio porta alla rilevazione di una segnalazione.

113 DIMENSIONE PULITO | 04/2024
Enjoy + Solution by Hygenia
In recent years, the European Union has taken decisive measures to reduce single-use plastic and combat environmental pollution. One of the most significant initiatives is Directive (EU) 2019/904 of the European Parliament and of the Council, known as the “Single-Use Plastics Directive.”
This directive aims to reduce the impact of specific plastic products on the marine environment and promote a circular economy. The Directive on Sustainable Use of Plastics has a direct impact on the hospitality industry, requiring hotels to progressively eliminate single-use plastic
products such as bottles and containers for personal hygiene items. This transition presents challenges but also opportunities for hotel operators who seek to comply with environmental regulations while maintaining high service standards for guests.

In response to this sustainability imperative, Hygenia introduced an innovative dispenser, Enjoy, several years ago, which represents a smart and eco-friendly alternative to traditional single-use courtesy line bottles. At the 2024 edition of Interclean Amsterdam, Hygenia is unveiling the evolution of this solution with the Enjoy + dispenser. Enjoy + is
La Soluzione Enjoy + di Hygenia
Negli ultimi anni, l’Unione Europea ha adottato misure decisive per ridurre l’uso di plastica monouso e contrastare l’inquinamento ambientale. Una delle iniziative più significative è la Direttiva (UE) 2019/904 del Parlamento europeo e del Consiglio, conosciuta come la “Direttiva sulla plastica monouso”. Questa direttiva mira a ridurre l’impatto di specifici prodotti di plastica sull’ambiente marino e promuovere un’economia circolare. La Direttiva sull’uso sostenibile della plastica ha un
impatto diretto sull’industria dell’ospitalità, richiedendo agli hotel di eliminare progressivamente prodotti di plastica monouso come bottiglie e flaconi per prodotti di igiene personale. Questa transizione presenta sfide ma anche opportunità per gli operatori alberghieri che desiderano conformarsi alle normative ambientali mantenendo elevati standard di servizio per gli ospiti. In risposta a questa esigenza di sostenibilità, Hygenia aveva creato già diversi anni fa un dispenser innovativo, Enjoy,
che rappresenta un’alternativa intelligente ed ecologica alle tradizionali bottiglie monouso delle linee cortesia.
Nella edizione 2024 di Interclean Amsterdam, Hygenia presenta l’evoluzione, il dispenser Enjoy* + non è solo un dispenser, ma una dichiarazione di intenti verso un futuro più sostenibile per l’ospitalità europea. Oltre ai benefici ambientali, Enjoy + offre vantaggi pratici agli operatori alberghieri. Le notifiche intelligenti del sistema avvisano il personale quando le scorte di prodotti per l’igiene
not just a dispenser; it is a commitment to a more sustainable future for European hospitality. In addition to environmental benefits, Enjoy + offers practical advantages to hotel operators.
The system’s smart notifications alert staff when hygiene product supplies are running low, optimizing inventory management and reducing operational costs associated with replenishment.
To learn more about Hygenia and Enjoy + and how it can help your hotel save, visit the page: www.hygenia.it/calcola-il-tuo-risparmio.
sono in esaurimento, ottimizzando la gestione dell’inventario e riducendo i costi operativi legati al rifornimento. Abbracciando tecnologie innovative e pratiche ecologiche, gli hotel possono trasformare il loro approccio alla gestione degli articoli per l’igiene personale, contribuendo a preservare l’ambiente e a garantire esperienze memorabili per gli ospiti. Per saperne di più su Hygenia e Enjoy + e su come possa aiutare il tuo hotel a risparmiare visita la pagina: www.hygenia.it/calcola-il-tuo-risparmio
sponsored content
hygenia.it





Planetary Health Festival 2024
To be held in Verona October 3-5, the Planetary Health Festival 2024 will explore crucial issues such as climate change, biodiversity and access to essential services, promoting a holistic vision for a global and sustainable future
Fabio Chiavieri

Last year, the world's population exceeded 8 billion people; in the early 1900s it was only 1.5 billion. Another constantly rising parameter is the planet's temperature: recently the
World Meteorological Organization identified 2023 as a record year, and the WHO secretary now calls this an era of global boiling.
Fifty percent of the world's economy, according to the World Economic Forum, is threatened by the collapse of biodiversity and the very high increase in zoonoses. Moreover, even more alarmingly, 30 percent of the world's
116 DIMENSIONE PULITO | 04/2024
EVENTS

population still cannot access essential services. Pope Francis says we are living through a change of epochs and, in fact, as many scholars also argue, a new geological era is beginning. For over 11,000 years we have had the Holocene, but humans have had such a strong and transformative impact on the world that we now speak of a new geological era called the Anthropocene.
What is clear from this plurality of elements is that it is imperative to work urgently to rebalance the relationship between humans and natural systems. And from here, comes the vision
of Planetary Health, i.e., the highest attainable level of equity health and well-being worldwide through balanced governance on the one hand of the political, human, economic, and social systems that determine the world's future, and on the other hand of the Earth's natural systems that define the environmental boundaries within which humanity can develop. In other words, planetary health brings together human health with animal, environmental, and social health in a global perspective, because what happens in a place far away from us can quickly have repercussions in Italy as well.
THE FESTIVAL
COLLABORATE ON THIS
EVENT
(LIST UPDATED TO 13/03/2024)
Partners
Comune di Verona
Edra
Patronages
Altems
CesDirSan
Cittadinanza Attiva
FIMG
Fmp
Fno TSRM e PSTRP
FNOFI
FNOVI
Lab GOV.city
Luiss law, digital innovation, sustainability
LUISS
Pontificia Accademia per la Vita
Università Cattolica
Precisely in order to affirm this very important vision, Edra has created Healtival, a company that will be responsible for organizing the planetary health festival to be held in Verona from October 3-5. The decision to hold this event in Verona was made because this city more than any other embodies balance from an environmental point of view. Three days to affirm this vision, create awareness among institutions up to citizens, clearly passing through all professionals, while identifying concrete actions and strategies to measure them and, above all, shar-
ing what are the best practices. In addition to the municipality of Verona, the Ministry of Health, the Ministry of the Environment, of the Pontifical Academy of Life, universities, institutions, businesses, foundations, and the third sector will lend their support. But above all it will be all of us because the effort to metabolize this vision will be so important.
THEMES
The agenda of this three-day Planetary Health Festival will include some plenary sessions and some more specific sessions where the issues of environmental sustainability and planetary health will be covered with the aim of giving a holistic view for a sustainable future. Global warming and all its effects such as zoonoses will be discussed, requiring a multidisciplinary approach among various professionals but also among ordinary people. Another very important topic that will be discussed in the plenary is the circular economy as a goal for all cities in the world in order to reorganize our lives and the structure of cities to pursue the concept of sustainability. In another plenary session, what is a new cultural ethical, philosophical and sociological horizon for the future of human life will be addressed in order

117 DIMENSIONE PULITO | 04/2024
to break down the culture of waste, of "disposable" consumerism, which does not care to save neither water, resources nor food.
The three days of the Planetary Health Festival will have many side activities such as: cultural paths, seminars, workshops, discussion tables, which will focus on more specific topics such as, for example, the impact of artificial intelligence on social health, the concept of the link between animal health and food safety and, therefore, the role of the veterinary professional in prevention policies. Workshops that can be important for disease prevention will also be organized involving many
actors including, for example, pharmacies and local authorities in the city of Verona. Energy will also be discussed because one cannot talk about planetary well-being without thinking about energy conservation and new forms of energy production, waste separation, and much more. Workshops and laboratories will investigate how waste can be reduced, involving the behavior of the individual citizen who can make a difference, without forgetting children, because the culture of saving is promoted from childhood.
Planetary health is the health of human civilization and the state of the natural systems on which it depends
One session will be devoted to mobility as one of the elements that can most impact environmental pollution. It will discuss sustainable mobility, new forms of mobility such as car sharing, bike sharing, new transportation systems that are increasingly being developed within Italian municipalities and beyond, and the concept of "clean area" applied by several municipalities to rid historic centers of private cars or otherwise combustion vehicles.
Another topic of vital importance that
will find ample space at the planetary health festival is that of food and consumption; in particular, the role that behaviors in consumption and eating habits can have on global sustainability and, therefore, on health and, consequently, on the spending that each state has to face for health care and the maintenance of health itself will be explored. But not only that. Food safety will be discussed here in order to avoid contamination and thus ensure a better lifestyle and avoid infection or spread of new diseases. The quality of life of people in adulthood will be another focus of the event. It will talk about sustainable aging, that is, how to be able to age healthily, what policies can be adopted so that people are active even in adulthood and old age, which can then contribute to the well-being of the community, to the economy of a country, but also and above all to reduce what is the economic and social impact that a generation of older people who do not age healthily can have instead.

118 DIMENSIONE PULITO | 04/2024 EVENTS
ECONATURAL, the real circular paper & dispenser system from beverage cartons

For 14 years EcoNatural has been synonymous with sustainable innovation. A project born from advanced technology that transforms
what is no longer needed into a resource, recycling all the components of beverage cartons thanks to a production process that is
ECONATURAL,
unique in the sector. Beverage cartons are an essential part of our daily lives. They are composed of cellulose fibres, polyethylene and aluminium and, if correctly sorted, can be recycled through a specific process.
Thanks to Lucart’s unique technology, the cellulose fibres are used to produce Fiberpack®, the raw material from which a complete range of toilet paper, towels, handkerchiefs, napkins and reels from the EcoNatural range is made.
The compound of polyethylene and aluminium, on the other hand, is used to produce Al.Pe®, which in turn is used to manufacture the dispensers, making it the only system able to offer a complete paper and dispenser
il vero sistema circolare dai cartoni per bevande
Da 14 anni EcoNatural è sinonimo di innovazione sostenibile. Un progetto nato da una tecnologia avanzata che trasforma ciò che non serve più in una risorsa, riciclando tutti i componenti dei cartoni per bevande grazie a un processo produttivo unico nel settore. I cartoni per bevande, infatti, sono una parte essenziale della nostra vita quotidiana. Sono composti da fibre di cellulosa, polietilene e alluminio e, se correttamente
selezionati, possono essere riciclati attraverso uno specifico processo. Grazie alla tecnologia esclusiva di Lucart, le fibre di cellulosa vengono utilizzate per produrre il Fiberpack®, la materia prima con cui viene realizzata una gamma completa di carta igienica, asciugamani, fazzoletti, tovaglioli e bobine della linea EcoNatural. Il compound di polietilene e alluminio, invece, viene utilizzato per produrre l’Al. Pe®, che a sua volta viene utiliz-
zato per fabbricare i dispenser, diventando così l’unico sistema in grado di offrire una soluzione completa di carta e dispenser realizzata interamente con cartoni alimentari riciclati. Nuovo Econatural FLOW: l’unico e il solo dispenser dai cartoni per bevande Lucart Professional presenta FLOW, la nuova gamma di dispenser della linea EcoNatural, realizzati in polietilene e alluminio provenienti da cartoni per
solution made entirely from recycled food cartons.
New Econatural FLOW: the one & only dispenser from beverage cartons
Lucart Professional presents FLOW, the new unique range of dispensers in the EcoNatural line, made from polyethylene and aluminium from beverage cartons, featuring a new exclusive and patented design with sinuous and elegant lines. The range includes dispensers for auto-cut towels, for centre-extension toilet paper, for folded towels, for jumbo toilet paper, for interleaved toilet paper and for refill soap, all in black and white finish. All FLOW dispensers are ReMade in Italy certified and are fully recyclable
bevande, e caratterizzati da un nuovo design esclusivo e brevettato, dalle linee sinuose ed eleganti. La gamma comprende dispenser per asciugamani a taglio automatico, per carta igienica ad estrazione centrale, per asciugamani piegati, per carta igienica jumbo, per carta igienica interfogliata e per sapone a ricarica, tutti in finitura bianca e nera. Tutti i dispenser FLOW sono certificati ReMade in Italy e sono completamente riciclabili
sponsored content
lucartprofessional.com
PLANETARY HEALTH FESTIVAL 2024
Si terrà a Verona dal 3 al 5 ottobre prossimi Planetary Health Festival 2024, l’evento dedicato alla salute planetaria che esplorerà temi cruciali come cambiamenti climatici, biodiversità e accesso ai servizi essenziali, promuovendo una visione olistica per un futuro globale e sostenibile
Fabio Chiavieri
Lo scorso anno, la popolazione mondiale ha superato gli 8 miliardi di persone, all’inizio del 900 erano solo un miliardo e mezzo. Un altro parametro in costante crescita è la temperatura del pianeta: recentemente l’Organizzazione Mondiale Meteorologica ha individuato il 2023 come anno record e il segretario dell’OMS definisce oramai questa un’era di ebollizione globale. Il 50% dell’economia mondiale, secondo il World Economic Forum, è minacciato dal collasso della biodiversità e dall’incremento elevatissimo delle zoonosi. Inoltre, dato ancora più allarmante, il 30% della popolazione mondiale ancora non riesce ad accedere ai servizi essenziali. Papa Francesco dice che stiamo vivendo non “un’epoca di cambiamenti” ma “un cambiamento di epoca” e, di fatto, come sostengono anche molti studiosi, sta iniziando una nuova era geologica. Per oltre 11 mila anni abbiamo avuto l’Olocene, ma l’uomo ha avuto un impatto così forte e trasformativo sul mondo, che oramai si parla di una nuova era geologica chiamata Antropocene. Quello che emerge chiaro da questa pluralità di elementi è che è indispensabile lavorare urgentemente per riequilibrare il rapporto tra uomo e sistemi naturali. E da qui, nasce la visione della Planetary Health, ovvero, il più elevato livello di salute e benessere di equità raggiungibile in tutto il mondo attraverso un’equilibrata governance da una parte dei sistemi politici, umani, economici e sociali determinanti per il futuro del mondo, e dall’altra dei sistemi naturali terrestri che definiscono i confini ambientali entro i quali l’umanità può svilupparsi. In altri termini la salute planetaria mette assieme la salute umana con quelle animale, ambientale, sociale in una prospettiva globale, perché quello che accade in un luogo molto lontano da noi (come abbiamo visto con il Covid) si può velocemente ripercuotere anche in Italia.
IL FESTIVAL
Proprio per affermare questa importantissima visione, Edra ha creato Healtival, una società che si occuperà di organizzare il festival della salute planetaria che si terrà a Verona dal 3 al 5 ottobre prossimi. La scelta di svolgere questo evento a Verona nasce perché questa città più
di altre incarna un equilibrio dal punto di vista ambientale.
Tre giorni per affermare questa visione, creare consapevolezza tra le istituzioni fino ai cittadini, passando chiaramente per tutti i professionisti, individuando al contempo azioni concrete e strategie per misurarle e, soprattutto, condividendo quelle che sono le migliori pratiche. Oltre al comune di Verona, daranno il loro sostegno il Ministero della Salute, il Ministero dell’Ambiente, della Pontificia Accademia della Vita, le università, gli enti, le imprese, le fondazioni, il terzo settore. Ma soprattutto saremo noi tutti perché lo sforzo di metabolizzare questa visione sarà importantissimo.
I TEMI COGENTI
L’agenda di questa tre giorni del festival del Planetary Health Festival prevede alcune sessioni plenarie e altre più specifiche in cui verranno trattate le tematiche della sostenibilità ambientale e della salute planetaria con l’obiettivo di dare una visione olistica per un futuro sostenibile. Si parlerà di riscaldamento globale e di tutti gli effetti da esso derivante come per esempio le zoonosi, che richiedono un approccio multidisciplinare tra i vari professionisti ma anche tra le persone comuni. Un altro argomento molto importante che verrà trattato in plenaria è quello dell’economia circolare in quanto obiettivo di tutte le città del mondo al fine di riorganizzare la nostra vita e le struttura delle città per perseguire il concetto di sostenibilità. In un’altra sessione plenaria verrà affrontato quello che è un nuovo orizzonte culturale etico, filosofico e sociologico per il futuro della vita dell’uomo per abbattere la cultura dello scarto, del consumismo “usa e getta”, che non si cura di risparmiare né acqua, né risorse né cibo. Le tre giornate del Planetary Health Festival potranno contare su tantissime attività collaterali quali: percorsi culturali, seminari, workshop, tavoli di discussione, che andranno a focalizzarsi su temi più specifici quali per esempio l’impatto dell’intelligenza artificiale sulla salute sociale, il concetto di legame tra salute animale e sicurezza alimentare e, quindi, il ruolo del professionista veterinario nelle politiche di prevenzione. Verranno organizzati anche laboratori che possono essere importanti per la prevenzione di malattie che coinvolgeranno molti attori tra cui, per esempio, le farmacie e gli enti territoriali sulla città di Verona. Si parlerà anche di energia perché non
si può parlare di benessere planetario senza pensare al risparmio energetico e alle nuove forme di produzione dell’energia, alla raccolta differenziata e a molto altro ancora. Workshop e laboratori indagheranno come si può ridurre lo spreco, coinvolgendo il comportamento del singolo cittadino che può fare la differenza, senza dimenticare i bambini, perché la cultura del risparmio si promuove fin dall’infanzia. Una sessione verrà dedicata alla mobilità come uno degli elementi che più può impattare sull’inquinamento ambientale. Si parlerà di mobilità sostenibile, delle nuove forme di mobilità come il car sharing, il bike sharing, i nuovi sistemi di trasporto che si stanno sempre più sviluppando all’interno dei comuni italiani e non solo, e del concetto di “area pulita” applicato da diversi comuni per liberare i centri storici dalle auto private o comunque dai mezzi a combustione.
Un altro argomento di vitale importanza che troverà ampio spazio al festival della salute planetaria è quello dell’alimentazione e dei consumi, in particolare, si approfondirà il ruolo che i comportamenti nei consumi e nelle abitudini alimentari possono avere sulla sostenibilità globale e, quindi, sulla salute e, conseguentemente, sulla spesa che ogni Stato deve affrontare per la sanità e per il mantenimento della salute stessa. Ma non solo. In questo ambito si discuterà di sicurezza alimentare al fine di evitare contaminazioni e garantire, quindi, un miglior stile di vita ed evitare infezioni o diffusioni di nuove malattie.
La qualità della vita delle persone in età adulta sarà un altro tema al centro dell’evento. Si parlerà dell’invecchiamento sostenibile, cioè di come poter invecchiare in salute, di quali politiche poter adottare affinché le persone siano attive anche nell’età adulta e anziana, che possono quindi contribuire al benessere della collettività, all’economia di un paese, ma anche e soprattutto per ridurre quello che è l’impatto economico e sociale che può avere invece una generazione di anziani che non invecchiano in salute.

120 DIMENSIONE PULITO | 04/2024
EVENTI

Falpi achieves a new milestone: the ECOVADIS Silver Top Certification for Corporate Sustainability
In February, Falpi obtained the ECOVADIS Silver Top certification: a prestigious recognition certifying the ongoing commitment to pursuing a virtuous path of corporate sustainability.
ECOVADIS, one of the most important international platforms for rating corporate sustainability, evaluated Falpi based on 21 aspects grounded in international CSR (Corporate Social Responsibility) standards, grouped into 4 key parameters: environment, labor and human rights protection, fair business practices, and sustainable procurement. The first parameter, Environment, reflects Falpi’s focus on reducing the environ-
mental impact of its activities. FALPI ranks within the top 14% of best-rated companies assessed by ECOVADIS in the Textile Production sector, positioning itself as a leader in environmental sustainability.
Labor Practices and Human Rights constitute the second parameter, emphasizing Falpi’s commitment to ensuring a safe, fair, and human rights-respecting work environment for all its employees. Falpi has always been dedicated to promoting diversity, inclusion, and respect for fundamental labor rights in all its activities. In this regard, FALPI ranks within the top 1% of best-rated companies as-
sessed by ECOVADIS in the Textile Production sector, highlighting its excellence in labor practices and human rights.
Ethics, the third parameter under evaluation, represents another fundamental pillar for Falpi, which adopts ethical policies and procedures guiding its decisions and actions, ensuring transparency, integrity, and legal compliance in all its activities.
Lastly, the fourth parameter, Sustainable Procurement, reflects Falpi’s commitment to collaborating with suppliers who share its sustainability values and social responsibility. The company actively promotes sustai-
nable supply chain practices, working with partners who adopt ethical and environmentally responsible practices.
“We are interested in using the rating issued by ECOVADIS - Andrea Loro Piana, CEO Falpi - as a reference point, as a starting point for continuous improvement in the sustainability of our actions.

Falpi raggiunge un nuovo traguardo: l’attestazione ECOVADIS Silver Top per la sostenibilità aziendale
Falpi ha ottenuto in febbraio l’attestazione ECOVADIS Silver Top: un riconoscimento prestigioso che certifica il costante impegno nel perseguire un virtuoso percorso di sostenibilità aziendale. ECOVADIS, una delle più importanti piattaforme internazionali di rating della sostenibilità aziendale, ha valutato Falpi in base a 21 aspetti basati su standard RSI internazionali (Responsabilità Sociale d’Impresa) riuniti in 4 parametri chiave: ambiente, tutela dei lavoratori e diritti umani, prassi aziendali eque e approvvigionamento sostenibile. Il primo,
l’Ambiente, riflette l’attenzione di Falpi nel ridurre l’impatto ambientale delle sue attività. Falpi si trova nel 14% delle migliori aziende valutate da ECOVADIS nel settore Produzione Tessili, posizionandosi tra i leader nel campo della sostenibilità ambientale. Le Pratiche Lavorative e i Diritti Umani costituiscono il secondo parametro, sottolineando l’impegno di Falpi per garantire un ambiente di lavoro sicuro, equo e rispettoso dei diritti umani per tutti i suoi dipendenti. Falpi si impegna da sempre a promuovere la diversità, l’inclusione e il rispet-
to dei diritti fondamentali dei lavoratori in tutte le sue attività. In questo ambito, Falpi si trova nel 1% delle migliori aziende valutate da ECOVADIS nel settore Produzione Tessili, evidenziando così la sua eccellenza nelle pratiche lavorative e nei diritti umani. L’Etica, il terzo parametro in valutazione, rappresenta un altro pilastro fondamentale per Falpi che adotta politiche e procedure etiche che guidano le sue decisioni e le sue azioni, garantendo trasparenza, integrità e conformità legale in tutte le sue attività. Infine, il quarto parametro, gli Acquisti
Sostenibili, riflette l’impegno di Falpi nel collaborare con fornitori che condividono i suoi valori di sostenibilità e responsabilità sociale. L’azienda promuove attivamente la catena di approvvigionamento sostenibile, lavorando con partner che adottano pratiche etiche e ambientalmente responsabili. “Siamo interessati ad utilizzare il rating rilasciato da Ecovadis - dichiara Andrea Loro Piana, AD Falpi - come punto di riferimento, come base di partenza per un miglioramento continuo nella sostenibilità delle nostre azioni”.
sponsored content
falpi.com
SIMPLIFY: The first carbon neutral range of Papernet
Carbon neutral companies, processes and products are those whose calculated CO2 emissions have been offset through the support of internationally recognized climate protection projects. From Papernet’s continuous research comes the new Simplify range, the first fully Carbon Neutral product line, created with the aim of contributing in a concrete and tangible way to global climate protection. Together with ClimatePartner we calculate the environmental footprint of Simplify products, thus defining the exact amount of CO2 that will be offset through a climate protection project. Papernet has chosen to protect the virgin forest of Lábrea, in the Brazilian federal state of Amazonas, which had the fourth highest deforestation rate in Brazil between 2008 and 2020. Ecosystems have been damaged and social conflicts
have occurred due to the theft of timber, the construction of new roads and the intensification of agriculture and animal husbandry, leading to the forced migration of local communities. With the help of monitoring activities and training courses for the local population, the project aims to control deforestation and safeguard the great variety of plants and animals in the Amazon rainforest. Forests are among the main absorbers of CO2, are home to a huge variety of species and are the source of livelihoods for local communities
However, the world’s forest areas have declined sharply in recent decades, due to increased human settlements, agricultural exploitation, illegal logging and the extraction of raw materials. Those involved in the project are protecting the area from deforestation together with the local popu-

lation, creating alternative economic livelihoods and training.
Moreover, as an additional commitment, for every tonne of CO2 offset, we plant a tree in Germany, thereby contributing to the adaptation of our forests to climate change. European ecosystems are affected by climate change: forest fires are destroying large areas and pests are spreading particularly fast in weakened forests. Tree species such as spruce suffer from drought and heat because

they have surface roots that do not reach the deeper layers of soil containing water reserves. This is why we support the afforestation and conversion of forests to mixed forests.
Our commitment to fighting climate change also goes through credible and transparent communication.
The ClimatePartner label on our packaging indicates that the product’s non-avoidable emissions have been calculated and offset through the Virgin Forest Protection Project (Lábrea, Brazil).
The unique ID number and the respective web address make it possible to track the exact amount of CO2 offset by Papernet and to obtain information on the climate protection project supported.

sponsored content
papernet.com



ON THE MARKET
development:
ADIATEK
Coral 80m II: Adiatek range is expanding
Coral 80m II is the new Adiatek floor scrubber: the 80cm brush base, the large tanks (100/105 l), the front-wheel drive and the high autonomy (over 4 hours) make this machine particularly suitable for large industries and structures, as well as for shopping malls. This model, which enters the market immediately after the Coral 65mII, expands and completes the Coral range. Thanks to the drive wheel, the intuitive human-machine interface, the innovative electronics and the new “low chamber” squeegee, this machine guarantees excellent performance and maintains a low cost. The new washing unit is made up of two independent gearmotors which ensure high cleaning quality and a higher level of silence. adiatek.com


CHRISTEYNS
The new generation system for mechanical dishwashing
The DUO Solid concept combines a solid detergent and a solid rinse aid in one dosing unit. This 2-in-1 dosing system is a unique concept for automatic dishwashing. The DUO Solid dosing unit doses both detergent and rinse aid directly into the wash stream. This automated, computer-controlled dosing action ensures a more precise and constant product level in the washing process than manual or hydraulic dosing. This means savings on product usage during the entire wash cycle. Christeyns offers 2 products compatible with the Duo Solid equipment. GREEN'R Autodish Solid as a highly concentrated solid detergent and Rinse Solid as a rinse aid both are suitable for the cleaning and maintenance of kitchen utensils in all types of professional dishwashers. christeyns.com
124 DIMENSIONE PULITO | 04 /2024 PRODUCT REVIEW edited by Loredana Vitulano
TODAY
latest
the cleaning world
Technology, research,
the
news from
ESSECINQUE
Aluminium frame with lock system and microfiber/cotton flat mop
The aluminium frame for hook and loop fastening system mops is an extraordinary cleaning product. The practical lock system allows the frame to clean any uneasy area by reaching even the most difficult points. The central block is released and moves to the side thanks to an easy movement. The frame suits the microfiber and cotton Microfast flat mop, the hook and loop fastening system mop of Essecinque: microfiber removes dirt and cotton keeps the mop wet for a long time, ensuring to clean many more meters of surface.
essecinque.net


ITALCHIMICA
Sistema Quantum. Ecology and savings
Sanitec Quantum is the line of concentrated liquid detergents developed specifically for professional fabric care. The system, comprising detergent, softener and additives, is Ecolabelcertified and meets the highest verified environmental requirements, thus representing a concrete commitment to sustainability. Formulations in the Quantum line are up to 3 times more concentrated than standard products, thus ensuring high performance with lower dosages and optimised running costs. Furthermore, thanks to the synergy between surfactants and enzymatic components, the system is designed to be active even at low temperatures, thus reducing washing costs and time, preserving fabrics for longer and contributing to reduced transport impact.
italchimica.it
KAIROSAFE
Lumitester Smart, the innovative bioluminometer for verifying the hygiene of surfaces
The effectiveness of the cleaning and sanitization processes can be easily checked with the use of an instrument called a bioluminometer which allows you to instantly check the hygiene level. The test is carried out with a special swab, which is swiped on the surface to be examined and then inserted into the bioluminometer to read the result. It should immediately be clarified that the instrument does not provide a direct measurement of the bacterial or viral load but detects the presence of organic material by measuring ATP, as happens with most bioluminometers, or ATP+ADP+AMP (A3), as happens with the Lumitester Smart. Whether the contamination arises from biofilm, bacteria or body fluids, ATP analysis is a universally recognized test for verifying cleaning protocols. The Lumitester allows you to obtain a general and rapid view of hygiene conditions, making it an essential tool in environmental sanitization processes. kairosafe.it

125 DIMENSIONE PULITO | 03/2024

L.R. FLAVOURS
Ethereal. Fragrance for scenting laundry
Ethereal, the new and captivating fragrance collection for scenting laundry, transforms every fabric care moment into an enveloping and relaxing experience. Inspired by the ethereal and engaging atmosphere of moments of pure relaxation, Ethereal fragrances wrap garments in a cloud of freshness, cleanliness, and comfort. Each fragrance in the collection, such as Cotton, Silk, Wool, Velvet, Jersey, is an essence of pure sophistication, created to evoke feelings of tranquility and harmony. Choose the fragrance that reflects the style of your product. Ethereal is more than just a collection; it's a touch of elegance, a moment of pure sensory pleasure. lrindustries.it
MAR PLAST
Sand&Stone collection, functionality meets aesthetics
Transforming public bathrooms into modern, welcoming spaces with innovative design solutions is Mar Plast mission, perfectly embodied in the new Sand&Stone collection. Made in recycled plastic, this line fits a granular texture, original and innovative. The color variants inspired to natural elements, Stone, a sophisticated dark grey, and Sand, an elegant beige suit any setting in a discreetly yet distinctly way. The design is contemporary, minimalist, and refined, crafted to minimize the profile of the consumable inside the dispenser, like a 'skin' that envelops the interior. Here, functionality meets aesthetics in a perfect match without compromises. marplast.it


LW44-52 Flexy Hybrid. Maximum comfort
The Lindhaus "LW44-52 Flexy Hybrid" batterypowered scrubber drier has a patented center joint that offers two modes of use: with a locked neck for maximum comfort and zero effort, or free to rotate 360 degrees. It folds down for access under tables and folds up for car transport. Only the 6lt clean water tank is placed on the body frame, this minimizes the handle weight. There is no limitation on the angle of use as all motors, battery and recovery tank are placed on the base. The 20Ah lithium battery allows 90 minutes of work in "ecomode". The "washable Hepa" filter is also standard and floor sanitizing function with UV-C led light technology (optional), which are especially important for healthcare environments.
lindhaus.it
126 DIMENSIONE PULITO | 04/2024 PRODUCT REVIEW
LINDHAUS
NETTUNO
Nettuno. Effective solutions for the communities
Attention to cleaning and disinfection of hands and surfaces is an essential element in the creation of proper hygiene and safety conditions. In particularly sensitive contexts, such as the food industry, healthcare, offices, but also home environments and areas subject to HACCP regimes, the need to adopt effective disinfection measures is crucial to prevent the spread of pathogens and complete professional cleansing with the elimination of viruses, fungi and bacteria. Nettuno R&D team, always at the forefront of developing innovative solutions, presents the new line of products for cleaning and disinfecting hands, surfaces, and for the treatment of swimming pools, accredited by the Italian Ministry of Health by PMC decree no. 23/2022.
nettuno.net

PAPERDI

AVANECO. Flexibility of use, attention to the environment Paperdi produces tissue paper for hygienic, sanitary, cleaning and industrial applications. Thanks to the integrated cycle, the company produces products with high quality raw materials and offers a range of products in pure cellulose and recycled paper: rolls of kitchen and kitchen towels, medical rolls, toilet paper, interfaced towels. The high quality combined with a consumer-oriented policy have made Paperdi a leading company in the national market with a development model that can reconcile business growth with customer satisfaction, value creation and environmental protection. With the V-folded towels of the new AVANECO line these two values are highlighted: the product is 100% sustainable and recyclable, from sheets to the packaging that is totally made of paper (free plastic) it facilitates the process of refilling the dispenser by helping the operator to do his job faster, using only a piece of garbage to dispose of the waste. Flexibility of use, attention to the environment, ease of use are definitely the key to the success of this product.
paperdi.it
POLYCHIM
FLASH JOY
Super-concentrated alcohol-based and pH-neutral detergent suitable for daily cleaning of all water-washable hard surfaces. It dries quickly without leaving streaks, it does not foam, it can be used by hand or with a floor cleaning machine, it leaves rooms with a pleasant and fresh citrus scent. Suitable for furniture and shiny floors for quick cleaning without rinsing, such as: ceramic, polished stoneware, leaded or polished stone, painted parquet. Advantages: the high concentration and the dosing systems facilitate the control of consumption, the containment of costs and the reduction of empty packaging to be disposed of. Available in various formats: 20 ml single dose, 1L bottle with measuring cup, 5L canister for dosing or dilution systems.
polychim.it

127 DIMENSIONE PULITO | 03/2024
ROSIWIT
Titan 810. The professional and reliable industrial scrubber robot
Titan 810, a professional industrial cleaning robot focused on large scene floor cleaning like warehouses, logistics and parkings. The cleaning features of Titan 810 include scrubbing version and scrubbing-sweeping 2-in-1 version to meet high quality cleaning requirements. Besides, with a 6-in1 workstation, technical sensors and cloud-based management platform equipped, this professional can offer you an efficient and safe cleaning. rosiwit.com



TTS
Effective and efficient without compromise
Laboratory tests confirm that Microred effectively removes viruses and bacteria from surfaces: specifically, 99.9% of Coronavirus 229E and up to 96.6% of the bacteria Staphylococcus aureus ATCC 6538, Pseudomonas aeruginosa ATCC 15442 and Enterococcus hirae ATCC 10541, ensuring a high level of hygiene. Not only effective, TTS's new microfibre is also sustainable: it is EU Ecolabel-certified, made with solar energy and passed the test according to ISO 23231 showing a low release of microplastics during machine washing. ttsystem.com
STI STEAM INDUSTRY
BugsBuster, effective solution to the control of the pests
BugsBuster is a new single-phase steam generator designed by STI Steam Industry specifically for a bedbug free environment. Its innovative approach provides an eco-friendly and highly effective solution to the control of these pests. The steam produced by BugsBuster differs from other steam generators because it is compressed and super-heated again before being dispensed. Bugsbuster is equipped with a 1200W superheating element that raises the steam temperature from 156°C to 220°C. Such temperature is necessary to eradicate bedbugs and various pests on the spot without dispersing them into the environment. The superheated, saturated steam penetrates deep into fabric surfaces, eliminating both bed bugs and their eggs, even if they are deposited in the most impenetrable hiding places. The super-dry steam generated does not wet mattresses, upholstery, fabrics, etc. The use of BugsBuster, additionally, guarantees very clean surfaces, free from bacteria and microorganisms. BugsBuster will be on display at Interclean, at STI Steam Industry booth #203, in Hall 5. stindustry.it

128 DIMENSIONE PULITO | 03/2024 PRODUCT REVIEW
INNOVAZIONE INNOVATION
Nuove frontiere nell’analisi degli alimenti
New frontiers in food analysis
SICUREZZA
SAFETY
Il ruolo dei detergenti nella resistenza antimicrobica
The role of detergents in antimicrobial resistance
PEST CONTROL
Parassiti nella
filiera alimentare
Parasites in the food supply chain
















ANNO 33 n. 4 MAGGIO 2024
Bioluminometro - Lumitester Smart
Strumentino portatile che rileva in tempo reale il grado di pulizia delle superfici.
Kairosafe propone il Lumitester Smart abbinato ai tamponi Lucipac A3, con i quali si preleva il campione.
Il test, rapido e preciso, è utilizzabile per il controllo della sanificazione in tutti gli ambiti, farmaceutico, alimentare, sanitario, HO.RE.CA, industriale ecc
Per ordinare su www.kairosafe.it cerca i codici:

codice 61324 - Lumitester Smart
codice 1702671-60361 - Lucipac A3 Surface, tamponi
codice 1702672-60365 - Lucipac A3 Water, tamponi
Il sistema evidenzia la presenza di sostanza organica (ATP e derivati) ed è di utilizzo molto semplice. Essenziale per il confronto prima e dopo la pulizia. I risultati sono visualizzati sul display e memorizzati nell’archivio cloud a cui si può accedere in qualsiasi momento per un continuo monitoraggio dei dati.
Visita il nostro e-shop e scarica gli approfondimenti tecnici
TEL 040 299502-2907149 WWW.KAIROSAFE.IT INFO@KAIROSAFE.IT SOLUZIONI PER IL CONTROLLO QUALITA’ KAIROSAFE
-------------------- Igiene delle superfici --------------------










































Contact us: info@igeax.com | www.igeax.com improve hygiene standards make cleaning protocols more effective manage your equipment correctly reduce the risk of cross-contamination DISCOVER THE RANGE Eager to learn more about the game-changing innovations for the food sector Made in Italy? STAND 05.418 Come and discover IGEAX’s world at Improving hygiene and safety in the food industry with the orange range THE
Rely on COLOUR CODE to:
ORANGE IMPERATIVE
MARKA per le industrie alimentari

Nel vasto panorama delle industrie alimentari, la pulizia e l’igiene sono due pilastri irrinunciabili per garantire la sicurezza e la qualità dei prodotti destinati al consumatore finale. Per implementare un’attenta attività di cleaning e disinfezione nelle industrie alimentari è necessario ricorrere all’utilizzo di detergenti professionali, i quali svolgono un ruolo fondamentale nell’assicurare ambienti di lavoro puliti e sicuri. La scelta dei detergenti è legata anche alle tipologie di sporco e
superfici da trattare ragion per cui è necessario selezionare soluzioni di cleaning professionali e specifiche, affinché siano garantite performance, igiene e sicurezza.
Marka, brand di MK spa, propone alcune soluzioni appositamente sviluppate dal suo laboratorio interno di R&D per i principali bisogni di cleaning nei contesti alimentari.
BASIFOAM 187 e FOAMCLOR LF, due detergenti alcalini schiumogeni (il
MARKA for food industry
In the vast landscape of the food industry, cleanliness and hygiene are two essential pillars to ensure the safety and quality of products destined for the end consumer. To implement careful cleaning and disinfection activities in the food industry, it is necessary to use professional detergents, which play an important role in ensuring clean and safe work environments. The choice of detergents is also linked to the
types of dirt and surfaces to be treated, so it is necessary to select professional and specific cleaning solutions to ensure performance, hygiene, and safety. Marka, brand of MK spa, offers some solutions specially developed by its in-house R&D laboratory for the main cleaning needs in food contexts. BASIFOAM 187 and FOAMCLOR LF, two foaming alkaline detergents (the latter based on active chlorine), usable with low
secondo a base di cloro attivo), utilizzabili con schiumatrici a bassa ed alta pressione, ideali per la pulizia ed igienizzazione di superfici, pavimenti e macchinari dell’industria alimentare. Per la rimozione di residui inorganici e per lavaggi CIP, DETER ACID NF è la soluzione ideale. Un detergente a base di acido fosfonitrico utilizzabile su tutte le superfici resistenti agli acidi.
MK OXI, invece, è il detergente a base di acido peracetico formulato per garantire un elevato potere
igienizzante su tutte le superfici resistenti agli acidi, senza lasciare residui e garantendo alte performance anche a basse temperature. Infine, DEGREASE 010 è lo sgrassatore specifico per rimuovere e dissolvere grassi animali e residui proteici da pavimenti, pareti ed attrezzature alimentari. È efficace su cappe e filtri e genera una magnifica schiuma con alto potere aggrappante. Investire nella pulizia e nell’igiene nelle industrie alimentari è una scelta etica e responsabile.
Marka è Protezione Profonda Professionale.

and high-pressure foamers, are ideal for cleaning and sanitizing surfaces, floors, and machinery in the food industry. For the removal of inorganic residues and CIP washes, DETER ACID NF is the right solution. A detergent based on phosphonitric acid, usable on all acid-resistant surfaces. MK OXI, on the other hand, is the peracetic acid-based detergent formulated to ensure high sanitizing power on all acid-resistant surfaces,
leaving no residues and ensuring high performance even at low temperatures. Finally, DEGREASE 010 is the specific degreaser for removing and dissolving animal fats and protein residues from floors, walls, and food equipment. It is effective on hoods and filters and generates magnificent foam with high gripping power.
Investing in cleanliness and hygiene in the food industry is an ethical and responsible choice.
informazione pubblicitaria
markacleaning.com



Scopri il nostro mondo su mkspa.com SISTEMI DI DETERGENZA INNOVATIVI, PER UN MONDO PIÙ ACCOGLIENTE. INNOVATIVE CLEANING SYSTEMS, FOR A MORE WELCOMING WORLD.
SOMMARIO IGIENE ALIMENTARE/FOOD HYGIENE

IN COPERTINA/COVER
Dal 1960, la storia di due generazioni unite dalla capacità di comprendere ed attuare continuamente i cambiamenti imposti dalla dinamica del mercato e dall’evoluzione dei consumatori con la coerenza e la forza d’animo derivanti dall’impostazione etica che mai deve cambiare. Rubino Chem è un’industria 4.0 e ha ottenuto la certificazione standard internazionale ISO 9001:2015 che stabilisce i requisiti per un sistema di gestione per la qualità.
Since 1960, the story of two generations united by the ability to understand and continuously implement the changes imposed by the dynamics of the market and the evolution of consumers with the coherence and strength of mind deriving from the ethical approach that must never change. Rubino Chem is an industry 4.0 and has obtained the international standard ISO 9001:2015 certification which establishes the requirements for a quality management system.
INNOVAZIONE INNOVATION
S 8
Tecniche omiche: la nuova frontiera nell’analisi degli alimenti
Omic techniques: the new frontier in food analysis
Elena Consonni
CASE HISTORY
S 16
Centro Carni Company: un esempio di best practices
Centro Carni Company: an example of best practices
Elena Consonni
ERRATA CORRIGE:
S 8

S 16

Segnaliamo che nell’articolo “Il metodo Seek and Destroy” pubblicato sul numero 01/2024 di Dimensione Pulito sono state riviste le dichiarazioni attribuite al dott. De Lucia. Leggi l’articolo completo dal QR code.
Please note that In the article "Il metodo Seek and Destroy" published in issue 01/2024 of Dimensione Pulito, statements attributed to Dr. De Lucia were revised. Full article available scanning the QR.

IMPIANTI FOOD PLANTS
S 20
L’acqua nell’industria alimentare
Water in the food industry
Stefania Milanello
SICUREZZA SAFETY
S 30
Resistenza agli antimicrobici: cause e conseguenze di un problema per la catena alimentare
Antimicrobial resistance: causes and consequences of a problem for the food chain
Francesca De Vecchi
DISINFESTAZIONE PEST CONTROL
Graziano Dassi
S 38
Gli antiparassitari nella filiera alimentare
Pesticides in the food supply chain
S44
Una novità nella lotta agli scarafaggi
A novelty in the fight against cockroaches
S 50
Filiera alimentare a 360° e il controllo dei roditori
All-around food supply chain and rodent control

S 20 S 30

S 50

Tecniche omiche: la nuova frontiera nell’analisi degli alimenti
Negli ultimi anni, grazie alla disponibilità di strumenti d'analisi sempre più performanti, si sono resi possibili nuovi metodi di indagine più performanti ma ancora molto costosi e di non facile interpretazione, ma destinati ad affermarsi in un futuro prossimo
Elena Consonni giornalista esperta in scienze e tecnologie alimentari

S•8 DIMENSIONE PULITO | 04/2024 IGIENE ALIMENTARE
INNOVAZIONE

Luigi Lucini, docente di Chimica agraria alla Facoltà di Scienze Agrarie, Alimentari e Ambientali dell’Università Cattolica
La nuova frontiera dell’analisi degli alimenti è rappresentata dalle tecniche omiche. Si tratta di metodi molto evoluti, che prevedono la raccolta e l’analisi statistica di un gran numero di dati nello stesso intervallo di tempo, per descrivere nel dettaglio un sistema biologico.
“Con l’espressione tecniche omiche –spiega Luigi Lucini, docente di Chimica agraria alla Facoltà di Scienze
Agrarie, Alimentari e Ambientali dell’Università Cattolica - intendiamo degli approcci analitici che vanno a caratterizzare una intera classe di molecole. Per esempio, la genomica che è la prima delle tecniche omiche ad essere adottata, caratterizza l'intero genoma, cioè tutti i geni di un organismo. Sono arrivate poi la trascrittomica, che identifica quali geni sono trascritti, la proteomica, quando questi geni sono copiati e tradotti in proteine, e la metabolomica che descrive i metaboliti, cioè i composti chimici presenti all'interno di una cellula all'interno di un tessuto e anche in un alimento”.
Questi approcci si sono resi possibili negli ultimi anni grazie all'evoluzione delle tecnologie di analisi, cioè alla disponibilità di strumenti d'analisi sempre più performanti. “Le tecniche che permettono di effettuare queste analisi - sottolinea - sono principalmente la spettrometria di massa e la risonanza magnetica nucleare. Si tratta però di strumenti però molto evoluti, rispetto a quelli classici, che permettono di individuare 20 o 30 composti chimici in una matrice. Adesso si possono misurare 7.000-10.000 composti diversi, a
seconda dipende dalla tecnica adottata, con una sola analisi”.
UN APPROCCIO NUOVO
Ma al di là delle possibilità offerte dalle innovazioni in ambito analitico, l’applicazione delle tecniche omiche in ambito alimentare prevede un cambio di mentalità. “Alla mia generazione - racconta - è stato insegnato che il metodo scientifico prevede un'ipotesi, che va verificata tramite un esperimento scientifico. Le scienze omiche sono un cambio di prospettiva: nel caso di un sistema molto complesso è molto difficile formulare un'ipotesi specifica precisa, allora il lavoro viene definito hypotesis free. Si lavora in maniera non mirata, cercando di caratterizzare completamente il sistema, che può essere appunto la cellula, l'organo, il tessuto o l'alimento, come nella mia attività”.
Una delle possibili applicazioni delle tecniche omiche in ambito alimentare è l’identificazione di frodi. “Per esempio - racconta Lucini - se dovessi usare le tecniche omiche per individuare se un olio etichettato DOP è invece proveniente da un’altra zona, dovrei analizzare diverse annate di quell’olio







OMIC TECHNIQUES: THE NEW FRONTIER IN FOOD ANALYSIS
In recent years, thanks to the availability of increasingly high-performance analysis tools, new methods of investigation have become possible, but they are still very expensive and not easy to interpret. Still, they are destined to become established in the near future
The new frontier in food analysis is omic techniques. These are highly evolved methods that involve the collection and statistical analysis of a large number of data in the same time interval to describe a biological system in detail.
"By the expression omic techniques - explains Luigi Lucini, professor of agricultural chemistry at the Faculty of Agricultural, Food and Environmental Sciences at Catholic University - we mean analytical approaches that go to
characterize an entire class of molecules. For example, genomics, which is the first of the omic techniques to be adopted, characterizes the entire genome, that is, all the genes in an organism. Then came transcriptomics, which identifies which genes are transcribed, proteomics, when these genes are copied and translated into proteins, and metabolomics, which describes metabolites, that is, the chemical compounds present within a cell within a tissue and also in a food."
These approaches have become possible in recent years due to the evolution of analysis technologies, that is, the availability of increasingly high-performance analysis tools. "The techniques that enable these analyses - he emphasizes - are mainly mass spectrometry and nuclear magnetic resonance. However, these
are highly evolved instruments, compared to the classical ones, which allow the detection of 20 or 30 chemical compounds in a matrix. Now you can measure 7,000 to 10,000 different compounds, depending on the technique used, with a single analysis."
A new approach
But beyond the possibilities offered by innovations in analytics, the application of omic techniques in food involves a change of mindset. "My generation - explains Lucini - was taught that the scientific method involves a hypothesis, which must be tested through a scientific experiment. Omic science is a change of perspective: in the case of a very complex system it is very difficult to formulate a specific precise hypothesis, then the work is called hypothesis
S•9 DIMENSIONE PULITO | 04/2024
senza cercare nulla in particolare, e trattare i risultati ottenuti con tecniche di statistica evolute per evidenziare l’impronta chimica di quell’olio, al di là della singola annata. Questa impronta chimica diventa il marcatore che identifica l’olio proveniente da quella zona. Se in un campione di olio non ritrovo questo stesso marcatore, significa che non proviene da quella zona”.
I marcatori evidenziati con l’applicazione delle tecniche omiche possono essere quindi utilizzati, come in questo caso, per definire l’origine geografica di un prodotto, oppure la sua qualità (per esempio per individuare una molecola che è sempre presente quando il caffè viene apprezzato, o una che invece è
associata al gusto rancido delle nocciole….), o ancora possono essere collegati a un effetto antiossidante degli alimenti.
“Tramite le tecniche omiche - commenta Lucini - si ottengono dataset molto molto ampi, quelli che chiamia-
mo i big data, che vanno poi interpretati per capire quali sono le differenze tra due condizioni di alta e bassa qualità, tra un prodotto originale e uno adulterato, tra uno sano e uno difettato… Gli ambiti di applicazione sono davvero ampi. Questi marcatori,

free. You work in an untargeted way, trying to completely characterize the system, which can be precisely the cell, organ, tissue or food, as in my work."
One of the possible applications of omic techniques in food is the identification of frauds.
"For example - Lucini says - if I were to use omic techniques to identify whether an oil labeled PDO is instead from another area, I would have to analyze several vintages of that oil without looking for anything in particular, and treat the results obtained with advanced statistical techniques to highlight the chemical fingerprint of that oil, beyond the single vintage. This chemical fingerprint becomes the marker that identifies the oil from that area. If I don't find this same marker in an oil sample, it means it doesn't come from that area."
The markers highlighted through the application of omics techniques can then be used, as in this case, to define the geographic origin of
a product, or its quality (for example, to identify a molecule that is always present when coffee is appreciated, or one that is instead associated with the rancid taste of hazelnuts...), or they can even be linked to an antioxidant effect of foods. "Through omic techniques - Lucini comments - we obtain very large datasets, what we call the big data, which must then be interpreted to understand what are the differences between two conditions of high and low quality, between an original product and an adulterated one, between a healthy one and a defective one... The areas of application are really wide. In fact, these markers can be used to advocate for the consumer, to think about how to design new foods that are healthier or are better liked... In short, they can be used depending on the purpose. The potential of these techniques is really high, because when you have so much information and you are able to interpret it correctly you can apply it in so many ways."
Cost, a limit to overcome
Are omic techniques therefore destined to become the reference methods for food analysis? Probably not in the immediate future, because of their cost and the complexity in interpreting the results. "The instrumentation needed to generate such a large amount of data - he points out - can cost 8-10 times more than similar instruments used for more traditional analyses. In addition, static analysis of the data collected requires high-level skills in this area. For these reasons, for now, these are new technologies, the diffusion of which is mostly limited in research, but I must say in recent years even some very structured companies, the big players in the food industry, are beginning to adopt these methods, as are the laboratories of the Agencies in charge of food control. Large companies can employ them in research and development, to develop products that can respond as much as possible to the benefits required by the market,
S•10 DIMENSIONE PULITO | 04/2024 IGIENE ALIMENTARE
INNOVAZIONE
infatti, possono essere utilizzati per difendere il consumatore, per pensare come disegnare nuovi alimenti che siano più salutari o siano più apprezzati…. Insomma si possono utilizzare in funzione dello scopo. La potenzialità di queste tecniche è veramente alta, perché quando si hanno a disposizione tantissime informazioni e si è capaci di intepretarle correttamente è possibile applicarle in tantissimi modi”.
IL COSTO, UN LIMITE
DA SUPERARE
Le tecniche omiche sono quindi destinate a diventare i metodi di riferimento per l’analisi dei prodotti alimentari?
Probabilmente non nell’immediato, a causa del loro costo e della complessità nell’interpretare i risultati.
“La strumentazione che serve per generare una tale mole di dati – precisa – può costare 8-10 volte più degli analoghi strumenti utilizzati per analisi più tradizionali. Inoltre l’analisi statica dei dati raccolti richiede delle competenze di livello elevato in questo ambito. Per questi motivi per ora si tratta di tecnologie nuove, la cui diffusione è per lo più limitata in ambito di ricerca, ma devo dire negli ultimi anni anche
alcune aziende molto strutturate, i big player dell’industria alimentare, cominciano ad adottare queste metodiche, così come i laboratori degli Enti deputati al controllo degli alimenti. Le grandi aziende possono impiegarle nella ricerca e sviluppo, per mettere a punto dei prodotti che possano rispondere il più possibile ai benefici richiesti dal mercato, ma anche per verificare le caratteristiche qualitative delle materie prime al momento del conferimento; le autorità di controllo per individuare frodi in commercio messe in atto a danno del consumatore”.
Nonostante i costi Luigi Lucini auspica una maggiore diffusione di questo approccio analitico. “La tecnologia –afferma - va a vantaggio dell'azienda che lavora bene e del consumatore.
C'è da augurarsi che i costi si abbassino e che queste tecniche diventino più accessibili e quindi siano più impiegate”.
TECNICHE OMICHE
E BIOLOGICO, UN CASO STUDIO
Le tecniche omiche sono al centro del progetto di ricerca “Omic technologies for consumer food engagement: innovazione nella tracciabilità degli
alimenti biologici e fiducia del consumatore”, realizzato da EngageMinds Hub – Consumer, Food & Health Research Center, e finanziato dall’Università Cattolica tra gli indirizzi di ricerca a interesse strategico, con la collaborazione interdisciplinare di diverse facoltà e dipartimenti dell’Ateneo. Il progetto ha l’obiettivo di indagare la percezione dei consumatori in merito all’idea dell'impiego delle tecnologie omiche a favore della tracciabilità e valutazione nutrizionale delle verdure e della frutta biologiche, richiamando l'attenzione sulle principali implicazioni in termini di salute e sostenibilità di questo tipo di innovazioni. Negli ultimi anni - come è emerso nel convegno organizzato nell’ambito del progetto di ricerca, che si è svolto all’Università Cattolica, campus di Cremona - è aumentata la richiesta da parte dei consumatori di cibi biologici. Nel mese in cui sono state effettuate le rilevazioni, il 40% degli italiani ha consumato prodotti di questo tipo almeno tre o quattro volte a settimana; i più amanti del genere sono i giovani (62%), i laureati (47%), e le persone originarie delle regioni del Sud e Isole (48%).
but also to verify the quality characteristics of raw materials at the time of delivery; the control authorities to detect fraud in commerce put in place to the detriment of the consumer." Despite the costs, Luigi Lucini advocates more widespread use of this analytical approach. "The technology - he says - benefits the company that works well and the consumer. There is hope that costs will come down and that these techniques will become more accessible and thus be more widely used."
Omics and biological techniques, a case study
Omic techniques are at the center of the research project "Omic technologies for consumer food engagement: innovation in organic food traceability and consumer trust," carried out by EngageMinds Hub - Consumer, Food & Health Research Center, and funded by the Catholic University among the research direc-
tions of strategic interest, with the interdisciplinary collaboration of several faculties and departments of the University.
The project aims to investigate consumer perceptions of the idea of using omics technologies for traceability and nutritional assessment of organic vegetables and fruits, drawing attention to the main health and sustainability implications of this type of innovation.
In recent years-as revealed at the conference organized as part of the research project, which took place at the Catholic University, Cremona campus-has been increasing consumer demand for organic food. In the month in which the surveys were carried out, 40 percent of Italians consumed such products at least three or four times a week; the most fond of the genre are young people (62 percent), college graduates (47 percent), and people from southern regions and islands (48 percent).
In particular, the organic foods most con-
sumed by Italians are fresh eggs (69 percent), vegetables (66 percent) and fruits (62 percent), chosen because they are considered healthy, natural and environmentally friendly. Indeed, it is widely believed that organic foods contain fewer pesticides and are produced by processes that pay special attention to safety. However, consumers are not that knowledgeable about organic certifications and for this reason may be misled in their purchases.
It is at this point that omic technologies come into play, which make it possible to assess whether a food product is truly organic by going to consider certain parameters that "traditional" certifications do not evaluate, for example, how the food is stored and transported. Food traceability, in this context, is considered an important tool for ensuring food quality and safety, characteristics that can influence consumer purchases.
"From the study - explains Greta Castellini,
S•11 DIMENSIONE PULITO | 04/2024
In particolare, gli alimenti biologici più consumati dagli italiani sono le uova fresche (69%), gli ortaggi (66%) e la frutta (62%), scelti poiché considerati salubri, naturali e rispettosi dell’ambiente. È infatti opinione diffusa che i cibi biologici contengano meno pesticidi e siano prodotti con processi che prestano una particolare attenzione alla sicurezza. Tuttavia, il consumatore non è poi così preparato rispetto alle certificazioni biologiche e per questo motivo può essere indotto in errore negli acquisti.
È a questo punto che entrano in gioco le tecnologie omiche, che permettono di valutare se un prodotto alimentare è davvero biologico, andando a considerare alcuni parametri che le certificazioni “tradizionali” non valutano, per esempio come l’alimento viene conservato e trasportato. La tracciabilità degli alimenti, in questo contesto, è considerata uno strumento importante per garantire la qualità e la sicurezza alimentare, caratteristiche che possono influenzare l’acquisto da parte dei consumatori.
“Dallo studio - spiega Greta Castellini, ricercatrice di Psicologia dei Consumi presso la Facoltà di Scienze Agrarie, Alimentari e Ambientali dell’Università Cattolica - emerge che la maggior parte degli italiani (79%) non ha mai sentito parlare delle tecnologie omiche applicate al cibo. Dopo aver presentato e spiegato det-
tagliatamente tali tecnologie e il loro potenziale ai partecipanti dello studio, questi ultimi le hanno considerate interessanti (54%), positive (58%) e non pericolose (55%). Tuttavia, sembrano emergere delle incertezze riguardo alla necessità di introdurre queste nuove tecnologie alimentari”.
Infatti, il 43% ritiene che l’utilizzo delle tecnologie omiche possa essere evitato in quanto non necessario ai fini della certificazione biologica di un alimento. In media, il campione dell’indagine ha affermato di essere disposto a pagare circa il 9% in più per gli ortaggi certificati con tecnologie omiche rispetto a quelli non certificati con tali tecnologie.
“A oggi le certificazioni a supporto sono principalmente cartacee - sostiene Luigi Lucini - e quindi più facilmente soggette a frodi, si auspica quindi il ricorso nei prossimi anni a queste nuove tecnologie omiche, quantomeno in un’ottica di verifiche a campione”.
“Tecnologico e biologico è un binomio che può suonare stridente per il consumatore - dichiara Guendalina Graffigna, direttrice di EngageMinds Hub – Consumer, Food & Health Research Center, Centro di ricerca in psicologia dei consumi e della salute dell’Università Cattolica , campus di Cremona e coordinatrice del progetto - in generale più incline ad assimilare le tecnologie alimentari ad un concet-
to di artefazione invece che percepirle come alleate per migliorare la sicurezza di un alimento. Dallo studio che abbiamo condotto, le evidenze raccolte indicano che è fondamentale implementare programmi di educazione e sensibilizzazione rivolti ai consumatori al fine di alfabetizzare sui processi di certificazione del biologico e accrescere la fiducia verso l'adozione di avanzate tecniche di analisi, quali quelle omiche, a favore della tutela dei consumatori.”
“I risultati della ricerca - aggiunge Giulia Sesini, dottoranda presso la Facoltà di Psicologia dell’Università Cattolica - evidenziano il ruolo centrale della fiducia negli enti certificatori per stimolare l’adozione delle nuove tecnologie alimentari, senza dimenticare l’importanza ricoperta dagli atteggiamenti verso il cibo più in generale”. I consumatori attribuiscono difatti una crescente rilevanza alla componente etica dei prodotti, fattore determinante nella scelta di cibi certificati tramite nuove tecnologie. “Da un punto di vista psicologico – sottolinea - è inoltre fondamentale differenziare i consumatori in base alle proprie abitudini di consumo per dare forma a una comunicazione mirata e personalizzata che vada a rassicurare in particolar modo i consumatori di cibi biologici sull’integrità del prodotto”.
“Anche i dati raccolti attraverso uno
researcher of Consumer Psychology at the Faculty of Agricultural, Food and Environmental Sciences at the Catholic University - it emerges that most Italians (79 percent) have never heard of omics technologies applied to food. After presenting and explaining these technologies and their potential in detail to the study participants, the latter considered them interesting (54%), positive (58%) and not dangerous (55%). However, uncertainties seem to be emerging regarding the need to introduce these new food technologies."
In fact, 43 percent believed that the use of omics technologies could be avoided as unneces-
sary for the purpose of organic certification of a food. On average, the survey sample said they were willing to pay about 9 percent more for vegetables certified with omics technologies than those not certified with such technologies.
"To date, the supporting certifications are mainly paper-based - says Luigi Lucini - and therefore more easily susceptible to fraud, so it is hoped that these new omics technologies will be used in the coming years, at least from the perspective of spot checks”.
“Technological and organic is a binomial that can sound jarring to the consumer - says Guendalina Graffigna, director of EngageMinds Hub
- Consumer, Food & Health Research Center, Research Center in Psychology of Consumption and Health at the Catholic University, Cremona campus, and coordinator of the project - in general more inclined to assimilate food technologies to a concept of artifact instead of perceiving them as allies to improve the safety of a food. From the study we conducted, the evidence gathered indicates that it is essential to implement education and awareness programs aimed at consumers in order to become literate about organic certification processes and increase confidence in the adoption of advanced analytical techniques, such as omics, in favor of
S•12 DIMENSIONE PULITO | 04/2024 IGIENE ALIMENTARE
INNOVAZIONE
studio sperimentale - afferma Paola Iannello, docente della Facoltà di Psicologia dell’Università Cattolica - confermano una certa apertura tra i consumatori nei confronti dell’introduzione delle tecnologie omiche. I risultati, infatti, mettono in evidenza che i prodotti etichettati come omici vengono mediamente valutati, sia dal punto di vista estetico che del gusto, in maniera del tutto simile ai prodotti eti-
chettati come biologici. Anche l’intenzione di acquisto espressa dai consumatori nei confronti dei prodotti omici e biologici è pressocché la medesima, ed è decisamente più elevata rispetto all’intenzione di acquisto espressa nei confronti dei prodotti ‘convenzionali’. Favorire nella percezione del consumatore questa ‘vicinanza’ potrebbe rivelarsi una modalità funzionale ed efficace per introdurre sul mercato pro-
dotti alimentari certificati attraverso le tecnologie omiche”.
CONCLUSIONI
Insomma, i presupposti a un maggiore impiego delle tecniche omiche ci sarebbero, anche se oltre a superare le barriere di costo, sarà necessario comunicare correttamente come e perché si utilizzano, per vincere le resistenze del consumatore.

consumer protection."
"The results of the research - adds Giulia Sesini, a doctoral student in the Faculty of Psychology at Catholic University - highlight the central role of trust in certifying bodies in stimulating the adoption of new food technologies, without forgetting the importance held by attitudes toward food more generally. In fact, consumers attach increasing importance to the ethical component of products, a determining factor in choosing foods certified through new technologies. From a psychological point of view - she stresses - it is also essential to differentiate consumers according to their consumption
habits in order to shape targeted and personalized communication that goes to reassure organic food consumers in particular about the integrity of the product”.
"The data collected through an experimental study - says Paola Iannello, professor of the Faculty of Psychology at Catholic University - also confirm a certain openness among consumers toward the introduction of omic technologies. The results, in fact, highlight that products labeled as omic are, on average, evaluated, both from the point of view of aesthetics and taste, quite similarly to products labeled as organic. The purchase intention expressed by consumers toward omic
and organic products is also about the same, and is significantly higher than the purchase intention expressed toward 'conventional' products. Fostering this 'closeness' in consumer perception could prove to be a functional and effective way to introduce certified food products through omic technologies to the market."
Conclusions
In short, the prerequisites to increased use of omics techniques would be there, although in addition to overcoming cost barriers, it will be necessary to properly communicate how and why they are used, to overcome consumer resistance.
S•13 DIMENSIONE PULITO | 04/2024

Come garantire la salubrità di un alimento?

L’igiene e la sicurezza alimentare sono di fondamentale importanza nell’industria alimentare.
Un alimento non sicuro, può compromettere la salute del consumatore, e può anche danneggiare l’azienda produttrice sia dal punto di vista economico che di immagine. Come possiamo garantire la qualità e la sicurezza di un alimento?
Per prevenire i problemi igienici e garantire la qualità e la sicurezza dei prodotti alimentari, è essenziale controllare tutti le fasi della preparazione a partire dall’acquisto delle materie prime, al confezionamento del prodotto finito e alla successiva distribuzione sulle nostre tavole.
È importante sottolineare che la normativa italiana in materia di sicurezza alimentare è molto rigorosa e prevede controlli frequenti da
parte delle autorità competenti, ma è l’azienda stessa il punto cruciale dell’operazione. È dovere e responsabilità dell’azienda seguire rigorose norme igieniche ed effettuare regolari controlli di igiene. Questi controlli devono essere condotti da personale qualificato e competente, in grado di individuare e risolvere tempestivamente eventuali problemi. Inoltre, è importante adottare misure preventive come la formazione del personale, la pulizia e la disinfezione costante degli ambienti di lavoro con l’utilizzo di detergenti e disinfettanti specifici meglio se certificati. Solo attraverso un impegno costante e un controllo attento è possibile garantire la sicurezza alimentare e la fiducia dei consumatori.
Applicando tutte le procedure in conformità alle norme igieniche, si ha la sicurezza di produrre un alimento di qualità, ma come garantirlo? E se fosse sfuggito qualcosa?
In un’azienda alimentare è necessario che si applichino anche dei sistemi di controllo oggettivi, rigorosi e costanti nel tempo.
Per effettuare dei test di verifica oggettivi ci si è sempre affidati all’esecuzione di tamponi microbiologici sulle superfici da controllare, per poi inviare i tamponi stessi al laboratorio per la successiva analisi. Que sti test fornisco risultati sicura mente precisi e oggettivi ma purtroppo tardivi.
La relativa facilità con cui un alimento si può con taminare e la sempre più capillare catena di distribu
zione, necessita di una risposta estremamente rapida sul livello igienico degli ambienti in cui gli alimenti vengono prodotti.

informazione pubblicitaria
È indispensabile che non si continui ad usufruire di un ambiente o di una superficie non correttamente sanificata, per non aumentare il rischio biologico durante la produzione.
Per ottenere un’informazione rapida e precisa sulle condizioni igieniche di una superficie, molte aziende alimentari hanno adottato una procedura semplice da svolgere ma estremamente veloce nel fornire il risultato (circa 10 sec.). Gli addetti alla produzione effettuano il Test dell’ATP utilizzando il Bioluminometro e i relativi tamponi monouso.
Il test di basa sulla ricerca di ATP (Adenosin Trifosfato), una molecola che si trova in tutte le cellule viventi e quindi è un indicatore di sporco organico. I residui organici,
infatti, sono il terreno ideale per la proliferazione batterica e quindi questo test fornisce indicazioni oggettive sul rispetto degli standard di pulizia.
Tra gli strumenti presenti sul mercato, il Bioluminometro EnSure Touch di Hygiena LTD è indubbiamente il più facile da utilizzare. La sua struttura simile a un normale smartphone con il menù ad icone e il display touch screen lo rende intuitivo e adatto a tutti gli operatori.
Tra i punti di forza dell’utilizzo del sistema Bioluminometro – tamponi per la verifica dell’igiene di una superficie, non c’è solo la velocità con cui si ottiene la risposta, ma anche la capacità di registrare e analizzare i dati ottenuti. Il nuovo Bioluminometro EnSure TOUCH è dotato di un
sistema di raccolta e analisi dati basata sulla connettività WiFi, che permette la registrazione e il salvataggio dei dati in tempo reale. Nel momento in cui l’operatore effettua il tampone, il responsabile può collegarsi al cloud e visualizzare il risultato ottenuto da qualsiasi postazione di lavoro. In questo modo i rischi di contaminazione vengono visualizzati e riconosciuti in tempo reale e si possono così applicare immediatamente le necessarie azioni correttive. La raccolta sistematica dei dati di monitoraggio offre la possibilità di tracciare e definire l’andamento dei risultati dei test su più posizioni/aree di applicazione per pianificare eventuali azioni a lungo termine e semplificando la gestione generale del rischio
biologico.
L’analisi dei dati raccolti può essere utile anche per la verifica dell’efficacia delle metodiche di pulizia applicate, così coinvolgendo anche gli addetti, si può redigere un programma di miglioramento continuo del livello igienico della produzione per garantire un ambiente sempre più pulito e sicuro per tutti coloro che lo frequentano. In conclusione, i problemi igienici nell’industria alimentare possono avere gravi conseguenze sulla salute dei consumatori e sull’azienda stessa. Fortunatamente il progresso tecnologico ci può fornire gli strumenti adatti per garantire la qualità e la sicurezza dei prodotti alimentari e scongiurare qualsiasi pericolo per il consumatore.

rgstrumenti.it
Centro Carni Company: un esempio di best practices
Dalle mezzene alle nuove battute al coltello, percorriamo il ciclo di lavorazione della carne bovina in una storica azienda veneta
Elena Consonni giornalista ed esperta in tecnologie alimentari
Culture, care, control: sono le tre parole che racchiudono la filosofia di Centro Carni Company, azienda di Tombolo (PD) che opera da oltre 40 anni nella lavorazione della carne bovina. I termini usati per descrivere i valori aziendali esprimono il costante impegno nei confronti del cliente - consumatore finale e operatore del settore - nell’offrire qualità, sostenibilità e innovazione costante in ogni gamma di prodotto. Il core business dell’azienda è il disosso, seguito dalle successive lavorazioni della carne, per una potenzialità giornaliera di 80 tonnellate. Oggi l’azienda, che conta 200 dipendenti, si sviluppa su una superficie di 14.000 mq coperti. Esporta in 21 Paesi e nel 2023 ha registrato un fatturato di 153 milioni di euro.
Per capire come si esprime concretamente la forte enfasi prestata agli

aspetti igienico-sanitari, ripercorriamo il ciclo di lavorazione della carne insieme a Nicole Fantinato, responsabile assicurazione qualità di Centro Carni Company, a partire dal ricevimento delle materie prime: le mezzene, gli anteriori e i posteriori.
“La sezione di ricevimento della merce in entrata - spiega Fantinato - è dotata di una stazione di sanificazione perché ogni operatore che entra deve avere mani e scarpe igienizzate. Quando arrivano i camion, i nostri operatori salgono nelle pedane e iniziano a sca-
S•16 DIMENSIONE PULITO | 04/2024 IGIENE ALIMENTARE
CASE HISTORY

Nicole Fantinato responsabile assicurazione qualità di Centro Carni Company
ricare la merce, controllando che i documenti corrispondano a quello che è effettivamente arrivato. Verificano poi il mezzo, sia la temperatura, sia lo stato di pulizia ed effettuano un primo controllo visivo del capo.”
Le mezzene passano poi alla zona di pesatura dove ogni capo viene pesato ed etichettato per creare il lotto di produzione che seguirà tutto il flusso
produttivo. Viene poi effettuato un secondo controllo, sulla base della classificazione SEUROP, uno strumento imposto dalla normativa comunitaria per assicurare una migliore trasparenza del mercato e garantire la corretta applicazione dei prezzi, che consente di valutare la conformazione della mezzena e lo stato di ingrasso.
“Tutti i dati raccolti in accettazionespiega - vengono monitorati, per permettere una corretta valutazione della merce fornita.”
SALA DISOSSO:
IL CUORE DELL’AZIENDA
Superata la fase di accettazione, le mezzene passano alla sezione disosso, uno snodo centrale in cui gli addetti, ai tavoli di lavorazione, separano manualmente i diversi tagli anatomici. Le lavorazioni sono effettuate in funzione dei prodotti che si desiderano ottenere e messi sottovuoto. In alcuni casi il taglio è già pronto per essere immesso sul mercato, in altri è destinato a ulteriori lavorazioni. Tutti i trasporti avvengono su nastro e prima di lasciare la sala il prodotto viene esaminato da un metal detector, per verificare l’assenza di residui metallici.
“Abbiamo messo a punto, inoltre, dei sistemi che ci permettono di valutare la resa lavorazione della carne, valutando quindi gli standard di quanto effettuato sulla materia prima lavorata, il tutto per migliorare l’operato quotidiano e i prodotti destinati ai diversi utilizzi: dal sottovuoto ai prodotti porzionati dai burger alla new entry: la battuta al coltello”.
PARTICOLARI ACCORTEZZE PER LA BATTUTA
La battuta al coltello è l’ultimo nato tra i prodotti della gamma Centro Carni Company, che ha deciso di inserirsi in un segmento di grande valore nell’ambito del mercato della carne. In Italia nel 2023 sono stati venduti 1.712.887 kg, confermando un trend crescente. Le vendite di tartare hanno registrato un aumento del +2,9% nel 2022 rispetto all'anno precedente e dello +0,46% nel 2023 rispetto al 2022. Trattandosi di un prodotto destinato al consumo crudo, la realizzazione di questa linea ha richiesto particolari accortezze, che hanno portato l’azienda veneta a un’ulteriore innalzamento dell’asticella della qualità. Infatti per la sua produzione è stata







CENTRO CARNI COMPANY: AN EXAMPLE OF BEST PRACTICES
Culture, care, control: these are the three words that encapsulate the philosophy of Centro Carni Company, a company from Tombolo (PD) that has been operating in the processing of beef for over 40 years. The terms used to describe the company values express the constant commitment towards the customer - final consumer and operator in the sector - in offering quality, sustainability and constant innovation in every product range.
The company's core business is deboning, followed by subsequent meat processing, for a daily potential of 80 tons. Today the company, which has 200 employees, spreads over a covered area of 14,000 m2. It exports to 21 countries and recorded a turnover of 153 million euros in 2023.
To understand how the strong emphasis placed
on hygienic-sanitary aspects is concretely expressed, let's retrace the meat processing cycle together with Nicole Fantinato, quality assurance manager of Centro Carni Company, starting from the receipt of the raw materials: the half-carcasses, the front ones and the rear.
“The section for receiving incoming goods - explains Fantinato - is equipped with a sanitization station because every operator who enters must have sanitized hands and shoes. When the trucks arrive, our operators climb onto the platforms and begin to unload the goods, checking that the documents correspond to what actually arrived. They then check the vehicle, both the temperature and the state of cleanliness and carry out an initial visual inspection of the garment."
The half-carcasses then move to the weighing
area where each item is weighed and labeled to create the production batch that will follow the entire production flow. A second check is then carried out, based on the SEUROP classification, a tool imposed by community legislation to ensure better market transparency and guarantee the correct application of prices, which allows the conformation of the half-carcass and the state of fattening to be assessed.
“All the data collected during acceptance - he explains - are monitored, to allow a correct evaluation of the goods supplied.”
Deboning room: the heart of the company
Once the acceptance phase has been completed, the half-carcasses move on to the deboning section, a central hub where the workers at the
S•17 DIMENSIONE PULITO | 04/2024

realizzata un’apposita sala all’interno degli stabilimenti dell’azienda, dove vengono portati al maggior livello di sicurezza possibile gli standard igienici già presenti in tutto lo stabilimento.
“In questa sezione – afferma Fantinato – sono autorizzate a entrare solo le persone che si occupano di questo
processo. Il processo - precisa - è organizzato in modo che gli operatori manipolino il meno possibile la carne. Un punto chiave nel mantenimento di elevati livelli di sicurezza è l’adeguata sanificazione. Questo non si discosta da quello che facciamo in tutto lo stabilimento. La ricerca e sviluppo
di questa gamma - sottolinea inoltre Fantinato - ha richiesto diverso tempo, per la messa a punto della sala. Prima di andare in produzione abbiamo fatto diverse prove”.
La Battuta al Coltello You&Meat è disponibile in due varianti di gusto che prevedono l’impiego di carne Aber-
processing tables manually separate the different anatomical cuts. The processes are carried out according to the products you wish to obtain and placed under vacuum. In some cases the cut is already ready to be placed on the market, in others it is destined for further processing. All transport takes place on belts and before leaving the room the product is examined by a metal detector to verify the absence of metal residues.
“We have also developed systems that allow us to evaluate the meat processing yield, thus evaluating the standards of what has been carried out on the processed raw material, all to improve the daily work and the products intended for different uses: from vacuum to portioned products from burgers to the new entry”.
Special precautions for the knife-cut
Knife meat is the latest addition to the Centro Carni Company range of products, which has decided to enter a high-value segment of the meat market. In Italy in 2023, 1,712,887 kg were sold, confirming a growing trend. Tartare sales recorded an increase of +2.9% in 2022 compared to the previous year and of +0.46% in 2023 compared to 2022.
Since this is a product intended for raw consumption, the creation of this line required particular attention, which led the Venetian company to further raise the quality bar. In fact, for its production, a special room has been created within the company's factories, where the hygiene standards already present throughout the factory are brought to the
highest level of safety possible.
“Only people who deal with this process are authorized to enter this section” – states Fantinato.
The process - he specifies - is organized so that the operators manipulate the meat as little as possible. A key point in maintaining high levels of safety is adequate sanitization. This is no different from what we do throughout the plant.”
The research and development of this range - Fantinato also underlines - required some time to fine-tune the room. Before going into production we did several tests."
You&Meat Knife-cut is available in two flavor variants which involve the use of sired Aberdeen Angus meat from the Centro Carni
S•18 DIMENSIONE PULITO | 04/2024 IGIENE ALIMENTARE CASE HISTORY

deen Angus sired proveniente dagli allevamenti della filiera di Centro Carni Company e di scottona. L’azienda sta già lavorando per proporre al consumatore nuove referenze.
LA QUALITÀ INIZIA IN ALLEVAMENTO
Sì perché se la battuta è il fiore all’occhiello dell’azienda, la qualità del
prodotto parte dalla selezione delle materie prime, che avviene in gran parte attraverso una filiera controllata dall’azienda, costituita da 17 tra allevamenti e macelli, in prevalenza veneti, per oltre 40 mila capi allevati ogni anno. Le attività che aderiscono al progetto di filiera si impegnano al rispetto di un protocollo condiviso con Centro Carni Company, che prevede l’applicazione delle tecniche e delle procedure derivanti dalla grande tradizione dell’allevamento italiano, nel totale rispetto degli standard legati al benessere animale.
Dalle aziende coinvolte passano oltre 700 capi al mese, ed è previsto un ulteriore aumento dei bovini allevati in Italia per conto di Centro Carni Company. Il progetto vuole garantire la massima qualità al consumatore finale, impegnandosi al continuo monitoraggio dell’animale. Ogni punto della filiera è fondamentale: dall'igiene degli ambienti al monitoraggio dello stato di salute del capo, fino all’alimentazione. Di conseguenza, tutti gli operatori che aderiscono al progetto vengono qualificati nel completo rispetto del Disciplinare.
LABORATORIO, PICCOLO MA EFFICIENTE
A verificare la sicurezza del prodotto c’è il laboratorio interno. “È un laboratorio microbiologico piccolo ma funzionale per le necessità del nostro autocontrollo - spiega Nicole Fantinato, responsabile della qualità di Centro Carni Company. Qui effettuiamo le analisi sul prodotto in ingresso, che servono anche per la valutazione dei fornitori e
i controlli a campione nelle varie fasi della lavorazione e lungo tutta la shelf life. Ovviamente non mancano le analisi sulle superfici a contatto, che devono essere pulite e sanificate.”
Ogni anno effettuiamo circa 3000 analisi microbiologiche, eseguite sia dal nostro laboratorio interno che affidate ad un laboratorio esterno.”
Company and Scottona supply chain farms. The company is already working to offer new products to consumers.
Quality begins on the farm
Yes, because if the knife-cut is the flagship of the company, the quality of the product starts from the selection of raw materials, which occurs largely through a supply chain controlled by the company, made up of 17 farms and slaughterhouses, mainly from Veneto , for over 40 thousand animals raised every year.
The activities that join the supply chain project are committed to respecting a protocol shared with Centro Carni Company, which involves the application of techniques and
procedures deriving from the great tradition of Italian breeding, in total compliance with the standards linked to animal welfare.
Over 700 animals per month pass through the companies involved, and a further increase in the number of cattle raised in Italy on behalf of Centro Carni Company is expected. The project aims to guarantee the highest quality to the final consumer, committing itself to continuous monitoring of the animal.
Every point in the supply chain is fundamental: from the hygiene of the environment to the monitoring of the health of the garment, up to nutrition. Consequently, all operators who join the project are qualified in full compliance with the Regulations.
Laboratory, small but efficient
The internal laboratory verifies the safety of the product. “It is a small but functional microbiological laboratory for our self-control needs - explains Nicole Fantinato, quality manager of Centro Carni Company. Here we carry out analyzes on the incoming product, which also serve to evaluate suppliers and carry out random checks at the various stages of processing and throughout the shelf life. Obviously there is no shortage of analyzes on contact surfaces, which must be cleaned and sanitized."
Every year we carry out approximately 3000 microbiological analyses, performed both by our internal laboratory and entrusted to an external laboratory."
S•19 DIMENSIONE PULITO | 04/2024
L’acqua nell’industria alimentare
La qualità dell’acqua impiegata nei processi produttivi influenza la qualità organolettica dell’alimento finito e la sua sicurezza, la durata e l’efficienza di impianti e attrezzature, i costi di manutenzione
Stefania Milanello esperta in tecnologie alimentari

S•20 DIMENSIONE PULITO | 04/2024 IGIENE ALIMENTARE
IMPIANTI
L’acqua è utilizzata nella produzione primaria, l’agricoltura e la zootecnia, per l’irrigazione e per l’abbeveraggio degli animali, nei processi produttivi dell’industria alimentare. Viene utilizzata come ingrediente, come acqua di processo per la detergenza e sanificazione, per il controllo delle temperature di processo e per il condizionamento degli ambienti. L’acqua utilizzata nell’industria alimentare deve essere sicura e per questo subisce trattamenti per eliminare patogeni e impurità. La qualità dell’acqua impiegata in un processo produttivo influenza la qualità organolettica dell’alimento finito e la sua sicurezza, l’efficienza del processo produttivo, la durata degli impianti e delle attrezzature, i costi di manutenzione.
LA RETE DI DISTRIBUZIONE
La rete che distribuisce acqua potabile può essere sottoposta a fenomeni di corrosione e incrostazione correlati all’acqua stessa. Per questo, occorre prevedere il comportamento dell’acqua nella rete di distribuzione, conoscendo alcuni parametri, usati per definire un indice numerico di stabilità
(Langelier o Ryznar) grazie al quale si comprende se l’acqua tenderà a formare depositi di calcio carbonato o sarà aggressiva per i metalli. La prevenzione e il controllo dei fenomeni corrosivi, attraverso trattamenti con inibitori di corrosione, diminuisce i livelli di contaminazione batterica. Per garantire un’elevata qualità dell’acqua impiegata nell’industria alimentare è quindi necessario garantire l’assenza di incrostazioni e biofilm delle reti di distribuzione.
QUALITÀ DELL’ACQUA
La direttiva 98/83/CE, recepita in Italia con il D.Lgs. n. 31/2001 circa la qualità delle “acque destinate al consumo umano”, stabilisce le norme di qualità che devono soddisfare tutte le acque, trattate o non trattate, destinate a uso potabile, culinario o per la preparazione di cibi in ambito domestico, e tutte le acque utilizzate in un’impresa alimentare per la fabbricazione, il trattamento, la conservazione o l’immissione sul mercato di prodotti o sostanze destinate al consumo umano, escluse quelle la cui qualità non può avere conseguenze sulla salubrità del prodotto alimentare finale. La stessa
direttiva, all’articolo 6, precisa che i parametri di qualità prestabiliti per le acque impiegate nelle imprese alimentari devono essere garantiti fino al punto di utilizzo. Il D.Lgs. 31/2001 stabilisce che il titolare dell’impresa alimentare è responsabile della qualità dell’acqua impiegata nel ciclo di produzione nel punto in cui l’acqua è utilizzata nell’impresa. Per acqua impiegata nel ciclo di produzione si intende sia quella usata come materia prima, sia quella per il processo, il lavaggio dei prodotti o dei macchinari. Ciò non significa che l’acqua deve essere “potabile” per tutti gli impieghi aziendali, ma solo per quelle fasi del ciclo produttivo nelle quali la sua qualità può avere conseguenze sulla salubrità del prodotto alimentare finito (le acque tecnologiche non devono essere “potabili”). Il D.Lgs. 31/2001, nell’allegato 1 parte A, indica i parametri microbiologici. Le industrie che impiegano l’acqua come alimento spesso adottano come criteri di qualità quelli dell’acqua destinata all’imbottigliamento. L’allegato 1 parte B indica, invece, i parametri chimici. L’allegato 1 parte C prende in considerazione i parametri indicatori. Inoltre,







WATER IN THE FOOD INDUSTRY
Water is used in primary production, agriculture and animal husbandry, for irrigation and for watering animals, in the production processes of the food industry. It is used as an ingredient, as process water for cleaning and sanitization, for controlling process temperatures and for air conditioning. The water used in the food industry must be safe and for this reason it undergoes treatments to eliminate pathogens and impurities. The quality of the water used in a production process influences the organoleptic quality of the finished food and its safety, the efficiency of the production process, the life of the systems and equipment, and maintenance costs.
The distribution network
The network that distributes drinking water can be subjected to corrosion and encrustation
phenomena related to the water itself. For this, it is necessary to predict the behavior of the water in the distribution network, knowing some parameters, used to define a numerical stability index (Langelier or Ryznar) thanks to which it is understood whether the water will tend to form calcium carbonate deposits or will be aggressive for metals. The prevention and control of corrosive phenomena, through treatments with corrosion inhibitors, decreases the levels of bacterial contamination. To guarantee high quality of the water used in the food industry it is therefore necessary to guarantee the absence of encrustations and biofilms in the distribution networks.
Water
quality
Directive 98/83/EC, implemented in Italy with
Legislative Decree no. 31/2001 regarding the quality of "water intended for human consumption", establishes the quality standards that must satisfy all water, treated or untreated, intended for drinking, culinary use or for the preparation of food in the home, and all water used in a food business for the manufacture, treatment, conservation or placing on the market of products or substances intended for human consumption, excluding those whose quality cannot have consequences on the healthiness of the final food product. The same directive, in Article 6, specifies that the pre-established quality parameters for water used in food businesses must be guaranteed up to the point of use. Legislative Decree 31/2001 establishes that the owner of the food business is responsible for the quality of the water used
S•21 DIMENSIONE PULITO | 04/2024

in the production cycle at the point where the water is used in the business. By water used in the production cycle we mean both that used as raw material and that for the process, washing of products or machinery. This does not mean that the water must be "drinkable" for all company uses, but only for those phases of the production cycle in which its quality can have consequences on the healthiness of the finished food product (technological waters must not be "drinkable").
Legislative Decree 31/2001, in Annex 1 part A, indicates the microbiological parameters. Industries that use water as food often adopt those of water intended for bottling as quality criteria. Annex 1 part B indicates the chemical parameters. Annex 1 part C takes the indicator parameters into consideration. Furthermore, in relation
to the parameters of pH, conductivity, sulphates and chlorides, regardless of their limits, the water must not be aggressive. Iron has a maximum limit of 200 µg/L set to guarantee the organoleptic characteristics of the water, reduce the risk of deposit formation and facilitate the microbiological control of the distributed water. Manganese (maximum limit 50 µg/L) gives water an unpleasant taste, can give rise to the formation of dark deposits in pipes and can alter the color of the water. Chlorine coverage is always recommended, so much so that a minimum disinfectant residue of 0.2 mg/L is required by the legislative decree in question.
Treatments
Water treatments for the food industry, such as
in relazione ai parametri di pH, conducibilità, solfati e cloruri, indipendentemente dai loro limiti, l’acqua non dovrà essere aggressiva. Il ferro ha un limite massimo di 200 µ g/L fissato per garantire le caratteristiche organolettiche dell’acqua, ridurre il rischio di formazione di depositi, facilitare il controllo microbiologico dell’acqua distribuita. Il manganese (limite massimo 50 µ g/L) conferisce all’acqua un sapore sgradevole, può dar luogo alla formazione di depositi scuri nelle condutture e può alterare la colorazione dell’acqua. La cloro copertura è sempre consigliata, tanto che un residuo di disinfettante minimo di 0,2 mg/L è previsto dal decreto legislativo in questione.
I TRATTAMENTI
I trattamenti delle acque per l’industria alimentare, quali addolcimento, scambio ionico, osmosi inversa, filtrazione, sono fondamentali e riguardano sia le acque primarie sia quelle di scarico, al fine di renderle idonee al contatto con gli alimenti e per i diversi processi tecnologici. Per questo devono essere rimossi microrganismi, inquinanti organici e inorganici, metalli, sali o gas in eccesso ecc. L’acqua viene utilizzata per le operazioni di lavaggio e sanificazione degli ambienti
softening, ion exchange, reverse osmosis, filtration, are fundamental and concern both primary and waste water, in order to make them suitable for contact with food and for the various technological processes . For this reason, microorganisms, organic and inorganic pollutants, metals, excess salts or gases, etc. must be removed. Water is used for washing and sanitizing operations of environments and equipment or in different phases of the production cycle, for example in exchangers, in refrigeration, but also as an ingredient.
The technologies and treatments available to make water suitable for the company are different, including: membrane and UV filtration systems, ion exchangers, reagent dispensers, anti-corrosion treatments. Membrane filtration is
S•22 DIMENSIONE PULITO | 04/2024 IGIENE ALIMENTARE
IMPIANTI
e delle attrezzature o in diverse fasi del ciclo produttivo, ad esempio negli scambiatori, nella refrigerazione, ma anche come ingrediente. Le tecnologie e i trattamenti a disposizione per rendere l’acqua idonea in azienda sono diversi, tra cui: sistemi di filtrazione con membrana, a UV, scambiatori di ioni, dosatori di reagenti, trattamenti anticorrosione. La filtrazione con membrana si basa sull’utilizzo di membrane semipermeabili in grado di trattenere i solidi in sospensione e altre sostanze, separandole dall’acqua, senza ricorrere a prodotti chimici. Si tratta inoltre di un processo che avviene a basse temperature. La filtrazione con membrana può essere micro, ultra e nanofiltrazione e osmosi inversa. Il diametro dei pori delle membrane di microfiltrazione varia da 0,1 a 10 µ m. Con l’ultrafiltrazione si utilizzano membrane con pori di circa 0,002-0,1 µ m in grado di rimuovere i microrganismi, compresi alcuni virus. Per la rimozione di sali dall’acqua si utilizzano la nanofiltrazione e l’osmosi inversa. Quest’ultima in particolare rimuove oltre il 99% del contenuto salino. Si tratta di una tecnica costosa. Le membrane vanno pulite periodicamente con lavaggi in corrente o in controcorrente, ad aria, con l’utilizzo di prodotti chimici e, nel
caso, sostituite.
Per abbattere la carica microbica delle acque vengono utilizzati anche i raggi UVC, senza alterarne le caratteristiche chimiche e organolettiche. La luce UV-C (2537 Å) altera il DNA dei microrganismi, impedendone la replicazione.
Grazie agli scambiatori di ioni si possono rimuovere sali dall’acqua, rendendola più dolce e/o deionizzata. Vengono rimossi in particolare gli ioni di calcio, magnesio e bicarbonato, responsabili della formazione di incrostazioni negli impianti. Le resine per lo scambio ionico non sono in grado di asportare prodotti organici, virus o batteri.
L’industria degli alimenti e delle bevande utilizza molta acqua, sia come ingrediente sia per il lavaggio, il trasporto, il riscaldamento o il raffreddamento di ingredienti e prodotti. Si parla sempre di più di utilizzo sostenibile delle risorse idriche. In questo senso, le aziende alimentari adottano sistemi per riutilizzare le acque di processo. La produzione agricola utilizza l’acqua degli scarichi per l’irrigazione o per l’acquacoltura, l’acqua di raffreddamento può essere riutilizzata per operazioni di lavaggio, così come quella di trasporto per la produzione di ghiaccio, acqua calda o vapore,
sempre nel rispetto degli standard qualitativi al fine di garantire la potabilità dell’acqua, anche a scopi di pulizia.
L’UTILIZZO DI VAPORE
L’acqua nell’industria alimentare viene utilizzata anche sotto forma di vapore direttamente o indirettamente a contatto con l’alimento. Il calore del vapore aiuta a eliminare potenziali contaminanti microbici, ma non possibili inquinamenti, derivanti dalla caldaia, dall’eccessiva presenza di sali nell’acqua, da fenomeni corrosivi sull’impianto, da eventuale microflora termoresistente. Le goccioline di vapore possono contenere solidi disciolti e sospesi presenti nell’acqua della caldaia che potrebbero contaminare gli alimenti o provocare danni agli impianti. Per questo è importante la generazione di vapore pulito, che dipende dalla caldaia, dall’acqua di alimentazione, dal sistema di distribuzione.
L’ACQUA NELLA SANIFICAZIONE
L’acqua è uno dei veicoli primari per la sanificazione all’interno del processo produttivo, presente nel prelavaggio, nelle soluzioni detergenti e disinfettanti, nel risciacquo intermedio e finale. La durezza è uno dei parametri
based on the use of semi-permeable membranes capable of retaining suspended solids and other substances, separating them from the water, without resorting to chemical products. It is also a process that takes place at low temperatures. Membrane filtration can be micro, ultra and nanofiltration and reverse osmosis. The pore diameter of microfiltration membranes varies from 0.1 to 10µm. Ultrafiltration uses membranes with pores of approximately 0.002-0.1 µm capable of removing microorganisms, including some viruses. Nanofiltration and reverse osmosis are used to remove salts from water. The latter in particular removes over 99% of the salt content. This is an expensive technique. The membranes must be cleaned periodically with current or counter-current
washing, with air, with the use of chemical products and, if necessary, replaced. UVC rays are also used to reduce the microbial load in the water, without altering its chemical and organoleptic characteristics. UV-C light (2537 Å) alters the DNA of microorganisms, preventing their replication.
Thanks to ion exchangers, salts can be removed from the water, making it softer and/or deionized. In particular, calcium, magnesium and bicarbonate ions are removed, responsible for the formation of encrustations in the systems. Ion exchange resins are not capable of removing organic products, viruses or bacteria.
The food and beverage industry uses a lot of water, both as an ingredient and for washing, transporting, heating or cooling ingredients and
products. There is more and more talk about the sustainable use of water resources. In this sense, food companies adopt systems to reuse process water. Agricultural production uses waste water for irrigation or aquaculture, the cooling water can be reused for washing operations, as well as transport water for the production of ice, hot water or steam, always in compliance with quality standards in order to guarantee the potability of the water, also for cleaning purposes.
The use of steam
Water in the food industry is also used in the form of steam directly or indirectly in contact with the food. The heat of the steam helps to eliminate potential microbial contaminants, but not possible pollution, deriving from the
S•23 DIMENSIONE PULITO | 04/2024
per valutare la “bontà” dell’acqua da utilizzare durante i processi di sanificazione. Essa può essere temporanea quando i sali precipitano e formano calcare, oppure permanente se i sali rimangono disciolti. Un’acqua dura riduce l’attività dei prodotti detergenti e disinfettanti, aumentandone il consumo, al fine di ottenere il risultato voluto. Il calcare inoltre ripara i microrganismi e rende le operazioni di disinfezione più complicate. Più l’acqua è dura, più il pH aumenta e deve essere tenuto sotto controllo grazie all’aggiunta di un acido, perché un pH alcalino potrebbe creare problemi di corrosione. Il calcare da solfato, così come quello da silicato non viene sciolto dagli acidi, e può essere evitato con l’utilizzo di appositi detergenti contenenti sequestranti. La loro presenza determina fenomeni di corrosione e la formazione di cattivi odori. Inoltre neutralizzano l’azione di alcuni agenti lubrificanti utilizzati in determinate attrezzature. Per tale motivo è consigliabile che i solfati siano inferiori a 30 mg/l e i silicati a 8 mg/l. Anche i colloidi devono essere tenuti sotto controllo perché favoriscono, tra l’altro, la formazione di biofilm e di depositi.
Se l’acqua è troppo dura va addolcita ad esempio con addolcitori a scambio
ionico. In alternativa, in commercio ci sono detergenti dotati di potere sequestrante per prevenire la precipitazione del calcare, grazie a sequestranti, ovvero molecole che formano
legami con gli ioni responsabili del calcare, quali calcio, magnesio, rame, ferro, formando complessi solubili, impedendo di conseguenza la formazione di depositi.

boiler, from the excessive presence of salts in the water, from corrosive phenomena on the system, from any heat-resistant microflora. The steam droplets may contain dissolved and suspended solids present in the boiler water which could contaminate food or cause damage to systems. This is why the generation of clean steam is important, which depends on the boiler, the feed water and the distribution system.
Role of water in sanification
Water is one of the primary vehicles for sanitization within the production process, present in the pre-wash, in detergent and disinfectant solutions, in the intermediate and final rinse. Hardness is one of the parameters for evaluat-
ing the "goodness" of the water to be used during sanitization processes. It can be temporary when the salts precipitate and form limestone, or permanent if the salts remain dissolved. Hard water reduces the activity of detergent and disinfectant products, increasing their consumption, in order to obtain the desired result. Limescale also repairs microorganisms and makes disinfection operations more complicated. The harder the water, the more the pH increases and must be kept under control by adding an acid, because an alkaline pH could create corrosion problems. Sulphate limescale, like silicate limescale, is not dissolved by acids, and can be avoided by using special detergents containing sequestrants. Their presence causes corrosion phenomena and the formation of bad
odors. They also neutralize the action of some lubricating agents used in certain equipment. For this reason it is advisable that sulphates are less than 30 mg/l and silicates less than 8 mg/l. Colloids must also be kept under control because, among other things, they favor the formation of biofilms and deposits. If the water is too hard it should be softened, for example with ion exchange softeners. Alternatively, there are detergents on the market with sequestering power to prevent the precipitation of limescale, thanks to sequestrants, i.e. molecules that form bonds with the ions responsible for limestone, such as calcium, magnesium, copper, iron, forming soluble complexes, preventing resulting in the formation of deposits.
S•24 DIMENSIONE PULITO | 04/2024 IGIENE ALIMENTARE IMPIANTI
L’innovazione che guarda al futuro
L’innovazione è il filo conduttore che accomuna l’intera produzione Igeax e orienta lo sviluppo di prodotti efficienti e sicuri in grado di soddisfare le specifiche esigenze del settore alimentare. La gamma in continua evoluzione si è recentemente arricchita di nuovi strumenti progettati per superare brillantemente ogni sfida, dalla preparazione del cibo alla pulizia delle superfici. A tal riguardo, i raschietti in polipropilene rappresentano una soluzione completa e utile in tutte le fasi: disponibili nella versione rigida e flessibile, sono ideali sia quando si processano alimenti molli e semiliquidi sia per la rimozione di residui da ogni tipo di superficie tra cui piani delicati, recipienti tondeggianti e bordi sottili. Ugualmente versatili, i nuovi pennelli sono imbattibili nei lavori di precisione: grazie alla rasatura a punta, garantiscono una distribuzio-
ne uniforme degli alimenti e una rimozione completa dello sporco dagli spazi più ristretti e difficili da raggiungere.
Tra le novità in gamma vi è anche una soluzione appositamente pensata per le temperature elevate: le speciali spazzole con fibre in PPS resistenti fino a 200°C sono progettate per rimuovere i residui da piani di cottura, griglie, teglie, padelle e superfici calde in generale. In particolare, lo spazzolino è ideale nei lavori di precisione mentre la spazzola è indicata per la pulizia intensa di superfici ampie.

la tracciabilità lungo l’intera filiera
Raschietti, pennelli e spazzole si distinguono inoltre per la speciale marcatura ecosostenibile che assicura
Innovation looking to the future
Innovation is the common thread that runs through all of Igeax’s production and guides the development of efficient and safe products that meet the specific needs of the food industry. The ever-evolving range has recently been enriched with new tools designed to brilliantly overcome any challenge, from food preparation to surface cleaning. For these purposes,
polypropylene scrapers are a complete and useful solution at all stages: available in hard and flexible versions, they are ideal when processing soft and semi-liquid food as well as for the removal of residues from all kinds of surfaces including delicate tops, rounded containers and thin edges. Just as versatile, the new brushes are unbeatable for precision work: thanks
Le novità non si esauriscono qui, da oggi la linea Hygiene offre uno strumento di prevenzione in più per favorire l’igiene e la sicurez-
za degli alimenti, tutelando la salute del consumatore: i prodotti sono ora disponibili in arancione, ampliando così ulteriormente la gamma di articoli Igeax in codice colore.
to their pointed trimming, they ensure even distribution of food and complete removal of dirt from the narrowest, hard-to-reach spaces. Among the new products in the range there is also a solution specially designed for high temperatures: special brushes with PPS fibres resistant up to 200°C are designed to remove residues from hobs, grills, pans and hot sur-
faces in general. In particular, the brush is ideal for precision work, while the small brush is suitable for intensive cleaning of large surfaces. Not only that, from now on the Hygiene line offers one more preventive tool to promote food hygiene and safety, protecting consumer health: products are now available in orange, further expanding the colour-coded Igeax range.
igeax.com informazione pubblicitaria
FULCRON. The solutions for mechanical washes with professional dishwashers

In the Ho.Re.Ca. segment, the increasingly strict regulations on food hygiene are driving industry operators to raise their cleaning standards.
Fulcron, a brand owned by Arexons, presents its Professional Dishwasher Detergents, which ensure highly professional results for mechanical washing with professional dishwashers and for their care and maintenance.
The Dishwasher Detergent, thanks to its excellent degreasing and sequestering properties, is particularly effective in removing grease and dry food residues. It is a concentrated alkaline low-foaming detergent, effective in soft, medium, and hard water conditions. Its composition reflects Arexons’ commit-
ment to the environment, as it is free of Chlorine, EDTA, and NTA. It is available in a 5 or 20-liter tank. The Dishwasher Rinse Aid, available in 5 or 10-liter tank, is a concentrated acid additive, ideal for the final rinse phase, which contains raw materials that ensure quick and impeccable drying without leaving unwanted streaks.
In addition to the detergents for large dishwashers, the line includes Fulcron Lavabar, in a 5-liter container, suitable for glassware machines and small dishwashers. It has excellent cleaning power, capable of removing even the most stubborn stains such as coffee, tea, lipstick, chocolate, and milk. The formulation is free of EDTA and NTA.
Fulcron also pays particular attention to the care and maintenance of professional dishwashers by offering Dishwasher Descaler. This product, available in a 5-liter tank, prevents corrosion and blockages, eliminating lime scale buildup and grease residues. Its formula does not introduce phosphates into the environment, which are considered harmful to the aquatic environment and responsible for the problem of eutrophication.
Fulcron Dishwashing Detergent is the specific product for manual dishwashing. Its neutral pH formulation is gentle on hands and respects dishes, ensuring deep and residue-free cleaning. The high-quality


surfactants in its composition ensure a degreasing and shining action, removing even the most stubborn dirt. It is available in a one-liter bottle and is also perfect for pre-soaking operations before automatic washes, pre-treating dishes, and facilitating the removal of encrustations and grease.
With the range of Professional Dishwasher Detergents, Fulcron continues to demonstrate its commitment to professional cleaning with targeted and innovative solutions. But not only that, Arexons, of which the Fulcron brand is part, is committed to sustainability by studying formulations that are increasingly environmentally friendly.

sponsored content
fulcron.it
Le soluzioni di FULCRON per i lavaggi meccanici con lavastoviglie professionali

Nel settore Ho.Re.Ca., le sempre più stringenti norme sull’igiene alimentare, spingono gli operatori del settore a elevare i loro standard di pulizia.
La linea di Detergenti Lavastoviglie Professionali di Fulcron, marchio di proprietà di Arexons, garantisce risultati altamente professionali per il lavaggio meccanico con lavastoviglie professionali e per la loro cura e manutenzione.
Il Detergente Lavastoviglie, grazie alle eccellenti proprietà sgrassanti e sequestranti, è particolarmente efficace nella rimozione di grasso e residui secchi di cibo. È un detergente concentrato alcalino a bassa schiuma, efficace in presenza di acque dolci, medie e dure. La sua composizione rispecchia l’impegno di
Arexons per l’ambiente, in quanto priva di Cloro, EDTA e NTA. È disponibile nel formato da 5 o da 20 litri.
Il Brillantante Lavastoviglie, in tanica da 5 o 10 litri, è un additivo acido concentrato, ideale per la fase finale di risciacquo, contenente materie prime che assicurano un’asciugatura rapida e impeccabile, senza lasciare aloni indesiderati.
Oltre ai detergenti per grandi lavastoviglie, la linea comprende il prodotto Fulcron Lavabar, nella tanica da 5 litri, adatto per macchine lavabicchieri e piccole lavastoviglie. Ha un’ottima capacità detergente, in grado di rimuovere anche le macchie più ostinate come quelle di caffè, tè, rossetto, cioccolata e latte. La formulazione è priva di EDTA e NTA.
Anche alla cura e alla manutenzione delle lavastoviglie professionali Fulcron dedica una particolare attenzione proponendo il Disincrostante Lavastoviglie. Tale prodotto, disponibile nel formato da 5 litri, previene i danni da corrosione e otturazione, eliminando gli accumuli di calcare e i residui di grasso.
La sua formula non comporta l’immissione nell’ambiente di fosfati, considerati dannosi per l’ambiente acquatico e responsabili del problema dell’eutrofizzazione.
Fulcron Detergente Piatti è, invece, il prodotto specifico per il lavaggio manuale delle stoviglie. La sua formulazione a pH neutro è delicata sulle mani e rispetta le stoviglie, garantendo una pulizia profonda e senza residui. I


tensioattivi di alta qualità presenti nella sua composizione assicurano un’azione sgrassante e brillantante, rimuovendo anche lo sporco più ostinato. È disponibile nel flacone da un litro ed è perfetto anche per le operazioni di ammollo prima dei lavaggi automatici, pretrattando le stoviglie e facilitando la rimozione di incrostazioni e unto.
Con la gamma Detergenti Lavastoviglie professionali, Fulcron continua a dimostrare il suo impegno nel campo della pulizia professionale con soluzioni mirate e innovative. Ma non solo, Arexons, di cui il marchio Fulcron fa parte, si impegna nel campo della sostenibilità con lo studio di formulazioni sempre più attente all’ambiente.

informazione pubblicitaria
fulcron.it



IL SUPER PULITO CHE SORPRENDE!








PRESTAZIONI PROFESSIONALI PER OGNI SUPERFICIE







Fulcron offre una gamma completa per la pulizia e l’igiene di qualsiasi ambiente, domestico e professionale. Grazie alla continua ricerca, i prodotti Fulcron offrono elevate prestazioni in termini di efficacia e rapidità d’azione e minimizzano l’impatto ambientale.
Fulcron è un brand di proprietà di Arexons S.p.a. scopri di più su www.fulcron.it




























































































































Resistenza agli antimicrobici: cause e conseguenze di un problema per la catena alimentare
Detergenti e disinfettanti sono un’importante misura di protezione della salute pubblica. Sono strumenti fondamentali anche per garantire la sicurezza dei prodotti alimentari
Francesca De Vecchi Tecnologa alimentare
Le corrette procedure di controllo dell’igiene dei processi di produzione prevedono il ricorso a detergenti e disinfettanti, secondo una metodologia pianificata in relazione ai pericoli connessi con una data produzione. L’utilizzo ha tuttavia alcune controindicazioni o, forse sarebbe più corretto dire, dei punti critici da gestire con particolare attenzione anche in relazione al concetto di sviluppo di una resistenza.
La resistenza antimicrobica (AMR) è infatti la capacità di un microrganismo di resistere all’azione di un agente antimicrobico, mediante una mutazione
genetica o il trasferimento di geni di resistenza da un microrganismo ad un altro. È un fenomeno che avviene naturalmente, con meccanismi diversi, come forma di adattamento all’ambiente per acquisire appunto l’abilità di resistere a molecole potenzialmente in grado di uccidere o arrestare la crescita (1). La conseguenza è dunque che i trattamenti diventano inefficaci e i microrganismi sopravvivono. Il fenomeno coinvolge sia agenti patogeni sia batteri alterativi e commensali che traggono benefici dalla loro associazione con l’uomo (e sono generalmente innocui) ma che possono costituire
un serbatoio di geni di resistenza, trasferiti tra specie batteriche nell’uomo e negli animali.
Va fatta prima di proseguire una precisazione. Per molto tempo si è parlato più comunemente di resistenza agli antibiotici, cioè a farmaci utilizzati per trattare le infezioni batteriche. Si è scelto più di recente di usare il termine “antimicrobico” perché più ampio, comprendendo non solo i farmaci ma anche tutta una serie di altri agenti infettivi come virus, protozoi, funghi responsabili potenzialmente di altrettante malattie. Tanto i primi quanto i secondi meritano la stessa attenzio-
S•30 DIMENSIONE PULITO | 04/2024 IGIENE ALIMENTARE
SICUREZZA

ne quando si ragiona in termini di resistenza, per cui è razionale usare il termine ombrello “antimicrobica”, per un problema – la resistenza - che ha assunto ormai proporzioni globali (2).
L’uso di sostanze ad azione antimicrobica per eliminare i patogeni e controllare la diffusione delle malattie infettive ha rappresentato certamente una svolta nella medicina. Se da un lato
quindi la resistenza ha ripercussioni dirette e indirette sulla salute pubblica, perché diminuisce la risposta alle terapie aumentando il rischio di decessi causati dalle infezioni (sia nell’uomo







ANTIMICROBIAL RESISTANCE: CAUSES AND CONSEQUENCES OF A PROBLEM FOR THE
Detergents and disinfectants are an important public health protection measure. They are also fundamental tools for ensuring the safety of food products
Correct hygiene control procedures for production processes include the use of detergents and disinfectants, according to a methodology planned in relation to the dangers associated with a given production. However, its use has some contraindications or, perhaps it would be more correct to say, critical points to be managed with particular attention also in relation to the concept of developing resistance.
FOOD CHAIN
Antimicrobial resistance (AMR) is in fact the ability of a microorganism to resist the action of an antimicrobial agent, through a genetic mutation or the transfer of resistance genes from one microorganism to another. It is a phenomenon that occurs naturally, with different mechanisms, as a form of adaptation to the environment to acquire the ability to resist molecules potentially capable of killing or stopping growth (1).
The consequence is therefore that the treatments become ineffective and the microorganisms survive. The phenomenon involves both pathogens and spoilage and commensal bacteria that benefit from their association with humans (and are generally harmless) but which can constitute a reservoir of resistance genes, transferred between bacterial species in humans and animals.
A clarification must be made before continuing. For a long time, resistance to antibiotics, that is, to drugs used to treat bacterial infections, was most commonly talked about. More recently it has been chosen to use the term “antimicrobial” because it is broader, including not only drugs but also a whole series of other infectious agents such as viruses, protozoa, fungi potentially responsible for as many diseases. Both the former and the latter deserve the same attention when thinking in terms of resistance, so it is rational to use the umbrella term
S•31 DIMENSIONE PULITO | 04/2024

sia negli animali da allevamento, per esempio), dall’altro, nella filiera alimentare, può avere importanti ricadute sulla sicurezza dei prodotti, perché limita le possibilità di agire verso patogeni responsabili di tossinfezioni veicolate dal cibo. La catena di approvvigionamento alimentare infatti offre condizioni in cui il trasferimento del gene di resistenza può avvenire attraverso molteplici percorsi, destando preoccupazione per il profilo igienico degli alimenti (3). I batteri resistenti agli antimicrobici derivati da animali destinati alla produzione alimentare inoltre possono diffondersi all’uomo attraverso
l’ingestione o la manipolazione di alimenti contaminati da batteri zoonotici come Campylobacter, Salmonella o Escherichia coli, dal contatto diretto con gli animali o, più raramente, dalla contaminazione ambientale.
Le infezioni da batteri resistenti agli antimicrobici diventano un problema di salute pubblica nel momento in cui non riescono ad essere curate con i farmaci solitamente utilizzati e di sicurezza alimentare, se impediscono la cura degli animali da carne.
Limitare la diffusione del fenomeno di resistenza è quindi una priorità di salute pubblica globale. Sebbene molti
fattori contribuiscano all’aumento della resistenza antimicrobica nei batteri che infettano l’uomo, l’uso di antibiotici sia in ambito clinico umano che per gli animali da produzione alimentare è fra i principali responsabili. Nel tempo però sono state sollevate alcune preoccupazioni in merito alla possibilità di co-selezione (cioè, tra sostanze chimiche per l’igiene alimentare e la ridotta suscettibilità antimicrobica).
Quindi, se fra le cause che hanno elevato il problema a fenomeno planetario, viene anche ipotizzato l’uso di biocidi è corretto ragionare in merito a queste sostanze per diffondere un uso più consapevole fra gli operatori della filiera.
Vediamo nell’ordine la situazione attuale e le implicazioni dell’ampio fenomeno della resistenza.
AMR: LA SITUAZIONE EUROPEA
L’Ecdc (Centro europeo per la prevenzione e il controllo delle malattie) ha già lanciato l’allarme sulla crescente minaccia della resistenza antimicrobica, stimando che oltre 35mila persone muoiono ogni anno a causa di infezioni resistenti agli antibiotici nell’Unione europea (UE), in Islanda e in Norvegia. Tanto che il 13 giugno 2023 è stata adottata anche una raccomandazione
“antimicrobial” for a problem - resistance - which has now assumed global proportions (2). The use of substances with antimicrobial action to eliminate pathogens and control the spread of infectious diseases certainly represented a turning point in medicine. Therefore, if on the one hand resistance has direct and indirect repercussions on public health, because it decreases the response to therapies, increasing the risk of deaths caused by infections (both in humans and in farm animals, for example), on the other, in food supply chain, can have important repercussions on product safety, because it limits the possibilities of acting against pathogens responsible for foodborne infections. In fact, the food supply chain offers conditions in which the transfer of the resistance gene can occur through multiple pathways, raising concerns about the hygienic profile of foods (3).
Antimicrobial-resistant bacteria derived from food-producing animals can also spread to humans through ingestion or handling of food contaminated with zoonotic bacteria such as Campylobacter, Salmonella or Escherichia coli, from direct contact with animals or, more rarely, from environmental contamination.
Infections caused by bacteria resistant to antimicrobials become a public health problem when they cannot be treated with the drugs usually used and food safety, if they prevent the care of meat animals.
Limiting the spread of resistance is therefore a global public health priority. Although many factors contribute to the increase in antimicrobial resistance in bacteria infecting humans, the use of antibiotics in both human clinical settings and for food-producing animals is among the primary
culprits. Over time, however, some concerns have been raised regarding the possibility of co-selection (i.e., between food hygiene chemicals and reduced antimicrobial susceptibility).
Therefore, if the use of biocides is also hypothesized among the causes that have elevated the problem to a global phenomenon, it is correct to think about these substances to spread a more conscious use among operators in the supply chain.
Let’s see in order the current situation and the implications of the broad phenomenon of resistance.
AMR: the European situation
The European Center for Disease Prevention and Control (ECDC) has already raised the alarm about the growing threat of antimicrobial resistance, estimating that over 35,000 people die every year from antibiotic-resistant infections in the Europe-
S•32 DIMENSIONE PULITO | 04/2024 IGIENE ALIMENTARE
SICUREZZA
(4) del Consiglio relativa all’intensificazione delle azioni dell’UE per combattere la resistenza antimicrobica in un’ottica “One Health”, che interessa cioè la salute umana, la salute animale, la salute delle piante e l’ambiente insieme; l’azione deve avere carattere transfrontaliero perché l’AMR non può essere affrontata da un singolo settore in modo indipendente o da singoli paesi. Gli obiettivi da conseguire entro il 2030 devono raccogliere gli sforzi di tutti e sono: una riduzione del consumo complessivo di antibiotici, preferenze specifiche per gruppi di antibiotici e la mitigazione delle infezioni causate da agenti patogeni che sono spesso resistenti a più antibiotici contemporaneamente.
Efsa (l’Autorità europea per la sicurezza alimentare) ed Ecdc pubblicano annualmente in modo congiunto un monitoraggio sull’antibiotico resistenza nell’Unione. Secondo l’ultimo rapporto (5) emesso la situazione è più o meno stazionaria rispetto agli anni precedenti, ma comincia finalmente ad emergere come la riduzione dell’uso di antibiotici negli animali (allevati per la filiera alimentare e destinati all’alimentazione umana), possa far diminuire il fenomeno, soprattutto relativamente ad alcuni batteri.
Il rapporto presenta i principali risultati del monitoraggio sulla resistenza antimicrobica in Salmonella spp., Campylobacter jejuni e C. coli nell’uomo e negli animali destinati alla produzione alimentare e delle relative carni. Tanto per gli animali quanto per le loro carni, vengono analizzati anche i dati sulla resistenza antimicrobica di Escherichia coli che svolge la funzione di indicatore commensale (e vedremo in seguito l’importanza di un monitoraggio), su E. coli produttrici di beta-lattamasi a spettro esteso (ESBL)-/AmpC beta-lattamasi (AmpC)−/carbapenemasi (CP) e sulla presenza di Staphylococcus aureus meticillino-resistente (MRSA).
I risultati e le tendenze descritte dall’ultimo report sono coerenti con quelli degli anni precedenti. La resistenza antimicrobica in Campylobacter (in particolare in C. coli) e in alcuni ceppi di batteri della Salmonella rimane elevata. Campylobacter proveniente dall’uomo e da animali destinati alla produzione alimentare continua a mostrare una resistenza molto elevata alla ciprofloxacina, un antimicrobico che viene frequentemente usato per combattere le infezioni nell’uomo. La resistenza combinata agli antimicrobici di importanza critica, definita come
resistenza a due diversi antimicrobici specifici, è risultata bassa, in generale, in Salmonella, Campylobacter ed E.coli Come anticipato, sebbene siano state riscontrate variazioni individuali fra i vari Stati membri dell’UE, i principali indicatori mostrano che sono stati compiuti progressi significativi nella riduzione della resistenza antimicrobica negli animali destinati alla produzione alimentare in diversi Stati membri. Sebbene siano risultati da tenere monitorati, la buona notizia sarebbe quindi che le politiche di contenimento possono portare a risultati tangibili. Il problema della resistenza dipende non solo dall’uso di antimicrobici nella filiera alimentare ma anche dall’uso umano. L’incidenza delle infezioni da Klebsiella pneumoniae resistente è aumentata di quasi il 50% tra il 2019 e il 2022. E sono pochissimi i trattamenti efficaci disponibili. Secondo Andrea Ammon, direttore dell’ECDC, bisogna tenere alta l’attenzione sul problema, perché, nonostante alcuni progressi, la resistenza antimicrobica rimane una sfida significativa nell’UE. Per raggiungere gli obiettivi per il 2030 è indispensabile intensificare gli sforzi per ridurre l’uso non necessario di antibiotici e migliorare le pratiche di prevenzione e controllo delle infezioni”.
an Union (EU). , Iceland and Norway. So much so that on 13 June 2023, a Council recommendation (4) was also adopted on the intensification of EU actions to combat antimicrobial resistance from a “One Health” perspective, i.e. affecting human health, animal health , plant health and the environment together; the action must be cross-border in nature because AMR cannot be addressed by a single sector independently or by individual countries. The objectives to be achieved by 2030 must gather everyone’s efforts and are: a reduction in the overall consumption of antibiotics, specific preferences for groups of antibiotics and the mitigation of infections caused by pathogens that are often resistant to multiple antibiotics simultaneously. EFSA (the European Food Safety Authority) and ECDC jointly publish annual monitoring of antibiotic resistance in the Union. According to the
latest report (5) issued, the situation is more or less stationary compared to previous years, but is finally starting to emerge as the reduction in the use of antibiotics in animals (bred for the food chain and intended for human consumption), can reduce the phenomenon, especially in relation to some bacteria.
The report presents the main findings of monitoring of antimicrobial resistance in Salmonella spp., Campylobacter jejuni and C. coli in humans and animals intended for food and meat production. For both animals and their meat, data are also analyzed on the antimicrobial resistance of Escherichia coli which acts as a commensal indicator (and we will see the importance of monitoring later), on E. coli producing beta-lactamases extended-spectrum (ESBL)-/AmpC beta-lactamase (AmpC)−/carbapenemase (CP) and on the presence of methicil-
lin-resistant Staphylococcus aureus (MRSA).
The results and trends described by the latest report are consistent with those of previous years. Antimicrobial resistance in Campylobacter (particularly C. coli) and some strains of Salmonella bacteria remains high. Campylobacter from humans and food-producing animals continues to show very high resistance to ciprofloxacin, an antimicrobial that is frequently used to fight infections in humans. Combined resistance to critical antimicrobials, defined as resistance to two different specific antimicrobials, was low overall in Salmonella, Campylobacter and E.coli. As anticipated, although individual variations were found across EU Member States, key indicators show that significant progress has been made in reducing antimicrobial resistance in food-producing animals in several Member States. Although these results need to be
S•33 DIMENSIONE PULITO | 04/2024
BIOCIDI E RESISTENZA: IL PROBLEMA DELLA
CONCENTRAZIONE
Come dicevamo l’altro imputato è la possibile resistenza generata dall’uso inappropriato di detergenti e disinfettanti. Di recente sono stati pubblicati studi con l’intento di dimostrare un possibile rischio di sviluppo di resistenza antimicrobica, in seguito all’uso di biocidi così come di una relazione tra l’uso di biocidi nella produzione alimentare e lo sviluppo di resistenza. Sebbene molti riportino l’isolamento di ceppi batterici resistenti agli antimicrobici negli alimenti, mancano prove certe che si possa attribuire la resistenza all’uso di biocidi. Inoltre, sebbene esista un rischio teorico di causalità, molti degli studi condotti per dimostrarlo sono studi in vitro, condotti cioè in condizioni non reali: che utilizzano isolati batterici coltivati o addestrati in laboratorio, trattati con concentrazioni subletali (al di sotto di quelle raccomandate dall’industria alimentare) di disinfettanti o agenti igienizzanti.
I biocidi o gli agenti igienizzanti svolgono un ruolo cruciale in varie fasi della filiera alimentare. Sono ampiamente utilizzati per la pulizia e la disinfezione delle aree di allevamento del bestia-
SICUREZZA
monitored, the good news would therefore be that containment policies can lead to tangible results. The problem of resistance depends not only on the use of antimicrobials in the food chain but also on human use. The incidence of resistant Klebsiella pneumoniae infections increased by almost 50% between 2019 and 2022. And there are very few effective treatments available. According to Andrea Ammon, Director of the ECDC, attention must be kept high on the problem, because, despite some progress, antimicrobial resistance remains a significant challenge in the EU. To achieve the 2030 goals, it is essential to intensify efforts to reduce unnecessary use of antibiotics and improve infection prevention and control practices.”
me, comprese le strutture e i veicoli di trasporto. Trovano largo impiego nella produzione alimentare, nella disinfezione delle attrezzature, dei contenitori e degli ambienti di produzione e di vendita al dettaglio. Il loro utilizzo, come dimostrato nel corso dei secoli, garantisce lo stato igienico degli ambienti di lavorazione, controllando lo
sviluppo di patogeni e di microrganismi alterativi. Un dato inequivocabile arriva dall’Interagency Retail Listeria monocytogenes Risk Assessment degli Stati Uniti che ha stimato che il rischio previsto di listeriosi, derivante dal consumo di prodotti pronti al consumo affettati o preparati nei reparti di gastronomia al dettaglio, aumenta di circa il

Biocides and resistance: the problem of concentration
As we were saying, the other defendant is the possible resistance generated by the inappropriate use of detergents and disinfectants. Studies have recently been published with the aim of demonstrating a possible risk of development of antimicrobial resistance following the use of biocides as well as a relationship between the use of biocides in food production and the development of resistance. Although many report the isolation of antimicrobial-resistant bacterial strains in foods, there is a lack of clear evidence that resistance can be attributed to the use of biocides. Furthermore, although there is a theoretical risk of causality, many of the studies conducted to demonstrate it are in
vitro studies, i.e. conducted in non-real conditions: using bacterial isolates grown or trained in the laboratory, treated with sublethal concentrations (below those recommended by the food industry) of disinfectants or sanitizing agents. Biocides or sanitizing agents play a crucial role at various stages of the food supply chain. They are widely used for cleaning and disinfecting livestock areas, including transport facilities and vehicles. They are widely used in food production, disinfection of equipment, containers and production and retail environments. Their use, as demonstrated over the centuries, guarantees the hygienic state of the processing environments, controlling the development of pathogens and spoilage microorganisms. An unequivocal data comes from the
S•34 DIMENSIONE PULITO | 04/2024 IGIENE ALIMENTARE
Rubino Chem, igiene e sicurezza


Nei settori del food e della ristorazione, il rischio di contaminazione è sempre
in agguato. Mantenere standard igienici elevati è indispensabile per garantire la sicurezza di clienti e lavoratori, la salvaguardia della reputazione e per soddisfare i requisiti normativi. Ecco perché affidarsi a prodotti professionali è fondamentale.
Rubino Chem , esperto nel settore della pulizia professionale, comprende l’importanza della sicurezza alimentare e offre soluzioni performanti per rispondere alle esigenze di questi settori. La linea HiMiX Professional con i suoi prodotti, Protection 24H e Olè Es -
Rubino Chem, hygiene and safety
In the food and catering sectors, the risk of contamination is always lurking. Maintaining high standards of hygiene is essential to ensure the safety of both customers and workers, safeguard reputation, and meet regulatory requirements. That’s why relying on professional products is crucial. Rubino Chem, an expert in the field of professional cleaning, understands the importance of food
safety and offers high-performance solutions to meet the needs of these sectors. The HiMiX Professional line, with its products, Protection 24H and Olè Essenza Ultra, proves to be a reliable ally in ensuring high hygiene standards in a simple and lasting way.
HiMiX – Protection 24H is a multi-purpose detergent based on quaternary ammonium salts. Its ready-to-use formula
senza Ultra , si dimostra un alleato affidabile per garantire standard igienici elevati in modo semplice e duraturo.
HiMiX – Protection 24H è un detergente multiuso a base di sali d’ammonio quaternario. La sua formula pronta all’uso evapora rapidamente, non lascia aloni e non richiede risciacquo. Grazie alla sua speciale composizione, è in grado di rimuovere efficacemente germi e batteri con una semplice azione meccanica, garantendo una protezione fino a 24 ore su tutte le superfici, anche dopo numerose manipolazioni. Il prodotto è conforme agli standard H.A.C.C.P. ed è estremamente versatile, adatto a interventi su tutti i tipi di superfici e arredi.
HiMiX – Olè Essenza Ultra è un detergente profumato e concentrato. La sua formula pronta all’uso spolve-
ra, deterge, deodorizza e profuma ambienti e superfici. È efficace nella pulizia quotidiana di tutte le superfici dure, diradando la polvere grazie alla sua formula antistatica ed eliminando gli odori sgradevoli, rilasciando nell’ambiente una fragranza persistente e gradevole.
Affidandosi ai detergenti di Rubino Chem, tutte le imprese e attività possono garantire la qualità dei propri prodotti e servizi e il benessere dei propri clienti.


evaporates quickly, leaves no streaks, and does not require rinsing. Thanks to its special composition, it effectively removes germs and bacteria with simple mechanical action, providing protection for up to 24 hours on all surfaces, even after numerous manipulations. The product is compliant with H.A.C.C.P. standards and it is extremely versatile, suitable for interventions on all types of
surfaces and furnishings.
HiMiX – Olè Essenza Ultra is a scented and concentrated detergent. Its ready-to-use formula dusts, cleans, deodorizes, and perfumes environments and surfaces. It is effective in the daily cleaning of all hard surfaces, reducing dust thanks to its antistatic formula and eliminating unpleasant odours, releasing a persistent and pleasant fragrance into the environment.
rubinochem.it informazione pubblicitaria
SICUREZZA

41% se non vengono eseguite attività di pulizia, lavaggio e sanificazione. Sebbene i biocidi siano fondamentali per la sicurezza e l’igiene alimentare, qualsiasi prova che il loro uso corretto o improprio possa contribuire alla comparsa di batteri con un fenotipo
resistente agli antibiotici, non dovrebbe comunque essere ignorata (6).
Al di là del mancato nesso di causalità sperimentalmente provato fra biocida e resistenza, vanno comunque osservate le corrette modalità di impiego. Non solo l’uso (o abuso) di farmaci,
dunque, ma anche l’utilizzo di sostanze ad azione antimicrobica può favorire il fenomeno della resistenza rendendo sempre più difficile trovare strategie per limitare o contenere la diffusione di microrganismi indesiderati. Negli ambienti di produzione alimentare
Interagency Retail Listeria monocytogenes Risk Assessment of the United States which estimated that the expected risk of listeriosis, deriving from the consumption of sliced or prepared ready-to-eat products in retail delicatessen departments, increases by approximately 41% if no cleaning, washing and sanitizing activities are carried out. Although biocides are critical to food safety and hygiene, any evidence that their correct or improper use may contribute to the emergence of bacteria with an antibiotic-resistant phenotype should not be ignored (6).
Beyond the lack of experimentally proven causal link between biocide and resistance, the correct methods of use must still be observed. Not only the use (or abuse) of drugs, therefore, but also the
use of substances with antimicrobial action can favor the phenomenon of resistance, making it increasingly difficult to find strategies to limit or contain the spread of unwanted microorganisms. In food production environments, compliance with the manufacturer’s instructions for use must be guaranteed, as well as avoiding dilution of the biocide’s active agent, for example by applying it in contexts where biofilm is present. The biofilm present in processing environments offers protection to microorganisms against cleaning and disinfectant agents by reducing or preventing their access through the presence of exopolysaccharides, polymers that make up the external skeleton of the biofilm, which increases in thickness with the passage of time. Furthermore, the state of nutrient de-
privation of the organisms within the biofilms acts as a further stress factor, increasing, given the mutual proximity, the possibility of genetic exchanges and therefore the passage of resistance between one organism and another.
The discussion must be extended to the application of good production practices and therefore not only to the correct use of sanitizing products or the elimination of biofilm from all contact surfaces through appropriate practices, but ultimately to the application of GMP as a method of I work to mitigate the risk of resistance arising. Disinfectants are complex formulations, containing one or more biocides and a series of excipients or adjuvants that enhance their activity or have their own activity. It is true that the concentrations of chemical
S•36 DIMENSIONE PULITO | 04/2024 IGIENE ALIMENTARE
deve essere garantito il rispetto delle istruzioni per l’uso del produttore, nonché l’evitare la diluizione dell’agente attivo del biocida, per esempio applicandolo in contesti dove sia presente biofilm. Il biofilm presente negli ambienti di lavorazione offre protezione ai microrganismi contro gli agenti detergenti e disinfettanti riducendone o impedendone l’accesso attraverso la presenza di esopolisaccaridi, polimeri che costituiscono lo scheletro esterno del biofilm, che aumenta di spessore con il passare del tempo. Inoltre, lo stato di privazione di nutrienti degli organismi all’interno dei biofilm agisce come ulteriore fattore di stress aumentando, visto la vicinanza reciproca, la possibilità di scambi genetici e dunque il passaggio di resistenza fra un organismo e un altro.
Il discorso va esteso all’applicazione delle buone pratiche di produzione e quindi non solo all’uso corretto dei prodotti sanificanti o all’eliminazione del biofilm da tutte le superfici di contatto attraverso pratiche appropriate, ma in definitiva all’applicazione alle GMP come metodo di lavoro per mitigare il rischio che insorga una resistenza. I disinfettanti sono formulazioni complesse, contenenti uno o più biocidi e una serie di eccipienti o
coadiuvanti che ne potenziano l’attività o hanno una propria attività. È pur vero che le concentrazioni di sostanze chimiche, che possono favorire l’adattamento fenotipico del microrganismo (e quindi sviluppare una resistenza), sono significativamente al di sotto dei livelli raccomandati per l’uso ai fini dell’igiene alimentare ma un’applicazione inappropriata per esempio con la diluizione dei principi attivi, o il mancato raggiungimento delle popolazioni microbiche (ad esempio, se rimane sporcizia organica sulle superfici o biofilm) possono costituire un rischio per la resistenza antimicrobica. In conclusione, la limitazione dell’uso di antimicrobici nella produzione agricola primaria di prodotti alimentari (vegetali e animali) è senz’altro l’azione prioritaria a livello globale per ridurre al minimo il rischio che si sviluppi una resistenza alle molecole e ai principi attivi di difesa dai patogeni e dovrebbe essere raggiunta aderendo alle buone pratiche agricole e alle buone pratiche veterinarie in materia di farmaci, con uno sforzo collettivo. Per quanto riguarda i biocidi e l’applicazione in ambito alimentare è comunque bene, sia in un’ottica generale di prevenzione della resistenza sia di efficacia dell’azione di pulizia e disinfezio-
ne degli ambienti, attenersi a una corretta applicazione secondo le istruzioni del produttore. Non ultimi - secondo gli esperti - particolare impegno va dedicato all’elaborazione e messa in pratica di programmi di pulizia che dovrebbero considerare gli scenari peggiori. Le attività di verifica e monitoraggio dovrebbero comprendere l’ispezione visiva e altri mezzi per garantire la rimozione dei materiali proteici o dello sporco organico durante la pulizia e l’applicazione della concentrazione effettiva o del tempo di contatto del biocida.
Fonti consultate per questo articolo
1) Piano Nazionale di Contrasto all’Antibiotico-Resistenza (PNCAR) 20222025
(2) FAO, 2020
(3) Antibiotic Resistance and Food Safety: Perspectives on New Technologies and Molecules for Microbial Control in the Food Industry. https://www. mdpi.com/2079-6382/12/3/550
(4) Gazzetta ufficiale dell’Unione europea (5) Efsa.europa.eu
(6) Relationship of Sanitizers, Disinfectants, and Cleaning Agents with Antimicrobial Resistance https://www. sciencedirect.com/science/article/pii/ S0362028X22102310
substances, which can favor the phenotypic adaptation of the microorganism (and therefore develop resistance), are significantly below the levels recommended for use for food hygiene purposes but an inappropriate application for example with the dilution of active ingredients, or failure to reach microbial populations (for example, if organic dirt remains on surfaces or biofilms) can pose a risk for antimicrobial resistance.
In conclusion, the limitation of the use of antimicrobials in the primary agricultural production of food products (vegetable and animal) is certainly the priority action at a global level to minimize the risk of developing resistance to the molecules and active ingredients defense against pathogens and should be achieved by adhering to good agricultu-
ral practices and good veterinary practices regarding medicines, with a collective effort.
As far as biocides and application in the food sector are concerned, it is still best, both from a general perspective of preventing resistance and the effectiveness of the cleaning and disinfection action of environments, to follow correct application according to the manufacturer’s instructions. Last but not least - according to experts - particular effort must be dedicated to the development and implementation of cleaning programs that should consider the worst-case scenarios. Verification and monitoring activities should include visual inspection and other means to ensure removal of protein materials or organic fouling during cleaning and application of the effective concentration
or contact time of the biocide.
Sources consulted for this article
1) Piano Nazionale di Contrasto all’Antibiotico-Resistenza (PNCAR) 2022-2025
(2) FAO, 2020
(3) Antibiotic Resistance and Food Safety: Perspectives on New Technologies and Molecules for Microbial Control in the Food Industry. https:// www.mdpi.com/2079-6382/12/3/550
(4) Gazzetta ufficiale dell’Unione europea
(5) Efsa.europa.eu
(6) Relationship of Sanitizers, Disinfectants, and Cleaning Agents with Antimicrobial Resistance https://www.sciencedirect.com/science/article/pii/ S0362028X22102310
S•37 DIMENSIONE PULITO | 04/2024
Gli antiparassitari nella filiera alimentare
Nel realizzare questa breve nota sugli antiparassitari ho cercato di mediare le motivazioni emozionali che sempre più prendono piede nella popolazione e le esigenze oggettive che ne giustificano l’utilizzo. Nel mio scrivere non prendo in esame chi da entrambe le parti ne fanno una bieca speculazione
Graziano Dassi
Mi pare calzante la figura della mitologia greca di Ermes (Mercurio per i latini) che, condannato da Zeus a dire la verità, riuscì a negoziare la condanna accettando di essere vincolato a dire la verità ma di non essere costretto a dire tutta la verità. E, scaltro come era, dicendo delle verità parziali riusciva a sostenere tesi spudoratamente menzognere.
Vero è che viviamo un momento di mutamenti così rapidi che la dialettica non è più il metodo che attraverso la interazione di due o più tesi contrapposte diventa uno strumento di indagine per avvicinarsi alla verità, ma lo strumento per ottenere consensi. Sia come sia una cosa è certa non sono in possesso di tutta la verità, ma

S•38 DIMENSIONE PULITO | 04/2024 IGIENE ALIMENTARE
DISINFESTAZIONE
La schistosomiasi (detta anche bilharziosi o distomatosi sanguigna) è una parassitosi causata da Platelminti del genere Schistosoma. Il serbatoio del parassita sono gli individui infestati cronicamente: i bovini possono essere serbatoi di S. japonicum. Gli ospiti intermedi sono molluschi gasteropodi d'acqua dolce, differenti a seconda della specie in questione. La malattia ha forme acute e croniche, diverse a seconda delle specie in causa e degli organi o tessuti coinvolti. La malattia è causa di quasi 10.000 morti all'anno. (Wikipedia)
è altrettanto vero che non ho l’obiettivo di sostenere tesi menzognere. L’obiettivo è promuovere una riflessione e possibilmente delle convinzioni basate su dati oggettivi, ove possibile definiti da numeri. Per fare ciò inizio a riportare delle cifre relative ai danni che i parassiti arrecano all’agricoltura nei paesi latino americani (Tab. 1).
Per quanto concerne la produzione dello scorso anno di mais la cifra stimata è di 850 mln di tonnellate ragion per cui se la percentuale di perdite fosse sempre del 40% si otterrebbe la cifra astronomica di 350 mln di t andate perdute. Più dell’intera produzione annua del Brasile.
Nella speranza che l’evoluzione agronomica e le migliori tecniche di lotta ai parassiti dimezzino la percentuale
di perdita con la diminuzione di utilizzo di antiparassitari, le cifre ci indicano che molto rimane da fare.
UNO SGUARDO ALLE
PARASSITOSI IMPORTANTI IN ALCUNE NAZIONI AFRICANE
A volo radente menziono, a puro titolo esemplificativo, la lotta alla locusta del deserto, alla mosca tsè tsè (vettore della tripanosomiasi o malattia del sonno), alle zanzare malarigene e la lotta alle limacce per contrastare la bilharziosi. In questo quadro di per sé allarmante il ruolo dell’educazione sanitaria, del rispetto dell’ambiente e l’introduzione di strategie di lotta sostenibili gli antiparassitari hanno una parte insostituibile. Naturalmente là dove servono, per il tempo che servo -
no, erogati al giusto dosaggio e nella giusta misura.
PAESI ASIATICI
Nel complesso continente asiatico mi limito a citare le numerose problematiche relative alla filiera del riso (Cina 212 milioni di t a seguire l'India con 178,3 e il Bangladesh con circa 55 milioni) per il settore agricolo e la malaria per la salute pubblica. Per dare un’idea di quanto incida la malaria nel mondo i dati per il 2017 sono 219 milioni di casi di infezione malarica con 435.000 decessi. Certamente il dato è impressionante e immaginando l’impegno tecnico ed economico che coinvolge la comunità scientifica, le varie organizzazioni (in primis l’OMS) e le varie Nazioni per debellare questo flagello è impossibile non provare un certo stupore di come un piccolissimo insetto riesca a tenere in scacco cotante risorse. In una scala enormemente più piccola riporto un esempio emblematico: in un allevamento industriale di suini da ingrasso in provincia di Lodi da alcuni anni si riscontra un deprezzamento di alcuni tagli nobili (cosce) perché le punture delle zanzare lasciano un







PESTICIDES IN THE FOOD SUPPLY CHAIN
In producing this brief note on pesticides, I have tried to mediate the emotional motivations that increasingly take hold in the population and the objective needs that justify their use. In my writing, I do not examine those on both sides who make it into a blatant speculation
The Greek mythological figure of Hermes (Mercury for the Latins) who, condemned by Zeus to tell the truth, managed to negotiate the sentence by accepting to be bound to tell the truth but not to be forced to tell the whole truth, seems fitting to me. And, astute as he was, by telling partial truths he managed to support shamelessly lying theories.
It is true that we live in a moment of such rapid changes that dialectics is no longer the method
which, through the interaction of two or more opposing theses, becomes an investigative tool for getting closer to the truth, but the tool for obtaining consensus.
Be that as it may, one thing is certain that I am not in possession of the whole truth, but it is equally true that I do not have the aim of supporting false theses. The objective is to promote reflection and possibly beliefs based on objective data, where possible defined by numbers.
To do this I begin to report some figures relating to the damage that parasites cause to agriculture in Latin American countries.
As regards last year's production of corn, the estimated figure is 850 million tonnes, which is why if the percentage of losses were always 40% we would obtain the astronomical figure of 350 million tonnes lost. More than Brazil's entire
annual production. In the hope that agronomic evolution and better pest control techniques will halve the percentage of loss with the reduction in the use of pesticides, the figures show us that much remains to be done.
A look at important parasites in some African nations
I mention, purely by way of example, the fight against the desert locust, the tsetse fly (vector of trypanosomiasis or sleeping sickness), malarial mosquitoes and the fight against slugs to combat bilharzia. In this already alarming picture, the role of health education, respect for the environment and the introduction of sustainable control strategies, pesticides play an irreplaceable part. Naturally where they are needed, for the time they are needed, delivered
S•39 DIMENSIONE PULITO | 04/2024
(Tab.1) Danni da parassiti all'agricoltura Paesi latino americani
TIPO DI COLTIVAZIONE PERDITA DI PRODUZIONE PER ATTACCHI PARASSITARI RIFERITI ALLA SECONDA METÀ DEL XX SECOLO I DATI ATTUALI NON SONO RIUSCITO A REPERIRLI
25 %
(MAIS) 40 %
34 %
CANNA DA ZUCCHERO 39 %
33 %
CAFFÈ 42 %
COLTURE A SEMI MINUTI 27 %
segno sulle carni. A titolo di cronaca l’integrazione fra la disinfestazione in atto sul territorio comunale e quelle adottate in ambito aziendale ha ridotto il problema, che pur tuttavia permane sia pure in forma assai ridotta. La tesi che sostengo potrebbe essere letta come un atteggiamento polemicamente controcorrente, ma non lo è nel modo più assoluto. Mi limito a cambiare la prospettiva con cui si osserva il fenomeno. E a ben guardare mi pare che il mio punto di vista sia valido anche per la plastica e gli antibiotici. Infatti, non sono gli antiparas-
sitari, le plastiche e gli antibiotici i colpevoli, ma il loro errato uso. (Tab. 2). La fonte è la Food and Drug Administration - risalgono ad alcuni decenni fa. Sarebbe interessante vedere come la migliorata competenza professionale e la maggiore coscienza ambientalista abbia modificato le cose e magari il numero totale dei casi indagati da cui sono state ricavate le percentuali.
CONCLUSIONI
Nell’ambito dei servizi di disinfestazione nell’ambito della filiera alimentare sempre più si sottolinea a ragion
veduta l’importanza del monitoraggio e della valutazione dei risultati. Dal mio punto di osservazione mi sentirei di affermare che là dove le norme volontarie sono state tradotte in comportamenti virtuosi (gestionali, strutturali e tecnico-professionali) il livello igienico ambientale e produttivo è migliorato in modo significativo.
at the right dosage and in the right measure.
Asian countries
In the complex Asian continent, I will simply mention the numerous problems relating to the rice supply chain (China 212 million tonnes, followed by India with 178.3 and Bangladesh with around 55 million) for the agricultural sector and malaria for public health.
To give an idea of how much malaria affects the world, the data for 2017 are 219 million cases of malaria infection with 435,000 deaths. Certainly the data is impressive and imagining the technical and economic commitment that involves the scientific community, the various organizations (primarily the WHO) and the various nations to eradicate this scourge, it is impossible not to feel a certain amazement at how a very small insect manages to keep so many resources in check. On an enormously
smaller scale, I report an emblematic example: in an industrial fattening pig farm in the province of Lodi, for some years there has been a depreciation of some noble cuts (thighs) because mosquito bites leave a mark on the meat. For the record, the integration between the disinfestation in place in the municipal area and those adopted within the company has reduced the problem, which nevertheless remains, albeit in a much reduced form.
The thesis I support could be read as a polemically counter-current attitude, but it is not absolutely so. I limit myself to changing the perspective with which the phenomenon is observed. And upon closer inspection it seems to me that my point of view is also valid for plastic and antibiotics. In fact, it is not pesticides, plastics and antibiotics that are the culprits, but their incorrect use.
Report on all cases of accidental poisonings
(Tab. 2) Rapporto su tutti i casi di avvelenamenti accidentali (infausti e no) riscontrati negli Stati Uniti d'America
(unfortunate and otherwise) found in the United States of America.
The source is the Food and Drug Administration - they go back a few decades. It would be interesting to see how improved professional competence and greater environmental awareness have changed things and perhaps the total number of cases investigated from which the percentages were obtained.
To sum up
In the context of disinfestation services in the food supply chain, the importance of monitoring and evaluating results is increasingly underlined. From my point of observation I would say that where voluntary standards have been translated into virtuous behavior (managerial, structural and technical-professional) the level of environmental and production hygiene has improved significantly.
S•40 DIMENSIONE PULITO | 04/2024 IGIENE ALIMENTARE
DISINFESTAZIONE
PRODOTTI FARMACEUTICI 57,9 % SOSTANZE PER LAVAGGIO E LUCIDATURE 12,0% COSMETICI 4,9 % ANTIPARASSITARI 4,9% TREMENTINA E COLORI 4,5 PIANTE VELENOSE 3,9 PRODOTTI PETROLCHIMICI 3,7 GAS E VAPORI 0,6 VARIE 6,3 IGNOTE 1,3
RISO
GRANOTURCO
COTONE
-
-
-
BANANE
-
-
Soluzioni innovative nel nuovo catalogo Copyr

Il 2024 ha visto un importante rinnovamento del catalogo Copyr dedicato ai professionisti della disinfestazione che si è arricchito oltre che di nuovi prodotti, di contenuti tecnici, nuove sezioni e consigli di utilizzo. Tra le novità più importanti spiccano
Only PyTM Microcaps, a completamento della linea Only Py TM, e il nuovo Goliath Gel New, che vanno ad aggiungersi all’innovativa KenyaSafe Py Plus e all’attrezzatura di riferimento per la nebulizzazione ULV, ossia il Nebulo EVO a Batteria. Only PyTM Microcaps è un insetticida concentrato microincapsulato ad ampio spettro d’azione. Contiene Piretro, un prin-
cipio attivo di origine vegetale che si ricava dai fiori di una pianta della famiglia delle Asteraceae, il Tanacetum cinerariifolium. Le microcapsule che contengono il Piretro sono realizzate con materiali di origine vegetale e libere da microplastiche. Le caratteristiche fisiche del formulato rendono Only PyTM Microcaps l’insetticida ideale per la difesa degli ambienti domestici, civili e industriali da insetti nocivi. Only PyTM Microcaps è efficace fino a una settimana dal trattamento contro zanzara comune e zanzara tigre per trattamenti all’interno e intorno alle abitazioni. È adatto per il controllo di zanzare, insetti striscianti, infestanti delle derrate, pulci e zecche che comunemente infestano gli ambienti civili,

domestici, industriali, zootecnici e le aree verdi. Le caratteristiche fisico-chimiche del formulato rendono possibile l’utilizzo con pompe irroratrici manuali e a motore, atomizzatori, compresi i nebulizzatori ULV (solo in ambienti interni).*
Goliath Gel New è il gel di BASF distribuito da Copyr. Goliath® Gel New è un’insetticida con azione attrattiva efficace contro vari tipi di scarafaggi: blattella germanica (Blattella germanica), blatta orientale (Blatta orientalis), blatta americana (Periplaneta americana) e blatta marrone o blatta dei mobili (Supella longipalpa) presenti allo stadio di sviluppo di ninfe e adulti.*
*Il testo corrisponde a quanto riportato in etichetta.
Innovative solutions in the new Copyr catalogue
In 2024, Copyr revamped its pest control catalog, adding new products and enhancing it with technical information, new sections, and usage tips.
Notable additions like Only PyTM Microcaps, which complements the existing Only Py line, and the new Goliath Gel New were introduced, along with the innovative KenyaSafe Py Plus and the benchmark ULV misting equipment, the Nebulo EVO Battery. Only PyTM Microcaps is a
broad-spectrum microencapsulated insecticide containing Pyrethrum, a plant-derived active ingredient extracted from a flower of the Asteraceae family, Tanacetum cinerariifolium. The microcapsules containing Pyrethrum are made from plant-derived materials and are free from microplastics. The physical characteristics of the formulation make Only PyTM Microcaps the ideal insecticide for protecting domestic, civil, and industrial envi-
ronments from harmful insects. It remains effective for up to a week against common mosquitoes and tiger mosquitoes for treatments inside and around homes. It is suitable for controlling mosquitoes, crawling insects, stored product pests, fleas, and ticks commonly found in domestic, civil, industrial, livestock, and green areas. The physical and chemical properties of the formulation allow for use with manual and motorized sprayers, atomizers, including
ULV misters (indoors only).*
Goliath Gel New is the BASF gel distributed by Copyr in Italy. Goliath® Gel New is an attractively effective insecticide against various types of cockroaches: German cockroach (Blattella germanica), Oriental cockroach (Blatta orientalis), American cockroach (Periplaneta americana), and Brown-banded cockroach (Supella longipalpa) in nymph and adult stages.* * information provided on the label.
copyr.eu informazione pubblicitaria
Nuvex Smoke: insetticida fumogeno a base di piretro autorizzato per l’impiego nelle industrie alimentari
Nell’ambito delle operazioni alimentari, il controllo degli insetti è una priorità assoluta per garantire la sicurezza e la qualità dei prodotti. In questo contesto, Nuvex Smoke emerge come un’opzione altamente efficace, grazie alla sua formulazione innovativa basata sull’estratto di piretro, un potente principio attivo di origine vegetale.
POTENZA NATURALE DEL PIRETRO
NELL’ELIMINAZIONE
DEGLI INSETTI
La natura vegetale del piretro rende il Nuvex Smoke perfettamente idoneo all’applicazione nelle industrie alimentari, poiché offre un’alta efficacia nei confronti degli insetti senza ricorrere a sostanze attive di
derivazione chimica.
La formulazione di Nuvex
Smoke consente una distribuzione uniforme del piretro all’interno degli ambienti trattati, raggiungendo anche gli angoli più nascosti e difficili da raggiungere. In questo modo,
si elimina la necessità di interventi mirati, garantendo una copertura completa e una maggiore efficacia nel controllo degli insetti.
La tecnologia di questo prodotto assicura quindi una rapida dispersione del principio attivo nell’am-

biente consentendo un’azione istantanea sugli insetti presenti.
SICUREZZA E CONFORMITÀ
ALLE NORMATIVE
Grazie alla sua formulazione a base di piretro, Nuvex
Smoke rispetta i rigorosi standard di sicurezza e igiene imposti nel settore alimentare. Questo insetticida fumogeno non lascia residui sulle superfici trattate e non presenta rischi significativi per la salute umana o l’ambiente circostante.
È registrato presso il Ministero della Salute come PMC (Presidio Medico Chirurgico) e riporta in etichetta diversi campi d’impiego tra cui l’industria alimentare.
Nuvex Smoke: pyrethrum-based smoke insecticide authorized for use in food industries
Within the purview of food operations, insect control stands as an absolute priority to ensure the safety and quality of products. In this context, Nuvex Smoke emerges as a highly effective option, owing to its innovative formulation based on pyrethrum extract, a strong plant-based active ingredient.
Natural power of pyrethrum in insect removal
The plant-based nature of py-
rethrum makes Nuvex Smoke perfectly suitable for application in food industries, offering high efficacy against insects without resorting to chemically derived active substances. The formulation of Nuvex Smoke allows uniform distribution of pyrethrum within treated environments, reaching even the most hidden and hard-to-reach corners. This eliminates the need for targeted interventions, ensuring
complete coverage and greater effectiveness in insect control. The technology of this product therefore ensures a rapid dispersion of the active ingredient in the environment, allowing instant effect on the present insects.
Safety and regulatory compliance
Thanks to its pyrethrum-based formulation, Nuvex Smoke adheres to the
stringent safety and hygiene standards imposed in the food sector. This smoke insecticide leaves no residues on treated surfaces and does not present significant risks to human health or the surrounding environment.
It is registered with the Ministry of Health as a Medical Device and indicates various fields of application on its label, including the food industry.
informazione pubblicitaria
newpharm.it

Addio zanzare e insetti molesti








New-Wall®







Insetticida in microemulsione acquosa, dotato di un rapido e persistente effetto abbattente e residuale.
Newthrin®
Microemulsione concentrata dalla massima azione abbattente coniugata ad un alta persistenza.
Nuvex® NO PBO
Emulsione concentrata a base di piretro, esercita un’azione snidante e un rapido effetto abbattente. Formulato con solventi a basso impatto ambientale.









www.newpharm.it
NEWTHRIN® NEW-WALL®
NUVEX® NO PBO
gli impianti automatizzati Presidi Medico Chirurgici (New-Wall ® Reg. n° 21329Newthrin ® Reg. n° 19494Nuvex ® NO PBO Reg. n° 20867). Prima dell’uso, leggere attentamente l’ etichetta e le informazioni sui prodotti.
Scopri
Una novità nella lotta agli scarafaggi
Premesso che la novità non è né tecnica né “entomologica”, ma risiede nel contesto ambientale. Ovvero si tratta di bonificare un piccolo edificio da anni utilizzato come sgabuzzino delle cose “che potrebbero servire”, cosa che poi non accade, per cui si era trasformato in un ricettacolo di polvere e in qualche riga negli inventari
Graziano Dassi

S•44 DIMENSIONE PULITO | 04/2024 IGIENE ALIMENTARE
DISINFESTAZIONE
Lstruttura è una palazzina di due piani costituita da un locale seminterrato di poco meno di 200 m2 con accesso per mezzo di una rampa. Un ex garage con un locale caldaia e una scala interna per accedere al piano rialzato costituito da tre locali più servizi igienici. Il primo piano è una sorta di open space con servizi e il tetto è costituito da un terrazzo. Corre voce che sarebbe più economico abbattere il tutto e costruire ex novo, ma che possibili intoppi burocratici abbiano indotto alla ristrutturazione. Sono voci di corridoio che poco coinvolgono la ditta servizi incaricata delle pulizie edili, della disinfestazione e dello sgombero materiali che viene affiancata da elettricisti dipendenti della società incaricati di sostituire il vecchio impianto elettrico con uno a norma.
Il primo incontro effettuato in remoto ha come ordine del giorno la stesura di un disciplinare tecnico, la relativa stima di costi, tempistica, garanzie ed eventuali penali da inserire nei contratti di affidamento. Le fasi principali richieste riguardanti la disinfestazione e disinfezione preliminari hanno come obiettivo garantire che i successivi in-
terventi di sgombero e ristrutturazione avvengano in condizioni ottimali. L’unica informazione fornita è che non vi erano tracce di roditori, ma era stata riscontrata una infestazione di blattelle germaniche, ragni, porcellini di terra e insetti vari. Le principali garanzie da fornire consistevano nel fatto che il materiale destinato alla discarica non fosse “abitato”, che gli ambienti post disinfestazioni non presentassero inquilini abusivi e, naturalmente, che gli addetti che successivamente avrebbero operato nei locali a vario titolo lo potessero fare in assoluta sicurezza. Nello stilare la relazione mi ronzava nella mente il trinomio che dovrebbe sempre, a parer mio, guidare la nostra professionalità: - la tecnica deve suggerire le soluzioni; - l’economia indirizzare le scelte (NB: economia non significa il prezzo più basso);
- la politica (intesa come gestione a tutto tondo) stabilire le priorità e la pianificazione.
SOLUZIONI TECNICHE
RIGUARDANTI LA DISINFESTAZIONE
I tempi stretti e la necessità di garanti-
re il risultato senza il rischio di residui attivi ha indirizzato la scelta degli insetticidi verso formulati ad azione abbattente, privi di effetti residuali e con un’ottima azione stanante.
Per le attrezzature di erogazione la scelta si è rivolta verso delle irroratrici a batteria dotate di lancia con ugello di erogazione a ventaglio regolabile in modo da poter regolare la sospensione insetticida a diverse micronizzazioni e il vantaggio di poter utilizzare una sola attrezzatura.
La modalità di applicazione consisteva in un intervento centripeto ovvero dal perimetro esterno verso il centro, trattando il pavimento e le pareti con l’ugello regolato a metà corsa in modo da poter “bagnare bene” evitando il più possibile sgocciolamenti.
Il materiale e le attrezzature dismesse furono micro-irrorate dando un giro ulteriore alla ghiera dell’ugello con l’obiettivo di avere il massimo della copertura possibile.
Per le canaline dell’impianto elettrico invece l’ugello è stato aperto al massimo per avere il getto il più ristretto possibile e la massima distanza di erogazione consentita dall’attrezzatura. NB: non vi era passaggio di corrente







A NOVELTY IN THE FIGHT AGAINST COCKROACHES
The structure examined in this article is a two-storey building consisting of a basement room of just under 200 m 2 with access via a ramp. A former garage with a boiler room and an internal staircase to access the mezzanine floor consisting of three rooms plus toilets. The first floor is a sort of open space with services and the roof consists of a terrace. There is a rumor that it would be cheaper to tear down everything and build from scratch, but that possible bureaucratic obstacles have led to the renovation. These are rumors that do little to involve the service company in charge of building cleaning, disinfestation and material clearing, which is supported by electricians employed by the company in charge of replacing the old electrical system with a compliant one.
The first meeting, held remotely, has as in its
agenda the drafting of a technical specification, the related estimate of costs, timing, guarantees and any penalties to be included in the assignment contracts.
The main phases required regarding preliminary disinfestation and disinfection aim to ensure that subsequent clearing and renovation interventions take place in optimal conditions.
The only information provided was that there were no traces of rodents, but an infestation of Blattella germanica, spiders, wood pigs and various insects had been found.
The main guarantees to be provided consisted in the fact that the material destined for the landfill was not "inhabited", that the post-disinfestation environments did not have illegal tenants and, naturally, that the workers who would subsequently operate in the premises in vari-
ous capacities could do so in absolute safety. While drawing up the report, the trinomial that should always, in my opinion, guide our professionalism was buzzing in my mind: - the technique must suggest solutions; - the economy directs choices (NB: economy does not mean the lowest price); - politics (understood as all-round management) establishing priorities and planning.
Technical solutions regarding disinfestation
The tight deadlines and the need to guarantee the result without the risk of active residues have directed the choice of insecticides towards formulations with a knockdown action, without residual effects and with an excellent rooting out action.
S•45 DIMENSIONE PULITO | 04/2024
elettrica. Per le operazioni di finissaggio si è chiuso l’ugello al massimo in modo di poter erogare una nebbia grossolana. I consumi sono stati di poco meno di 90 L all’1% di concentrazione (superfici orizzontali + erogazione nell’aria ambiente + materiale da smaltire + alcuni punti da ripassare) pari a un litro di formulato commerciale.
Gli ambienti sono rimasti chiusi per poco più di 75 ore. Il montante ore è stato di 6 ore per un tecnico e contemporaneamente 6 ore di un operatore generico.
OPERAZIONI DI
DISINFEZIONE
Alla riapertura si è proceduto a una disinfezione utilizzando un nebulizzatore con un disinfettante regolarmente registrato. NB. Non ho ulteriori informazioni sui consumi e il montante ore.
CONCLUDENDO
Al termine delle operazioni descritte la Direzione ha preteso primo una dichiarazione formale che garantisse che le operazioni fossero state eseguite a regola d’arte e, secondo, che una circostanziata ispezione effettuata in contraddittorio fra il referente

della ditta appaltatrice e il supervisore aziendale, dichiarasse l’avvenuta eradicazione dalle blattelle.
Dopo di che si è proceduto allo sgombero del materiale e alle pulizie edili. Una nota positiva è stata che al termine di dette operazioni non sono state osservate blattelle girovaganti a dimostrazione che i trattamenti erano stati effettuati in modo professional-
mente corretto e che i disciplinari avevano indicato linee guida efficaci. Per quanto mi è dato sapere nessun altro lavoro di ristrutturazione è in atto. Aggiungo che sono rimasto positivamente stupito delle richieste effettuate da un geometra (tale era la scolarità del coordinatore aziendale dei servizi) fossero così circostanziate e concrete.
For the dispensing equipment, the choice was towards battery-powered sprayers equipped with a lance with an adjustable fan-shaped dispensing nozzle so as to be able to adjust the insecticide suspension to different micronizations and the advantage of being able to use a single piece of equipment.
The application method consisted of a centripetal intervention, i.e. from the external perimeter towards the center, treating the floor and walls with the nozzle adjusted halfway so as to be able to "wet well" avoiding drips as much as possible.
The disused material and equipment were micro-sprayed by giving an additional turn to the nozzle ring with the aim of having the maximum coverage possible.
For the electrical system ducts, however, the nozzle was opened to the maximum to have the jet as narrow as possible and the maximum dispensing distance allowed by the equipment.
NB: there was no electrical current flowing. For the finishing operations, the nozzle was closed to the maximum in order to be able to deliver a coarse mist.
Consumption was just under 90 L at 1% concentration (horizontal surfaces + delivery into the ambient air + material to be disposed of + some points to be reviewed) equal to one liter of commercial formulation.
The rooms remained closed for just over 75 hours.
The total hours were 6 hours for a technician and at the same time 6 hours for a general operator.
Disinfection operations
Upon reopening, disinfection was carried out using a nebulizer with a regularly registered disinfectant.
NB. I have no further information on consumption and hours.
In conclusion
At the end of the operations described, the Management first demanded a formal declaration guaranteeing that the operations had been carried out in a workmanlike manner and, secondly, that a detailed inspection carried out jointly between the contact person of the contracting company and the company supervisor, declared the eradication of cockroaches has occurred. After which the material was removed and the building was cleaned. A positive note was that at the end of these operations no wandering cockroaches were observed, demonstrating that the treatments had been carried out in a professionally correct manner and that the regulations had indicated effective guidelines. As far as I know, no other renovation work is underway. I would add that I was positively amazed that the requests made by a surveyor (such was the education of the company services coordinator) were so detailed and concrete.
S•46 DIMENSIONE PULITO | 04/2024 IGIENE ALIMENTARE
DISINFESTAZIONE
I nnovative automatic spray can insecticide

NEW FORMULA with pure Pyrethrins, Geraniol, and MGK® -264
NUOVA FORMULA con Piretrine pure, Geraniolo ed MGK® -264



EFFECTIVE AGAINST FLIES, MOSQUITOES AND FOOD PESTS
EFFICACIA SU MOSCHE, ZANZARE E INSETTI DELLE DERRATE
VEGETAL ORIGIN ORIGINE VEGETALE FOR FOOD INDUSTRY SPECIFICO

PER INDUSTRIA ALIMENTARE
Medical Device with insecticidal action, use with caution. Always read the label and product information before use. Attention is drawn to the hazard warnings and symbols on the label. The text in the specifications corresponds to the label approved by the Ministry of Health. È un Presidio Medico Chirurgico ad azione insetticida, usare con cautela. Prima dell’uso leggere sempre l’etichetta e le informazioni sul prodotto. Si richiama l’attenzione sulle frasi e sui simboli di pericolo riportati in etichetta. DISCOVER MORE
L’ innovazione nell’erogazione automatica Since 2006 with www.copyr.eu
Vebi Tech. DK Extreme l’evoluzione
della microincapsulazione
spersibilità del prodotto, la -
sule è di origine vegetale,
La formulazione, inoltre, di-
fatici, aromatici e clorurati, tutte caratteristiche che rendono il nuovo prodotto una soluzione per la lotta
stro laboratorio R&D e che si sposa con il percorso di -
è adatto per il controllo di insetti volanti e striscianti che comunemente

La Divisione Vebi Tech si rivolge alle aziende e ai professionisti della disinfestazione, offrendo un’ampia gamma di prodotti e soluzioni con molteplici tipi di formulazioni e principi attivi per la lotta a roditori e insetti nocivi. Inoltre, l’assortimento si completa con diserbanti, repellenti, disinfettanti, lampade a luce U.V., attrezzature per la sanificazione e soluzioni naturali per la cura del verde. Ricerca continua, investimenti in innovazione e miglioramento costante: sono gli elementi che contraddistinguono il dipartimento Ricerca e Sviluppo di Vebi Tech. La Divisione vanta una profonda conoscenza del settore, frutto del lavoro di tecnici esperti, speri-
mentazione sul campo e in laboratorio, sinergie di idee in collaborazione con professionisti, enti accreditati, clienti, fornitori e Università.
Vebi Tech garantisce attività di consulenza, formazione e supporto agli operatori del settore e alle aziende, attraverso corsi pensati ad hoc per soddisfare le esigenze specifiche del cliente. Infatti, l’obiettivo è affiancare i nostri clienti nell’individuazione del problema, analizzandone ogni aspetto per un intervento mirato, radicale ed efficace.
Oggi le moderne aziende di disinfestazione scelgono attentamente i prodotti, valutano l’efficacia nell’ambito di interesse, per il preciso target e sono attenti alle caratteristiche tecniche che devono
essere sempre più orientate alla salvaguardia dell’ambiente e delle persone.
Dal laboratorio R&D di Vebi Tech nasce DK Extreme, insetticida concentrato microincapsulato ad ampio spettro d’azione.
Il prodotto si inserisce all’interno della linea DK ovvero la gamma di insetticidi in formulazione microincapsulata studiata dall’azienda che garantisce una doppia azione: l’effetto immediato, abbattente ottenuto dal principio attivo libero e l’effetto residuale, duraturo nel tempo grazie al graduale rilascio dello stesso contenuto nelle microcapsule.
DK Extreme è un’evoluzione dello storico DK 10.2: la microincapsulazione è innovativa, la struttura è a “guscio

infestano gli ambienti civili, domestici, industriali, ambienti zootecnici e aree verdi. È efficace per il trattamento contro: zanzare comuni e zanzara tigre, vespe, mosche, mosca cavallina, blatte, formiche, pulce e zecca.
Le caratteristiche fisico-chimiche del formulato rendono possibile l’utilizzo con qualsiasi tipologia di attrezzatura compresi i nebulizzatori ULV (solo in ambienti interni) e termonebbiogeni.
DK Extreme elimina gli insetti presenti al momento del trattamento e previene l’insorgere di successive infestazioni fino a 2 settimane.
Vebi Tech | YOUR BEST PARTNER IN PROFESSIONAL SOLUTIONS

-
-
vebitech.it informazione pubblicitaria

Filiera alimentare a 360° e il controllo dei roditori
Nell’affrontare e risolvere al meglio i problemi della lotta ai parassiti nella filiera alimentare un suggerimento di semplificare le cose, definire gli obiettivi e chiarire i tempi e le modalità di realizzazione potrebbe essere d’aiuto
Graziano Dassi

L’obiettivo che mi prefiggo deriva da una giovanile esperienza sportiva: dovevo insegnare a dei bambini a nuotare. Premetto che mi avevano "rifilato" quelli che avevano paura dell’acqua. In quei lontani tempi lo stile natatorio di riferimento
era quello a rana. Dopo due lezioni mi sono scoraggiato: i ragazzini erano un disastro e fra i motivi c’era anche quello che io stesso non amavo e non sapevo neppure nuotare bene a rana. Che fare? Un papà dei miei discepoli mi disse: “Ma li faccia giocare, a me
interessa che sappiano stare a galla, non devono diventare dei campioni”. Una affermazione ovvia e piena di buon senso per cui tutti a giocare e poi tutti attaccati al bordo a fare le bollicine. Ovvero, prendere fiato poi immergere la faccina in acqua e sof-
S•50 DIMENSIONE PULITO | 04/2024 IGIENE ALIMENTARE
DISINFESTAZIONE

fiare fuori il fiato facendo le bollicine; poi tirare fuori la testolina respirare e, pronti via, fare di nuovo le bollicine.
Alla fine delle dieci sedute tutti stavano a galla interpretando in modo assai fantasioso uno stile libero, soprattutto libero. E tutti si sentivano dei piccoli Tarzan.
Probabilmente la premessa è fuori tema, ma volevo solo sottolineare che nell’affrontare e risolvere al meglio i problemi della lotta ai parassiti nella
filiera alimentare un suggerimento di semplificare le cose, definire gli obiettivi e chiarire i tempi e le modalità di realizzazione potrebbe essere d’aiuto. Lo slogan dell’esposizione sarà: “Sarò breve, fin dall’età della pietra…” Per iniziare un breve excursus sulla produzione mondiale di alcune derrate, tanto per avere un’idea delle dimensioni in cui ci muoviamo. Poi un esempio di lotta mirata in viticultura. E, tanto per semplificare l’esposizione, un rapido
sguardo ai messaggini e alle informazioni che transitano in internet in un giorno e di come le traduce in informazioni (e denaro); per poi proporre un metodo per redigere un disciplinare tecnico-operativo di derattizzazione.
EXCURSUS SULLA PRODUZIONE MONDIALE DI ALCUNE DERRATE
Per quanto riguarda la produzione mondiale di riso, secondo le ultime stime della FAO nel 2022 la produzione mondiale di riso è diminuita del 2,4%, passando a 772,3 milioni di tonnellate (512,8 milioni di tonnellate su base lavorata) dai 791,6 milioni di tonnellate del 2021.
Ad agosto, l'International Grain Council (IGC), che riunisce i principali Paesi importatori ed esportatori del mondo, ha previsto una produzione mondiale di grano di 784 milioni di tonnellate nel 2023-24, in leggero calo del 2,4% rispetto all'anno precedente.
I volumi globali di nocciole ammontano invece a 1.230.128 tonnellate, in linea con le stime precedenti e meglio del raccolto 2021/22, pari a 1.165.150 ton.
Considerazioni:
L’obiettivo è produrre questi volumi nel rispetto dell’ambiente e in modo







ALL-AROUND FOOD SUPPLY CHAIN AND RODENT CONTROL
In addressing and best solving the problems of pest control in the food chain, it is useful to define the objectives and clarify the timeframe and manner of implementation
The goal I aim to achieve through this article comes from a youthful sporting experience: I had to teach some children to swim. Let me start by saying that those who were afraid of water had "foisted" me. In those distant times the reference swimming style was breaststroke. After two lessons I got discouraged: the kids were a disaster and among the reasons there was also that I didn't like them myself and I didn't even know how to swim breaststroke well. What to do? One of my disciples' father told me: "But let them play, I'm interested in them knowing how to stay afloat, they don't
have to become champions." An obvious statement full of common sense whereby everyone plays and then everyone sticks to the edge to make bubbles. That is, take a breath then immerse the face in water and blow out the breath making bubbles; then pull out the little head, breathe and, ready to go, make bubbles again. At the end of the ten sessions everyone was afloat interpreting a freestyle, especially free, in a very imaginative way. And everyone felt like little Tarzans.
The premise is probably off topic, but I just wanted to underline that in addressing and solving the problems of fighting parasites in the food supply chain as best as possible, a suggestion to simplify things, define the objectives and clarify the times and methods of implementation could be useful.
The slogan of the exhibition will be: "I will be brief, since the Stone Age..." To begin, a brief excursus on the global production of some foodstuffs, just to get an idea of the dimensions in which we move. Then an example of targeted struggle in viticulture. And, just to simplify the exposition, a quick look at the messages and information that pass through the internet in a day and how it translates them into information (and money); to then propose a method for drawing up a technical-operational rodent control specification.
Overview on the world production of some foodstuffs
As regards world rice production, according to the latest FAO estimates, in 2022 world rice production decreased by 2.4%, to 772.3 million
S•51 DIMENSIONE PULITO | 04/2024
sostenibile. La domanda è come e in quanto tempo. È la stessa domanda che ogni industria della filiera alimentare dovrebbe porsi nel dialogare con le ditte di servizio.
UN ESEMPIO DI LOTTA MIRATA
IN VITICULTURA
È innegabile che fra la difesa fitosanitaria in agricoltura e nel mondo della disinfestazione vi siano non poche analogie, fra cui la lotta mirata. Fra le tante fantascientifiche applicazioni tecnologiche che stanno prendendo piede in viticoltura vi è quella dei droni erogatori di fitofarmaci. Detta così la notizia potrebbe non suscitare tanta meraviglia, ma il drone è munito di un sistema che visualizza i filari e le singole piante di vite e tratta solo quelle malate. La qual cosa è sicuramente degna di strappare un applauso.
Considerazioni:
Ora mi immagino dei droni che svolazzano in un capannoni spaventando i piccioni al pari delle poiane di una poiana di Harris (Parabuteo unicinctus) oppure a monitorare qualche roditore in cerca di cibo, oppure a ispezionare qualche punto critico in cerca
di tignole o qualche Oryzaephilus.
UN RAPIDO SGUARDO
ALLE INFORMAZIONI
CHE TRANSITANO IN INTERNET IN 60 SECONDI
I ricercatori hanno scoperto che in un minuto su internet avvengono acquisti tramite e-commerce per una cifra che supera i 900mila dollari. I messaggi scambiati su WhatsApp nello stesso lasso di tempo sfiorano i 38 milioni, le mail invece svettano a quota 187 milioni al minuto, più bassi gli sms che però si difendono con un ottimo 18 milioni di scambi in 60 secondi. Nell'ambito dei social network, in un minuto, Facebook conta 973mila login, Twitter 481mila tweet e Snapchat fa registrare la notevole cifra di 2,4 milioni di video pubblicati.
Quello che più mi impressiona è come questa immensa mole di dati venga elaborata e tradotta in informazioni che dal punto di vista economico abbiano un valore tanto alto da creare imperi come quello di Google (ed è solo un esempio). Ma ho scoperto che per tradurre i dati in un valore misurabile in dollari o in euro il segreto è
la capacità di selezionare e correlare i dati in modo da diventare un efficace strumento di strategie commerciali. I dati in sé da soli non avrebbero nessun pratico valore!
Considerazioni:
In una scala assai più limitata di dati, ma comunque importante, mi è accaduto in alcune grandi aziende alimentari dove i report di monitoraggio avrebbero richiesto molte ore per essere lette, elaborate e tradotte in aggiornamento alle azioni di disinfestazione. Mi pare quindi opportuno porre l’attenzione al fatto che non sono i dati rilevati (che in ogni caso devono essere esatti), ma nella capacità di modificare gli interventi rendendoli uno strumento di miglioramento dei servizi. Tanto più necessari alla luce delle nuove norme che regolamentano la lotta ai roditori.
DISCIPLINARE TECNICO-OPERATIVO DI DERATTIZZAZIONE E CRITERI PROGETTUALI
Valutazioni preliminari atte a definire i criteri progettuali (non prendo in esame la o le specie di roditori presenti,
tonnes (512.8 million tonnes on a processed basis) from 791.6 million tons in 2021.
In August, the International Grain Council (IGC), which brings together the world's main importing and exporting countries, forecast global wheat production of 784 million tonnes in 2023-24, down slightly by 2.4% compared to last year. Global volumes of hazelnuts amounted to 1,230,128 tonnes, in line with previous estimates and better than the 2021/22 harvest, equal to 1,165,150 tonnes.
Observations: The goal is to produce these volumes respecting the environment. The question is how and in how long. It is the same question that every industry in the food supply chain should ask itself when communicating with service companies.
An example of targeted struggle in viticulture
It is undeniable that there are many similarities between phytosanitary defense in agriculture and in the world of disinfestation, including
targeted control. Among the many science fiction technological applications that are taking hold in viticulture is that of drones dispensing pesticides. Put like this, the news may not cause much surprise, but the drone is equipped with a system that displays the rows and individual vine plants and treats only the diseased ones. Which is definitely worthy of a round of applause.
Observations: Now I imagine drones fluttering in a shed, scaring pigeons like a Harris's buzzard (Parabuteo unicinctus), or monitoring some rodent in search of food, or inspecting some critical point in search of moths or some Oryzaephilus.
A look at the information that travels across the internet
Researchers have discovered that in one minute online purchases are made via e-commerce for a sum exceeding 900 thousand dollars. Messages exchanged on WhatsApp in the same period of time are close to 38 million, while
emails stand out at 187 million per minute, while text messages are lower but defend themselves with an excellent 18 million exchanges in 60 seconds. In the context of social networks, in one minute, Facebook has 973 thousand logins, Twitter 481 thousand tweets and Snapchat records the remarkable figure of 2.4 million videos published. What impresses me most is how this immense amount of data is processed and translated into information that from an economic point of view has such a high value as to create empires like that of Google (and this is just one example). But I discovered that to translate the data into a measurable value in dollars or euros, the secret is the ability to select and correlate the data in such a way as to become an effective tool for commercial strategies. The data itself would have no practical value!
Observations: On a much more limited scale of data, but still important, it happened to me in some large food companies where the moni-
S•52 DIMENSIONE PULITO | 04/2024 IGIENE ALIMENTARE
DISINFESTAZIONE
dando per note le diverse tecniche operative):
1) Valutare l’infestazione in atto e la pressione di infestazione in atto.
2) L’obiettivo è valutare se ci sono gli estremi per una derattizzazione in continuo (permanent baiting).
NB. Nella relazione sarebbe utile specificare se le condizioni “di alto rischio” sono eliminabili e se SI fare una previsione del tempo necessario. In ogni caso la relazione dovrebbe essere rinnovata anno per anno.
3) Se le condizioni di derattizzazione in continuo sono ravvisate resta la buona pratica di eliminare i punti esca non soggetti a consumo purché le ispezioni confermino la non presenza di roditori. Naturalmente se il non consumo coincide con una presenza murina la prima cosa da fare è cambiare l’esca per valutare che non sia un problema di appetibilità; oppure passare a un'altra tecnica come le trappole a cattura multipla o tagliole.
4) Se le condizioni ambientali sono coerenti con le pratiche di derattizzazione a tempo determinato si procede secondo le indicazioni riportate in etichetta integrate con le buone prati-

che che l’ars disinfestandi suggerisce. Le linee guida del disciplinare deve indicare (dando per scontata l’ottemperanza delle norme cogenti e di quelle volontarie se ve ne sono):
A) Le reciproche responsabilità nello spirito di darsi una mano e non di mettere davanti le mani.
B) Gli obiettivi che ci si propone e i tempi di realizzazione.
C) I criteri di valutazione dei risultati.
D) Il periodo di tempo massimo che deve trascorrere fra un aggiornamento e l’altro.
Nel punto A) riporterei anche come l’Azienda e la Ditta di servizio intendono collaborare nella logica della prevenzione e della manutenzione anti-intrusione.
UNA PRECISAZIONE
La realizzazione di un programma di derattizzazione deve essere economico, la qual cosa non significa “regalata”. La Qualità ha un prezzo ed entrambe le parti ne devono essere consapevoli. Sottolineo che quanto affermato è valido per ogni tipo di attività.
toring reports would have required many hours to be read, processed and translated into updates for disinfestation actions. It therefore seems appropriate to me to pay attention to the fact that it is not the data collected (which in any case must be accurate), but the ability to modify interventions, making them a tool for improving services. All the more necessary in light of the new rules regulating the fight against rodents.
Technical-operational regulations for rodent control and design criteria
Preliminary assessments aimed at defining the design criteria (I do not examine the species of rodents present, taking the different operational techniques as known):
1) Evaluate the current infestation and the current infestation pressure.
2) The objective is to evaluate whether there are conditions for continuous rodent control (permanent baiting).
NB: In the report it would be useful to specify whether the "high risk" conditions can be eliminated and if YES to make a forecast of the time necessary. In any case the relationship should be renewed year by year.
3) If continuous rodent control conditions are identified, it remains good practice to eliminate bait points not subject to consumption as long as inspections confirm the non-presence of rodents. Naturally, if non-consumption coincides with a murine presence, the first thing to do is to change the bait to assess whether it is not a palatability problem; or switch to another technique such as multi-catch traps or leghold traps.
4) If the environmental conditions are consistent with the fixed-term rodent control practices, proceed according to the indications on the label integrated with the good practices that a correct pest control suggests.
The guidelines of the specification must indicate (taking for granted compliance with the mandatory and voluntary regulations if there are any):
A) Mutual responsibilities in the spirit of helping each other and not giving up.
B) The objectives set and the timescales for implementation.
C) The criteria for evaluating the results. The maximum period of time that must pass between one update and another.
In point A) I would also report how the Company and the service company intend to collaborate in the logic of anti-intrusion prevention and maintenance.
A clarification
The implementation of a rodent control program must be economical, which does not mean "given away". Quality has a price and both parties must be aware of this. I underline that what has been stated is valid for every type of activity.
S•53 DIMENSIONE PULITO | 04/2024

I metodi della soppressione Animal Welfare. Elettrocuzione e anidride carbonica

Come è ben noto a tutti i professionisti del Pest Management, la gestione dei roditori sinantropici è imprescindibile al fine di garantire, sia a livello territoriale e comprensoriale pubblico, sia in ambito produttivo e abitativo, condizioni di igiene e sicurezza idonee agli esseri umani e agli animali non target. Nel corso degli anni i sistemi e i prodotti impiegati per il controllo dei roditori sono stati molteplici, passando dal trappolaggio all’impiego di sostanze chimiche. Gli anticoagulanti di seconda generazione hanno avuto negli ultimi 50 anni un primato assoluto, tuttora detenuto, sebbene siano considera-
ti estremamente pericolosi e dannosi per l’ambiente e gli animali non target e influiscano negativamente sul benessere animale.
È nata così nel tempo la necessità di progettare nuovi dispositivi che, pur garantendo un elevato livello di efficacia, sopprimessero topi e ratti nella maniera più rapida e indolore possibile.
A testimonianza di come per le autorità europee la via intrapresa ai fini della gestione del controllo dei roditori sia sempre più orientata ad un uso di sistemi non-chimici, nel 2018, con l’obiettivo di ridurre l’uso delle sostanze biocide e valutare l’impatto sul benessere animale dei dispositivi alternativi di
controllo per roditori esistenti sul mercato, nasce il gruppo di lavoro NoCheRo, Non-Chemical alternatives for Rodent Control.
E così che, al fianco e come alternativa alle classiche spezzacollo a molla, sono stati introdotti sul mercato nuovi dispositivi e metodiche di soppressione in grado di rispondere all’esigenza di tutelare il benessere animale: sia le trappole ad elettrocuzione che quelle ad anidride carbonica, nascono proprio per rispondere a questo bisogno. Le trappole ad elettrocuzione mirano a completare un ciclo di cattura/soppressione in un arco di tempo non superiore ai 2 minu-
The methods of Animal Welfare suppression. Electrocution and carbon dioxide
Over the years, the systems and products used for rodent control have been numerous, ranging from trapping to the use of chemical substances. Second-generation anticoagulants have had an absolute primacy in the last 50 years, still held, although they are considered extremely dangerous and harmful to the environment and non-target animals, negatively impacting animal welfare. Designing new devices that, while ensuring a high level of effectiveness, suppressed mice and rats in the quickest and most painless way possible, respon-
ded to an increasingly strong need to protect animal welfare. This is how, alongside and as an alternative to the classic spring neckbreakers, electrocution and carbon dioxide traps were introduced onto the market. There are various electrocution trapping systems on the market or those that exploit the biocidal action of carbon dioxide but none of these systems allows multiple captures, which in the case of severe infestations is crucial for rodent control to be carried out effectively. To overcome this problem, Ekommerce has developed and
presented two new versions of Ekomille to the Pest Management market: the CO2 and Z versions. Ekomille Z is equipped with an electrocution suppression system. Thanks to the presence of four “suppression chambers” and a impeller, with which the system is integrated, the mouse or rat, once suppressed, is transferred to the lower tank, leaving the machine free from obstructions and ready to make a new capture. Ekomille CO2 is currently the only system that integrates a carbon dioxide delivery mechanism for the painless suppression of mice
and rats. It has obtained biocidal registration for the control of the black rat and is being extended on the label for the gray rat and house mouse. The system is highly efficient as it delivers carbon dioxide directly into the capture tank, suppressing rodents in an extremely short time frame: approximately 12-15 seconds for mice and 20-35 seconds for rats. The speed and guarantee of effectiveness make Ekomille CO2 the fastest and most reliable system for the suppression of mice and rats currently present throughout the world.
informazione pubblicitaria

ti, sfruttando una scarica elettrica ad alto voltaggio (circa 9.000 V) e basso amperaggio. L’infestante, investito dal passaggio di energia elettrica subisce una paralisi della funzione muscolare, che ne impedisce la fuga. Le scosse si susseguono fino a provocare un arresto cardiaco con conseguente morte del roditore. Sul mercato sono disponibili
dispositivi ad elettrocuzione sia per topi che per ratti. Tuttavia spesso e volentieri, soprattutto le trappole ad elettrocuzione per ratti non consentono catture multiple rendendo necessaria la rimozione delle carcasse dopo ogni singola cattura. Per ovviare alle problematiche descritte e proprie delle classiche trappole ad elettrocuzione Ekommerce ha sviluppato e presentato al mercato del Pest Management un upgrade di Ekomille. Ekomille Z - questo il nome dell’ultimo modello della nostra linea di dispositivi per la cattura multipla di roditori sinantropici – è integrato di un sistema di soppressione ad elettrocuzione. Grazie alla presenza di quattro “camere di sop-
pressione” e di una girante, di cui il sistema è integrato, il topo o il ratto non appena soppresso, viene trasferito nel serbatoio inferiore, lasciando la macchina libera da ingombri e pronta ad effettuare una nuova cattura. A proposito delle trappole ad anidride carbonica nel panorama mondiale esistono solo due prodotti che ne sfruttano l’azione tossica per inalazione quale sistema di soppressione. Il primo, ad uso esclusivo di una grande multinazionale del Pest Management, impiega la CO2 per la soppressione di topi ma consente solo catture singole. La versione CO2 di Ekomille, nata quale completamento della linea animal friendly, è attualmente l’u-
nico sistema che integra un meccanismo di erogazione di anidride carbonica per la soppressione indolore di topi e ratti. Ha ottenuto la registrazione biocida per il controllo del ratto nero ed è in fase di estensione in etichetta per ratto grigio e topo domestico. Il sistema è altamente efficiente poiché eroga l’anidride carbonica direttamente nel serbatoio di cattura, sopprimendo i roditori in un arco di tempo estremamente breve, circa 12-15 secondi per i topi e 20-35 secondi per i ratti. La velocità e la garanzia di efficacia rendono Ekomille CO2 il sistema più veloce e affidabile per la soppressione di topi e ratti attualmente presente in tutto il panorama mondiale.

ekommerce.it
Ottimizzare i costi di derattizzazione Un caso di studio
La sostituzione dell’esca e una ripianificazione degli interventi ha consentito di azzerare i danni derivanti dall’azione dei roditori e dimezzare il costo complessivo del prodotto utilizzato
Francesco Gullo


S•56 DIMENSIONE PULITO | 04/2024 IGIENE ALIMENTARE
DISINFESTAZIONE
Il caso di studio presentato in questo articolo è relativo ad un hub satellite di una piattaforma alimentare ubicata in centro Italia. Poiché dal sito principale i vettori trasportano derrate alimentari (a base di farina) presumibilmente infestate da roditori appartenenti alla specie Rattus norvegicus, nei siti satelliti si verificano danni variabili a seconda delle annate sia sulle strutture sia sugli alimenti. Nel 2022 i consumi di esca anticoagulante sono stati rilevati a gennaio e a dicembre, ed erano bassi. Nonostante la bassa popolazione murina apparentemente sotto controllo, sono stati tuttavia osservati danni sia sulle infrastrutture, sia sugli alimenti specialmente quelli in transito dalla piattaforma principale (a base di farina) in trasferimento. Danni accettabili da un punto di vista di valutazione del rischio, ma che hanno indotto l’impresa addetta alla derattizzazione e la proprietà ad alzare il livello di guardia ed adottare soluzioni innovative. Nel 2023 il piano di derattizzazione ha visto la sostituzione dell’esca anticoagulante (Bromadiolone) con Selontra e una ripianificazione degli interventi con l’obiettivo di ridurre i danni diret-
ti ed indiretti. Il programma di derattizzazione ha previsto l’abbinamento delle esche chimiche a trappole multicattura (modello Tin Cat) usate anche nel 2022. Nelle aree interne sono state utilizzate 132 trappole multicattura, posizionate nei percorsi di passaggio dei roditori e in prossimità delle fonti alimentari facilmente aggredibili. Il controllo esterno invece è stato gestito con 74 contenitori porta esche riforniti con 120 grammi di Selontra assicurati al contenitore grazie al foro centrale presente nel blocco stesso. I contenitori sono stati posizionati in modo da creare una barriera nel perimetro esterno e una zona di protezione ulteriore nel reparto stoccaggio delle derrate in transito all’ingresso dell’edificio.
La scelta di Selontra è stata fatta per diverse ragioni:
• riduzione dei quantitativi di prodotto per il controllo della popolazione;
• l’appetibilità del prodotto osservata in precedenti impieghi effettuati dall’impresa di disinfestazione;
• la velocità di azione del Colecalciferolo, permessa dal suo meccanismo d’azione che induce ipercalcemia che genera inappetenza e mortalità in brevissimo tempo;
• la possibilità di adottare la tecnica del permanent baiting, che con Selontra è possibile qualora l’impresa disinfestatrice valuti un alto rischio di infestazione. L’azienda è stata monitorata continuamente da gennaio a dicembre 2023, con controlli sistematici al fine di valutare i consumi di esca e le catture (operazione analoga è stata condotta nel 2022). I risultati sono stati molto interessanti in quanto all’interno dello stabilimento non sono stati osservati né danni, né segni di presenza di roditori peraltro confermati dalle trappole che non hanno catturato nessun muride. Anche all’esterno dello stabilimento nella zona di transito delle derrate non sono stati osservati danni agli alimenti né alla struttura come invece successo nel 2022. A differenza dell’anno precedente quando pochissimi contenitori furono visitati dai roditori e il consumo di esca era pressoché nullo, nel 2023, Il 25% dei contenitori ha registrato (vedi foto) pasturazione con consumi di esca principalmente nei mesi di aprile (con consumo moderato), agosto (con consumo moderato) e tra novembre e dicembre (con consumo elevato). I consumi maggiori sono stati rilevati nelle aree più esterne







OPTIMIZING DERATIZATION COSTS: A CASE STUDY
The case study presented in this article is about a satellite hub of a food platform located in central Italy. As carriers transport foodstuffs (flour-based) presumably infested with rodents belonging to the species Rattus norvegicus from the main site to the satellite sites, variable damage occurs depending on the year on both structures and foodstuffs. In 2022, the consumption of anticoagulant bait was recorded in January and December and was low. Despite the low murine population seemingly under control, damage was nevertheless observed on both infrastructure and food, especially those in transit from the main (flour-based) transfer platform. Damage that was acceptable from a risk assessment point of view, but prompted the deratization company and the property to raise the guard level and adopt innovative solutions.
In 2023, the deratization plan saw the replacement of anticoagulant bait (Bromadiolone) with Selontra and a re-planning of interventions with the aim of reducing direct and indirect damage. The deratization program included the combination of chemical baits with multi-catch traps (Tin Cat model) also used in 2022. In indoor areas, 132 multi capture traps were used, placed in rodent passage routes and near easily attacked food sources. External control, on the other hand, was managed with 74 bait containers stocked with 120 grams of Selontra secured to the container by the central hole in the block itself. The containers were positioned in such a way as to create a barrier in the outer perimeter and an additional protection zone in the food storage area in transit at the building entrance.
Selontra was chosen for several reasons: - reduction of product quantities for population control;
- the palatability of the product observed in previous uses made by the pest control company;
- the speed of action of Cholecalciferol, allowed by its mechanism of action that induces hypercalcemia generating inappetence and mortality in a very short time;
- the possibility of adopting the permanent baiting technique, which is possible with Selontra if the pest control company assesses a high risk of infestation.
The site was continuously monitored from January to December 2023, with systematic checks in order to assess bait consumption and
S•57 DIMENSIONE PULITO | 04/2024
e più lontane dallo stabilimento. L’aumento dei consumi nel 2023 è legato a due fattori, da un lato l’aumento della popolazione autoctona, per effetto della presenza di incolti e rifiuti in aree limitrofe all’impianto ma anche ai vettori che trasportano con gli alimenti i ratti da una piattaforma all’altra. Ciò significa che sia la barriera protettiva esterna sia le postazioni nell'area di transito degli alimenti hanno contribuito al controllo perfetto della popolazione, e che Selontra ha permesso di azzerare i danni. Nonostante la maggiore pasturazione il quantitativo di prodotto utilizzato è stato molto inferiore all’esca anticoagulante utilizzata negli anni precedenti, grazie alla riduzione dello smaltimento dell'esca non consumata dopo 35 gg di intervento, con un costo complessivo del prodotto dimezzato ed un risultato migliore non avendo rilevato nessun danno. Il raggiungimento degli obiettivi prefissati dunque permette di concludere che con il prodotto utilizzato si è ottenuto il risultato atteso in termini di riduzione dei danni, ottimizzando allo stesso tempo i costi. Tutto ciò è stato possibile grazie al presidio qualificato del personale dell’impresa di disinfestazione che ha indotto l’azienda ad

estendere l’impiego di Selontra a tutti i siti lavorativi.
L’IMPRESA
Romana Ambiente S.r.l. è un’impresa di Pest Control (derattizzazione, disinfestazione, allontanamento volatili, trasporto rifiuti pericolosi, disinfezione e sanificazione) che opera da decenni nel mercato nazionale. I suoi principali clienti appartengono a Industrie Farmaceutiche, Industrie Alimentari, Strutture Ospedaliere, Allevamenti, Grande Distribuzione Organizzata, Facility Ma-
nagement e Enti Pubblici e Privati. La politica della Società è sempre stata quella di garantire al cliente una fornitura "full service" dei servizi, al tempo stesso è sempre stata impegnata nell’introduzione di nuove tecnologie e nuovi prodotti al fine di aumentare l’efficienza gestionale, operativa e la qualità dei servizi prestati. Romana Ambiente possiede numerose certificazioni, è socio AIDPI (Associazione Imprese di Disinfestazione Professionali Italiane) ed è iscritta all’Albo Nazionale Gestori Ambientali in diverse categorie.
captures (similar operation was conducted in 2022). The results were very interesting in that neither damage nor signs of rodent presence were observed inside the plant, also confirmed by the traps that did not capture any murids. Even outside the plant in the transit area of the foodstuffs, no damage to food or structure was observed as was the case in 2022. In contrast to the previous year when very few containers were visited by rodents and bait consumption was almost zero, in 2023, 25% of the containers recorded pasturing with bait consumption mainly in April (with moderate consumption), August (with moderate consumption) and between November and December (with high consumption). The highest consumption was found in the areas outermost and furthest from the plant.
The increase in consumption in 2023 is related to two factors, on the one hand, the increase in the native population, due to the presence
of uncultivated land and garbage in areas surrounding the plant but also to the vectors that transport rats with food from one platform to another. This means that both the outer protective barrier and the stations in the food transit area contributed to perfect population control, and Selontra allowed zero damage. Despite the increased baiting the amount of product used was much less than the anticoagulant bait used in previous years, with an overall cost of the product halved and a better result as no damage was detected. The achievement of the set goals therefore allows us to conclude that with the product used, the expected result in terms of damage reduction was achieved while optimizing costs. All this was possible thanks to the qualified manning of the pest control company's staff, which led the company to extend the use of Selontra to all work sites.
About the company which performed the ser-
vice: Romana Ambiente S.r.l. is a Pest Control company (pest control, bird removal, hazardous waste transport, disinfection and sanitization services) that has been operating in the national market for decades. Its main clients belong to Pharmaceutical Industries, Food Industries, Hospital Facilities, Livestock Farms, Large Scale Retail, Facility Management, and Public and Private Entities.
The Company's policy has always been to guarantee the customer a "full service" supply of services, at the same time it has always been committed to the introduction of new technologies and new products in order to increase management and operational efficiency and the quality of the services provided. Romana Ambiente holds numerous certifications, is a member of AIDPI (Association of Italian Professional Pest Control Companies) and is registered with the National Register of Environmental Managers in several categories.
S•58 DIMENSIONE PULITO | 04/2024 IGIENE ALIMENTARE
DISINFESTAZIONE



Il 9 e 10 ottobre 2024 i massimi protagonisti di un settore in rapida evoluzione - professionisti, aziende e stakeholder - sotto la spinta dell’innovazione digitale, del green e delle tecnologie 4.0 si incontreranno per un confronto aperto e stimolante sulle principali sfide che attendono il mondo del Professional Cleaning
per sponsorizzare dircom@quine.it Organizzato da ISCRIVITI GRATUITAMENTE WWW.CLEANINGPIU.IT IL CONVEGNO
PULITO PROFESSIONALE
THE NEW DATE
OTTOBRE 2024 TORN A IL CONV EGNO DIGI IL CONV EGNO
PULITO PROFE
SION ALE SAVE THE DATE 18 - 19 SE TTEMBRE 2024
TORNA IL CONVEGNO DIGITALE DEDICATO ALLA CULTURA DEL PULITO
SUL
SAVE
9 - 10
SUL
S

THERE IS NOTHING LIKE ECONATURAL
EcoNatural is the result of an ambitious project to recover and transform the various components of beverage cartons into paper and dispensers. Lucart’s virtuous and fully certified process contributes to the complete circular recycling of these materials, transforming them into new secondary raw materials for its EcoNatural line products.
ND LIFE OF
Recycling waste
BEVERAGECARTONS
Beverage
Transformation
THE MOST COMPLETE PAPER+DISPENSER RANGE FROM BEVERAGE CARTONS








Sustainability Report 2023 considering 1L beve rage cartons
*Source: Lucart
Cellulose Fibres
Aluminium Polyethylene
process
EcoNatural Paper EcoNatural Dispenser
cartons
FULL RANGE AVAILABLE IN BLACK & WHITE
A T URALFL WDISPENSER

THE ONE & ONLY FROM BEVERAGE CARTONS

108 beverage cartons recycled to produce one dispenser.* A complete range in black and white Fully recyclable and certified NEW PATENTED DESIGN






NEW
NOCE
*EcoNatural Flow Folded Hand towel dispenser, considering 1L be verage cartons
THE REAL CIRCULAR SYSTEM

NEW PATENTED DESIGN
New life for beverage cartons.
EcoNatural is an eco-friendly PAPER+DISPENSER system, a fully certified and concrete example of the circular economy. Lucart Professional gives new life to beverage carton components: it uses Fiberpack® produced from the cellulose fibres to make paper, and the aluminium and polyethylene to produce Al.Pe.®, the recycled raw material from which dispensers are made.
BILLIONS of beverage cartons recovered.
1 Source: Lucart Sustainability Report, 2013-2023, considering 1L beverage cartons.
BOOTH 12.301
1 10.7
ECONATURAL.














































 Soluzioni d’igiene e di protezione professionale
Soluzioni d’igiene e di protezione professionale






















 Pedrini Direttore Tecnico Dimensione Pulito
Pedrini Direttore Tecnico Dimensione Pulito










































































































 Giuseppe Riello, president of AFIDAMP
Giuseppe Riello, president of AFIDAMP


















 Andrea Laguardia, National Director of Legacoop Produzione e Servizi
Andrea Laguardia, National Director of Legacoop Produzione e Servizi